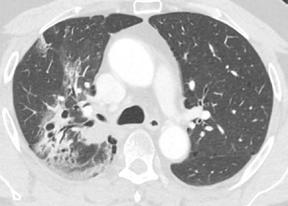

![]()



Patrocina: Colabora: Organiza:

Título: II Clinic Contest Navarra. Concurso Casos Clínicos en Fibrilación Auricular, Tromboembolismo Venoso asociado al Cáncer y Control de Dislipemia con Terapia Oral en el ámbito sanitario de Navarra.
Coordinador:
Gonzalo Luis Alonso Salinas. Cardiología. Hospital Universitario de Navarra (HUN).
Edición: Gráficas Pamplona.
Colegio de Médicos de Navarra: Avda. Baja Navarra, 47 (31002) Pamplona Tfno. 948 22 60 93 • Fax 948 22 65 28 prensa@medena.es // www.colegiodemedicos.es
I.S.B.N.: 978-84-09-74461-9
DL. Acceso: 1380-2025
https://colegiodemedicos.es/ https://www.daiichi-sankyo.es/
© Reservados todos los derechos de edición.
© Queda prohibida la reproducción total o parcial de esta obra por cualquier medio o procedimiento.
en Fibrilación Auricular, Tromboembolismo Venoso asociado al Cáncer y Control de Dislipemia con Terapia
Oral en el ámbito sanitario de Navarra
PRIMER PREMIO ANTICOAGULANDO AL BORDE DEL ABISMO: TRES EVENTOS, UNA DECISIÓN ...........................................................................
Alberto Vera Sainz. Cardiología. HUN.
Elena Sola Aparicio. Hematología. HUN.
ACCÉSIT
Amaia Ochoa González. MIR. Cardiología. CUN.
Rocío Álvarez Abril. MIR Cardiología. CUN.
Nahikari Salterain González. Cardiología. CUN.
Juan José Gavira Gómez. Cardiología. CUN.
FIBRILACIÓN AURICULAR Y UNA VÁLVULA MECÁNICA
EN UN CASO DE DISECCIÓN AÓRTICA IATROGÉNICA. ¿QUÉ PUEDE SALIR MAL? ........................................................................................ 33
Andoni Fernández González. MIR Cardiología. HUN.
Pablo Legarra Oroquieta. Cardiología. HUN.
Marina Virosta Gil. Cardiología. HUN.
FIBRILACIÓN AURICULAR PERIOPERATORIA (FAOP): ¿EPIFENÓMENO AISLADO O SIGNO DE ALARMA? .................................. 39
Jorge Gutiérrez Dubois. Medicina Interna. HUN. J. Ignacio Alaez Cruz. Medicina Interna. HUN.
Ignacio Otermin Maya. Medicina interna. HUN.
BRADIARRITMIA EN PACIENTE CON FIBRILACIÓN AURICULAR, ¿EVOLUCIÓN DE LA ENFERMEDAD O EFECTO FARMACOLÓGICO? .................................... 45
Ángela García Zuazola. MIR Cardiología. HUN.
Coro Velasco Gametxogoikoetxea. MIR. Cardiología. HUN.
Inés Suescun Colomo. MIR. Cardiología. HUN
FIBRILACIÓN AURICULAR EN PACIENTE JOVEN Y CHA2DS2-VA=0, ¿REQUIERE UN MANEJO ESPECIAL? ............................ 51
Coro Velasco Gametxogoikoetxea. MIR. Cardiología. HUN.
Ángela García Zuazola. MIR Cardiología. HUN.
Inés Suescun Colomo. MIR Cardiología. HUN.
ABLACIÓN DE VENAS PULMONARES MEDIANTE ELECTROPORACIÓN PARA EL CONTROL DEL RITMO EN LA FIBRILACIÓN AURICULAR PERMANENTE: A LA CUARTA VA LA VENCIDA ............................................................................................................................ 57
María Del Carmen Santisteban Alonso. MIR. MFyC. C.S.IturramaHUN.
Paola Herrero González. MIR MFyC. C.S.Iturrama-HUN.
Ana Smith López. MIR. MFyC. C.S. Iturrama-HUN
ANTICOAGULACIÓN EN FA, ¿EXISTE ALGO MÁS? .....................................
62
Paola Herrero González. MIR MFyC C.S. Iturrama-HUN.
Ana Smith López. MIR MFyC C.S. Iturrama-HUN.
María Del Carmen Santisteban Alonso. MFyC C.S. Iturrama-HUN.
FIBRILACIÓN AURICULAR EN PORTADOR DE MARCAPASOS: MANEJO MULTIDISCIPLINAR .................................................................................
67
Jana Millán Bernal. MIR MFyC. C.S. Aranguren.
Blanca López De Jaime. MIR MFyC. C.S. Aranguren.
CUANDO EL ELECTROCARDIOGRAMA
CALLA, EL SÍNTOMA HABLA ...................................................................................
73
Ana María Álvarez Aramburu. Medicina Interna. HUN.
Blanca López De Jaime. Medicina Interna. HUN.
Laura Aparicio Cordero. Medicina Interna. HUN.
FIBRILACIÓN AURICULAR Y PREVENCIÓN
SECUNDARIA DEL ICTUS: CUANDO LA ANTICOAGULACIÓN NO ES SUFICIENTE ......................................................... 78
Amaia Loyola Arrieta. MIR Cardiología. HUN.
Maite Odriozola Garmendia. MIR Análisis Clínicos. HUN.
Marina Virosta Gil. MIR Cardiología. HUN.
EMBOLISMO RECURRENTE CON INR TERAPÉUTICO:
¿PUEDE FALLAR LO QUE PARECE FUNCIONAR? ...................................... 85
Marina Virosta Gil. MIR Cardiología. HUN.
Amaia Loyola Arrieta. MIR Cardiología. HUN.
Andoni Fernández González. MIR. Cardiología. HUN.
FIBRILACIÓN AURICULAR EN EL ANCIANO FRÁGIL: EQUILIBRIO CLÍNICO ENTRE CARDIOVERSIÓN, ANTICOAGULACIÓN Y FUNCIÓN .........................................................................90
Marta Lorente Escudero. MIR Geriatría. HUN.
María Del Carmen Santisteban Alonso. MIR MFyC. C.S. Iturrama.
Stephania Rodríguez Villeda. MIR Medicina del Trabajo.
¿EMBOLISMO SÉPTICO ANTICOAGULADO O FIBRILACIÓN
AURICULAR SIN ANTICOAGULAR? ANTE TODO, CALMA ...................... 95
Maider Olaizola Guerrero. MIR Medicina Interna. HUN.
June García Bascones. MIR Cardiología. HUN. Carlos Vizcay Aranaz. Medicina Interna. HUN.
FRACTURA DE CADERA EN PACIENTE ANCIANA PLURIPATOLÓGICA CON FIBRILACIÓN AURICULAR: UN ABORDAJE COMPLEJO Y LLENO DE MATICES ................................. 100
Irene Criado Martín. Geriatría. HUN.
Inés Suescun Colomo. MIR. Cardiología. HUN.
FIBRILACIÓN AURICULAR Y ANEMIA FERROPÉNICA: UNA COMBINACIÓN MUY HABITUAL, ¿MIEDO A ANTICOAGULAR? ................................................................................. 105
Amaia Urtasun Rezusta. MIR. Oncología Médica. HUN. Iratxe Sánchez Cordero. MIR MFyC. C.S. San Martín (Vitoria-Gasteiz). Ángela Gómez Garduño. Medicina Interna. HUN.
CONTROL DE FRECUENCIA EN EQUIPO .........................................................
110
Javier Ecay Narvaiz. MIR MFyC. C.S. Mendillorri. Amaia Cabasés Ordóñez. MFyC. C.S. Aranguren.
FIBRILACIÓN AURICULAR Y VALVULOPATÍA
REUMÁTICA: ASPECTOS CLAVE A CONSIDERAR........................................ 115
Inés Suescun Colomo. MIR Cardiología. HUN.
Coro Velasco Gametxogoikoetxea. MIR Cardiología. HUN.
Ángela García Zuazola. MIR Cardiología. HUN.
TROMBOEMBOLISMO VENOSO ASOCIADO A CÁNCER. Casos finalistas ..............................................................................................121
SEGUNDO PREMIO
DEL HALLAZGO INCIDENTAL AL MANEJO
DEL TROMBO TUMORAL: EBUS EN EL DIAGNÓSTICO PRECOZ DE TROMBOEMBOLISMO..................................
Ana José Martín Serrablo. MIR Neumología. HUN.
Roger Antoni Frigola Castro. MIR Cirugía Vascular. HUN.
Enara Echauri Carlos. MIR Medicina Interna. HUN.
TERCER PREMIO
DIAGNÓSTICO Y TRATAMIENTO DE LA TROMBOSIS VENOSA PROFUNDA (TVP) DISTAL EN PACIENTE ONCOLÓGICO DESDE ATENCIÓN PRIMARIA. .............................................
Iñigo Poyo Molina. MFyC. C.S. Chantrea.
......................................................................................
ACCIDENTE CEREBROVASCULAR EN RELACIÓN A CALCIFICACIÓN CASEOSA DEL ANILLO MITRAL.
¿ANTICOAGULAMOS? ................................................................................................135
Andoni Fernández González. MIR. Cardiología. HUN.
Amaia Martínez León. Cardiología. HUN.
Amaia Loyola Arrieta. MIR. Cardiología. HUN.
EMBOLISMO PULMONAR, MÁS ALLÁ DE LA TROMBOEMBOLIA ......................................................................................................140
Amaia Loyola Arrieta. MIR Cardiología. HUN.
Marina Virosta Gil. MIR Cardiología. HUN.
Andoni Fernández González. MIR Cardiología. HUN.
DE LA ALTERACIÓN ELECTROCARDIOGRÁFICA A LA TROMBOENDARTERECTOMÍA PULMONAR: UN TRATAMIENTO DEFINITIVO ............................................................................ 146
Marina De La Escosura Muñoz. MIR Neumología. HUN.
Ana José Martín Serrablo. MIR Neumología. HUN.
TROMBOSIS NO PROVOCADA:
¿UN INDICIO DE MALIGNIDAD OCULTA? ........................................................152
Ariadna Setuain Indurain. MIR Medicina Interna. HUN.
Amaia Torrecilla Ugarte. MIR Medicina Interna. HUN.
LARGA SUPERVIVENCIA TRAS TROMBOEMBOLISMO PULMONAR BILATERAL GRAVE EN PACIENTE EN SITUACIÓN DE HOSPITALIZACIÓN PALIATIVA Y CON UNA MUTACIÓN
ONCOGENÉTICA SUSCEPTIBLE DE TERAPIA ONCOLÓGICA
...........................................................................................................................
José Juan Illarramendi Mañas. Oncología Médica. HUN.
Emilio Gomez Arteta. Hematología. HUN.
Jorge Illarramendi Esteban. MIR Hematología. HUN.
Marina Segur García. Cardiología. HUN.
CRÓNICO Y MIELODISPLASIA, RELACIÓN
...................................................................................................
Marina De La Escosura Muñoz. MIR. Neumología. HUN. Andrea Téllez Lorenzo. MIR Neumología. HUN.
José Alberto Espinoza Pérez. Neumología. HUN.
TROMBOSIS VENOSA PROFUNDA COMO DEBUT DE LEIOMIOSARCOMA DE VENA CAVA ..................................................................
174
Eugenia Cañete Dellamea. MIR Oncología Médica. HUN.
Amaia Urtasun Rezusta. MIR Oncología Médica. HUN.
DE LA DISNEA INESPECÍFICA AL DIAGNÓSTICO CONFIRMADO...............................................................................
180
Amaia Cabasés Ordóñez. MFyC. C.S. Aranguren.
Javier Ecay Narváiz. MFyC. C.S. Mendillorri.
Leyre Langarica Villar. MFyC. C.S. Aranguren.
DILEMAS EN LA ANTICOAGULACIÓN ONCOLÓGICA: MANEJO DE UN TEP RECURRENTE ..................................................................
Marina Planelles Ripoll. MIR Oncología Médica. HUN.
Marta Moneo Puig. MIR Oncología Médica. HUN.
185
UN HUMO DE MUCHOS FUEGOS: DISNEA MULTIFACTORIAL EN UN PACIENTE ONCOLÓGICO .......................................................................... 191
Ignacio Antonio Martínez Adán. MIR. Neumología. HUN.
Carlos Idoate Domenech. MIR Neumología. HUN.
Sonia Herrero Martín. Neumología. HUN.
TROMBOSIS ASOCIADA A CATÉTER VENOSO CENTRAL DE INSERCIÓN PERIFÉRICA, A PROPÓSITO DE UN CASO .......................... 197
Amaia Torrecilla Ugarte. MIR Medicina Interna. HUN. Ariadna Setuain Indurain. MIR Medicina Interna. HUN.
Pablo Lasa Berasain. MIR Medicina Intensiva. HUN.
ANTICOAGULACIÓN EN PACIENTES CON CÁNCER Y AFECTACIÓN CEREBRAL, CONSIDERACIONES
ESPECIALES EN EL USO DE ANTICOAGULANTES ORALES DE ACCIÓN DIRECTA ............................................................................. 202
Sara Labari Jiménez. MIR Hematología y Hemoterapia. HUN.
Amaya Sádaba Martínez. MIR Oncología Médica. HUN.
TROMBOSIS VENOSA CEREBRAL EN CONTEXTO DE CARCINOMA DE OVARIO: UNA COMPLICACIÓN POCO COMÚN............................................................................................................... 207
Marta Moneo Puig. MIR Oncología Médica. HUN.
Maria José Lecumberri Biurrun. MIR Oncología Médica. HUN.
TRES TERRITORIOS, UN ORIGEN: EL ICTUS COMO PRIMERA PISTA DE UN SÍNDROME PROTROMBÓTICO PARANEOPLÁSICO ............................................................213
Inhar Esnaola Barriola. MIR Neurología. HUN.
Elena Escriche Gorospe. MIR Neurología. HUN.
Maria Molina Goicoechea. Neurología. HUN.
EL MANEJO INTEGRAL ANTE LO INUSUAL ................................................... 219
Ainhoa Sánchez Pastor. MIR Medicina Interna. HUN.
Pablo Aragón Muñoz. MIR Medicina Interna. HUN.
Ana María Álvarez Aramburu. Medicina Interna. HUN.
MÁS ALLÁ DE LA TROMBOSIS ............................................................................. 224
Diego Amigot Baldero. MIR Medicina Interna. HUN.
Enara Echauri Carlos. MIR Medicina Interna. HUN.
Carlos Vizcay Aranaz. Medicina Interna. HUN.
¿Y SI NO ES TEP? ......................................................................................................... 229
Andrea Ortega Picón. MIR Neumología. HUN.
Óscar Gil Sodupe. MIR Neumología. HUN.
María Alfonso Imízcoz. Neumología. HUN.
SÍNCOPE COMO SÍNTOMA GUÍA TUMORAL ................................................ 234
Andrea Macua Landívar. MIR Medicina Interna. HUN.
Ana María Álvarez Aramburu. Medicina Interna. HUN.
LO QUE SE ESCONDE TRAS UNA TROMBOSIS
VENOSA PROFUNDA ................................................................................................ 239
Laura Valderas Monge. MIR Medicina Interna. HUN.
Maddi Taboada Palacio. MIR Medicina Interna. HUN.
Francisco Javier Anniccherico Sánchez. Medicina Interna. HUN.
TROMBOSIS EN CASCADA EN EL PACIENTE ANCIANO: PRESENTACIÓN ATÍPICA DE UN ADENOCARCINOMA PANCREÁTICO OCULTO .......................................................................................... 244
Marta Lorente Escudero. MIR Geriatría. HUN.
Belén González Glaría. Geriatría. HUN.
TROMBOSIS TRAS EL CATÉTER........................................................................... 250
Claudia Agra Martínez. MIR Oncología Médica. HUN.
Amaya Sádaba Martínez. MIR Oncología Médica. HUN.
CONTROL DE DISLIPEMIA CON TERAPIA ORAL.
Casos finalistas ............................................................................................ 256
ACCÉSIT
REDEFINICIÓN DEL RIESGO CARDIOVASCULAR
EN LA PRÁCTICA CLÍNICA HABITUAL ...............................................................257
Enara Echauri Carlos. MIR Medicina Interna. HUN.
Diego Amigot Baldero. MIR Medicina Interna. HUN.
Joao Luis Modesto Dos Santos. Medicina Interna. HUN.
ACCÉSIT
CONTROL LIPÍDICO EN PACIENTES
INTOLERANTES A ESTATINAS: TOLERANCIA PRIMERO, EFECTIVIDAD DESPUÉS ................................... 262
Miriam Sánchez Sánchez. MIR Cardiología. HUN.
Lorena Malagón López. Cardiología. HUN.
Casos presentados ......................................................................................268
NO OLVIDES EL RIESGO CARDIOVASCULAR .............................................. 269
Maddi Taboada Palacios. MIR Medicina Interna. HUN.
Laura Valderas Monge. MIR Medicina Interna. HUN.
Ángela Gómez Garduño. Medicina Interna. H. García Orcoyen. Estella.
HDL ELEVADO, ¿QUÉ DEBO HACER? ............................................................. 274
Maite Odriozola Garmendia. MIR Análisis Clínicos. HUN.
Amaia Loyola Arrieta. MIR Cardiología. HUN.
Marina Virosta Gil. Cardiología. HUN.
RIESGO EXTREMO, SOLUCIONES INTELIGENTES: REDIBUJANDO EL FUTURO LIPÍDICO............................................................. 279
Pablo Aragón Muñoz. MIR Medicina Interna. HUN.
Ainhoa Sánchez Pastor. MIR Medicina Interna. HUN.
Marina Virosta Gil. Medicina Interna. HUN.
PERSIGUIENDO EL OBJETIVO: MÁS ALLÁ DE LAS INDICACIONES DE LOS TRATAMIENTOS
HIPOLIPEMIANTES .....................................................................................................
June García Bascones. MIR Medicina Interna. HUN.
Maider Olaizola Guerrer. MIR Medicina Interna. HUN.
Sergio Arnedo Hernández. Medicina Interna. HUN.
OPTIMIZACIÓN DE PERFIL LIPÍDICO MEDIANTE
TRATAMIENTO ORAL: PRESENTACIÓN DE UN CASO............................. 289
Julene Ugarriza Ortueta. MIR Cardiología. HUN.
OPTIMIZACIÓN DEL TRATAMIENTO HIPOLIPEMIANTE
EN PACIENTE DE MUY ALTO RIESGO CARDIOVASCULAR .................. 294
Amaia Yuan Ibargoyen Aira. MIR Cardiología. HUN.
LA AORTA PELUDA: EL MANEJO DE LA MANIFESTACIÓN
MÁS EXTREMA DE LA ATEROMATOSIS DEL ARCO AÓRTICO............ 299
Inhar Esnaola Barriola. MIR Neurología. HUN.
Elisa Martínez Campos. Neurología. HUN.
Roberto Muñoz Arrondo. Neurología. HUN. EZETIMIBA AL
..........................................................................................
Jon Yoldi Urdíroz. MIR Endocrinología y Nutrición. HUN.
304
Sofía Baniandrés Eizaguirre. MIR Endocrinología y Nutrición. HUN.
Ander Ernaga Lorea. Endocrinología y Nutrición. H. García Orcoyen. Estella.
PARTICULARIDADES DEL ICTUS ISQUÉMICO POR EMBOLISMO CÁLCICO: UN DESAFÍO DIAGNÓSTICO Y TERAPÉUTICO ............................................. 310
Elena Escriche Gorospe. MIR Neurología. HUN.
María Molina Goicoechea. Neurología. HUN.
Beatriz Zandio Amorena. Neurología. HUN.
DESAFÍOS DE LA HIPERCOLESTEROLEMIA
FAMILIAR EN LA MUJER...........................................................................................
316
Alba Domínguez Castillo. MIR Cardiología. CUN.
Rocío Álvarez Abril. MIR Cardiología. CUN.
ANEURISMA CORONARIO, DESAFÍO Y ESTRATEGIA PARA EL MANEJO DEL RIESGO CARDIOVASCULAR ................................321
Rocío Álvarez Abril. MIR Cardiología. CUN.
Alba Domínguez Castillo. MIR Cardiología. CUN.
INTERRELACIÓN ENTRE EL SÍNDROME DE MOYAMOYA Y LA ATEROESCLEROSIS: EL PAPEL DE LA LIPOPROTEÍNA(A) EN LA PATOGENIA VASCULAR ..................................
326
Adrián Jiménez Delgado. MIR. Neurología. HUN. Elena María Escriche Gorospe. MIR Neurología. HUN. Inhar Esnaola Barriola. MIR Neurología. HUN.
VICTORIA DE LAS TERAPIAS CLASICAS FRENTE A iPCSK9 EN EL MANEJO DE LA HIPERCOLESTEROLEMIA
FAMILIAR HOMOCIGOTA ..........................................................................................331
Ángela Alonso Echarte. MIR Endocrinología y Nutrición. HUN. Javier Aguirre Castiella. MIR Endocrinología y Nutrición. HUN.
Ander Ernaga Lorea. Endocrinología y Nutrición. H. García Orcoyen. Estella.
de autores .......................................................................................... 338
La medicina se construye a partir del conocimiento compartido, la experiencia clínica y el compromiso continuo con la mejora asistencial. Esta segunda edición del libro de casos clínicos sobre anticoagulación y lípidos consolida un proyecto que nació con vocación docente y colaborativa, y que hoy puede considerarse el mayor concurso de casos clínicos a nivel regional, tanto por número de participantes como por volumen de casos presentados. Además, se ha convertido en una de las iniciativas más reconocidas y valoradas a nivel nacional dentro del ámbito de la formación médica basada en casos.
En esta edición han participado profesionales de Osasunbidea, de centros de salud, del Hospital Universitario de Navarra y de la Clínica Universidad de Navarra. La colaboración entre atención primaria y especializada, así como entre hospitales públicos y privados, vuelve a demostrar la capacidad de la comunidad médica navarra para trabajar unida, con rigor y entusiasmo. Como en la edición anterior, la participación de médicos residentes y adjuntos ha sido clave: la mirada complementaria de diferentes generaciones enriquece cada caso y refleja la realidad del trabajo clínico en equipo.
Como novedad destacada, esta segunda entrega incorpora una sección centrada en el manejo de los lípidos, con casos clínicos especialmente relevantes que abordan desde el diagnóstico hasta la toma de decisiones terapéuticas en contextos reales. Esta ampliación temática reafirma el espíritu de este proyecto: ofrecer una herramienta formativa dinámica, útil y profundamente conectada con la práctica diaria.
Mantener el nivel científico y humano de la primera edición era un reto, pero también una responsabilidad. Y esta segunda edición no solo ha estado a la altura, sino que ha reforzado el carácter integrador y participativo de la iniciativa. La final de la liga, como ya es tradición, ha sido una auténtica fiesta de la medicina: un espacio de encuentro, aprendizaje y celebración compartida del conocimiento clínico.
Es un honor seguir formando parte de este camino. Este libro es más que una recopilación de casos; es un reflejo del compromiso de nuestros profesionales con la excelencia, la docencia y el trabajo en equipo. Gracias a todos los que lo han hecho posible. Que esta segunda edición continúe inspirando, enseñando y uniendo.
Gonzalo Luis Alonso Salinas. Cardiólogo del Hospital Universitario de Navarra, profesor de la Universidad Pública de Navarra y coordinador del Certamen.
Al Colegio de Médicos de Navarra, por asumir el proyecto y coorganizarlo. A los Comités Científicos, por su dedicación.
■ Comité Científico Coagulación:
Dra. Maria José Paloma Mora .... Hematología. HUN.
Dr. Javier Romero Roldán ........... Cardiología. HUN.
Dra. Lucia Teijeira Sánchez ........ Oncología. HUN.
Dr. Abel Cedeño Veloz ................ Geriatría. HUN.
■ Comité Científico Lípidos:
Dra. Emma Anda Apiñaniz.......... Endocrinología. HUN.
Dra. Maria Bonilla Hernández .... Medicina Interna. HUN.
Dra. Lizar Zabala Diaz ................. Cardiología. HUN.
Dra. María Herrera Isasi .............. Neurología. HUN.
A quienes han moderado el Concurso:
Dra. Beatriz Merino .................... Cardiología. HUN.
Dr. Pablo Legarra ......................... Cardiología. HUN.
Dra. María Gonzalo ..................... Geriatría. HUN.
Dra. Itxaso Marín ......................... Geriatría. HUN.
Dr. Ander Ernaga .......................... Endocrinología. HUN.
Dr. Rafael Bartolomé ................... AP. Centro de salud de Rochapea.
Dr. Julio Sánchez .......................... Medicina Interna. HUN.
Dra. Edurne Madoz ...................... AP. Centro de salud de Burlada.
Dra. Julia Coll ................................ Hematología. HUN.
Dra. María Victoria Aznar .......... Hematología. HUN.
Dra. Amaia Ibarra ......................... Urgencias. HUN.
Dra. Ana García Arellano ............ Urgencias. HUN.
Al Jurado calificador de la sesión final:
Dra. Virginia Álvarez Asiain ....... Jefa Área del Corazón. HUN.
Dra. Margarita Redondo Izal ...... Jefa Servicio Hematología. HUN.
Dra. María Ruiz Castellano ......... Jefa Servicio Medicina Interna. HUN.
A Daiichi-Sankyo, por su patrocinio.

II CLINIC CONTEST NAVARRA En Fibrilación Auricular, Tromboembolismo Venoso asociado al Cáncer y Control de Dislipemia con Terapia Oral en el ámbito sanitario de Navarra
Alberto Vera Sainz. Cardiología.
Elena Sola Aparicio. Hematología.
Hospital Universitario de Navarra (HUN).

CLINIC CONTEST NAVARRA En Fibrilación Auricular, Tromboembolismo Venoso asociado al Cáncer y Control de Dislipemia con Terapia Oral en el ámbito sanitario de Navarra Fibrilación auricular
Paciente de 61 años con antecedentes de fibrilación auricular (FA) de reciente diagnóstico no anticoagulada por CHA2DS2VA 0. Consulta en Urgencias el día 16/02/2022 por afasia. A su llegada el paciente se encuentra asintomático, sin embargo, mientras permanece en Urgencias vuelve a presentar un nuevo episodio de afasia. A la exploración física, además de la afasia, presenta anestesia de toda la extremidad superior derecha. Se activa código ictus y se hace un angioTAC craneal, que muestra una oclusión de la rama M1 de la arteria cerebral media izquierda de perfil cardioembólico. Se decide iniciar tratamiento fibrinolítico y tratamiento endovascular, recanalizando la rama M2 de la arteria cerebral media mediante el implante de un stent retriever al cuarto intento. Tras ello, el paciente pasa a la Unidad de Ictus con mejoría sintomática.
El día 18/2/2022 el paciente refiere dolor torácico. Se realiza un electrocardiograma, que muestra elevación del segmento ST en las derivaciones anteriores en relación con un infarto agudo de miocardio (IAM) anterior. Se activa código infarto y se realiza una coronariografía emergente, que muestra una oclusión de perfil embólico en la arteria descendente anterior media (Figura 1, flecha amarilla). Se trata con trombectomía aspirativa con buen resultado angiográfico final con flujo TIMI 3. Se inicia tratamiento con perfusión de heparina sódica. El día 19/2 el paciente comienza con cefalea muy intensa y afasia, por lo que se activa nuevamente código ictus y se realiza un angioTAC craneal que muestra una hemorragia subaracnoidea (HSA) de predominio izquierdo secundaria a sangrado por un aneurisma disecante de la rama M2 de la arteria cerebral media izquierda (Figura 2, flecha amarilla). Se decide completar estudio con una angiografía que confirma los hallazgos del TAC. Por el alto riesgo de resangrado y la necesidad de anticoagulación oral permanente, se decide embolización del aneurisma con coils, que resulta exitoso (Figura 3, flecha amarilla). Se reinicia durante el ingreso perfusión de heparina sódica y unos días antes del alta se comienza con anticoagulación oral con apixaban 5 mg/12 horas. La evolución clínica es favorable, siendo la exploración física al alta normal. Tras tres años de seguimiento bajo tratamiento con apixaban 5 mg/12 horas no han sido reportados nuevos episodios de sangrado ni de trombosis.
Alberto Vera Sainz y Elena Sola Aparicio
El caso presentado describe a un paciente de 61 años con FA de reciente diagnóstico, sin anticoagulación previa por un CHA₂DS₂-VA de 0, que desarrolla en pocos días tres eventos clínicos mayores: un ictus isquémico embólico, un IAM también de perfil embólico y una HSA secundaria a un aneurisma disecante en la rama M2 de la arteria cerebral media izquierda. Esta rara secuencia de eventos plantea un escenario clínico de extrema complejidad, donde el manejo antitrombótico, particularmente la indicación de anticoagulación oral, requiere una cuidadosa evaluación riesgo-beneficio.
Comparado con la literatura existente, el caso más cercano en complejidad es el reportado por Tokuda et al. (1) en el que un paciente con FA presentó simultáneamente un ictus embólico y un IAM debido a trombos con origen común. Este caso refuerza la relación entre FA no anticoagulada y embolismos múltiples, aunque no se describen complicaciones hemorrágicas añadidas. La presencia simultánea de eventos embólicos en cerebro y corazón, como ocurre en ambos casos, genera un reto terapéutico por la necesidad urgente de anticoagulación frente al riesgo de sangrado, más aún en presencia de dispositivos como stents coronarios o intracraneales.
Por otro lado, Cao et al. (2) presentan dos casos de ictus isquémico agudo asociado a hemorragia subaracnoidea convexa contralateral, donde la coexistencia de fenómenos isquémicos y hemorrágicos plantea dudas diagnósticas y terapéuticas similares. En ambos pacientes se administró tratamiento antitrombótico sin que se produjeran eventos hemorrágicos adicionales, lo que sugiere que, en determinados contextos, puede ser viable mantener tratamiento antitrombótico incluso tras una HSA.
Maeda et al. (3) describen una situación clínica comparable en términos de simultaneidad de eventos vasculares dispares, al reportar un caso de disección espontánea de arteria coronaria asociada a disección de arteria vertebral con HSA. Esta combinación poco frecuente resalta la importancia de considerar una fragilidad vascular subyacente o un mecanismo sistémico predisponente, como posiblemente ocurrió en nuestro paciente, donde el aneurisma disecante pudo haberse precipitado por maniobras endovasculares o factores hemodinámicos posteriores a la trombectomía.
En nuestro caso, tras el tratamiento exitoso de los tres eventos y la embolización del aneurisma, se decidió iniciar anticoagulación oral
II CLINIC CONTEST NAVARRA En Fibrilación Auricular, Tromboembolismo Venoso asociado al Cáncer y Control de Dislipemia con Terapia Oral en el ámbito sanitario de Navarra Fibrilación auricular
con apixaban 5 mg cada 12 horas, con buena tolerancia y sin recurrencias ni eventos hemorrágicos durante tres años de seguimiento. Esta evolución favorable apoya que, en pacientes seleccionados, una estrategia de anticoagulación a largo plazo puede ser segura incluso tras un episodio de HSA, si el foco hemorrágico ha sido resuelto de forma eficaz.
Este caso ilustra una presentación extremadamente infrecuente de triple evento vascular agudo en un paciente con FA no anticoagulada, y plantea un desafío terapéutico donde la decisión de anticoagular requiere balancear cuidadosamente el riesgo trombótico frente al riesgo hemorrágico. La comparación con los casos disponibles en la literatura sugiere que, con un abordaje multidisciplinar y manejo invasivo adecuado, la anticoagulación oral puede ser una estrategia válida y segura incluso en contextos clínicos inicialmente adversos.
BIBLIOGRAFÍA
1. Tokuda K, Shindo S, Yamada K, Shirakawa M, Uchida K, Horimatsu T, Ishihara M, Yoshimura S. Acute Embolic Cerebral Infarction and Coronary Artery Embolism in a Patient with Atrial Fibrillation Caused by Similar Thrombi. J Stroke Cerebrovasc Dis. 2016 Jul;25(7):1797-1799.
2. Cao Y, Cao J, Ji S, Xu S, Liu C. Acute ischemic stroke with contralateral convexal subarachnoid hemorrhage: two cases report. BMC Neurol. 2019 Jun 18;19(1):132.
3. Maeda I, Imahori T, Miyake S. A Case of Subarachnoid Hemorrhage Due to Vertebral Artery Dissection Following Spontaneous Coronary Artery Dissection on the Same Day: A Clinical Image. World Neurosurg. 2025 Jan;193: 76-78.



II CLINIC CONTEST NAVARRA En Fibrilación Auricular, Tromboembolismo Venoso asociado al Cáncer y Control de Dislipemia con Terapia Oral en el ámbito sanitario de Navarra
Amaia Ochoa González. MIR. Cardiología.
Rocío Álvarez Abril. MIR. Cardiología.
Nahikari Salterain González. Cardiología.
Juan José Gavira Gómez. Cardiología. Clínica Universidad de Navarra (CUN).

Ochoa González, Rocío Álvarez Abril, Nahikari Salterain González y Juan José Gavira Gómez
Fibrilación auricular permanente con diagnóstico reciente de angiopatía amiloide cerebral.
Varón de 78 años con antecedentes de diabetes mellitus tipo 2, hipertensión arterial, enfermedad renal crónica (FG 44 mL/min), deterioro cognitivo multidominio y múltiples antecedentes oncológicos urológicos. En marzo 2023, es diagnosticado de fibrilación auricular (FA), tras detectar pulso arrítmico en contexto de bronquitis aguda. Presentaba un riesgo cardioembólico elevado (CHA₂DS₂-VA 4) y se inició anticoagulación con rivaroxabán. En abril 2024, ante un episodio de diplopía binocular, se realizó resonancia magnética cerebral evidenciando la presencia de múltiples microhemorragias y lesiones isquémicas sugestivas de angiopatía amiloide cerebral (AAC).
En octubre de 2024 se realizó, bajo anestesia general, cierre percutáneo de orejuela izquierda mediante acceso femoral derecho, guiado por angiografía y ecocardiografía transesofágica (ETE), y ajustando la dosis de heparina intraprocedimiento de manera estrecha (guiada por TTPA). Se implantó con éxito un dispositivo Amulet 25 mm sin complicaciones. Tras el procedimiento, se suspendió anticoagulación y valorando riesgo-beneficio, se inició antiagregación con clopidogrel, manteniendo control cardiológico y neurológico estrecho.
El paciente evolucionó favorablemente, permaneciendo estable y asintomático desde el punto de vista cardiovascular. Fue dado de alta a las 48 horas, tras confirmar adecuado posicionamiento del dispositivo en ETT. A los 45 días, el ETE de control evidenció el dispositivo de cierre de orejuela izquierda normoposicionado, sin evidenciarse flujos compatibles con leak peridispositivo mediante Doppler color. Se mantuvo el tratamiento con clopidogrel, sin registrar eventos hemorrágicos ni isquémicos posteriores.
CLINIC CONTEST NAVARRA En Fibrilación Auricular, Tromboembolismo Venoso asociado al Cáncer y Control de Dislipemia con Terapia Oral en el ámbito sanitario de Navarra Fibrilación auricular
La angiopatía amiloide cerebral es una enfermedad cerebrovascular caracterizada por el depósito de proteína ß-amiloide en las paredes de arterias pequeñas y capilares cerebrales, provocando fragilidad vascular y un mayor riesgo de hemorragias intracerebrales lobares. La AAC es la causa más frecuente de hemorragia cerebral lobar espontánea en adultos mayores normotensos y su prevalencia aumenta con la edad, alcanzando hasta un 20-40% de las personas mayores sin demencia y un 50-60% de los pacientes con demencia.
Dado que la AAC suele ser infradiagnosticada y puede cursar de forma asintomática, el diagnóstico precoz es fundamental para la toma de decisiones clínicas, especialmente en pacientes con fibrilación auricular candidatos a tratamiento anticoagulante, ya que la presencia de microhemorragias multiplica hasta 8 veces el riesgo de hemorragia intracraneal.
En pacientes con FA y diagnóstico de AAC, los anticoagulantes deben evitarse, considerando siempre riesgo-beneficio. Algunos datos sugieren que el riesgo de hemorragia es mayor con acenocumarol o warfarina que con anticoagulantes directos, aunque la evidencia aún es limitada. Por ello, la colaboración estrecha entre servicios de Cardiología y Neurología, es fundamental para confirmar el diagnóstico y establecer un abordaje multidisciplinar.
En este contexto clínico de alto riesgo hemorrágico, el cierre percutáneo de orejuela izquierda representa una alternativa segura y eficaz para la prevención del ictus. Sin embargo, tras el CPOI, la estrategia antitrombótica óptima a seguir en pacientes con FA no valvular no está completamente definida. Los ensayos clínicos sugieren inicialmente 45 días de anticoagulación más aspirina después del implante percutáneo, seguido de 6 meses de doble antiagregación en pacientes sin fugas significativas alrededor del dispositivo, y posteriormente monoantiagregación. A pesar de esto, la práctica clínica nos enfrenta a individualizar las recomendaciones de práctica clínica teniendo en cuenta el riesgo beneficio de nuestros pacientes.
Amaia Ochoa González, Rocío Álvarez Abril, Nahikari Salterain González y Juan José Gavira Gómez
1. Van Gelder IC, Rienstra M, Bunting KV, Casado-Arroyo R, Caso V, Crijns HJGM, et al. 2024 ESC Guidelines for the management of atrial fibrillation developed in collaboration with the European Association for CardioThoracic Surgery (EACTS). Eur Heart J. 2024; ehae176. doi:10.1093/eurheartj/ ehae176.
2. Llagostera-Martín M, Cainzos M, Salvatella N, Cubero-Gallego H, Mas-Stachurska A, Sánchez-Carpintero A, et al. Single antiplatelet therapy after left atrial appendage closure in patients with AF: safety and effectiveness. Rev Esp Cardiol. 2024;77(2):150-7. doi: 10.1016/j. recesp.2023.06.013.
3. Sánchez-Carpintero A, Llagostera-Martín M, Cubero-Gallego H, Salvatella N, Mas-Stachurska A, Cainzos M, et al. Efectividad y seguridad de una estrategia de antiagregación plaquetaria simple tras cierre percutáneo de orejuela izquierda en pacientes con fibrilación auricular. Rev Esp Cardiol. 2024;77(2):158-66. doi:10.1016/j.recesp.2023.06.014.
4. Kozberg MG., Perosa V., Gurol ME., van Veluw SJ. A practical approach to the management of cerebral amyloid angiopathy. International Journal of Stroke. 2021;16(4):356-69, doi: 10.1177/1747493020974464.
5. H.J. Lin, P.A. Wolf, M. Kelly-Hayes, A.S. Beiser, C.S. Kase, E.J. Benjamin, et al. Stroke severity in atrial fibrillation. The Framingham Study. Stroke, (1996), 27 pp. 1760-1764
6. D.R. Holmes, V.Y. Reddy, Z.G. Turi, S.K. Doshi, H. Sievert, M. Buchbinder, et al. Percutaneous closure of the left atrial appendage versus warfarin therapy for prevention of stroke in patients with atrial fibrillation: a randomised non-inferiority trial. Lancet, (2009), 374 pp. 534-542. http:// dx.doi.org/10.1016/S0140-6736(09)61343-X|Medline.
7. Wilson D, et al. Cerebral microbleeds and intracerebral hemorrhage risk in anticoagulated patients. Stroke. 2019; 50(4): 1044–1050.
8. V.Y. Reddy, S. Möbius-Winkler, M.A. Miller, P. Neuzil, G. Schuler, J. Wiebe, et al. Left atrial appendage closure with the watchman device in patients with a contraindication for oral anticoagulation: the ASAP study (ASA Plavix Feasibility Study With Watchman Left Atrial Appendage Closure Technology).
9. J Am Coll Cardiol, (2013), 61 pp. 2551-2556 http://dx.doi.org/10.1016/j. jacc.2013.03.035|Medline.

II CLINIC CONTEST NAVARRA En Fibrilación Auricular, Tromboembolismo Venoso asociado al Cáncer y Control de Dislipemia con Terapia Oral en el ámbito sanitario de Navarra
AURICULAR Y UNA VÁLVULA
NO FINALISTAS
CASOS PRESENTADOS
Andoni Fernández González.
MIR. Cardiología.
Pablo Legarra Oroquieta. Cardiología.
Marina Virosta Gil.
Cardiología.
Hospital Universitario de Navarra (HUN)

CLINIC CONTEST NAVARRA En Fibrilación Auricular, Tromboembolismo Venoso asociado al Cáncer y Control de Dislipemia con Terapia Oral en el ámbito sanitario de Navarra Fibrilación auricular
Mujer de 73 años con antecedentes de hipertensión arterial, trombopenia en contexto de lupus eritematoso sistémico, episodio de hipotiroidismo inducido por amiodarona y fibrilación auricular (FA) en estrategia de control de frecuencia cardiaca, anticoagulada con antivitamina K. Como fundamental antecedente cardiológicos destaca una valvulopatía reumática con afectación mitral, que inicialmente se reparó en 1997 mediante abordaje transapical (dejando como secuela aneurisma apical) y se recambió en 2007 por prótesis mecánica. Posteriormente, fue diagnosticada de doble lesión aórtica reumática con estenosis severa e insuficiencia ligera, con fracción de eyección preservada, pero insuficiencia tricuspídea severa e hipertensión pulmonar de predominio poscapilar. Ingresó programada para implante percutáneo de válvula aórtica (TAVI) vía transfemoral, con los principales condicionantes de bloqueo de rama derecha y altura límite de tronco coronario izquierdo (TCI), por lo que se administró clopidogrel 600 mg previamente al procedimiento.
Previo implante de marcapasos temporal yugular derecho se llevó a cabo el procedimiento. Durante la liberación de prótesis mediante inflado del balón, tuvo lugar la embolización supra-anular de la misma, dejando por un lado una insuficiencia aórtica severa y por otro lado ocluyendo parcialmente ambos troncos coronarios. Empleando doble acceso radial se enganchó la prótesis mediante un lazo y se desplazó hacia aorta ascendente, dejando hueco para la colocación de una segunda prótesis en situación correcta y evitando la oclusión de los ostium coronarios y troncos supra-aórticos. En ausencia de bloqueo auriculoventricular se retiró el marcapasos temporal, se evidenció un hematoma yugular derecho y, a través de analítica, se detectó anemización de 2,5 puntos. Mediante angiografía, se descartó enfermedad coronaria y, mediante ecocardiograma transesofágico, se confirmó normoposición de la prótesis, objetivándose al mismo tiempo una disección aórtica.
DIAGNÓSTICO Y ACTITUD INICIAL
Se realizó una tomografía computarizada (TC) con contraste de forma emergente, que mostró una disección aórtica iatrogénica tipo A focal de origen en la zona 0 del cayado con extensión al tronco braquiocefálico derecho (1) sin afectar al resto de troncos supra-aórticos, cayado o aorta descendente (Figuras 1 y 2); además del hematoma
IATROGÉNICA. ¿QUÉ PUEDE SALIR MAL?
Andoni Fernández González, Pablo Legarra Oroquieta y Marina Virosta Gil
yugular con signos de sangrado activo. La paciente fue trasladada a la unidad de cuidados críticos cardiológicos. Teniendo en cuenta el alto riesgo hemorrágico (necesidad de anticoagulación permanente, administración de clopidogrel previa al TAVR y sangrado activo cervical), el alto riesgo quirúrgico y la ausencia de compromiso neurológico y hemodinámico se optó por manejo conservador (2,3) con monitorización estrecha mediante técnicas de imagen cardiaca y control estricto de la presión arterial (4).
MANEJO DEL CASO
Una vez tomada la decisión acerca del manejo médico de la patología, quedaba la complicada decisión acerca de la suspensión y posterior reinicio de anticoagulación.
Como argumentos a favor del reinicio precoz de la anticoagulación, destacan la FA con severa dilatación auricular izquierda, la condición de portadora de válvula mecánica mitral y la existencia de aneurisma apical (aumento del riesgo trombo-embólico, aunque no suponga por sí misma indicación para anticoagulación).
Como principales argumentos en contra, destacan la disección aórtica aguda, el sangrado activo cervical y la administración de clopidogrel previa al procedimiento.
En nuestro caso, debido al elevado riesgo de eventos tromboembólicos, se decidió el reinicio de la anticoagulación una vez cedida la anemización y el sangrado cervical.
Durante las primeras horas de ingreso, se identificó FA con periodos autolimitados de bloqueo auriculoventricular completo, sin evidencia de hipoperfusión ni signos de insuficiencia cardiaca. La repetición del ecocardiograma trans-torácico no mostró progresión de la disección. A pesar de la compresión del hematoma cervical, la anemia progresó hasta 7,8 g/dL precisando transfusión de un concentrado de hematíes, y hubo agravamiento de la trombopenia precisando bolos de corticoides. Se pospuso la anticoagulación hasta cese de sangrado, reiniciándose bajo pauta de heparina no fraccionada, sin progresión adicional de la anemia. La paciente experimentó una evolución clínica favorable, con estabilidad hemodinámica, sin nuevos episodios de sangrado ni progresión de la disección aórtica. Precisó intervención quirúrgica en dos ocasiones, por pseudoaneurisma
II CLINIC CONTEST NAVARRA En Fibrilación Auricular, Tromboembolismo Venoso asociado al Cáncer y Control de Dislipemia con Terapia Oral en el ámbito sanitario de Navarra Fibrilación auricular
y disección de la arteria radial derecha, respectivamente. Finalmente pudo ser dada de alta tras 22 días de ingreso (Figura 3), bajo anticoagulación con acenocumarol.
Previamente a la realización de una intervención invasiva, es necesario plantear el riesgo de complicaciones.
La necesidad de anticoagulación en pacientes con elevado riesgo tromboembólico puede ser un quebradero de cabeza en caso de complicaciones vasculares.
La decisión de reintroducir anticoagulación y la elección del momento óptimo deben ser individualizados en escenarios de compleja resolución para los que no existe evidencia sólida.
En pacientes con tratamiento antitrombótico es imprescindible la reevaluación constante de la situación para la detección y manejo precoz de complicaciones.
1. 2024 ESC Guidelines for the management of peripheral arterial and aortic diseases. European Heart Journal (2024) 45, 3538–3700. https://doi. org/10.1093/eurheartj/ehae179.
2. Cavanaugh, S.; Amirjamshidi, H.; Hisamoto, K. Navigating the Unexpected: Iatrogenic Aortic Injuries during Transcatheter Aortic Valve Replacement (TAVR). J. Clin. Med. 2023, 12, 7630.
3. Ashwat E, Ahmad D, Pompeu M, et al. Acute Aortic Dissection After Transcatheter Aortic Valve Replacement, The American Journal of Cardiology, Volume 222, 2024, Pages 108-112.
4. Rujirachun P, Junyavoraluk A, Jakrapanichakul D, et al. Immediate aortic dissection after transcatheter aortic valve replacement: A case report and review of the literature. Clin Case Rep. 2021 Jul 6;9(7): e04412.
AURICULAR Y
EN UN CASO DE DISECCIÓN AÓRTICA IATROGÉNICA. ¿QUÉ PUEDE SALIR MAL?
Andoni Fernández González, Pablo Legarra Oroquieta y Marina Virosta Gil

Figuras 1 y 2: Prótesis aórtica migrada y disección aórtica focal tipo A, de origen en la curvatura menor del arco aórtico (zona 0) hasta la bifurcación de la arteria braquiocefálica derecha; sin afectación de del resto de troncos supra-aórticos, del resto del cayado aórtico o de la aorta descendente.

II CLINIC CONTEST NAVARRA En Fibrilación Auricular, Tromboembolismo Venoso asociado al Cáncer y Control de Dislipemia con Terapia Oral en el ámbito sanitario de Navarra Fibrilación auricular
Dia 1: Implante de TAVI
Dia 3: Cese de sangrado. Reinicio de anticoagulación
Dia 2: Anemización. Transfusión de hematíes
Dias 8 y 9: Pseudoaneurisma radial derecho: Diagnóstico e intervención
Dias 16: Disección distal de arteria radial derecha: Diagnóstico e intervención Ingreso

Dia 2: Disección aórtica tipo A
Dia 2: Hematoma cervical derecho
Alta +22
Dia 7: Angio-TC de control
• Estabilidad de disección aórtica
• Reducción del hematoma cervical
Dia 2: Agudización de trombopenia
Administración de bolus de corticoides
Figuras 3: Timeline de eventos y complicaciones que tuvieron lugar desde el ingreso hasta el alta, en orden cronológico.
II CLINIC CONTEST NAVARRA En Fibrilación Auricular, Tromboembolismo Venoso asociado al Cáncer y Control de Dislipemia con Terapia Oral en el ámbito sanitario de Navarra
NO FINALISTAS
CASOS PRESENTADOS
Jorge Gutiérrez Dubois. Medicina Interna.
J. Ignacio Alaez Cruz. Medicina Interna.
Ignacio Otermin Maya. Medicina interna.
Hospital Universitario de Navarra (HUN)

CLINIC CONTEST NAVARRA En Fibrilación Auricular, Tromboembolismo Venoso asociado al Cáncer y Control de Dislipemia con Terapia Oral en el ámbito sanitario de Navarra Fibrilación auricular
Paciente de 72 años sin antecedentes de interés hasta la fecha, ingresa para intervención de artroplastia total de cadera izquierda.
El acto quirúrgico y anestésico transcurren sin incidencias.
A la mañana siguiente de la intervención, y mientras se encuentra monitorizada en sala de reanimación, se objetiva arritmia cardíaca por fibrilación auricular (FA) con respuesta ventricular media (RVM) a 88 lpm sin alteraciones en el segmento ST. La paciente se encuentra totalmente asintomática desde el punto de vista cardiorrespiratorio, con EVA de 0 y hemodinámicamente estable con TA de 138/63, eupneica manteniendo saturación de O2 de 97% con gafas de oxígeno a 2 lpm y afebril. Diuresis por encima de 0.5 ml/kg/min con un volumen en 24 horas de 920 cc para un balance total de + 1500 cc. Drenaje de 250 cc y hemoglobina esa mañana 11.5 g/dL.
El servicio de anestesia se pone en contacto con nosotros, que indicamos administrar 300 mg de amiodarona ev antes del alta a planta.
Ya en planta se sigue objetivando la arritmia cardíaca sin que haya cambios en la situación clínica de la paciente, por lo que se decide iniciar perfusión continua de 600 mg de amiodarona en 12 horas. Al terminar la perfusión, la paciente sigue arrítmica, hemodinámicamente estable, con FC en torno a 90 lpm y sin cambios clínicos, por lo que se decide iniciar tratamiento con bisoprolol a dosis de 2.5 mg. cada 12 horas con buena tolerancia y recuperando Rs.
Al alta, la paciente continúa con el tratamiento con bisoprolol a la misma dosis y apixaban 2.5 mg cada 12 horas como profilaxis de enfermedad tromboembólica tras artroplastia total de cadera. CHA₂DS₂ VASc 2 puntos. Se solicitan Ecocardiograma TT y HOLTER de forma ambulatoria con revisión en consulta.
Revisión en consulta a los 2 meses; asintomática y en ritmo sinusal. Ecocardiograma TT: datos de cardiopatía hipertensiva con FEVi conservada y sin dilatación auricular.
Holter: Ritmo sinusal, FC entre 47 y 93 lpm y FC media 64 lpm. Sin pausas significativas ni BAV. ESV y EV aislados no significativos. No se registran episodios de FA.
Se procede a dar de alta a la paciente manteniendo su tratamiento con bisoprolol y sin iniciar anticoagulación.
¿EPIFENÓMENO
O SIGNO DE ALARMA?
Jorge Gutiérrez Dubois, J. Ignacio Alaez Cruz e Ignacio Otermin Maya.
La fibrilación auricular paroxística (FAP) periquirúrgica es una complicación relativamente frecuente, especialmente en cirugía cardíaca donde aparece hasta en el 30-50% de los pacientes (1-3). En el caso de la cirugía mayor no cardiotorácica, como la artroplastia total de cadera, la incidencia se estima entre el 1 y el 5% de los casos (4) y se relaciona con la edad avanzada, antecedentes de FAP previa, valvulopatías, HTA y aumento de diámetro de aurícula izda.
La importancia de estos eventos radica en averiguar si se tratan de fenómenos aislados en relación al estrés que conlleva la intervención, o si bien son una alarma o un signo de una cardiopatía subyacente y/o predisponen a la aparición posterior de FA.
¿Qué dicen los estudios al respecto? 30–50% resolución espontánea a Rs dentro de las primeras 24 horas (5).
Marcador de desarrollar FA permanente con el tiempo: 25-40% desarrollan FA permanente o recurrente en los próximos 5 años (6).
Aumento de desarrollo de ictus 1.5–2 veces en estos 5 años (7).
¿Y la anticoagulación?
Acudamos a las guías:
II CLINIC CONTEST NAVARRA En Fibrilación Auricular, Tromboembolismo Venoso asociado al Cáncer y Control de Dislipemia con Terapia Oral en el ámbito sanitario de Navarra Fibrilación auricular
Aspecto
Estratificación del riesgo
FA < 48 horas
Score CHA2DS2VACs obligatorio + HAS-BLED para riesgo hemorrágico Guías Europeas (ESC)
CHA2DS2-VASc=0: No anticoagulación
• CHA2DS2-VASc=1 (♀) ó 2 (♂): Considerar anticoagulación (Clase IIª, Nivel B)
• CHA2DS2-VASc≥2 (♂) ó ≥3(♀): Anticoagulación recomendada (Clase I, Nivel A)
FA > 48 horas
Duración postresolución
Anticoagulación recomendada independientemente del CHA2DS2VACs )Clase I, Nivel A)
Bajo riesgo: mínimo 4 semanas
• Con factores de riessgo: Considerar 12 semanas
• Monitorización ECG recomendada
Elección de anticoagulante
Particularidades
ACODs prefeeridos sobre AVK (Clase I, Nivel A)
• Fase perioperatoria: HBPM inicialmente
• Diferenciación más explícita por género en CHA2DS2VACs
• Mayor prefeerencia por ACODs
Guías Americanas (AHA/ACC)
Score CHA2DS2VACs obligatorio + valoración del riesgo hemorrágico perioperatorio
Bajo riesgo: anticoagulación no mandatoria
• CHA2DS2-VASc≥2: Considerar anticoagulación (Clase IIª)
• Decisión individualizada según riesgo de sangrado
Anticoagulación recomendada si no hay contraindicaciones (Clase I)
Mínimo 4 semanas tras cardioversión
• Extensión en pacientes con alto riesgo embólico
• Monotorización ECG para confirmar ritmo sinusal
ACODs o warfarina (INR 2.03.0) considerados equivalentes
• Fase perioperatoria: heparina no fraccionada o HBPM
• Mayor énfasis en individualización según riesgo homerrágico perioperatorio
• Equilibrio riesgo embólico vs. riesgo homorrágico
¿EPIFENÓMENO AISLADO O SIGNO DE ALARMA?
Jorge Gutiérrez Dubois, J. Ignacio Alaez Cruz e Ignacio Otermin Maya.
O más gráfico en un algoritmo:
Áreas de incertidumbre
¿Dosis de prevención tromboembólica en bajo riesgo?
En cuanto al seguimiento: ¿ECG anual? ¿Holter en esos 5 primeros años?
¿Se mantiene el tratamiento con beta bloqueante?
¿Si aumenta el CHADS VASC a pesar de no objetivarse recidiva, ACO?
II CLINIC CONTEST NAVARRA En Fibrilación Auricular, Tromboembolismo Venoso asociado al Cáncer y Control de Dislipemia con Terapia Oral en el ámbito sanitario de Navarra Fibrilación auricular
1. Echahidi N, Pibarot P, O’Hara G, Mathieu P. Mechanisms, prevention, and treatment of atrial fibrillation after cardiac surgery. J Am Coll Cardiol 2008;51:793–801. https://doi. org/10.1016/j.jacc.2007.10.043.
2. Gillinov AM, Bagiella E, Moskowitz AJ, Raiten JM, Groh MA, Bowdish ME, et al. Rate control versus rhythm control for atrial f ibrillation after cardiac surgery. N Engl J Med 201.
3. Gaudino M, Di Franco A, Rong LQ, Piccini J, Mack M. Postoperative atrial fibrillation: from mechanisms to treatment. Eur Heart J 2023; 44:1020–39. https://doi. org/10.1093/ eurheartj/ehad019.
4. Bhave PD, Goldman LE, Vittinghoff E, et al. Incidence, predictors, and outcomes associated with postoperative atrial fibrillation after major noncardiac surgery. Am Heart J 2012; 164:918.
5. Danelich IM, Lose JM, Wright SS, et al. Practical management of postoperative atrial fibrillation after noncardiac surgery. J Am Coll Surg 2014; 219:831.
6. Lowres, N., Mulcahy, G., Jin, K., Gallagher, R., Neubeck, L., & Freedman, B. (2018). Incience of postoperative atrial fibrillation recurrence in patients discharged in sinus rhythm after cardiac surgery: A systematic review and meta analysis. Interactive Cardiovascular and Thoracic Surgery, 26(3), 504 511.
7. Gialdini, G., Nearing, K., Bhave, P. D., Bonuccelli, U., Iadecola, C., Healey, J. S., & Kamel, H. Perioperatie atrial fibrillation and the long term risk of ischemic stroke. JAMA, 312(6), 616, 622. https://doi.org/10.1001/ jama.2014.9143.
II CLINIC CONTEST NAVARRA En Fibrilación Auricular, Tromboembolismo Venoso asociado al Cáncer y Control de Dislipemia con Terapia Oral en el ámbito sanitario de Navarra
NO FINALISTAS
Ángela García Zuazola.
MIR. Cardiología.
Coro Velasco Gametxogoikoetxea.
MIR. Cardiología.
Inés Suescun Colomo.
MIR. Cardiología.
Hospital Universitario de Navarra (HUN).

II CLINIC CONTEST NAVARRA En Fibrilación Auricular, Tromboembolismo Venoso asociado al Cáncer y Control de Dislipemia con Terapia Oral en el ámbito sanitario de Navarra Fibrilación auricular
Paciente de 64 años acude al servicio de Urgencias por presentar cuadro de malestar general asociado a mareo de horas de evolución.
Antecedentes:
Factores de riesgo cardiovascular, Diabetes mellitus tipo 2, sobrepeso.
Historia cardiológica previa:
Fibrilación auricular (FA) y flutter auricular (FLA) común paroxísticos sintomáticos:
- En 2014 episodio de FA paroxística sintomático. Valorada en consulta de Cardiología, se realizó ecocardiograma transtorácico (ETT) que descartó cardiopatía estructural. Se realizó Holter electrocardiograma (ECG) que mostró ritmo sinusal con extrasistolias no significativas. Se inicia tratamiento con Bisoprolol 2,5 mg 1 comprimido en la cena.
- En enero 2018 presenta episodios de palpitaciones, se objetivó FA con respuesta ventricular media (RVM) a 90 lpm y episodio de FLA común. En abril se inicia tratamiento antiarrítmico y se realiza radioablación punto a punto de venas pulmonares (VVPP) y ablación del istmo cavo tricupídeo (ICT); ambas efectivas. Tras inicio del tratamiento permanece asintomática. Finalmente, en agosto 2018 se suspende Flecainida.
- En seguimiento en consultas de Arritmias, en mayo de 2019, reaparecen síntomas y presenta FA en el ECG. Se plantea reintervención. Finalmente, se reinicia Flecainida.
- En marzo 2020 se mantiene asintomática, se suspende tratamiento antiarrítmico.
- Asintomática hasta agosto de 2020, que presenta nuevos episodios. Se reinicia Flecainida.
- En los controles permanece asintomática, sin necesidad de medicación antiarrítmica.
- En abril 2024, episodio de palpitaciones de 48 horas de duración autolimitado. En ECG realizado se objetiva FLA común. Se pauta Rivaroxabán 20 mg diarios.
- En mayo 2024 en consulta de revisión, no presenta nuevos episodios. Ante reaparición del flutter, se plantea reintervención. Se acuerda con la paciente optar por estrategia “pill in the pocket”.
Episodio de FA paroxística
BRADIARRITMIA EN PACIENTE CON FIBRILACIÓN AURICULAR, ¿EVOLUCIÓN DE LA ENFERMEDAD O EFECTO FARMACOLÓGICO?
Ángela García Zuazola, Coro Velasco Gametxogoikoetxea e Inés Suescun Colomo
Episodio de palpitaciones ritmo sinusual
Episodio de palpitaciones: FA y FLA común. Consulta arritmias: ablación de VVPP+ y ablación del itsmo cavo tricuspídeo +fármacos antiarritmicos (FAA)
Persistencia síntomas
Nuevo episodio de FA
Controles: permanece asintomática
03/20: Asintomática: suspensión FAA 08/20: Nuevo episodio palpitaciones: reintroducción flecainida: permanece asintomática
Control
18/04: nuevo episodio de palpitaciones
ECG: FA y FLA común. ¿Reintervención? → estrategia pill in the pocket Se inicia anticoagulación indefinida
11/24: acude a urgencias por malestar general y mareo
ECG: FA lenta
Otros:
- Enfermedad tromboembólica venosa (ETEV) (tromboembolismo pulmonar (TEP) de riesgo bajo y trombosis venosa profunda) no provocado en diciembre de 2020 (no estaba anticoagulada por su FA al presentar CHADsVASc=1).
Tratamientos previos:
- Rivaroxabán: 20 mg/24 h (0-1-0)
- Bisoprolol: 2,5mg si precisa
- Flecainida:100mg/12h (0,5-0-0,5) si precisa-
- Escitalopram 10 mg/24h (1-0-0)
- Escitalopram 20mg/24h (0-1-0)
- Pantoprazol 40 mg/24h (1-0-0)
CLINIC CONTEST NAVARRA En Fibrilación Auricular, Tromboembolismo Venoso asociado al Cáncer y Control de Dislipemia con Terapia Oral en el ámbito sanitario de Navarra Fibrilación auricular
Acude a Urgencias el 25 noviembre por cuadro de malestar general con mareo de horas de evolución, sin otra clínica asociada. No dolor torácico, no síncope, no clínica infecciosa ni sugestiva de insuficiencia cardiaca. Se realiza ECG objetivando FA lenta a 45 lpm. Permanece hemodinámicamente estable con PA 130/80 mmHg, SatO2 basal normal, afebril. Ingresa en Observación para lavado de Flecainida (última dosis el día 24/11 a las 20h, sin toma reciente de Bisoprolol) y monitorización. Durante su estancia en Observación la mañana del día 25 presenta varias pausas sinusales significativas y sintomáticas sin llegar a sincoparse, la más larga precedida de FA a 110 lpm con posterior pausa de 8 segundos. Se solicita valoración por parte de Cardiología.
Exploración física:
Presenta buen estado general, hemodinámicamente estable con PA 130/80 mmHg, afebril, eupnecia, saturando 99% a aire ambiente. No presenta signos de ingurgitación yugular. A la auscultación cardiopulmonar permanece rítmica sin soplos ni ruidos patológicos sobreañadidos. No presenta edemas en miembros inferiores y la exploración abdominal es anodina
Pruebas complementarias:
- En ECG sucesivos se objetiva ritmo nodal a 45 lpm, que alterna rachas de FA lenta a 43 lpm. En posteriores, se evidencia bradicardia sinusal a 43 lpm. Finalmente, en la telemetría se objetivan pausas sinusales significativas sintomáticas de hasta 8 segundos, con una racha de FA rápida que sale con una pausa significativa posterior (síndrome bradicardia-taquicardia).
- Analítica de sangre: hemograma y coagulación sin alteraciones. Función renal conservada. Iones en rango. Troponinas normales. Péptido natriurético en rango normal para la edad.
- Radiografía de tórax no presenta alteraciones significativas.
- Se realiza ecoscopia que describe ventrículo izquierdo no dilatado con FEVI (fracción de eyección del ventrículo izquierdo) conservada sin segmentarismos. Sin valvulopatías significativas. Ventrículo derecho normal. Aurícula izquierda ligeramente dilatada. Insuficiencia tricuspídea leve que permite estimar una PSAP (presión sistólica de arteria pulmonar) normal. No derrame pericárdico. Vena cava inferior ligeramente dilatada con colapso inspiratorio conservado.
BRADIARRITMIA EN PACIENTE CON FIBRILACIÓN AURICULAR, ¿EVOLUCIÓN DE LA ENFERMEDAD O EFECTO FARMACOLÓGICO?
Ángela García Zuazola, Coro Velasco Gametxogoikoetxea e Inés Suescun Colomo
Durante el ingreso la paciente permanece hemodinámicamente estable, sin datos de insuficiencia cardiaca. Tras la retirada de la Flecainida desde su ingreso, se mantiene monitorizada durante toda su estancia, sin evidenciarse nuevas pausas significativas, permaneciendo en ritmo sinusal con tendencia a la bradicardia (45-60 lpm). Clínicamente, no repite sintomatología (no mareo, ni síncope). Se la realiza un test de atropina, que resulta positivo, por lo que se interpreta como disfunción sinusal en el contexto de la toma de Flecainida.
Tras comentar el caso con unidad de arritmias, se decide realizar de forma ambulatoria nueva ablación de venas pulmonares, siendo dada de alta sin tratamiento antiarrítmico.
DISCUSIÓN
La fibrilación auricular (FA) es la arritmia sostenida más frecuente, con una prevalencia estimada del 2-4% en la población general. Tiene un gran impacto a nivel de mortalidad cardiovascular por su asociación con insuficiencia cardíaca, eventos embólicos y deterioro funcional. En ocasiones, no se diferencia del flutter auricular y se asume que las implicaciones clínicas de ambas arritmias son parecidas.
Las guías proponen el abordaje de la FA mediante el enfoque AF-CARE (Fibrilación auricular—[C] Comorbilidad y manejo de los factores de riesgo, [A] Evitar los accidentes cerebrovasculares y la tromboembolia arterial, [R] Reducir los síntomas mediante el control del ritmo y la frecuencia, [E] Evaluación y reevaluación periódica); este algoritmo propone una atención integral, incorporando el control de síntomas, la evaluación del riesgo embólico y el manejo personalizado de cada paciente.
Existen casos en los que la arritmia persiste pese a un correcto manejo, lo que plantea desafíos terapéuticos importantes, como se manifiesta en la evolución del caso.
En primer lugar, en aquellos pacientes con FA paroxística sintomática que persiste pese a medicación antiarrítmica, como es el caso de nuestra paciente, se recomienda el aislamiento de venas pulmonares (AVP). No obstante, los estudios demuestran que incluso con aislamiento duradero, una proporción significativa de pacientes presentan recurrencias. En estos casos, se pueden considerar diversas opciones terapéuticas: reintervención AVP, la ablación del nodo auriculoventricular con implante de marcapasos o estrategias farmacológicas más conservadoras, como la estrategia pill-in-the-pocket (PIP).
II CLINIC CONTEST NAVARRA En Fibrilación Auricular, Tromboembolismo Venoso asociado al Cáncer y Control de Dislipemia con Terapia Oral en el ámbito sanitario de Navarra Fibrilación auricular
La PIP es útil en hasta una cuarta parte de los pacientes, permite manejar los episodios sintomáticos en domicilio mediante la autoadministración de los fármacos antiarrítmicos. Requiere un perfil determinado de pacientes: aquellos con episodios poco frecuentes, sin cardiopatía estructural significativa y con buena capacidad de reconocer sus síntomas. Los pacientes con el uso de la Flecainida pueden desarrollar disfunción sinusal, como ilustra nuestro caso (el test de atropina es positivo, por lo que el nodo sinusal funciona correctamente una vez se ha eliminado el fármaco). En estos contextos, se recomienda una nueva ablación de venas pulmonares.
En definitiva, tal como propone el algoritmo AF-CARE, es clave la atención integral de estos pacientes para garantizar una buena calidad de vida, el control de los síntomas y de la carga arrítmica, valorando en todo momento las preferencias individuales de cada paciente.
1. Hindricks G, Potpara T, Dagres N, Arbelo E, Bax JJ, Blomström-Lundqvist C, et al. 2024 ESC Guidelines for the management of atrial fibrillation developed in collaboration with the European Association for CardioThoracic Surgery (EACTS). Eur Heart J. 2024. https://doi.org/10.1093/ eurheartj/ehae176
2. Kotecha D, Ahmed A, Calvert M, Lencioni M, Terwee CB, Lane DA. Patient-reported outcomes for quality of life assessment in atrial fibrillation: a systematic review of measurement properties. PLoS One. 2016;11(11):e0165790. https://doi.org/10.1371/journal.pone.0165790
3. El Hussein MT, Pamnani P. Pill-in-the-pocket for paroxysmal atrial fibrillation: a review and case study. J Nurse Pract. 2024;20(7):105080. doi:10.1016/j.nurpra.2024.105080.
4. Reiffel JA, Blomström-Lundqvist C, Boriani G, Goette A, Kowey PR, Merino JL, Piccini JP, Saksena S, Camm AJ. Real-world utilization of the pill-inthe-pocket method for terminating episodes of atrial fibrillation: data from the multinational Antiarrhythmic Interventions for Managing Atrial Fibrillation (AIM-AF) survey. Europace. 2023 Jun 24;25(6):euad162. doi: 10.1093/europace/euad162.
II CLINIC CONTEST NAVARRA En Fibrilación Auricular, Tromboembolismo Venoso asociado al Cáncer y Control de Dislipemia con Terapia Oral en el ámbito sanitario de Navarra
CASOS PRESENTADOS
NO FINALISTAS
Coro Velasco Gametxogoikoetxea.
MIR. Cardiología.
Ángela García Zuazola.
MIR. Cardiología.
Inés Suescun Colomo.
MIR. Cardiología.
Hospital Universitario de Navarra (HUN).

CLINIC CONTEST NAVARRA En Fibrilación Auricular, Tromboembolismo Venoso asociado al Cáncer y Control de Dislipemia con Terapia Oral en el ámbito sanitario de Navarra Fibrilación auricular
Varón de 38 años, sin tratamiento habitual ni hábitos tóxicos. Como antecedentes personales destacaba un episodio aislado de palpitaciones en 2022, estudiado por Cardiología, donde no se objetivó cardiopatía estructural y el cuadro sugería extrasistolia por la variabilidad de la frecuencia cardiaca (FC) en pulso periférico. No había mostrado otra sintomatología de perfil cardiogénico y no se llegó a objetivar arritmia en el electrocardiograma (ECG). Ocurrió en contexto de estrés emocional importante. Con todo ello, se dio de alta al paciente. Por otro lado, el paciente había presentado en 2021 cefalea por hipotensión de líquido cefalorraquídeo (LCR) secundaria a fístula de LCR en espacio epidural dorsal, que fue resuelta.
Como antecedentes familiares destacaban: Flutter auricular ablacionado en el padre. Además, su abuelo y tío abuelo paterno habían presentado muerte por infarto agudo de miocardio (IAM) a los 87 años y 58 años respectivamente, según refería el paciente. Su prima paterna sufrió una muerte por IAM con 43 años y su primo paterno sufrió un IAM con 45 años, según refería también el paciente. Por parte materna afirmaba existir antecedentes cardiológicos relevantes, pero no supo especificar.
MOTIVO DE CONSULTA Y EPISODIO ACTUAL
3 años más tarde del primer episodio de palpitaciones, en 2025 acudió nuevamente al servicio de Urgencias por palpitaciones. Se trataba, por lo tanto, del segundo cuadro de palpitaciones. Refería que, nuevamente en contexto de estrés emocional importante y enfado, había experimentado un episodio de mareo seguido de un cuadro de palpitaciones, que en Urgencias mantenía, aunque de menor intensidad que al inicio. Habían transcurrido 2 horas desde el inicio del cuadro. No presentaba dolor torácico, disnea, síncope ni otra sintomatología cardiogénica añadida. El episodio le recordaba al cuadro anterior de palpitaciones de 2022. Además, refería un cuadro catarral en los días previos con congestión nasal, odinofagia y expectoración escasa de aspecto blanquecina. Sin embargo, no había asociado disnea ni fiebre ni presentaba otros síntomas por aparatos.
Exploración física:
Presentaba un buen estado general. Estaba consciente y orientado temporo-espacialmente. Se encontraba hemodinámicamente
Y CHA2DS2-VA=0, ¿REQUIERE UN MANEJO ESPECIAL?
Coro Velasco Gametxogoikoetxea, Ángela García Zuazola e Inés Suescun Colomo
estable con una tensión arterial sistólica de 124 mm Hg y una diastólica de 78 mm Hg. El pulso era irregular con una FC aproximada de 130 latidos por minuto (lpm). La saturación era 100% basal y no presentaba fiebre. No presentaba ingurgitación yugular. La auscultación pulmonar era anodina. En la auscultación cardiaca no se objetivaron soplos, pero el ritmo era irregular. No presentaba edemas ni otros signos de insuficiencia cardiaca (IC). La exploración neurológica era anodina.
Pruebas complementarias:
ECG: fibrilación auricular (FA) con una respuesta ventricular media de 131 lpm de QRS estrecho. No presentaba alteraciones en la repolarización.
Analítica sanguínea básica: hemograma sin hallazgos relevantes, los iones se encontraban en rango óptimo, la función renal estaba conservada y el NT-proBNP era de 26 pg/mL [0-450 pg/mL]. La proteína C reactiva era de 1.5 mg/L [0-5 mg/L].
EVOLUCIÓN
Tras objetivar la FA, el paciente se trasladó a la sala de reanimación para monitorización. A su llegada, mostraba una FC oscilante entre 125-160 lpm. Se administró una dosis de bisoprolol 5 mg vía oral, persistiendo FC en torno a 120 lpm. Finalmente se realizó una cardioversión eléctrica bajo sedoanalgesia con fentanilo y propofol, revirtiendo a ritmo sinusal. Se administró enoxaparina sódica 80 mg inicialmente. Tras estabilidad hemodinámica, el paciente fue dado de alta sin tratamiento anticoagulante ante escala CHA2DS2 -VA=0.
DISCUSIÓN
La FA es la taquiarritmia supraventricular sostenida más frecuente en la práctica clínica. Se ha asociado con la muerte, los síndromes coronarios agudos, la IC, la hospitalización y el accidente cerebrovascular (1). La FA de debut en pacientes jóvenes es rara, más inusual cuanto más precoz sea la edad de inicio (2). La suposición de que los pacientes menores de 60 años pueden no considerarse de riesgo es falsa por varias razones, entre ellas que hay estudios que muestran que la IC manifiesta presenta raíces en una etapa temprana de taquimiocardiopatía que podría haberse establecido años antes, quizás
CLINIC CONTEST NAVARRA En Fibrilación Auricular, Tromboembolismo Venoso asociado al Cáncer y Control de Dislipemia con Terapia Oral en el ámbito sanitario de Navarra Fibrilación auricular
por debajo de los 60 años (3). Además, las estrategias de diagnóstico actuales basadas en dispositivos portátiles han aumentado el número de pacientes diagnosticados con FA asintomática y tales diagnósticos están más extendidos en pacientes jóvenes menores de 60 años por la mayor tasa de alfabetización digital, en quienes se ve afectada por una compleja interacción de mecanismos autoinmunes, inflamatorios y electrofisiológicos (4).
La inflamación es un proceso complejo con interacciones entre diversos tipos de células inmunitarias, moléculas de señalización y componentes del complemento. El control de los anticuerpos circulantes y el diseño de autoanticuerpos específicos son opciones terapéuticas prometedoras, ya que algunos autoanticuerpos se han considerado contribuyentes potenciales en la patogénesis de la FA, actuando como agonistas simpaticomiméticos y parasimpaticomiméticos (5).
Las enfermedades arritmogénicas hereditarias incluyen las miocardiopatías, resultantes de mutaciones en genes que codifican proteínas estructurales específicas, y las canalopatías, caracterizadas por alteraciones en el potencial de acción regulador de los canales transmembrana. Ambos trastornos se asocian con remodelación auricular, cambios histológicos y alteraciones en las características del potencial de acción auricular que pueden aumentar el riesgo de FA. La primera manifestación de éstas podría ser la FA paroxística y las formas persistentes de FA tienden a no responder a los fármacos antiarrítmicos en estas afecciones (4). Además, en un estudio multicéntrico observacional retrospectivo en unidades de cardiopatías familiares se observó que en una población muy seleccionada que debutaba con FA < 50 años, existía una significativa tasa de mutaciones relacionadas con miocardiopatías, la más frecuente LMNA. Concluyeron que estos pacientes debutan más jóvenes, tienen más FA permanente y peor fracción de eyección del ventrículo izquierdo (FEVI). Por lo tanto, alcanzar un diagnóstico genético proporcionaría una oportunidad a la hora de prevenir eventos arrítmicos y muerte súbita, a pesar de que el panel genético en FA no está rutinariamente indicado (5).
Otros desencadenantes posibles en pacientes con FA menores de 60 años son la hipertensión sistémica, el sobrepeso, la diabetes y el abuso de alcohol. El consumo de alcohol, de manera dependiente de la dosis, no solo aumenta la incidencia de FA, sino que aumenta el riesgo de tromboembolia (4). El tabaco es un factor de riesgo importante para la FA, ya que tanto el tabaquismo directo como los productos de
EN PACIENTE JOVEN Y CHA2DS2-VA=0, ¿REQUIERE UN MANEJO ESPECIAL?
Coro Velasco Gametxogoikoetxea, Ángela García Zuazola e Inés Suescun Colomo
tabaco que no se queman pueden aumentar la vulnerabilidad a la FA, pues la nicotina favorece la neurotransmisión simpática e indirectamente la consiguiente fibrosis auricular (6).
En cuanto al uso de la anticoagulación, se recomienda la anticoagulación a largo plazo en los pacientes con una puntuación CHA2DS2VA de 2 o más y debe considerarse en aquellos con una puntuación CHA2DS2 -VA de 1. La anticoagulación a corto plazo tras la cardioversión (4 semanas) se indica en todos los pacientes, aunque en caso de CHA2DS2-VA=0 sería opcional si el inicio de la FA es inferior 24 horas y el riesgo tromboembólico es bajo (7). En consecuencia, no se indicó anticoagulación ni a corto ni a largo plazo al alta hospitalaria, conforme a la puntuación CHA₂DS₂-VA=0 y las recomendaciones actuales. Este caso resalta la importancia de sospechar enfermedades subyacentes incluso en FA aparentemente benigna en jóvenes y la necesidad de un enfoque diagnóstico personalizado.
II CLINIC CONTEST NAVARRA En Fibrilación Auricular, Tromboembolismo Venoso asociado al Cáncer y Control de Dislipemia con Terapia Oral en el ámbito sanitario de Navarra Fibrilación auricular
1. January CT, Wann LS, Calkins H, Chen LY, Cigarroa JE, Cleveland JC Jr, et al. 2019 AHA/ACC/HRS focused update of the 2014 AHA/ACC/HRS guideline for the management of patients with atrial fibrillation: A report of the American college of cardiology/American heart association task force on clinical practice guidelines and the heart rhythm society. J Am Coll Cardiol 2019;74(1):104–32. Disponible en: http://dx.doi.org/10.1016/j. jacc.2019.01.011
2. Pérez BG, Rojas JGS, Jiménez FJB, López AB, Jáimez JJ, Torrecillas JMG, et al. 6004-4. Fibrilación auricular DE Novo en pacientes jóvenes Como red flag DE miocardiopatía o canalopatía. Rendimiento Del estudio genético. Rev Esp Cardiol. 2024;77:696–7. Disponible en: http://dx.doi. org/10.1016/s0300-8932(25)00699-2.
3. Brugada J, Katritsis DG, Arbelo E, Arribas F, Bax JJ, Blomström-Lundqvist C, et al. 2019 ESC Guidelines for the management of patients with supraventricular tachycardia The Task Force for the management of patients with supraventricular tachycardia of the European Society of Cardiology (ESC). Eur Heart J. 2020;41(5):655–720. Disponible en: http:// dx.doi.org/10.1093/eurheartj/ehz467.
4. Curcio A, Scalise R, Indolfi C. Pathophysiology of atrial fibrillation and approach to therapy in subjects less than 60 years old. Int J Mol Sci. 2024;25(2):758. Disponible en: http://dx.doi.org/10.3390/ijms25020758.
5. Li J. The Role of Autoantibodies in Arrhythmogenesis. Curr. Cardiol. Rep. 2020;23(1):3. Disponible en: http://dx.doi.org/10.1007/s11886-020-01430-x.
6. Kondo T, Nakano Y, Adachi S, Murohara T. Effects of tobacco smoking on cardiovascular disease. Circ J. 2019;83(10):1980–5. Disponible en: http:// dx.doi.org/10.1253/circj.CJ-19-0323
7. Van Gelder IC, Rienstra M, Bunting KV, Casado-Arroyo R, Caso V, Crijns HJGM, et al. 2024 ESC Guidelines for the management of atrial fibrillation developed in collaboration with the European Association for CardioThoracic Surgery (EACTS). Eur Heart J. 2024;45(36):3314–414. Disponible en: http://dx.doi.org/10.1093/eurheartj/ehae176
II CLINIC CONTEST NAVARRA En Fibrilación Auricular, Tromboembolismo Venoso asociado al Cáncer y Control de Dislipemia con Terapia Oral en el ámbito sanitario de Navarra
NO FINALISTAS
CASOS PRESENTADOS
PERMANENTE:
María Del Carmen Santisteban Alonso.
MIR. Medicina Familiar y Comunitaria.
Paola Herrero González.
MIR. Medicina Familiar y Comunitaria.
Ana Smith López.
MIR. Medicina Familiar y Comunitaria.
Centro de Salud Iturrama/Hospital Universitario de Navarra (HUN).

II CLINIC CONTEST NAVARRA En Fibrilación Auricular, Tromboembolismo Venoso asociado al Cáncer y Control de Dislipemia con Terapia Oral en el ámbito sanitario de Navarra Fibrilación auricular
Mujer de 64 años, que acude para realización de ablación de venas pulmonares (VVPP) mediante electroporación por fibrilación auricular (FA) permanente tras tres ablaciones que no resultaron efectivas. Destacan los siguientes antecedentes personales de interés:
■ Factores de riesgo cardiovascular: Hipertensión arterial esencial (HTA) en tratamiento con Losartán 50 mg. Dislipemia en tratamiento en prevención primaria con Simvastatina 10 mg.
■ Fibrilación auricular (FA) paroxística recurrente (2014) con sintomatología de grado III según la clasificación de la European Rhytm Association (EHRA), CHA2DS2-VA2 1 punto (HTA) anticoagulada con Rivaroxabán 20 mg y con realización de tres ablaciones (2016, 2020 y 2021). Ausencia de cardiopatía estructural.
■ Síncope de perfil cardiogénico por probable disfunción sinusal farmacológica (2023).
■ Cáncer de mama izquierda multifocal tratado con mastectomía (2009), quimioterapia y tamoxifeno.
Mujer de 64 años que refiere palpitaciones y disnea de mínimos esfuerzos con limitación de la actividad diaria de meses de evolución.
Niega dolor torácico, mareo y síncope. No presenta ortopnea, bendopnea, disnea paroxística nocturna, edemas en extremidades inferiores, oliguria ni nicturia. No refiere clínica infecciosa a nivel respiratorio, digestivo ni urinario. Se encuentra afebril.
Exploración física:
En consulta presenta tensión arterial de 134/75 mm Hg y frecuencia cardiaca de 67 latidos por minuto (lpm).
- Buen estado general. Normohidratada y normoperfundida. Eupneica en reposo.
- Cabeza y cuello: No ingurgitación yugular.
- Auscultación cardiaca: Arrítmica sin soplos audibles.
- Auscultación pulmonar: Murmullo vesicular conservado sin ruidos patológicos.
- Abdomen: Anodino.
- Extremidades inferiores: No edemas ni signos de trombosis venosa profunda.
- Neurológico: No evidencia de focalidad neurológica.
ABLACIÓN DE VENAS PULMONARES MEDIANTE ELECTROPORACIÓN PARA EL CONTROL DEL RITMO EN LA FIBRILACIÓN AURICULAR PERMANENTE: A LA CUARTA VA LA VENCIDA
María Del Carmen Santisteban Alonso, Paola Herrero González y Ana Smith López
Pruebas complementarias:
- Electrocardiograma (ECG): Se objetiva FA con ritmo ventricular medio (RVM) a 63 lpm con QRS estrecho y ondas T negativas en I, aVL e intervalo QT en rango.
- Radiografía de tórax: No se evidencian cardiomegalia ni derrame pleural.
- Analítica sanguínea: Presenta hemograma, coagulación, función renal y tiroidea, perfil lipídico, férrico y hepático sin alteraciones y troponina y NT-proBNP en rango de normalidad.
- Ecocardiograma: Presenta aurículas y ventrículos con tamaño y función normales con fracción de eyección del ventrículo izquierdo (FEVI) del 60%. No se visualiza derrame pericárdico.
EVOLUCIÓN
Se trata de una mujer con FA paroxística recurrente EHRA III, que presenta progresión a FA permanente y se encuentra sintomática. Ha sido sometida a tres ablaciones de venas pulmonares (VVPP) que no han resultado efectivas.
La primera ablación se realizó mediante radiofrecuencia (RF) en mayo de 2016 y la segunda, mediante el mismo procedimiento, en febrero de 2020. Tras nueva recidiva, en julio de 2021, se efectúo el tercer procedimiento mediante crioablación.
Debido a que presentó otra recidiva de FA en marzo de 2022, se aumentó la dosis de Flecainida a 100 mg cada 12 horas. En enero de 2023, se disminuyó la dosis de Bisoprolol por empeoramiento de la clase funcional (EHRA III). Posteriormente, en noviembre de 2023, presentó un síncope de perfil cardiogénico por probable disfunción sinusal farmacológica tras nuevo episodio de FA. De modo que, se indicó tratamiento con Amiodarona 200 mg cada 24 horas y se propuso mantener en FA permanente en marzo de 2024. Sin embargo, dado que persistía muy sintomática, se propuso la opción de “pace and ablate” y, finalmente, se decidió nuevo intento de ablación mediante energía de campos pulsados (pulsed-field ablation: PFA) o electroporación, que se realizó en agosto de 2024 y logró reversión a ritmo sinusal (RS). Actualmente, la paciente se encuentra asintomática, en RS y está en tratamiento con Sotalol 40 mg cada 12 horas para reducir las probabilidades de recidiva.
II CLINIC CONTEST NAVARRA En Fibrilación Auricular, Tromboembolismo Venoso asociado al Cáncer y Control de Dislipemia con Terapia Oral en el ámbito sanitario de Navarra Fibrilación auricular
El caso descrito pone de manifiesto la indicación de nivel de evidencia IA de la ablación con catéter de VVPP como estrategia de control del ritmo, en pacientes con FA paroxística o persistente resistente o intolerante al tratamiento con fármacos antiarrítmicos de clase I o III con el objetivo de reducir los síntomas, la recurrencia y la progresión de la FA.
Debido a los tres fracasos de las ablaciones efectuadas, se planteó la terapia de ablación del nodo auriculoventricular (NAV) e implantación de marcapasos a nivel ventricular derecho, biventricular o del sistema de conducción (haz de His o rama izquierda), conocida como “pace and ablate”, puesto que está indicada en caso de fracaso de ablación en FA permanente sintomática y ha demostrado que reduce la mortalidad cardiovascular, las hospitalizaciones y las recurrencias de FA. Sin embargo, dados los posibles riesgos asociados, como la miocardiopatía inducida por marcapasos secundaria a disincronía ventricular producida por estimulación apical derecha, las complicaciones relacionadas con el dispositivo (disfunción e infección) y la muerte súbita en relación con la prolongación del intervalo QT, finalmente, se optó por un nuevo intento de ablación mediante PFA o electroporación. Este procedimiento constituye una alternativa eficaz y segura a la ablación realizada mediante energías térmicas, como la crioablación o la radiofrecuencia. De manera que se ha implementado en la práctica clínica diaria. Su eficacia en la tasa de aislamiento de VVPP y su efectividad clínica a medio plazo comparada con las energías térmicas ha sido similar en los ensayos clínicos aleatorizados realizados. A pesar de presentar tiempos de procedimiento y de laboratorio de catéter más cortos que los procedimientos térmicos, la electroporación es considerablemente más costosa debido al coste más elevado del equipo.
ABLACIÓN DE VENAS PULMONARES MEDIANTE ELECTROPORACIÓN PARA EL CONTROL DEL RITMO EN LA FIBRILACIÓN AURICULAR PERMANENTE: A LA CUARTA VA LA VENCIDA
María Del Carmen Santisteban Alonso, Paola Herrero González y Ana Smith López
1. Van Gelder IC et al. 2024 ESC Guidelines for the management of atrial fibrillation developed in collaboration with the European Association for Cardio-Thoracic Surgery (EACTS): Developed by the task force for the management of atrial fibrillation of the European Society of Cardiology (ESC), with the special contribution of the European Heart Rhythm Association (EHRA) of the ESC. Eur Heart J. 2024;45(26):3314-3414.
2. Tung R, Burri H. Role of conduction system pacing in ablate and pace strategies for atrial fibrillation. Eur Heart J Suppl. 2023;25(Suppl G):56-62.
3. Kueffer T, Stettler R, Maurhofer J, Madaffari A, Stefanova A, Iqbal SUR, Thalmann G, Kozhuharov NA, Galuszka O, Servatius H, Haeberlin A, Noti F, Tanner H, Roten L, Reichlin T. Pulsed-field vs cryoballoon vs radiofrequency ablation: Outcomes after pulmonary vein isolation in patients with persistent atrial fibrillation. Heart Rhythm. 2024;21(8):12271235.
4. Lemoine MD, Obergassel J, Jaeckle S, Nies M, Taraba S, Mencke C, Rieß J, My I, Rottner L, Moser F, Ismaili D, Reißmann B, Ouyang F, Kirchhof P, Rillig A, Metzner A. Pulsed-field- vs. cryoballoon-based pulmonary vein isolation: lessons from repeat procedures. Europace. 2024;26(9): 221.
5. Calvert P, Mills MT, Xydis P, Essa H, Ding WY, Koniari I, Farinha JM, Harding M, Mahida S, Snowdon R, Waktare J, Borbas Z, Modi S, Todd D, Ashrafi R, Luther V, Gupta D. Cost, efficiency, and outcomes of pulsed field ablation vs thermal ablation for atrial fibrillation: A real-world study. Heart Rhythm. 2024 Sep;21(9):1537-1544.
II CLINIC CONTEST NAVARRA En Fibrilación Auricular, Tromboembolismo Venoso asociado al Cáncer y Control de Dislipemia con Terapia Oral en el ámbito sanitario de Navarra
CASOS PRESENTADOS
NO FINALISTAS
Paola Herrero González.
MIR. Medicina Familiar y Comunitaria. Ana Smith López.
MIR. Medicina Familiar y Comunitaria.
María del Carmen Santisteban Alonso.
MIR. Medicina Familiar y Comunitaria.
Centro de Salud Iturrama/Hospital
Universitario de Navarra (HUN).

Paola Herrero González, Ana Smith López y María Del Carmen Santisteban Alonso
Mujer de 78 años, con antecedentes personales de interés de:
■ Leucemia linfática crónica con trasplante alogénico y remisión completa (2001).
■ Síndrome mielodisplásico de bajo riesgo con citopenias leves (2010).
■ Fibrilación auricular (FA) paroxística sin cardiopatía estructural (2007) anticoagulada con Apixabán 2.5 mg/12h (2018). Actualmente CHADSVA 3 puntos (Mujer, >75 años).
■ Hemorragia digestiva baja (HDB) de repetición, en contexto de tratamiento crónico con anticoagulación oral (ACO), que ha requerido múltiples ingresos hospitalarios:
- Primer ingreso (02/2018): HDB en relación con Angiodisplasia colon fulgurada.
- Segundo ingreso (04/2024): Hemorragia digestiva alta (HDA) exteriorizada en forma de melenas con anemización secundaria, que requirió trasfusión de un concentrado de hematíes.
- Tercer ingreso (09/2024): HDB de origen secundario a divertículos en yeyuno.
■ Anemia microcítica crónica, en tratamiento con hierro oral 100 mg/24 h. Última hemoglobina 10.1 g/dl, tras último ingreso (Octubre/2024).
Acude a consulta de Atención Primaria (AP) por rectorragia en Febrero de 2025. Refiere 3 episodios al día de deposición con sangre roja brillante de poca cuantía, de 4 días de evolución, con disminución progresiva de la cantidad de sangrado. Asocia astenia, no refiere mareo ni síncope. No dolor abdominal asociado. No clínica urinaria. Buena tolerancia a la vía oral. No dolor torácico ni disnea. No otra clínica de alarma. Afebril. Niega consumo de antiinflamatorios. Última toma de ACO (Apixabán 2.5 mg) la noche anterior.
En exploración física destaca tacto rectal con dedil manchado con escasos restos hemáticos. Mantiene estabilidad hemodinámica. Resto de exploración anodina.
Se solicita analítica sanguínea (AS) urgente, donde destaca anemia macrocítica con Hb 9.5 g/dl (previa 10.1g/dl), Plaquetas 66x10^9/L, Urea 55mg/dl, Cr 0.68mg/dl, FG 84mL/min/1,73m2. Dada la cronicidad del
II CLINIC CONTEST NAVARRA En Fibrilación Auricular, Tromboembolismo Venoso asociado al Cáncer y Control de Dislipemia con Terapia Oral en el ámbito sanitario de Navarra Fibrilación auricular
cuadro, la estabilidad hemodinámica y la ausencia de datos de alarma, se realiza interconsulta (IC) con Digestivo y Hematología para valorar actitud a seguir. Finalmente, se decide suspender ACO e iniciar enoxaparina 60mg/24h. Se acuerda seguimiento ambulatorio en AP junto a Digestivo y Hematología. Se realiza control evolutivo estrecho con resolución completa del cuadro.
Tras reintroducir ACO a los 15 días, presenta nuevo episodio de melenas con anemización secundaria (Hb 7,1mg/dl) por lo que se decide derivar a Urgencias para ingreso en Digestivo para manejo.
Pruebas complementarias:
■ Gastroscopia: Gastritis crónica. Pólipos gástricos.
■ Colonoscopia: Angiodisplasias en colon ascendente y sigma que se fulguran.
■ Cápsula endoscópica: Divertículos aislados en tramos proximales, sin estigmas de sangrado en mucosa de intestino delgado visualizado.
■ Electrocardiograma: Ritmo sinusal a 65 lpm, eje a +60º, voltajes normales, sin alteraciones de la repolarización. PR normal y QRS estrecho.
■ Ecocardiograma: Función sistólica biventricular normal. No valvulopatías.
EVOLUCIÓN
Durante el ingreso se transfunden dos concentrados de hematíes y se administra Octaplex para revertir anticoagulación. Se realiza IC con Cardiología para valorar cierre de la orejuela izquierda (LAA) como alternativa al tratamiento. Tras valoración multidisciplinar entre servicio de Digestivo, Hematología y Cardiología, se decide realizar cateterismo cardiaco para cierre de LAA.
Previa profilaxis antibiótica y bajo anestesia general, se realiza cierre de LAA con acceso vía venosa femoral derecha y arteria radial derecha, con implante de Amulet® 25mm. El procedimiento cursa sin incidencias y posteriormente se realiza control de ecocardiograma transesofágico intraoperatorio. Durante su ingreso en planta, el paciente presenta buena evolución y ante ausencia de complicaciones es dado de alta.
Paola Herrero González, Ana Smith López y María Del Carmen Santisteban Alonso
La FA es la arritmia más prevalente a nivel mundial y afecta a más de 50 millones de personas. Además se estima un aumento de estas cifras en los próximos años. Por todo esto, supone una elevada carga asistencial y económica ya que se considera un importante factor de riesgo tromboembólico.
Este caso propone valorar el cierre de LAA como alternativa para los pacientes que tienen FA y presentan complicaciones hemorrágicas secundarias a las terapias anticoagulantes. Ya que LAA es el principal factor intracardíaco para la formación de trombos en pacientes con FA (1).
El cierre de orejuela es un procedimiento efectivo utilizado para prevenir eventos tromboembólicos en los pacientes con fibrilación auricular (FA) que tienen contraindicaciones para la anticoagulación a largo plazo.
Existen estudios que demuestran la no inferioridad en la prevención de eventos trombóticos relacionados con la FA (2), comparando el cierre de LAA con la ACO (3).
Según las guías europeas 2020 (4), con indicación clase IIB y nivel de evidencia B, los principales candidatos que se beneficiarían son los pacientes con FA no valvular que tienen un alto riesgo de ictus y que no pueden recibir tratamiento anticoagulante debido a riesgos de sangrado o que presenten alguna contraindicación absoluta para la ACO, entre las cuales destacan antecedentes de hemorragia intracraneal o gastrointestinal significativa, asi como enfermedad renal crónica avanzada.
Entre las complicaciones más frecuentes se mencionan el taponamiento cardiaco y trombosis relacionada con el dispositivo, aunque estos están presentes en un número reducido de casos.
II CLINIC CONTEST NAVARRA En Fibrilación Auricular, Tromboembolismo Venoso asociado al Cáncer y Control de Dislipemia con Terapia Oral en el ámbito sanitario de Navarra Fibrilación auricular
1. Landmesser U, Skurk C, Tzikas A, Falk V, Reddy VY, Windecker S. Left atrial appendage closure for stroke prevention in atrial fibrillation: current status and perspectives. Eur Heart J. 2024 Aug 21;45(32):2914-2932. doi: 10.1093/eurheartj/ehae398. PMID: 39027946; PMCID: PMC11335376.
2. Osmancik, Pavel et al. “Left Atrial Appendage Closure Versus Direct Oral Anticoagulants in High-Risk Patients With Atrial Fibrillation.” Journal of the American College of Cardiology vol. 75,25 (2020): 3122-3135. doi: 10.1016/j.jacc.2020.04.067.
3. Ruff CT, Giugliano RP, Braunwald E, et al. Comparison of the efficacy and safety of new oral anticoagulants with warfarin in patients with atrial fibrillation: a meta-analysis of randomised trials. Lancet. 2014; 383:955962.
4. Hindricks G et al. Guía ESC 2020 sobre el diagnóstico y tratamiento de la fibrilación auricular, desarrollada en colaboración de la European Association for Cardio-Thoracic Surgery (EACTS). Rev Esp Cardiol.2021; 74(5): 437.e1-e116.
II CLINIC CONTEST NAVARRA En Fibrilación Auricular, Tromboembolismo Venoso asociado al Cáncer y Control de Dislipemia con Terapia Oral en el ámbito sanitario de Navarra
CASOS PRESENTADOS
NO FINALISTAS
Jana Millán Bernal.
MIR. Medicina Familiar y Comunitaria.
Blanca López De Jaime.
MIR. Medicina Familiar y Comunitaria.
Centro de Salud Aranguren.

NAVARRA En Fibrilación Auricular, Tromboembolismo Venoso asociado al Cáncer y Control de Dislipemia con Terapia Oral en el ámbito sanitario de Navarra Fibrilación auricular
Paciente de 59 años, sin antecedentes personales de interés, que acudió a Urgencias por cuadro de gastroenteritis aguda (GEA), presentando en dos ocasiones pérdida de conocimiento de segundos de duración. Ambiente epidémico familiar (GEA en esposa).
■ Exploración física: Destaca cierto grado de deshidratación; resto sin hallazgos.
■ E.C.G: Ritmo sinusal a 60 latidos por minuto (lpm), eje cardiaco normal, no alteraciones de la repolarización.
En Urgencias presenta un nuevo síncope con cortejo vegetativo, de segundos de duración con recuperación al colocar posición trendelemburg. Ingresa en observación, cursa sin incidencias, inicia tolerancia oral y es dado de alta con diagnóstico de síncopes vasovagales en contexto de gastroenteritis aguda.
Tras alta su médico de Atención Primaria (MAP), realiza interconsulta (IC) a Cardiología. El paciente es valorado y diagnosticado de síncopes sugestivos de origen vasovagal.
Se realiza interconsulta a Neurología, tras cuya valoración, con anamnesis dirigida, no hay datos concluyentes de comicialidad, ni datos focales. Emitiendo juicio clínico de síncopes vasovagales e indicando seguimiento por su MAP.
7 años después, teniendo el paciente 65 años de edad y ningún factor de riesgo cardiovascular, acudió de nuevo a Urgencias. Había presentado algún otro síncope aislado durante estos años por los que había consultado en Atención Primaria (AP).
EL motivo de esta nueva consulta en Urgencias es un episodio de pérdida de conocimiento, con pródromos previos que consisten en mareo, palidez cutánea y visión borrosa, con resolución espontánea pocos segundos después. Tras el cual presenta malestar general, náuseas y vómitos de repetición. No movimientos involuntarios de extremidades, no mordedura de lengua, no alteración de esfínteres, no periodo confusional posterior. No cefalea, ni otra focalidad neurológica grosera asociada. No tos, ni expectoración. No dolor torácico, opresión, ni palpitaciones. No disnea, no ortopnea. No edemas en EEII, ni tampoco datos clínicos sugestivos de TVP. No dolor abdominal. No alteración del ritmo ni consistencia deposicional. No síndrome miccional. No otra clínica acompañante.
■ Constantes: Presión arterial: 95/55 mm Hg. Pulso: 55 x’. Sat. O2: 95%. FiO2: 21%
Jana Millán Bernal y Blanca López De Jaime
■ E.C.G: Bradicardia sinusal a 54 lpm, no alteraciones de la repolarización, PR normal, QRS estrecho.
Durante su espera para la realización de pruebas complementarias en Urgencias, presenta un nuevo episodio con intensa clínica vegetativa asociada, por lo que es trasladado a la sala de reanimación para monitorización continua. Posteriormente, durante el traslado a realización de tomografía computarizada para descartar tromboembolismo pulmonar (TC TEP), también monitorizado, el paciente pierde bruscamente la conciencia y comienza con náuseas y vómitos biliosos. Es entonces cuando, en el monitor portátil, se objetiva asistolia de 20 segundos de duración, continuada por QRS aislados de morfología normal, que aumentan su frecuencia progresivamente hasta alcanzar su frecuencia cardiaca habitual, aunque permaneciendo vagal durante varios minutos. Se realiza la prueba complementaria sin incidencias y durante el traslado de nuevo a reanimación el paciente presenta episodio clínicamente similar, registrándose asistolia de 10 segundos, tras lo cual presenta episodio de pérdida de consciencia con mirada fija hacia arriba, náuseas y vómitos; se coloca perfusión de Aleudrina, pero antes de comenzar a perfundir aparecen en pantalla complejos QRS de morfología normal de frecuencia progresiva hasta estabilizarse en 54 lpm. Persiste varios minutos con síntomas vagales.
Se consulta con Cardióloga de guardia que decide ingreso en planta de hospitalización con monitorización con impresión diagnóstica de síncopes recurrentes de perfil vasovagal con respuesta cardioinhibitoria probablemente predominante con BAV completo objetivado (> a 6s).
Durante el ingreso se propone implante de marcapasos DDD, ST Jude. En monitorización telemétrica se observa que el paciente se encuentra en fibrilación auricular (FA). Ese mismo día está programada la implantación de marcapasos. Al volver, el paciente persiste en FA. Se administra 150 mg de Flecainida endovenoso, al cabo de una media hora presenta cuadro vagal con hipotensión marcada 50 mmHg coincidiendo con paso a sinusal, sin síncope asociado como en otras ocasiones. Recupera en Trendelemburg. No se inicia anticoagulación en ese momento (CHADS-VASc 1).
En consulta de revisión de Cardiología: Marcapasos normofuncionante. Presenta FA a 66 lpm en la revisión y el marcapasos informa que ha presentado la arritmia desde enero del 2021. Se solicita a su médico de Atención Primaria que valore pertinencia de tratamiento anticoagulante.
II CLINIC CONTEST NAVARRA En Fibrilación Auricular, Tromboembolismo Venoso asociado al Cáncer y Control de Dislipemia con Terapia Oral en el ámbito sanitario de Navarra Fibrilación auricular
Consulta AP: No cumple criterios para anticoagulación oral (CHADS-VASc 1). Se realiza ecocardioscopia.
Ecocardioscopia: Fracción de eyección normal, crecimiento Aurícula Derecha, válvula aórtica fibrosada, datos de insuficiencia mitral moderada y posible hipertrofia de ventrículo izquierdo.
Ante los hallazgos ecográficos, se inicia anticoagulación con sintrom y se realiza nueva interconsulta a Cardiología.
Se confirma y diagnostica Cardiopatía Valvular: Insuficiencia mitral moderada (II-III/IV), Insuficiencia aórtica leve-moderada, FVI conservada. PSAP normal, FA permanente. El paciente inicia tratamiento con Bisoprolol 2.5 mg cada 24h manteniendo anticoagulación y revisión en 1 año.
En resumen, este caso ilustra la complejidad de manejar pacientes con síncopes recurrentes y la importancia de un enfoque multidisciplinario, que incluya tanto Atención Primaria como Cardiología.
La evolución del paciente, desde episodios vasovagales hasta la detección de fibrilación auricular y la necesidad de implante de marcapasos, destaca cómo las patologías cardíacas y no cardíacas pueden interactuar y complicar el diagnóstico y tratamiento. Además, resalta la relevancia de realizar un seguimiento cuidadoso, ajustar terapias y coordinar esfuerzos entre diferentes niveles asistenciales para garantizar una atención integral y personalizada.
En definitiva, este caso nos recuerda que una evaluación exhaustiva y un enfoque colaborativo son clave para mejorar la calidad de vida de nuestros pacientes y prevenir complicaciones mayores.
Según la guía ESC 2024 sobre el diagnóstico y tratamiento de la fibrilación auricular, se subraya especialmente el protocolo asistencial AF-CARE (1. Anticoagulación, 2. Frecuencia y ritmo, 3. Cardiopatía y comorbilidades, 4. Anticoagulación optimizada, 5. Reducción de eventos) promoviendo la colaboración multidisciplinaria centrada en el paciente.
En cuanto a anticoagulación destaca la optimización como ajuste de la anticoagulación a las características del paciente, mejorando la adherencia.
La presencia de un marcapasos no elimina la necesidad de anticoagulación en pacientes con FA. La decisión de iniciar o mantener la terapia debe basarse en la evaluación del riesgo tromboembólico según escalas como CHA2DS-VASc, independientemente de la presencia del dispositivo.
Jana Millán Bernal y Blanca López De Jaime
1. Hindricks G, Potpara T, Drages N, Arbelo E, Bax JJ, Blomström-Lundqvist C, et al. 2024 ESC Guidelines for de management of atrial fibrillation developed in collaboration with the European Heart Rhythm Association (EHRA) of the ESC. Eur Heart J. 2024;45(20):1471-1631.
2. Grupo de trabajo de la SEC para la guía ESC 2024 sobre fibrilación auricular y Comité de Guías de la SEC. Comentarios a la guía ESC 2024 sobre el diagnóstico y tratamiento de la fibrilación auricular. Rev Esp Cardiol. 2025;78 (4):249-55.

II CLINIC CONTEST NAVARRA En Fibrilación Auricular, Tromboembolismo Venoso asociado al Cáncer y Control de Dislipemia con Terapia Oral en el ámbito sanitario de Navarra Fibrilación auricular

II CLINIC CONTEST NAVARRA En Fibrilación Auricular, Tromboembolismo Venoso asociado al Cáncer y Control de Dislipemia con Terapia Oral en el ámbito sanitario de Navarra
CASOS PRESENTADOS
NO FINALISTAS
Ana María Álvarez Aramburu.
Medicina Interna.
Blanca López De Jaime.
Medicina Interna.
Laura Aparicio Cordero.
Medicina Interna.
Hospital Universitario de Navarra (HUN).

II CLINIC CONTEST NAVARRA En Fibrilación Auricular, Tromboembolismo Venoso asociado al Cáncer y Control de Dislipemia con Terapia Oral en el ámbito sanitario de Navarra Fibrilación auricular
Mujer de 86 años, con antecedentes personales a destacar de obesidad grado 2, hipertensión arterial esencial, diabetes mellitus tipo 2, bloqueo aurículo-ventricular de 1º grado, linfocitosis B monoclonal y una disnea de esfuerzo que había sido estudiada recientemente con un ecocardiograma transtorácico y unas pruebas de función respiratoria sin alteraciones significativas. Independiente para actividades básicas e instrumentales de la vida diaria y con funciones intelectuales superiores conservadas.
Ingresa inicialmente en planta de hospitalización convencional por un cuadro compatible con insuficiencia cardiaca congestiva e insuficiencia respiratoria aguda parcial secundaria. Durante su estancia en planta, la paciente presenta un episodio autolimitado de palpitaciones por la noche, de minutos de duración que, en el momento de realizar el electrocardiograma (ECG), ya había cedido por lo que no se llegó a hacer. Posteriormente se traslada a Hospitalización a Domicilio para continuar con tratamiento deplectivo endovenoso y oxigenoterapia.
Estando ya en domicilio presenta un nuevo episodio de palpitaciones, por el que avisa y se acude a realizar ECG, que en ese momento se encuentra en ritmo sinusal. Se reinterroga a la paciente, quien refiere episodios similares previos al ingreso desde hace varios meses, por lo que se ha realizado ECG en múltiples ocasiones sin objetivar alteraciones significativas y se han interpretado como en contexto de ansiedad, indicándole tomar alprazolam, con lo que refiere la paciente que cedían. Tras revisar historia y ECG previos que confirman esta información, dada la edad y la pluripatología, se decide colocar un holter-ECG de 3 días. Se recibe informe del registro del primer día, en el que se informa de ritmo sinusal con extrasístoles supraventriculares frecuentes y, a la espera del informe del segundo día, la paciente precisa valoración por un episodio de pérdida de consciencia de 5 minutos de duración, con recuperación espontánea, previo al que refería palpitaciones de 1 hora de duración, y ECG en el momento de la valoración en ritmo sinusal. Se recibe informe del segundo día en el que se informa episodio de fibrilación auricular (FA) paroxística de 1 hora y 27 minutos coincidente con la sintomatología referida por la paciente. La paciente es diagnosticada de fibrilación auricular paroxística, se calcula escala de riesgo trombótico CHA₂DS₂-VA con una puntuación de 5 puntos y se inicia anticoagulación terapéutica con Apixaban. Se realiza además
Ana María Álvarez Aramburu, Andrea Macua Landivar y Laura Aparicio Cordero
ajuste de dosis de Bisoprolol para intentar control sintomático, que se ve parcialmente limitado por frecuencia cardiaca en torno a 50 lpm entre episodios de fibrilación auricular. La paciente evoluciona favorablemente de los signos y síntomas de congestión y finalmente es dada de alta, pendiente de revisión ambulatoria.
Este caso presenta una mujer de edad avanzada, con importante comorbilidad crónica, pero independiente y con buena calidad de vida, a la que se le diagnostica una FA paroxística de manera más o menos incidental en el contexto de un primer episodio de descompensación de insuficiencia cardiaca. La aparición de palpitaciones autolimitadas durante su estancia hospitalaria, y posteriormente en su domicilio, junto con un episodio sincopal, representa un patrón clínico clásico de presentación de arritmias supraventriculares en adultos mayores. El hecho de que en los ECG previos estuviera en ritmo sinusal, resalta la importancia de herramientas diagnósticas prolongadas como el Holter de varios días que, en este caso, permitió evidenciar un episodio de fibrilación auricular coincidente con la sintomatología, que hasta ese momento no se conocía.
Desde el punto de vista diagnóstico, la fibrilación auricular en esta paciente puede tener un origen multifactorial. La edad avanzada, las comorbilidades de la paciente como la obesidad y la diabetes mellitus que pueden favorecer el remodelado auricular, las alteraciones ecocardiográficas secundarias a la hipertensión arterial como la hipertrofia ventricular izquierda y la disfunción sistólica, así como la propia insuficiencia cardiaca, son factores predisponentes para esta arritmia. Cabe destacar que, en nuestro caso, el hecho de que la paciente presentase disnea de esfuerzo habitual previo al ingreso, sin haberse detectado alteraciones significativas en los estudios realizados, sugiere una posible contribución a esta clínica de la fibrilación auricular paroxística.
Las implicaciones pronósticas de este diagnóstico son múltiples, tanto a corto como a largo plazo. En primer lugar, la FA se asocia con un aumento significativo del riesgo de accidente cerebrovascular isquémico. Este riesgo existe incluso en episodios breves, lo que ha llevado a considerar la anticoagulación terapéutica desde el primer episodio documentado en paciente con alto riesgo trombótico, como sería el caso de nuestra paciente. En segundo lugar, la FA se asocia
II CLINIC CONTEST NAVARRA En Fibrilación Auricular, Tromboembolismo Venoso asociado al Cáncer y Control de Dislipemia con Terapia Oral en el ámbito sanitario de Navarra Fibrilación auricular
con un peor pronóstico y un aumento de la mortalidad por todas las causas y la mortalidad cardiovascular, debido a su asociación con insuficiencia cardiaca, deterioro funcional progresivo y hospitalizaciones frecuentes. En tercer y último lugar, desde el punto de vista funcional, la FA puede ocasionar un declive en cualquier paciente, que puede ser muy significativo en aquellos de mayor edad y con mayor pluripatología como en este caso. Además, los episodios de síncope pueden ser indicativos de pausas bradicárdicas asociadas o disfunción del nodo sinusal subyacente, escenario particularmente preocupante en personas mayores, en quienes las caídas pueden tener consecuencias graves como fracturas, pérdida de autonomía, etc.
El manejo terapéutico en este caso se centra, por un lado, en la valoración de la indicación de inicio de anticoagulación, que dado el elevado riesgo tromboembólico de nuestra paciente, con una puntuación de 5 puntos en la escala de CHA₂DS₂-VA, y la ausencia de contraindicaciones, estaría claramente recomendado. Además, la elección de Apixaban como anticoagulante de acción directa se alinea con las recomendaciones de las guías actuales, dado su buen perfil de seguridad, especialmente en población anciana y con riesgo de sangrado. Por otro lado, desde el punto de vista del control del ritmo y la frecuencia, se opta por una estrategia de control de frecuencia y con esto de la sintomatología, con Bisoprolol. Esta decisión se basa en diversos factores clínicos relevantes relacionados con la paciente, como la edad avanzada, las comorbilidades asociadas, la tolerancia sintomática y el riesgo de bradiarritmias. En este tipo de pacientes, la estrategia de control de la frecuencia ha demostrado no ser inferior en términos de mortalidad o eventos mayores comparada con el control de ritmo, y suele ser más segura y sencilla de manejar. Cabe destacar que esta cuestión se vio limitada por la bradicardia sinusal entre episodios de FA, lo que probablemente en el futuro haga necesario plantear otras opciones de tratamiento.
En conclusión, este caso destaca la importancia de una valoración integral del paciente pluripatológico con síntomas como palpitaciones o síncope, así como la utilidad de herramientas diagnósticas prolongadas y la necesidad de una estrategia terapéutica individualizada, que permita optimizar el manejo y mejorar el pronóstico de este tipo de pacientes.
María Álvarez Aramburu, Andrea Macua Landivar y Laura Aparicio Cordero
1. Joglar, José A et al. “2023 ACC/AHA/ACCP/HRS Guideline for the Diagnosis and Management of Atrial Fibrillation: A Report of the American College of Cardiology/American Heart Association Joint Committee on Clinical Practice Guidelines.” Circulation vol. 149,1 (2024): e1-e156. doi:10.1161/ CIR.0000000000001193.
2. Ko, Darae et al. “Atrial Fibrillation: A Review.” JAMA vol. 333,4 (2025): 329342. doi:10.1001/jama.2024.22451.
3. Aronow, Wilbert S. “Management of the older person with atrial fibrillation.” The journals of gerontology. Series A, Biological sciences and medical sciences vol. 57,6 (2002): M352-63. doi:10.1093/gerona/57.6.m352.
4. Volgman, Annabelle Santos et al. “Management of Atrial Fibrillation in Patients 75 Years and Older: JACC State-of-the-Art Review.” Journal of the American College of Cardiology vol. 79,2 (2022): 166-179. doi:10.1016/j. jacc.2021.10.037.
5. Chyou, Janice Y et al. “Atrial Fibrillation Occurring During Acute Hospitalization: A Scientific Statement From the American Heart Association.” Circulation vol. 147,15 (2023): e676-e698. doi:10.1161/ CIR.0000000000001133.
II CLINIC CONTEST NAVARRA En Fibrilación Auricular, Tromboembolismo Venoso asociado al Cáncer y Control de Dislipemia con Terapia Oral en el ámbito sanitario de Navarra
CASOS PRESENTADOS
NO FINALISTAS
Amaia Loyola Arrieta.
MIR. Cardiología.
Maite Odriozola Garmendia.
MIR. Análisis Clínicos.
Marina Virosta Gil.
MIR. Cardiología.
Hospital Universitario de Navarra (HUN).

Amaia Loyola Arrieta, Maite Odriozola Garmendia y Marina Virosta Gil
Mujer de 80 años.
Antecedentes a destacar:
■ Factores de riesgo cardiovascular: hipertensión, dislipemia sin tratamiento farmacológico.
■ Hipotiroidismo en tratamiento sustitutivo.
■ Asma bronquial bien controlada con tratamiento broncodilatador.
■ Fibrilación auricular (FA) paroxística desde 2020, sin cardiopatía estructural. Anticoagulada de forma crónica, inicialmente con Acenocumarol, que posteriormente se cambió a Rivaroxaban 20 mg 0-1-0 por mal control de INR.
■ En 2021, Ictus isquémico de la arteria cerebral media (ACM) derecha de etiología cardioembólica en paciente con ACOD (Rivaroxaban 20 mg 0-1-0). Se cambió anticoagulación a Dabigatrán etexilato 150 mg 1-0-1.
■ En el seguimiento presenta epistaxis anterior izquierda de área de Kiesselbach, por lo que se decide cambio de Dabiagtrán a Edoxaban 60 mg 0-1-0.
HISTORIA ACTUAL
Estando previamente asintomática, acude al servicio de Urgencias por alteración del lenguaje (dificultad para evocar palabras). Dado que la paciente vive sola, no se sabe el tiempo de evolución, si bien el hijo refiere que habló con ella por última vez hace 36 horas. La paciente refiere que inicialmente ha presentado dificultad para ver y posteriormente ha desarrollado dificultad para la emisión y comprensión del lenguaje.
Exploración física:
Auscultación cardiaca rítmica sin ruidos patológicos. Auscultación pulmonar sin alteraciones patológicas significativas. En la exploración neurológica se objetiva hemianopsia derecha, afasia mixta de predominio sensitivo. Asimetría facial leve derecha. NIHSS: 6
Pruebas complementarias:
TAC-craneal: Oclusión de la ACM 2 izquierda con área de penumbra significativa. Ejes carotideos permeables. Resto de vasos intracraneales permeables. Sin signos de estenosis ni oclusiones en el sistema vertebrobasilar (Figura 1).
II CLINIC CONTEST NAVARRA En Fibrilación Auricular, Tromboembolismo Venoso asociado al Cáncer y Control de Dislipemia con Terapia Oral en el ámbito sanitario de Navarra Fibrilación auricular
Durante su estancia en Urgencias, la paciente presenta mejoría espontánea hasta NIHSS: 1-0 (por afasia motora leve) por lo que no se propone tratamiento revascularizador en fase aguda. Se solicita valoración por Hematología, quienes cambian Edoxaban por Apixaban.
Durante su ingreso en Unidad de Ictus se mantiene estable y afebril, en ritmo de FA conocida con tendencia a taquicardia y tras comprobar estabilidad clínica es dada de alta.
Ante embolizaciones cerebrales recurrentes, a pesar de correcta anticoagulación, se presenta el caso en comité de Cardiología-Neurología-Hematología considerándose a la paciente candidata a cierre percutáneo de orejuela (COI), manteniendo posteriormente tratamiento anticoagulante. Para ello, se completa estudio con:
■ Ecocardiograma transesofágico: Orejuela dilatada en manga de viento con ecocontraste severo con datos favorables para cierre (Boca: 23x21mm, área 439cm2, perimetro:76mm; Landing 16x17mm, área: 260mm2, perímetro: 59mm). Distancia a Circunfleja 7mm y a mitral >4mm. Función biventricular conservada. (Figura 2)
Una vez completado el estudio se explica a la paciente el procedimiento y su idoneidad, dada la historia y la anatomía objetivada. La paciente acepta.
El estudio preoperatorio se realiza de forma ambulatoria por el servicio de Anestesia y, de manera programada, se procede a COI. El procedimiento se realiza percutáneamente bajo anestesia general y guiado con ecocardiografía transesofágica con dispositivo Watchman®Fx 24 con éxito (Figura 3). Tras comprobar con controles ecocardiográficos normoposición del dispositivo y ausencia de complicaciones mecánicas es dada de alta.
La fibrilación auricular (FA) constituye la arritmia más prevalente en la práctica clínica, y se asocia con un incremento significativo en el riesgo de eventos embólicos, siendo el accidente cerebrovascular (ACV) isquémico su manifestación más grave. El origen de los émbolos suele localizarse en la orejuela auricular izquierda y el riesgo de embolia es independiente a su patrón temporal (paroxística, persistente o permanente).
Amaia Loyola Arrieta, Maite Odriozola Garmendia y Marina Virosta Gil
La implementación de terapias anticoagulantes, en conjunto con una adecuada estratificación del riesgo tromboembólico y hemorrágico, ha permitido una reducción sustancial de la incidencia de estas complicaciones. En este contexto, las guías clínicas actualizadas en 2024 recomiendan el empleo de la escala CHA₂DS₂-VA para la evaluación del riesgo embólico. Esta herramienta asigna un punto por la presencia de insuficiencia cardíaca o disfunción ventricular izquierda, hipertensión arterial, diabetes mellitus, enfermedad vascular (coronaria, carotidea, periférica o aórtica), y edad entre 65 y 74 años; y dos puntos en casos de edad ≥75 años o antecedentes de ACV o accidente isquémico transitorio. Se establece como indicación de anticoagulación una puntuación ≥2 (recomendación clase I-C), siendo también razonable considerarla en pacientes con un puntaje de 1 y bajo riesgo hemorrágico (recomendación clase IIa-C).
El tratamiento anticoagulante de elección incluye antagonistas de la vitamina K (AVK) o anticoagulantes orales de acción directa (ACOD). No obstante, en pacientes que desarrollan eventos embólicos recurrentes o presentan complicaciones hemorrágicas relevantes, a pesar de un tratamiento anticoagulante adecuado, es necesario considerar estrategias terapéuticas alternativas.
En este marco, el COI ha emergido como una opción válida en determinados perfiles de pacientes. Este procedimiento tiene como objetivo la prevención del ACV isquémico en pacientes con FA no valvular y contraindicación o fallo del tratamiento anticoagulante. Las indicaciones actuales incluyen la presencia de hemorragias de repetición bajo anticoagulación óptima o eventos embólicos recurrentes en el contexto de una correcta adherencia al tratamiento. A pesar de la limitada evidencia disponible hasta la fecha, los estudios realizados han demostrado que el procedimiento es seguro y potencialmente eficaz en la reducción del riesgo embólico en esta población seleccionada.
Este caso pone en manifiesto la necesidad de una relación estrecha y comunicación fluida entre distintas especialidades para detectar aquellos pacientes que ingresan repetidamente en distintos departamentos para poder ofrecerles el mejor tratamiento.
II CLINIC CONTEST NAVARRA En Fibrilación Auricular, Tromboembolismo Venoso asociado al Cáncer y Control de Dislipemia con Terapia Oral en el ámbito sanitario de Navarra Fibrilación auricular
1. Sociedad Europea de Cardiología. Guía ESC 2024 sobre el diagnóstico y tratamiento de la fibrilación auricular. [Internet]. 2024 [citado 2025 May 4]. Disponible en: https://secardiologia.es/images/2024/Gu%C3%ADas/ Final_GPC_ESC_2024_Fibrilaci%CC%81n_auricular.pdf
2. Galloo X, Carmeliet T, Prihadi EA, Lochy S, Scott B, Verheye S, et al. Left atrial appendage occlusion in recurrent ischaemic stroke, a multicentre experience. Acta Clin Belg. 2022 Apr;77(2):255-260. doi: 10.1080/17843286.2020.1821494. PMID: 32951514.
3. Masjuan J, Salido L, DeFelipe A, Hernández-Antolín R, Fernández-Golfín C, Cruz-Culebras A, et al. Oral anticoagulation and left atrial appendage closure: a new strategy for recurrent cardioembolic stroke. Eur J Neurol. 2019 May;26 (5):816-820. doi: 10.1111/ene.13894. PMID: 30586229.

FIBRILACIÓIN AURICULAR Y PREVENCIÓN SECUNDARIA DEL ICTUS: CUANDO LA ANTICOAGULACIÓN NO ES SUFICIENTE


II CLINIC CONTEST NAVARRA En Fibrilación Auricular, Tromboembolismo Venoso asociado al Cáncer y Control de Dislipemia con Terapia Oral en el ámbito sanitario de Navarra Fibrilación auricular


II CLINIC CONTEST NAVARRA En Fibrilación Auricular, Tromboembolismo Venoso asociado al Cáncer y Control de Dislipemia con Terapia Oral en el ámbito sanitario de Navarra
CASOS PRESENTADOS
NO FINALISTAS
Marina Virosta Gil.
MIR. Cardiología.
Amaia Loyola Arrieta.
MIR. Cardiología.
Andoni Fernández González.
MIR. Cardiología.
Hospital Universitario de Navarra (HUN).

II CLINIC CONTEST NAVARRA En Fibrilación Auricular, Tromboembolismo Venoso asociado al Cáncer y Control de Dislipemia con Terapia Oral en el ámbito sanitario de Navarra Fibrilación auricular
Paciente de 70 años, que ingresa por trombosis protésica. Con antecedentes de hipertensión arterial y tabaquismo activo, con valvulopatía mixomatosa mitral y tricuspídea (enfermedad de Barlow), intervenida quirúrgicamente con recambio valvular mitral por prótesis mecánica y anuloplastia tricuspídea tres años antes. Con función biventricular conservada y la prótesis mostraba un funcionamiento normal.
En el postoperatorio inmediato se documentó fibrilación auricular, por lo que se inició anticoagulación con antagonistas de la vitamina K (AVK), con doble indicación: prevención de eventos embólicos por arritmia y por prótesis mecánica.
La evolución en los años posteriores a la cirugía estuvo marcada por la aparición de múltiples eventos embólicos, a pesar de una anticoagulación dentro de rangos terapéuticos. Un año después de la intervención presentó un infarto agudo de miocardio de probable origen embólico, con imagen sospechosa de trombosis protésica que no se modificó tras tratamiento con antagonistas de vitamina K (AVK) y antiagregación, sin confirmación posterior mediante tomografía computarizada (TC). Posteriormente, requirió ingreso en tres ocasiones por accidentes cerebrovasculares isquémicos transitorios, de probable etiología cardioembólica en el contexto de fibrilación auricular y prótesis mitral mecánica, sin evidencia de trombo protésico, auricular ni ventricular.
Durante el último ingreso previo al actual, se evidenció un deterioro de la función ventricular de etiología no isquémica, con disfunción sistólica severa (fracción de eyección del 32%) y un gran aneurisma apical, sin imágenes compatibles con trombo intracavitario ni trombosis protésica.
Durante el seguimiento ambulatorio, se solicitó ecocardiografía transesofágica (ETE), que mostró un ventrículo izquierdo ligeramente dilatado, con hipercontractilidad basal y función sistólica moderadamente deprimida. Se observó imagen sugestiva de trombo móvil sobre pannus sobre la prótesis mitral mecánica, con disminución de la movilidad del disco posterior, sin repercusión funcional (Figura 1). El resto de válvulas mostraban funcionalidad conservada, por lo que se indicó ingreso para inicio de anticoagulación parenteral y seguimiento evolutivo.
A su ingreso, la paciente se encontraba hemodinámicamente estable, en fibrilación auricular con tendencia a la taquicardia. Estaba
Marina Virosta Gil, Amaia Loyola Arrieta y Andoni Fernández González
asintomática desde el punto de vista cardiorrespiratorio, sin datos de insuficiencia cardíaca ni focalidad neurológica aparente. No se objetivaron signos de embolismo sistémico.
Pruebas complementarias
El electrocardiograma mostró fibrilación auricular con respuesta ventricular en torno a 90 latidos por minuto. La radiografía de tórax no evidenció patología pulmonar aguda. Los análisis de laboratorio (bioquímica, hemograma y coagulación) fueron normales. Se inició perfusión de heparina sódica con tiempos de APTT oscilantes y antiagregación con Ácido acetilsalicílico (AAS). La paciente permaneció asintomática, sin signos de insuficiencia cardíaca ni complicaciones hemorrágicas. El estudio de trombofilias fue negativo.
A las 24 horas del ingreso, se realizó una TC cardíaca que no mostró imágenes de trombo en la prótesis mitral, cavidades ventriculares ni en la orejuela izquierda. No obstante, ante la persistencia de la sospecha clínica, se repitió la ETE a las 72 horas, identificándose una imagen de trombo móvil de gran tamaño adherido al anillo protésico, sin interferencia en la funcionalidad valvular y con función biventricular conservada.
Ante estos hallazgos, y bajo sospecha de trombosis protésica recurrente con embolización sistémica, se decidió realizar un recambio de la prótesis mecánica mitral por una biológica y cierre quirúrgico de la orejuela izquierda.
Durante el postoperatorio, la paciente presentó episodios de fibrilación auricular rápida, que revirtieron a ritmo sinusal tras tratamiento con Amiodarona. Se decidió modificar el régimen antitrombótico a Warfarina asociada a Ácido acetilsalicílico, sin que se hayan registrado nuevos eventos tromboembólicos ni complicaciones hemorrágicas. Se documentó además mejoría progresiva de la función ventricular.
La trombosis protésica es una complicación grave cuya presentación clínica puede variar desde hallazgos incidentales hasta el shock cardiogénico. La localización mitral conlleva un riesgo tromboembólico aproximadamente doble al de la aórtica. En este caso,
II CLINIC CONTEST NAVARRA En Fibrilación Auricular, Tromboembolismo Venoso asociado al Cáncer y Control de Dislipemia con Terapia Oral en el ámbito sanitario de Navarra Fibrilación auricular
la coexistencia de valvulopatía mitral y fibrilación auricular complicó el manejo antitrombótico, a pesar de un INR dentro del rango terapéutico.
Este caso subraya la necesidad de mantener una alta sospecha clínica y realizar una evaluación ecocardiográfica precoz, especialmente mediante ETE. La TC puede aportar información útil en la diferenciación entre trombo y pannus.
Aunque la cirugía suele ser el tratamiento de elección en casos de trombosis valvular obstructiva, otras estrategias contempladas por las guías incluyen la anticoagulación parenteral y la trombólisis sistémica. Se están explorando nuevas alternativas terapéuticas, como el uso de anticoagulantes de acción directa en pacientes con bioprótesis, si bien su uso en prótesis mecánicas sigue siendo controvertido. La elección del tratamiento debe individualizarse, considerando el grado de obstrucción, el estado hemodinámico y las comorbilidades del paciente.
Este caso resalta la complejidad del manejo de pacientes con fibrilación auricular y prótesis valvulares, y pone de manifiesto la necesidad de estudios adicionales sobre el papel de nuevas estrategias antitrombóticas con fibrilación auricular y prótesis mecánicas.
BIBLIOGRAFÍA
1. Baumgartner H, Falk V, Bax JJ, et al. 2017 ESC/EACTS Guidelines for the Management of Valvular Heart Disease. Revista Española De Cardiología (English Edition). 2018;71(2):110. doi:10.1016/j.rec.2017.12.013.
2. Antón BD, Rodríguez-Roda J, Rodriguez-Rodrigo FJ. Trombosis bioprotésica mitral resuelta con dabigatrán. Revista Española De Cardiología. 2018;73(1):86. doi:10.1016/j.recesp.2018.09.014.
3. Aguilar-Molina OE, Prada-Escobar D, Gándara-Ricardo JA, Páramo HDA, Senior-Sánchez JM, Muñoz-Ortiz E. Trombosis valvular y terapia trombolítica en la era moderna: reporte de un caso. Archivos Peruanos De Cardiología Y Cirugía Cardiovascular. 2021;2(3):196-199. doi:10.47487/ apcyccv.v2i3.149.
EMBOLISMO RECURRENTE CON INR TERAPÉUTICO: ¿PUEDE FALLAR LO QUE PARECE FUNCIONAR?
Marina Virosta Gil, Amaia Loyola Arrieta y Andoni Fernández González

Figura 1: Ecocardiografía transesofágica al ingreso: Prótesis mecánica bidisco en posición mitral con imagen de trombo móvil sobre pannus de localización en anillo posterior del lado auricular.


Figura 2: Ecocardiograma tranesofágico con nueva imagen de trombosis protésica, tras realización de TAC cardiaco.
II CLINIC CONTEST NAVARRA En Fibrilación Auricular, Tromboembolismo Venoso asociado al Cáncer y Control de Dislipemia con Terapia Oral en el ámbito sanitario de Navarra
CASOS PRESENTADOS
NO FINALISTAS
Marta Lorente Escudero.
MIR. Geriatría. HUN.
María Del Carmen Santisteban Alonso.
MIR Medicina Familiar y Comunitaria.
Centro de Salud Iturrama.
Stephania Rodríguez Villeda.
MIR. Medicina del Trabajo.

Marta Lorente Escudero, María Del Carmen Santisteban Alonso y Stephania Rodríguez Villeda
Mujer de 86 años que acude al servicio de Urgencias, hasta en dos ocasiones, por episodios de palpitaciones y dolor centrotorácico opresivo asociados a disnea de mínimos esfuerzos de una semana de evolución.
La paciente presenta los siguientes antecedentes personales de interés:
■ Factores de riesgo cardiovascular: Hipertensión arterial y dislipemia en tratamiento farmacológico en prevención primaria.
■ Fibrilación auricular permanente desde 2021, anticoagulada con Apixaban 5 mg cada 12 horas.
■ Enfermedad renal crónica estadio G3 A2.
Es destacable su situación basal, realizada en función de la valoración geriátrica integral:
- A nivel funcional, presenta una dependencia moderada para las actividades básicas (índice de Barthel 50/100) e instrumentales (índice de Lawton 3/8) de la vida diaria. Escasa deambulación con apoyo de bastón, transferencias sin ayuda. Presenta riesgo de caídas por fragilidad moderada, sarcopenia y gonalgia.
- A nivel cognitivo-anímico, no presenta deterioro ni tiene antecedentes de delirium y se encuentra eutímica, a pesar de insomnio crónico de conciliación.
- A nivel nutricional, refiere hiporexia en los últimos meses secundaria a boca seca que no controla con medidas higiénico-dietéticas. Presenta pérdida de peso de 2-3 kg en cinco meses. Niega disfagia. Hábito deposicional regular.
- A nivel social, es viuda y reside sola en un piso sin barreras arquitectónicas. Tiene un hijo con quien no mantiene relación. No tiene tramitada la ley de dependencia y ha solicitado teleasistencia, que está en proceso de tramitación.
- A nivel sensorial, presenta déficit visual corregido con gafas e hipoacusia bilateral sin corrección con audífonos.
- A nivel doloroso, destaca gonartrosis bilateral con regular control con analgesia de primer escalón.
- Otros síndromes geriátricos: polifarmacia con toma de 7 fármacos.
II CLINIC CONTEST NAVARRA En Fibrilación Auricular, Tromboembolismo Venoso asociado al Cáncer y Control de Dislipemia con Terapia Oral en el ámbito sanitario de Navarra Fibrilación auricular
Mujer de 86 años que acude inicialmente al servicio de Urgencias, derivada desde el Centro de Salud, por episodio de 24 horas de evolución de palpitaciones y dolor centrotorácico opresivo, no irradiado, sin cortejo vegetativo, desencadenado en reposo y de más de 10 minutos de duración. Refiere disnea de mínimos esfuerzos de una semana de evolución y ortopnea de dos almohadas sin disnea paroxística nocturna, aumento de edemas en extremidades inferiores, oliguria ni nicturia. No presenta otra clínica por aparatos asociada. Sin sintomatología infecciosa y afebril.
Exploración física (primera atención en Urgencias):
Paciente con buen estado general y hemodinámicamente estable con las constantes vitales dentro de la normalidad. A destacar, frecuencia cardiaca (FC) a 67 latidos por minuto (lpm) y saturación de oxígeno a 96% aire ambiente.
- Cabeza y cuello: Xerostomía. No micosis oral. No ingurgitación yugular.
- Auscultación cardiopulomonar: Rítmica sin soplos. Crepitantes húmedos bibasales.
- Abdomen: Anodino con peristaltismo de progresión presente.
- Extremidades inferiores: No edemas ni signos de trombosis venosa profunda.
- Neurológico: Sin focalidad neurológica objetivada.
Pruebas complementarias:
Estas son las pruebas complementarias realizadas durante la atención en los distintos centros sanitarios:
- Electrocardiograma (ECG): En el registro inicial del Centro de Salud se objetivó FA con ritmo ventricular medio (RVM) a 140 lpm. En la primera visita a Urgencias, tras la realización de cardioversión eléctrica efectiva, se evidenció ritmo sinusal (RS) a 69 lpm con PR normal, QRS estrecho, QTc límite (425) y ondas Q en I, AvL, V5 y V6 presentes en registros previos (2024). En la segunda visita a Urgencias, se constató FA a 130 lpm sin otras alteraciones significativas.
- Analítica sanguínea: En ambas visitas a Urgencias, presentó aumento del fragmento terminal N del péptido natriurético tipo B (NT-proBNP) (6.255 pg/mL) y troponina I en rango normal.
Marta Lorente Escudero, María Del Carmen Santisteban Alonso y Stephania Rodríguez Villeda
- Radiografía de tórax: En la primera atención en Urgencias, se apreció cardiomegalia y signos de redistribución vascular. En la segunda, sin cambios respecto a la previa.
- Ecoscopia a pie de cama: Dilatación biauricular, FEVI 40%, cava no dilatada y compresible y ausencia de derrame pericárdico.
Inicialmente, la paciente acudió a Urgencias por episodio de FA rápida a 140 lpm. En el traslado en ambulancia de Soporte Vital Avanzado presentó diaforesis y náuseas, por lo que, ante dudosa inestabilidad hemodinámica, se realizó cardioversión eléctrica bajo sedo-analgesia y se consiguió revertir la FA a RS. En sala de reanimación, tras objetivarse estabilidad clínico-analítica (seriación enzimática y eléctrica negativas), se decide alta a domicilio manteniendo la misma dosis de anticoagulación (Apixaban 5 mg/12 horas) e iniciando tratamiento beta-bloqueante con Bisoprolol (2.5 mg/12 horas) como tratamiento frenador.
A las 48 horas del alta, acudió nuevamente a Urgencias por persistencia de malestar general y palpitaciones, objetivándose taquicardia a 130 lpm. Dada la estabilidad hemodinámica, se decide ingreso en Medicina Interna para control de frecuencia cardiaca y tratamiento depletivo endovenoso por insuficiencia cardiaca secundaria a la FA. Su evolución fue relativamente favorable, decidiéndose traslado a un hospital de media estancia para recuperación, dado deterioro funcional agudo y optimización de soporte social tras 7 días de hospitalización. Al alta, se realizó ajuste de dosis de anticoagulación: Apixaban 2.5 mg/12h (por peso de 57.9 kg y edad de 85 años).
La fibrilación auricular (FA) es una patología altamente prevalente en el paciente anciano, superando el 15 % en octogenarios y nonagenarios, especialmente en presencia de fragilidad, multimorbilidad y polifarmacia (1). A pesar de ello, la mayoría de estudios y guías de práctica clínica carecen de estratificación por edad, comprometiendo su validez externa en poblaciones geriátricas heterogéneas.
En el caso clínico presentado, se optó por cardioversión eléctrica, intervención respaldada por la ACC (American College of Cardiology) 2023 en situaciones de inestabilidad hemodinámica o tras fracaso farmacológico. Sin embargo, su uso en pacientes frágiles requiere una
II CLINIC CONTEST NAVARRA En Fibrilación Auricular, Tromboembolismo Venoso asociado al Cáncer y Control de Dislipemia con Terapia Oral en el ámbito sanitario de Navarra Fibrilación auricular
evaluación exhaustiva de la tolerancia a la sedación y del riesgo de eventos adversos (2). Otro estudio de la American Heart Journal (2023) alertó sobre un aumento significativo de bradiarritmias post-cardioversión en mayores de 80 años con cardiopatía estructural (3).
En cuanto al uso de anticoagulantes orales, como en el caso presentado, reciente evidencia refuerza su utilidad en ancianos frágiles, ya que se ha demostrado que su implementación reduce eventos clínicos adversos (como ictus) sin incremento significativo en sangrado mayor, aunque su beneficio neto disminuye con la fragilidad (4), existiendo una evidencia limitada específica en esta población concreta (5)guidelines advocate anticoagulation based on the CHA2DS2-VASc score for all AF patients aged 75 and above. However, some practitioners are hesitant to prescribe anticoagulants to older and frail patients due to perceived elevated bleeding risks. This review delves into the comparative treatment outcomes of DOACs versus vitamin K antagonists (VKAs.
En conclusión, el manejo de la FA en el anciano frágil debe basarse en una valoración geriátrica integral que considere riesgo tromboembólico, sangrado, funcionalidad y fragilidad, priorizando decisiones terapéuticas individualizadas basadas en evidencia actual y contexto clínico.
1. Parks AL, Frankel DS, Kim DH, Ko D, Kramer DB, Lydston M, et al. Management of atrial fibrillation in older adults. BMJ. 2024 Sep 17;386:e076246.
2. Joglar JA, Chung MK, Armbruster AL, Benjamin EJ, Chyou JY, Cronin EM, et al. 2023 ACC/AHA/ACCP/HRS Guideline for the Diagnosis and Management of Atrial Fibrillation: A Report of the American College of Cardiology/American Heart Association Joint Committee on Clinical Practice Guidelines. Circulation. 2024 Jan 2;149(1):e1–156.
3. Rasmussen PV, Blanche P, Dalgaard F, Gislason GH, Torp-Pedersen C, Tønnesen J, et al. Electrical cardioversion of atrial fibrillation and the risk of brady-arrhythmic events. Am Heart J. 2022 Feb;244:42–9.
4. Søgaard M, Jensen M, Højen AA, Larsen TB, Lip GYH, Ording AG, et al. Net Clinical Benefit of Oral Anticoagulation Among Frail Patients With Atrial Fibrillation: Nationwide Cohort Study. Stroke. 2024 Feb;55(2):413–22.
5. Spruit JR, de Vries TAC, Hemels MEW, Pisters R, de Groot JR, Jansen RWMM. Direct Oral Anticoagulants in Older and Frail Patients with Atrial Fibrillation: A Decade of Experience. Drugs Aging. 2024 Sep;41(9):725–40.
II CLINIC CONTEST NAVARRA En Fibrilación Auricular, Tromboembolismo Venoso asociado al Cáncer y Control de Dislipemia con Terapia Oral en el ámbito sanitario de Navarra
CASOS PRESENTADOS
NO FINALISTAS
Maider Olaizola Guerrero.
MIR. Medicina Interna.
June García Bascones.
MIR. Cardiología.
Carlos Vizcay Aranaz.
Medicina Interna.
Hospital Universitario de Navarra (HUN).

II CLINIC CONTEST NAVARRA En Fibrilación Auricular, Tromboembolismo Venoso asociado al Cáncer y Control de Dislipemia con Terapia Oral en el ámbito sanitario de Navarra Fibrilación auricular
Varón de 91 años que ingresa desde Urgencias, en febrero de 2025, por infección del tracto urinario (ITU) con aislamiento de Staphylococcus aureus meticilín sensible (SAMS), en contexto de sondajes vesicales intermitentes por retención aguda de orina (RAO) de repetición. Refiere además inestabilidad y síncope asociado con traumatismo craneoencefálico leve. El paciente se encontraba en ritmo sinusal al ingreso.
El paciente, autónomo en actividades básicas y sin antecedentes de fibrilación auricular, presenta al ingreso un episodio de ITU complicada con SAMS, iniciándose antibioterapia con ceftriaxona. La evolución inicial es favorable. Sin embargo, días después, desarrolla debilidad hemicorporal derecha y disartria. Se realiza escáner craneal sin hallazgos agudos. Al empeorar clínicamente, con aparición de foco neurológico más evidente y soplo sistólico de nueva aparición en auscultación cardíaca, se solicita resonancia magnética craneal, donde se evidencian múltiples infartos isquémicos subagudos supratentoriales e infratentoriales, de probable origen cardioembólico.
Ante sospecha de endocarditis infecciosa (EI) con embolismos sépticos, se inicia tratamiento antibiótico dirigido (cloxacilina, ampicilina y gentamicina) y anticoagulación con enoxaparina a dosis terapéuticas, dado el hallazgo de fibrilación auricular (FA) de nueva aparición en la reevaluación clínica a la semana del ingreso. A los pocos días, el paciente presenta melenas sin repercusión hemodinámica, por lo que se decide suspender la anticoagulación.
Tras estabilización clínica y mejora neurológica parcial (de aproximadamente dos semanas de ingreso), se le traslada a un centro de media estancia para continuar el tratamiento antibiótico y rehabilitación funcional.
Los eventos embólicos (EE) son la complicación extracardiaca más frecuente de las EI (14-30%). A pesar de que solo entre el 10-50% de ellos son sintomáticos, se estima que aumentan un 30% la mortalidad hospitalaria en estos pacientes.
La hemorragia cerebral (HC), aun siendo menos frecuente (en torno al 3%), presenta mayor mortalidad asociada. Por ello, la anticoagulación en pacientes con EI y EE cerebrales es un tema controvertido.
SIN ANTICOAGULAR?
ANTE TODO, CALMA
Maider Olaizola Guerrero, June García Bascones y Carlos Vizcay Aranaz
El caso ilustra una situación clínica frecuente y compleja: un paciente con EI izquierda por S. aureus y evidencia de embolismos cerebrales sépticos, que desarrolla fibrilación auricular (FA) de nueva aparición. Ante esta circunstancia, surgen dos interrogantes clínicos clave: ¿debe iniciarse anticoagulación en estos casos? ¿Debe suspenderse si el paciente ya la recibía previamente por FA?
La anticoagulación en la fase activa de la EI ha sido objeto de debate durante décadas. Si bien inicialmente se consideraba que podría mejorar la penetración antibiótica en las vegetaciones, la evidencia actual ha revertido esta visión. En la fase activa de la infección, especialmente por S. aureus, el riesgo de hemorragia intracraneal (HIC) se incrementa notablemente, incluso en pacientes sin anticoagulación previa. El uso de anticoagulantes puede exacerbar este riesgo, sobre todo en el contexto de embolismos sépticos con daño endotelial, formación de aneurismas micóticos o transformación hemorrágica de infartos.
Distintas guías y revisiones coinciden en que no se recomienda iniciar anticoagulación en pacientes con EI sobre válvula nativa y embolismos cerebrales recientes, salvo que exista una indicación independiente de la infección (como FA con alto riesgo tromboembólico). Incluso en esos casos, el momento de inicio es crucial: se sugiere retrasar la anticoagulación al menos 1–2 semanas si el infarto cerebral es extenso o si hay sospecha de hemorragia. En infartos pequeños, podría iniciarse con heparinas tras 48–72 horas y reevaluación por neuroimagen.
En este caso, la decisión inicial de anticoagular al paciente con FA de nueva aparición se revirtió tras la aparición de melenas, valorando el riesgo hemorrágico frente al beneficio tromboembólico. La evolución favorable tras suspensión de anticoagulación apoya una actitud conservadora en pacientes añosos y frágiles con eventos embólicos menores.
Por otro lado, en pacientes ya anticoagulados previamente por FA u otras indicaciones, la literatura sugiere suspender temporalmente la anticoagulación durante la fase activa si se produce un evento embólico cerebral o si aparecen signos de hemorragia, especialmente en infección por S. aureus. La interrupción breve (una o dos semanas) no parece aumentar el riesgo de nuevos eventos en pacientes con válvula protésica o FA estable.
CLINIC
NAVARRA En Fibrilación Auricular, Tromboembolismo Venoso asociado al Cáncer y Control de Dislipemia con Terapia Oral en el ámbito sanitario de Navarra Fibrilación auricular
¿Iniciaría anticoagulación en este caso? Probablemente no de forma inmediata, salvo evidencia clara de FA persistente con alto riesgo tromboembólico y lesiones cerebrales pequeñas sin transformación hemorrágica. Reevaluaría el caso a los pocos días con nueva imagen.
¿Retiraría anticoagulación en alguien ya anticoagulado por FA? Sí. Si existen embolismos cerebrales sépticos recientes convendría retirar anticoagulación, especialmente en la fase activa de EI; incluso, sin signos de HC. La reintroducción debe individualizarse según evolución clínica y neurológica.
En definitiva, el enfoque se debe individualizar, centrando la atención en el balance riesgo/beneficio para optimizar el pronóstico. Pero, en resumen, ante la duda de si anticoagular o no, mejor esperar.
ANTICOAGULAR?
ANTE TODO, CALMA
Maider Olaizola Guerrero, June García Bascones y Carlos Vizcay Aranaz
1. María Castiñeira-Busto, Emad Abu-Assi, Martínez-Monzonis A, PeñaGil C, Raposeiras-Roubin S, José Ramón González-Juanatey. Predicción del riesgo de embolia sistémica séptica en pacientes con endocarditis infecciosa. Revista española de cardiología (Ed impresa) [Internet]. 2015 Jan 1;68(1):78–9. Availablefrom: https://www.revespcardiol.org/esprediccion-del-riesgo-embolia-sistemica-articulo-S0300893214005144
2. Fuente, López Rodríguez, R, Ferreiro, Lado L. Controversias en endocarditis infecciosas. Anales de Medicina Interna [Internet]. 2025 [cited 2025 Apr 22];22(5):244–7. Availablefrom: https://scielo.isciii.es/scielo. php?script=sci_arttext&pid=S0212-71992005000500011.
3. Tornos P, Almirante B, Mirabet S, Permanyer G, Pahissa A, Soler-Soler J. Infective Endocarditis Due to Staphylococcus aureus. Archives of Internal Medicine. 1999 Mar 8;159(5):473.
4. Kanter, M. C., and R. G. Hart. “Neurologic Complications of Infective Endocarditis.” Neurology, vol. 41, no. 7, 1 July 1991, pp. 1015–1015, https://doi. org/10.1212/wnl.41.7.1015. Accessed 13 May 2020.
5. F, Varona J. “Complicaciones Neurológicas Como Manifestación Inicial de Endocarditis Infecciosa.” Anales de Medicina Interna, vol. 24, no. 9, 2025, pp. 439–441, scielo.isciii.es/scielo.php?script=sci_arttext&pid =S0212-71992007000900007. Accessed 22 Apr. 2025.
6. Hart, R G, et al. “Mechanisms of Intracranial Hemorrhage in Infective Endocarditis.” Stroke, vol. 18, no. 6, Nov. 1987, pp. 1048–1056, https://doi. org/10.1161/01.str.18.6.1048. Accessed 15 Mar. 2021
7. Arboix, Adria, and Josefina Alio. “Acute Cardioembolic Cerebral Infarction: Answers to Clinical Questions.” Current Cardiology Reviews, vol. 8, no. 1, 1 June 2012, pp. 54–67, https://doi.org/10.2174/157340312801215791. Accessed 10 Apr. 2020.
8. Scheggi, Valentina, et al. “Impact of Septic Cerebral Embolism on Prognosis and Therapeutic Strategies of Infective Endocarditis: A Retrospective Study in a Surgical Centre.” BMC Infectious Diseases, vol. 22, no. 1, 17 June 2022, https://doi.org/10.1186/s12879-022-07533-w. Accessed 25 Apr. 2025.
9. Yamada, ShokoMerrit, et al. “A Case of Multiple Cerebral Hemorrhages Followed by Shower Emboli.” Radiology Case Reports, vol. 19, no. 10, June 2024, pp. 4561–4564, pubmed.ncbi.nlm.nih.gov/39220788/, https://doi. org/10.1016/j.radcr.2024.07.088.
II CLINIC CONTEST NAVARRA En Fibrilación Auricular, Tromboembolismo Venoso asociado al Cáncer y Control de Dislipemia con Terapia Oral en el ámbito sanitario de Navarra
NO FINALISTAS
CASOS PRESENTADOS
Irene Criado Martín. Geriatría.
Inés Suescun Colomo. MIR. Cardiología.
Hospital Universitario de Navarra (HUN).

Irene
Criado Martín e Inés Suescun Colomo
Motivo de consulta:
Caída con dolor e impotencia funcional en cadera izquierda.
Antecedentes personales:
Hipertensión arterial, cardiopatía valvular degenerativa, insuficiencia mitral al menos moderada con fracción de eyección conservada, fibrilación auricular anticoagulado con Apixaban, enfermedad renal crónica estadio 3-a, polimialgia reumática, divertículos de colon y síndrome vestibular periférico. Tratamiento previo: Betahistina 16 mg 1 c/12 h, Bisoprolol 2,5mg (1-0-1/2), Esomeprazol 20mg /24h, Lorazepam 1mg /24h, Mirtazapina 15 mg /24h, Paracetamol 1g /8h, Apixaban 2,5mg /12h.
Situación basal (previa al ingreso). Física: camina con andador, incontinencia de orina ocasional, ayuda en ducha; independiente para todo lo demás (Índice de Barthel 85/100). Maneja el teléfono y lava la ropa (Índice de Lawton 2/8). Mental: sin deterioro cognitivo, animo preservado, insomnio manejado farmacológicamente. Social: vive en domicilio sin barreras arquitectónicas, con uno de sus dos hijos (la otra vive fuera de la comunidad). Nutricional: dieta variada, no pérdida de peso, no disfagia. Otros síndromes geriátricos: hipoacusia leve, caídas de repetición, estreñimiento. Anamnesis: cuenta caída en domicilio, precedida de mareo coincidiendo con un cambio postural. No pérdida de conciencia ni traumatismo craneoencefálico. No otra sintomatología acompañante. Refiere mareos frecuentes, con varias caídas en el último año, habiendo cogido por ello mucho miedo a caer. No otra clínica en la anamnesis por órganos y aparatos. Niega cambios recientes en la medicación. Exploración física (al ingreso): peso 65 kilos, tensión arterial 120/60, frecuencia cardiaca 110, saturación mantenida, afebril. Arrítmica, sin ruidos patológicos a nivel pulmonar, abdomen anodino, con miembro inferior izquierdo acortada y en rotación externa.
Pruebas complementarias:
Ubicación Urgencias Ingreso traumatología Reingreso geriatría
Analítica Hb 12.1, FG: 35 Hb: 8.2, FG: 16 Hb 11, FG: 28
ECG FA RVM a 89 lpm FA con RV a 110 lpm FA con RV 140
CLINIC CONTEST NAVARRA En Fibrilación Auricular, Tromboembolismo Venoso asociado al Cáncer y Control de Dislipemia con Terapia Oral en el ámbito sanitario de Navarra Fibrilación auricular
Ingresa con el diagnóstico de fractura subcapital de cadera izquierda, para intervención quirúrgica. Se realiza interconsulta a Geriatría y Hematología (que indica terapia con Bemiparina, suspendiendo Apixaban). La intervención se realiza 60 h después de su llegada a Urgencias, con colocación de prótesis parcial. Como complicaciones postquirúrgicas se detecta anemización de 4 puntos de hemoglobina, que requieren de 1 concentrado de hematíes más hierro endovenoso, estreñimiento, retención aguda de orina y taquicardia (FA con RVR a 110 latidos). Se realiza adecuado control del dolor, recibe tratamiento precoz con fisioterapia, se suplementa dieta y se indican laxantes orales para manejo de estreñimiento. Al alta, nueve días después del ingreso, camina con andador y ayuda de una persona, precisando ayuda en actividades básicas, animo deprimido en el contexto de deterioro funcional, vuelve a domicilio. Se indica tratamiento con Denosumab, suplementando calcio y vitamina D; se indica ejercicio físico (Vivifrail A); se indican suplementos hiperproteicos; se ajusta analgesia y se aumenta dosis de Bisoprolol (de 3.75 a 5 mg cada 24h) y se reintroduce Apixaban. Se intenta retirada de Lorazepam por aumentar riesgo de caídas, sin lograrse. Se recomienda control de frecuencia cardiaca por médico de Primaria y cuidador principal. Remitida a consultas externas (monográficas caídas).
Evolución tras el alta:
Consulta en dos ocasiones en Urgencias por frecuencias elevadas (120 a 130 lpm), finalmente ingresa en Geriatría tras tres semanas del alta, por FA con RVR a 140 lpm y disnea. En el reingreso se descartan razonablemente posibles eventos desencadenantes como infecciones respiratorias o de orina, así como tromboembolismo pulmonar (mediante gammagrafía). Se ajusta tratamiento con Digoxina y Bisoprolol. Se logra controlar frecuencias, siendo alrededor de 100 lpm. Se incentiva durante el ingreso la deambulación con fisioterapia, dado que en domicilio no había progresado en la recuperación funcional por miedo a caerse de nuevo y sobrecarga del cuidador. Es dada de alta con deambulación con andador y supervisión. Indicamos seguimiento tras tres semanas con analítica, teniendo FG habitual y digoxinemia en rango. Se decide seguimiento muy estrecho por médico de Primaria y Geriatría, por alto riesgo de intoxicación digitálica, caídas y deterioro de función renal.
Irene Criado Martín e Inés Suescun Colomo
La incidencia anual de fracturas de cadera en mayores de 65 años es de 7 casos por cada 1.000 habitantes en España (1) y la prevalencia de FA es del 8,5% en mayores de 60 años, con un incremento progresivo con la edad, alcanzando un 16,5% en los mayores de 85 años (2). La incidencia de fracturas de cadera en pacientes con FA es significativamente mayor en comparación con aquellos sin FA, debido a factores de riesgo común y uso de fármacos en FA, entre otros (3). La fractura de cadera requiere de intervención quirúrgica urgente y una de sus complicaciones más frecuentes es la amenización. Con el uso cada vez más frecuente de los anticoagulantes directos, en su mayoría sin antídoto (a diferencia de los inhibidores de vitamina K), surge la preocupación por el retraso en la intervención. En cirugías mayores, en varios estudios, se observa la seguridad de Apixaban con suspensión 48h previo a la cirugía y reintroducción 48h después (4), aunque en la práctica clínica con frecuencia se apliquen tiempos mayores.
Como en el caso presentado, es frecuente el mal control de la frecuencia cardíaca en pacientes con FA tras una cirugía mayor y esto se debe a diferentes factores, entre ellos estrés adrenérgico, pérdida de volumen e inflamación (5). Tendemos a un control estricto de esta con un objetico de 80 lpm o menos; sin embargo, según la American Heart Association (AHA), un objetivo de frecuencia cardíaca de menos de 110 lpm es razonable para la mayoría de los pacientes con FA.
En este caso, la fractura de cadera no solo ha condicionado un mal control de FC, sino un deterioro funcional y anímico de la paciente, así como sobrecarga del cuidador y, en conjunto, el reingreso.
En pacientes ancianos pluripatológicos es frecuente encontrar dosis reducidas de Apixaban aunque no esté indicado (6). En muchas ocasiones el límite es muy difuso (FG en torno a 30, peso variable) y hay que individualizar en función del riesgo y la situación clínica.
■ El mayor riesgo de fractura de cadera en personas con fibrilación auricular muestra lo importante que es saber cómo tratar bien esta condición cuando un paciente ingresa por una fractura de cadera.
■ Es importante considerar estrategias de prevención de fracturas de cadera en pacientes con FA, incluyendo la evaluación y tratamiento de la osteoporosis.
II CLINIC CONTEST NAVARRA En Fibrilación Auricular, Tromboembolismo Venoso asociado al Cáncer y Control de Dislipemia con Terapia Oral en el ámbito sanitario de Navarra Fibrilación auricular
■ Es fundamental un abordaje integral en el paciente con FA y fractura de cadera dado que la evolución clínica, funcional y contexto social, están íntimamente relacionadas.
1. Torregrosa Suau Ó. La incidencia de la fractura de cadera se sitúa en siete casos por cada 1.000 habitantes mayores de 65 años en España [Internet]. Madrid: Sociedad Española de Medicina Interna; 2020 [citado 2025 mayo 8]. Disponible en: https://www.fesemi.org/informacion/prensa/ semi/la-incidencia-de-la-fractura-de-cadera-se-situa-en-siete-casos-porcada-1000
2. Ruigómez A, Rodríguez LA, Wallander MA, Johansson S, Jones R. Prevalencia de fibrilación auricular en la población general de 60 años o más en España: estudio PREV-ICTUS. Rev Esp Cardiol. 2008;61(10):1041–7. Disponible en: https://www.revespcardiol.org/es-prevalencia-fibrilacionauricular-poblac-articulo-13107118
3. Wang Y, Wang Z, Gu W, et al. Atrial fibrillation and the risk of bone fractures: a meta-analysis of prospective cohort studies. Medicine (Baltimore). 2024;103(52):e41049. doi:10.1097/MD.0000000000041049.
4. January CT, Wann LS, Calkins H, Chen LY, Cigarroa JE, Cleveland JC Jr, et al. 2023 ACC/AHA guideline for the diagnosis and management of atrial fibrillation: a report of the American College of Cardiology/American Heart Association Joint Committee on Clinical Practice Guidelines. Circulation. 2024;149(1):e1–e156. doi:10.1161/CIR.0000000000001193.
5. Chyou JY, Barkoudah E, Dukes JW, et al. Atrial fibrillation occurring during acute hospitalization: a scientific statement from the American Heart Association. Circulation. 2023;147(15):e676–e698. doi:10.1161/ CIR.0000000000001133.
6. Spruit JR, de Vries TAC, Hemels MEW, Pisters R, de Groot JR, Jansen RWMM. Direct oral anticoagulants in older and frail patients with atrial fibrillation: a decade of experience. Drugs Aging. 2024 Sep;41(9):725–740.
II CLINIC CONTEST NAVARRA En Fibrilación Auricular, Tromboembolismo Venoso asociado al Cáncer y Control de Dislipemia con Terapia Oral en el ámbito sanitario de Navarra
CASOS PRESENTADOS
NO FINALISTAS
Amaia Urtasun Rezusta.
MIR. Oncología Médica. HUN.
Iratxe Sánchez Cordero.
MIR. Medicina Familiar y Comunitaria.
Centro de Salud San Martín (Vitoria-Gasteiz).
Ángela Gómez Garduño.
Medicina Interna. HUN

II CLINIC CONTEST NAVARRA En Fibrilación Auricular, Tromboembolismo Venoso asociado al Cáncer y Control de Dislipemia con Terapia Oral en el ámbito sanitario de Navarra Fibrilación auricular
Varón de 90 años, que consulta por disnea súbita de mínimos esfuerzos de 48 horas de evolución.
Antecedentes personales:
No alergias medicamentosas conocidas. Diabetes mellitus tipo 2. Dislipemia. Hipertensión arterial. Enfermedad renal crónica (ERC) estadio 3aA3. Infecciones de tracto urinario inferior de repetición. Adenocarcinoma de próstata tratado en 2011 con radioterapia y bloque hormonal. Extirpación de dos carcinomas basocelulares en 2024.
Situación basal: independiente para actividades básicas de la vida diaria y funciones superiores preservadas. Reside junto a su mujer en su domicilio habitual y realiza vida activa.
Tratamiento habitual:
Cianocobalamina mensual, Telmisartan 80 mg/Amlodipino 5 mg cada 24h, Linagliptina 2,5 mg/Metformina 850 mg cada 12 horas, Atorvastatina 20 mg cada 24 horas, Noctamid 1 mg antes de dormir, Silodosina 8 mg cada 24horas.
ENFERMEDAD ACTUAL
Consulta por disnea súbita de mínimos esfuerzos de 48 horas de evolución con ortopnea la noche previa. No presenta aumento de edemas en extremidades inferiores ni aumento de perímetro abdominal. No dolor torácico o palpitaciones. Afebril.
Como hallazgo reseñable, el paciente asocia anemia microcítica hipocrómica (Hb 10gr/dl) desde hace 5 meses, que no había sido estudiada. No refiere exteriorización de sangrado.
Exploración física
A su llegada a planta, tras pasar 48 horas en observación con tratamiento diurético endovenoso, presenta tensión arterial de 133/83 mmHg, frecuencia cardíaca de 93 lpm, temperatura de 37,2ºC y saturación de oxígeno de 96% con fracción inspirada de oxígeno de 36%.
Aceptable estado general, consciente, orientado en las tres esferas y colaborador. Taquipnea con habla entrecortada, tonos cardíacos arrítmicos con soplo sistólico en foco aórtico e hipofonesis en base derecha. Abdomen blando y depresible, no doloroso a la palpación. En
UNA COMBINACIÓN MUY HABITUAL, ¿MIEDO A ANTICOAGULAR?
Amaia Urtasun Rezusta, Iratxe Sánchez Cordero y Ángela Gómez Garduño
extremidades inferiores mínimos edemas con fóvea en puntos declives y pulsos periféricos simétricos.
Pruebas complementarias
- Analítica sanguínea: anemia microcítica con una hemoglobina de 8,6 g/dl y un perfil ferropénico. Glucosa 182 mg/dl, urea 51 mg/dl, creatinina 1,18 mg/dl, Filtrado glomerular 54ml/min/1,73m2, péptido natriurético de 12348 pg/ml. proteína C reactiva de 335 mg/l.
- Electrocardiograma de urgencias: ritmo sinusal a 80 latidos por minuto con bloqueo completo de rama derecha.
- Electrocardiogramas en planta: fibrilación auricular (FA) paroxística con ritmo ventricular a 80 latidos por minuto.
- Radiografía de tórax: índice cardiotorácico aumentado, con redistribución vascular y derrame pleural bilateral con posible infiltrado en lóbulo inferior derecho.
- Ecoscopia a pie de cama: base pulmonar derecha patrón C y en base pulmonar izquierda atelectasia con derrame pleural moderado. Cava de 1,7 cm, colapsable a más del 50% con la inspiración. Fracción de eyección de ventrículo izquierdo que impresiona de límite o ligeramente reducida (Mitral Annular Plane Systolic Excursion (MAPSE) 8 mm).
- Gastroscopia: sin hallazgos relevantes. Se tomaron biopsias gástricas con hallazgos de gastritis crónica (Helicobater pylori negativa) y biopsia duodenal sin lesión histológica significativa.
- Colonoscopia: no se pudo completar por formación de bucle constante asociado a una mucosa friable.
- Tomografía axial computarizada abdominal: colon derecho con espasticidad y diverticulosis, sin otros hallazgos relevantes.
- Dado que era el primer episodio de descompensación cardíaca y en vista de lo anteriormente mencionado, se solicitó ecocardiograma transtorácico (ETT) reglado.
Se trata de un paciente de edad avanzada que ingresa por insuficiencia cardiaca con derrame pleural asociado en contexto de FA paroxística, neumonía derecha y anemia ferropénica. Durante su ingreso presenta muy buena respuesta a tratamiento diurético con mejoría de la congestión en 48-72 horas. Se inició tratamiento con inhibidores del cotransportador de sodio-glucosa tipo 2 y beta-
II CLINIC CONTEST NAVARRA En Fibrilación Auricular, Tromboembolismo Venoso asociado al Cáncer y Control de Dislipemia con Terapia Oral en el ámbito sanitario de Navarra Fibrilación auricular
bloqueante a dosis bajas. Se administró tratamiento antibiótico de forma empírica sin aislamientos microbiológicos. Aunque no se objetivó exteriorización de sangrado durante el ingreso, dada la pronta mejoría cardiorrespiratoria, para estudio de la anemia ferropénica se realizó estudio endoscópico digestivo con los resultados previamente mencionados. La anemia fue tratada con ferroterapia endovenosa, administrando una primera dosis en urgencias y una segunda en planta con una optimización de hemoglobina de 9,4 g/dl.
Tras constatar una FA paroxística con una puntuación de 5 en la escala CHA2DS2-VASc, se inició anticoagulación con heparina de bajo peso molecular y tras realización de estudio endoscópico digestivo se inició tratamiento con Edoxaban a dosis de 30 mg/día por ERC con filtrado glomerular al alta de 46 ml/min/1,73m2.
Al mes fue valorado en consultas externas, pendiente de realización de ETT reglado. El paciente refería notable mejoría clínica, incorporándose progresivamente a su vida habitual. Presentaba saturación de oxígeno basal de 95%, sin signos de congestión y manteniéndose en FA con buen control de frecuencia cardíaca. Negaba exteriorización de sangrados y en la analítica presentaba hemoglobina de 12 g/dl con niveles de hierro corregidos y reticulocitos de 1,6%.
Al tratarse de un varón de edad avanzada y múltiples comorbilidades que ingresa por insuficiencia cardíaca en el contexto de una anemia, es fundamental valorar de manera individualizada la indicación de anticoagulación teniendo en cuenta tanto el riesgo tromboembólico como el riesgo hemorrágico, así como la elección del anticoagulante. El uso de Edoxabán en pacientes ancianos pluripatológicos con riesgo de sangrado se considera una opción segura y eficaz gracias a su perfil de seguridad y simplicidad en el manejo. Edoxabán ofrece una eficacia comparable a Warfarina en prevención de eventos tromboembólicos con un riesgo menor de hemorragias mayores, especialmente intracraneales, lo cual es crucial en pacientes frágiles (1). Además, su administración una vez al día y la ausencia de necesidad de controles rutinarios mejoran la adherencia terapéutica, algo particularmente importante en ancianos con regímenes complejos.
Desde una perspectiva clínica, el uso de Edoxabán se respalda por evidencia sólida en esta población vulnerable. El estudio ETNA-AF Europe, que incluyó a más de 13.000 pacientes, mostró que los índices de
UNA COMBINACIÓN MUY HABITUAL, ¿MIEDO A ANTICOAGULAR?
Amaia Urtasun Rezusta, Iratxe Sánchez Cordero y Ángela Gómez Garduño
hemorragia intracraneal (HIC) y sangrado mayor en pacientes frágiles tratados con Edoxabán fueron bajos, incluso en aquellos con insuficiencia renal o múltiples comorbilidades (2). En particular, la incidencia anual de HIC en pacientes frágiles fue del 0,15%, comparado con el 0,27% en pacientes no frágiles.
1. Giugliano RP, Ruff CT, Braunwald E, et al. Edoxaban versus Warfarin in Patients with Atrial Fibrillation. N Engl J Med. 2013;369(22):2093–2104.
2. De Caterina R, Ammentorp B, Darius H, et al. Edoxaban for stroke prevention in atrial fibrillation in routine clinical care: 1-year follow-up of the prospective observational ETNA-AF-Europe study. Eur Heart J Cardiovasc Pharmacother. 2020;6(4):245–254.
II CLINIC CONTEST NAVARRA En Fibrilación Auricular, Tromboembolismo Venoso asociado al Cáncer y Control de Dislipemia con Terapia Oral en el ámbito sanitario de Navarra
Javier Ecay Narvaiz.
Centro de Salud Mendillorri.
Amaia Cabasés Ordóñez.
CASOS PRESENTADOS
NO FINALISTAS
MIR. Medicina Familiar y Comunitaria.
Medicina Familiar y Comunitaria.
Centro de Salud Aranguren.

Varón de 71 años con episodios de mareo y disnea en los últimos 3 días. Atendido en Urgencias hospitalarias: “Flúter con respuesta ventricular media (RVM) mantenida”, tras tratamiento oral con Bisoprolol 5 mg, recomendando seguimiento por su médico de Atención Primaria.
Antecedentes:
Cardiopatía isquémica, de perfil vasoespástico (coronariografía con coronarias normales en abril de 2017).
Debut de fibrilación auricular (FA) en el postoperatorio de cirugía de cadera (octubre de 2020). Desde entonces ha presentado episodios de FA paroxística sintomática (5-7 anuales), con respuesta ventricular rápida. Ecoscopia normal y FEVI conservada. CHA2DS2-VASc 1, HAS-BLED 1, anticoagulado con acenocumarol. Control de frecuencia con Diltiazem 120 mg cada 12 horas.
Dislipemia, tratada con Simvastatina 40mg. No alergias conocidas. No hábitos tóxicos.
Jubilado, vive en domicilio con su esposa. Vida independiente y activa: hace gimnasia en domicilio, camina a diario durante una hora, y cuida y juega habitualmente con su nieto de 9 años, sin disnea ni dolor torácico. Buen control de tensión arterial esporádico.
Desde hace 3 días, al realizar los ejercicios de gimnasia, comienza a notar palpitaciones y sensación de mareo, que impide hacer esfuerzos y jugar al fútbol con su nieto. Refiere cierta mejoría en Urgencias con la medicación pautada, pero ha vuelto a presentar el mismo cuadro.
La subida al centro de salud le provoca una disnea evidente, por lo que las administrativas lo acompañan a la sala de Urgencias donde se realiza un electrocardiograma (ECG).
En exploración, niega dolor torácico y náuseas. No sudoración, ni disnea aunque menor sensación de mareo. No ha presentado síncope.
No identifica ningún desencadenante: no fiebre ni clínica infecciosa, no toma alcohol ni otros tóxicos, tampoco antinflamatorios u otros fármacos adicionales.
Exploración física:
Hemodinámicamente estable, con constantes vitales: tensión arterial 104/87 mmHg, frecuencia cardíaca 110 latidos por minuto
II CLINIC CONTEST NAVARRA En Fibrilación Auricular, Tromboembolismo Venoso asociado al Cáncer y Control de Dislipemia con Terapia Oral en el ámbito sanitario de Navarra Fibrilación auricular
(lpm), temperatura axilar 35.3ºC, saturación de oxígeno 96% basal, frecuencia respiratoria 18 respiraciones por minuto.
Buen estado general. Normohidratado y normoperfundido. Eupnéico en reposo, sin taquipnea ni trabajo respiratorio. No ingurgitación yugular. Auscultación cardíaca arrítmica, sin soplos audibles. Auscultación pulmonar: murmullo vesicular conservado, sin otros ruidos ni áreas hipofonéticas. Abdomen blando y depresible, sin masas ni visceromegalias, no doloroso; ruidos hidroaéreos presentes. Extremidades inferiores: No edemas ni signos de trombosis venosa profunda. Se palpan pulsos periféricos simétricos, retromaleolares débiles. Relleno capilar conservado, menor de 2 segundos.
Pruebas complementarias:
INR: 2.3. ECG: arrítmico, fibrilación auricular con conducción ventricular a 102 lpm, con eje neutro y bloqueo de rama derecha, con ondas T negativas en V1-4, ya presentes en trazados previos.
Ante la clínica, las constantes en el límite y el ECG, se le propone al paciente acudir de nuevo a Urgencias, pero se niega por obligaciones personales y porque se encuentra mejor en ese momento.
Se decide conjuntamente preparar un volante de derivación a Urgencias para acudir en el momento que presente el mínimo dolor torácico y se realiza interconsulta a Cardiología para acordar el mejor fármaco frenador en este caso, dados los antecedentes de angina vasoespástica. A pesar de la indicación de antagonistas de los canales de calcio (Diltiazem), se acuerda aumentar dosis de Bisoprolol, vista la buena tolerancia en Urgencias y en episodios previos (con estrecha vigilancia). Se decidió instaurar Bisoprolol 2.5 mg cada 12h y revisión a diario en el centro de salud con ECG. Durante los siguientes 4 días, se aumentó progresivamente la dosis hasta 5mg cada 12h, comprobando buena tolerancia y ausencia de dolor torácico. Al cabo de los 7 días, el paciente acudió con los mismos síntomas pero con peor aspecto general, disnea de pequeños esfuerzos, crepitantes finos en bases pulmonares y edemas maleolares, tensión arterial de 98/77 mmHg, frecuencia cardíaca 128 lpm y sin mostrar mejoría en el ECG.
Se decidió enviarle a Urgencias para realizar un mejor control de la frecuencia cardíaca. El paciente fue ingresado en observación y se administró Bisoprolol oral y Amiodarona endovenosa para conseguir
controlar la frecuencia de la FA con respuesta ventricular rápida. Incluso se logró la reversión a ritmo sinusal antes del alta. También se inició tratamiento diurético (Furosemida 40mg) ante los signos de insuficiencia cardíaca leve que presentaba tras 10 días de evolución.
Finalmente, fue valorado en consulta de Cardiología:
- Se actualizó la ecografía cardíaca: ventrículo izquierdo de espesor parietal, tamaño y función sistólica global normal; patrón de llenado aparentemente normal; ventrículo derecho normal; insuficiencia mitral leve degenerativa; aurícula izquierda ligeramente dilatada (en anteroposterior, 37 mm); raíz aórtica de tamaño normal; sin derrame pericárdico.
- Se decidió cambiar el anticoagulante de Acenocumarol a Edoxaban, por comodidad del paciente: CHA2 DS2-VA 1, HAS-BLED 1, con tiempo en rango terapéutico >60% con acenocumarol.
- Se mantiene Bisoprolol 5 mg cada 12 horas.
- Se cita en consulta específica de arritmias para valoración y estudio por “episodios de FA y flúter no común paroxísticos”.
La FA es una de las enfermedades cardíacas más frecuentes, con gran impacto en todos los niveles asistenciales. Además de producir síntomas que reducen la calidad de vida, los pacientes presentan riesgo elevado de sufrir accidente cerebrovascular (ACV), insuficiencia cardíaca y otros eventos tromboembólicos (daño cerebral subclínico), lo que contribuye a un mayor riesgo de mortalidad asociado a FA (1).
En nuestro caso, el paciente presentaba episodios paroxísticos de FA y flúter auricular, que es otra arritmia frecuente (317 por 100.000 personas-año en sujetos mayores de 50 años) y que coexisten en más del 50% de los pacientes con flúter (2).
Las nuevas guías defienden un abordaje personalizado de cada caso, acorde a la evolución particular de cada paciente, a través de estrategias como AF-CARE. En ella se debe realizar (C) una búsqueda activa de comorbilidades y factores de riesgo, (A) prevención del ACV y tromboembolismos, (R) reducción de los síntomas y comorbilidades a través de un control eficaz del ritmo y/o la frecuencia en cada caso, y (E) reevaluación de cada aspecto en los diferentes niveles asistenciales, dadas las comorbilidades cambiantes (1).
En nuestro caso, se buscó un abordaje personalizado y coordinado entre los diferentes niveles asistenciales, no encontrando factores de
II CLINIC CONTEST NAVARRA En Fibrilación Auricular, Tromboembolismo Venoso asociado al Cáncer y Control de Dislipemia con Terapia Oral en el ámbito sanitario de Navarra Fibrilación auricular
riesgo adicionales en el presente episodio (C), garantizando una adecuada anticoagulación (INR en rango y posterior cambio a anticoagulantes orales) (A), buscando la mejor estrategia de control de síntomas (inicialmente control de frecuencia, y posterior resolución de la clínica al realizar reversión farmacológica y valoración futura de procedimientos avanzados para prevenir nuevos episodios) (R) y reevaluación en cada nivel asistencial (Atención Primaria, Urgencias y Cardiología). A nivel de Atención Primaria el control de frecuencia y ritmo supone un reto en algunos pacientes con episodios de arritmia rápida. Sin embargo, la capacidad de seguimiento estrecho, el uso de guías clínicas actualizadas y la comunicación con otros niveles asistenciales pueden ser la clave para ofrecer al paciente el tratamiento más adecuado.
1. Van Gelder IC, Rienstra M, Bunting KV, et al. 2024 ESC Guidelines for the management of atrial fibrillation developed in collaboration with the European Association for Cardio-Thoracic Surgery (EACTS). Eur Heart J. 2024;45(36):3314-3414. doi:10.1093/eurheartj/ehae176.
2. Granada J, Uribe W, Chyou PH, Maassen K, Vierkant R, Smith PN, et al. Incidence and predictors of atrial flutter in the general population. J Am Coll Cardiol. 2000;36(7):2242–6. doi: 10.1016/S0735-1097(00)00982-7.
II CLINIC CONTEST NAVARRA En Fibrilación Auricular, Tromboembolismo Venoso asociado al Cáncer y Control de Dislipemia con Terapia Oral en el ámbito sanitario de Navarra
CASOS PRESENTADOS
NO FINALISTAS
Inés Suescun Colomo.
MIR. Cardiología.
Coro Velasco Gametxogoikoetxea.
MIR. Cardiología.
Ángela García Zuazola.
MIR. Cardiología.
Hospital Universitario de Navarra (HUN).

II CLINIC CONTEST NAVARRA En Fibrilación Auricular, Tromboembolismo Venoso asociado al Cáncer y Control de Dislipemia con Terapia Oral en el ámbito sanitario de Navarra Fibrilación auricular
Paciente de 65 años, que acude al servicio de Urgencias por cuadro de malestar general consistente en astenia, edemas en EEII y epigastralgia.
Antecedentes personales:
Factores de riesgo cardiovascular: HTA, Dislipemia, sobrepeso.
Historia cardiológica previa:
Seguimiento en consultas de cardiología desde 2006 por valvulopatía reumática mitral, ultimo control ecográfico: doble lesión mitral con estenosis leve-moderada e insuficiencia moderada (II-III/IV). Ventrículo izquierdo no dilatado con FEVI (fracción de eyección del ventrículo izquierdo) conservada. PSAP (Presión Sistólica de la Arteria Pulmonar) estimada de 30 mmHg. Función de ventrículo derecho conservado. Aurícula izquierda dilatada 49 mmL.
Otros:
Mutación V Leiden. Trombosis venosa profunda (TVP) recurrente en tratamiento con sintrom. Crisis convulsiva tónico-clónica, posible crisis secundariamente generalizada. Migraña con aura visual.
ENFERMEDAD ACTUAL
El paciente acude a Urgencias por cuadro de malestar general consistente en astenia de una semana de evolución, discreto aumento de edemas y epigastralgia de características urentes, principalmente tras las comidas.
Ultima revisión cardiológica hace 8 días. En ese momento, el paciente estaba asintomático desde el punto de vista cardiológico. Se objetivó caída en fibrilación auricular (FA) con respuesta ventricular rápida a 118 lpm. Ecoscopia: doble lesión mitral con estenosis e insuficiencia moderadas. Se inicia estrategia de control de frecuencia aumentando dosis de Bisoprolol a 5 mg/12h y revisión con ecocardiograma reglado en 6 meses.
Tratamientos previos:
Sintrom 4 mg según controles de hematología. Atorvastatina 10 mg 0-0-1; Acediur 20/12,5 mg 0-0-1; Trileptal 300 mg 2-0-2.
ASPECTOS CLAVE A CONSIDERAR Inés Suescun Colomo, Coro Velasco Gametxogoikoetxea y Ángela García Zuazola
Exploración física:
Contantes: Tensión arterial 117/77 mmHg, frecuencia cardiaca 83 latidos por minuto (lpm), saturación basal 96%, afebril.
Paciente presenta buen estado general. Consciente y orientado, bien perfundido. Eupneico en reposo.
Auscultación cardiaca arrítmica, soplo sistólico en foco mitral con irradiación axilar, auscultación pulmonar sin ruidos sobreañadidos.
Edemas maleolares hasta tercio inferior tibial. Pulsos periféricos presentes y simétricos. No presenta signos de ingurgitación yugular.
Exploración abdominal: blando y depresible, sin masas ni megalias. Dolor a la palpación de epigastrio. Ruidos de peristaltismo conservados. No signos de irritación peritoneal.
Pruebas complementarias:
- ECG: FA con RVM rápida a 130 lpm. Eje QRS dentro de la normalidad. QRS estrecho sin alteraciones de la repolarización. Se repite ECG y se realiza tira de ritmo tras exploración donde se observa ECG: FA con RVM a 90 lpm. QRS estrecho sin alteraciones de la repolarización.
- Analítica de sangre: hemograma sin alteraciones. Coagulación con INR 3. Función renal conservada. Iones en rango. NT-proBNP 7000.
- Radiografía de tórax no presenta alteraciones significativas.
- Se realiza ecoscopia a pie de cama en la que se aprecia: doble lesión mitral con estenosis e insuficiencia moderadas (II/III-IV) ventrículo izquierdo no dilatado con FEVI conservada. Ventrículo derecho normal. Aurícula izquierda dilatada. No derrame pericárdico.
Durante su estancia en Urgencias, el paciente permanece hemodinámicamente estable. En la exploración se registran FC en torno a 90-100 lpm, pese a primer ECG registrado con FA a 136 lpm. Se administra una Omeprazol 40 mg y 2 g de Metamizol iv con mejoría clara de la epigastralgia. Así mismo, se administra 20 mg de Furosemida iv.
Se decide el alta del paciente a domicilio con diagnóstico de posible insuficiencia cardiaca con función preservada, en paciente con FA y valvulopatía reumática. Se prescribe para el domicilio Furosemida 20 mg/24 vo con control en una semana por parte de su médico de
II CLINIC CONTEST NAVARRA En Fibrilación Auricular, Tromboembolismo Venoso asociado al Cáncer y Control de Dislipemia con Terapia Oral en el ámbito sanitario de Navarra Fibrilación auricular
Atención Primaria. Mantenemos estrategia de control de frecuencia y anticoagulación con sintrom. En función de evolución, plantear adelantar cita con Cardiología o realizar interconsulta no presencial.
La prevalencia de la FA se ha visto en aumento en los últimos años, siendo esta la arritmia más prevalente, con una estimación aproximada de 50 millones de personas en 2020. En nuestro caso, nos encontramos ante un paciente con un riesgo incrementado de presentar FA, en concreto la prevalencia de FA en paciente con valvulopatía reumática oscila entre el 29% y el 70 %.
La valvulopatía reumática es causada por una respuesta anormal tras una infección por el Streptococcus pyogenes, lo que conlleva un remodelado valvular, siendo el más común la estenosis mitral y el más relacionado con la FA la valvulopatía mitral mixta con insuficiencia tricupídea.
En cuanto al tratamiento de nuestro paciente en el momento del debut de FA, se opta por un tratamiento de control de frecuencia, dado que ese momento el paciente se encontraba asintomático. En caso de presentar una valvulopatía con presencia de síntomas limitantes (NYHA III o IV), se debería considerar la intervención valvular y se podía plantear conjuntamente a modo de control de ritmo la realización de una ablación.
El segundo aspecto importante en el manejo de la FA es la anticoagulación; nuestro paciente ya se encontraba anticoagulado por trombosis de repetición con factor genético predisponente, sin embargo, en el caso contrario tendría indicación de anticoagulación con fármacos antagonistas de vitamina K, independientemente del CHA₂DS₂VASc, dado que, la estenosis mitral reumática moderada tiene un alto riesgo de tromboembolismo. La elección de antagonistas vitamina K se debe principalmente a la falta de evidencia que respalde el uso de los anticoagulantes directos en esta población específica.
Por último, hay que destacar el aparente debut de insuficiencia cardiaca conservada (IC-FEc), dada la presencia de signos indirectos de ello, como son la presencia de edemas y un NT-proBNP elevado. Aunque esto podría parecer sencillo, el diagnóstico de IC-FEc en pacientes que a su vez presentan FA resulta un reto.
La coexistencia de ambas patologías, es relativamente frecuente y complica la identificación de la IC-FEc, ya que ambas condiciones
REUMÁTICA: ASPECTOS CLAVE A CONSIDERAR
Inés Suescun Colomo, Coro Velasco Gametxogoikoetxea y Ángela García Zuazola
pueden presentar síntomas superpuestos, así como, comparten factores de riesgo y mecanismos subyacentes
Como bien sabemos la FA se detecta con relativa facilidad mediante electrocardiograma, pero el diagnóstico de IC-FEc, requiere una evaluación más completa que considere síntomas, hallazgos clínicos, alteraciones estructurales y funcionales del corazón, biomarcadores y parámetros hemodinámicos. Es por esto que en este paciente podríamos plantear un posible diagnóstico de IC-FEc, sin embargo necesitamos una evaluación a largo plazo.
Para facilitar esta tarea, es fundamental contar con algoritmos y herramientas específicos que permitan diferenciar la IC-FEc de manera más fiable como son HFA-PEFF y H2FPEF sin embargo han demostrado una precisión moderada en pacientes con FA, por lo cual siempre deben ir acompañadas de una adecuada valoración por el clínico.
II CLINIC CONTEST NAVARRA En Fibrilación Auricular, Tromboembolismo Venoso asociado al Cáncer y Control de Dislipemia con Terapia Oral en el ámbito sanitario de Navarra Fibrilación auricular
1. Nielsen JC, Lin YJ, de Oliveira Figueiredo MJ, Sepehri Shamloo A, Alfie A, Boveda S, et al. European Heart Rhythm Association (EHRA)/Heart Rhythm Society (HRS)/Asia Pacific Heart Rhythm Society (APHRS)/ Latin American Heart Rhythm Society (LAHRS) expert consensus on risk assessment in cardiac arrhythmias: use the right tool for the right outcome, in the right population. Heart Rhythm. 2020;17(9):e269–e316. doi:10.1016/j.hrthm.2020.05.004.
2. Kumar RK, Antunes MJ, Beaton A, Mirabel M, Nkomo VT, Okello E, et al. Contemporary diagnosis and management of rheumatic heart disease: implications for closing the gap: a scientific statement from the American Heart Association. Circulation. 2020;142(20):e337–e357. doi:10.1161/CIR.0000000000000921.
3. Otto CM, Nishimura RA, Bonow RO, Carabello BA, Erwin JP 3rd, Gentile F, et al. 2020 ACC/AHA guideline for the management of patients with valvular heart disease: a report of the American College of Cardiology/ American Heart Association Joint Committee on Clinical Practice Guidelines. J Thorac Cardiovasc Surg. 2021;162(2):e183–e353. doi:10.1016/j. jtcvs.2021.04.002.
4. Joglar JA, Chung MK, Armbruster AL, Benjamin EJ, Chyou JY, Cronin EM, et al. 2023 ACC/AHA/ACCP/HRS guideline for the diagnosis and management of atrial fibrillation: a report of the American College of Cardiology/American Heart Association Joint Committee on Clinical Practice Guidelines. Circulation. 2024;149(1):e1–e156. doi:10.1161/ CIR.0000000000001193
5. Ariyaratnam JP, Mishima RS, Kadhim K, Emami M, Fitzgerald JL, Thiyagarajah A, et al. Utility and validity of the HFA-PEFF and H2FPEF scores in patients with symptomatic atrial fibrillation. J Am Coll Cardiol HF. 2024;12(6):1015–25.


En Fibrilación Auricular, Tromboembolismo Venoso asociado al Cáncer y Control de Dislipemia con Terapia Oral en el ámbito sanitario de Navarra
Ana José Martín Serrablo.
MIR. Neumología.
Roger Antoni Frigola Castro.
MIR. Cirugía Vascular.
Enara Echauri Carlos.
MIR. Medicina Interna.
Hospital Universitario de Navarra (HUN).

Ana José Martín Serrablo , Roger Antoni Frigola Castro y Enara Echauri Carlos
Mujer de 53 años, natural de Colombia, que tras sospecha de lesión tumoral tibial derecha se inicia proceso diagnóstico. Entre sus antecedentes personales destacan lupus eritematoso sistémico, miopatía inflamatoria y miositis orbitaria de probable etiología autoinmune, sin hábitos tóxicos a destacar.
En este caso, el proceso diagnóstico se inicia mediante una ecografía de bultoma doloroso en vientre muscular tibial anterior y se completa estudio mediante resonancia magnética (RM) con resultado de “hallazgos compatibles con sarcoma/mixofibrosarcoma”, por lo que se realiza biopsia. Se confirma por anatomía patológica la presencia de sarcoma de alto grado compatible con tumor de la vaina del nervio periférico maligno. Ante estos hallazgos, se decide cirugía y braquiterapia de la lesión tras tomografía computarizada por emisión de positrones (PET-TC), dónde se observa un nódulo pulmonar en lóbulo superior izquierdo (LSI) sugestivo de metástasis, actividad metabólica en hilio contralateral inespecífico, lesión nodular en la región poplítea, así como aumento de actividad metabólica de la lesión intramuscular del compartimento anterior de la tibia derecha y aumento de actividad del recorrido vascular en relación con ectasia por compresión. Tras esto, se extirpa la lesión principal y metástasis del hueco poplíteo ipsilateral, con colocación de implante de braquiterapia para braquiterapia perioperatoria (20 y en 5 fracciones).
A todo el proceso oncológico, hay que añadir que, durante esos meses de estudio, la paciente ha permanecido con dolor intenso en la pierna; tanto por las lesiones y el compromiso a nivel del paquete vasculonervioso, como por los procedimientos quirúrgicos realizados, limitando su movilidad al uso de dos bastones y una ortesis de tobillo, favoreciendo el sedentarismo e inmovilización gran parte del día. Al mes de la cirugía, acude de forma programada para LA realización de una ecobroncoscopia (EBUS-TBNA) para completar estudio de extensión oncológico, así como descartar un tumor sincrónico de origen pulmonar. Se localiza adenopatía derecha a nivel 11R, mediante EBUS-TBNA, y a su lado se observa en el interior de la arteria pulmonar una imagen sugestiva de trombo, por lo que se solicita AngioTC que confirma el diagnóstico de trombo tumoral en la arteria pulmonar derecha e infarto pulmonar en lóbulo inferior derecho (LID), aumento del tamaño del nódulo de LSI y aparición de nódulo en LID (Figura 1).
II CLINIC CONTEST NAVARRA En Fibrilación Auricular, Tromboembolismo Venoso asociado al Cáncer y Control de Dislipemia con Terapia Oral en el ámbito sanitario de Navarra Tromboembolismo venoso asociado a cáncer
En ese momento, se decide ingreso en planta de hospitalización para estudio y se inicia anticoagulación con heparina de bajo peso molecular (HBPM) a mg/kg cada 12h (70 mg/12h). La paciente presenta dolor pleurítico submamario izquierdo y aumento de edema y empastamiento de extremidad inferior derecha (EID). En el ecodoppler de EID se objetiva trombosis venosa profunda (TVP) en vena poplítea derecha y secuelas postquirúrgicas (hematomas y osteotomía de peroné).
Sin embargo, a los dos días de ingreso presenta episodio de hemoptisis franca. Se decide vigilancia clínica y, en caso de nuevo episodio, retirar anticoagulación y dar preferencia a la clínica hemorrágica, puesto que la TVP no es proximal y el trombo pulmonar probablemente sea de origen tumoral.
Por otra parte, se inicia quimioterapia con doxorrubicina e ifosfamida ante anatomía patológica de tumor de alta agresividad, crecimiento del tumor y aparición de nuevas lesiones sugestivas de metástasis. Al alta y tras valorar riesgo-beneficio de anticoagulación y buscando un mayor control tras el antecedente de hemoptisis reciente, se mantiene HBPM a dosis terapéuticas. Un mes más tarde, ya en consultas, se decide modificar anticoagulación, iniciando tratamiento con Edoxaban 60 mg/24h por los antecedentes descritos (TEP, TVP, neoplasia en tratamiento).
En los controles posteriores mediante TC y PET-TC se objetiva progresión tumoral a nivel pulmonar con aparición de nuevos nódulos y aumento de tamaño de los previos, lesión de partes blandas que rompe 6º arco costal izquierdo, gran derrame pleural derecho, importante tumoración en pierna derecha y probable metástasis ósea en diáfisis tibial y peroné. Además de nuevo defecto de repleción en arteria lobar de lóbulo medio en TC, y persistencia de TVP de aspecto crónico, por lo que se decide mantener anticoagulación con Edoxaban hasta el momento actual, en paciente con función renal normal.
Este caso representa un ejemplo paradigmático de tromboembolismo venoso (TEV) en una paciente diagnosticada de tumor de la vaina del nervio periférico maligno metastásico, donde coexisten factores de riesgo de trombosis de etiología diversa (factores de riesgo moderado como el LES, quimioterapia, cáncer metastásico, TVP, cirugía o factores de riesgo leve como inmovilización y reposo en cama >3
Ana José Martín Serrablo , Roger Antoni Frigola Castro y Enara Echauri Carlos
días, mecánicos por la compresión vascular, obesidad por inflamación sistémica) (1). Además de la complejidad del caso a nivel diagnóstico y terapéutico por la concomitancia de la TVP en la vena poplítea derecha, la trombosis de origen tumoral en la arteria pulmonar y el infarto pulmonar asociado.
En pacientes oncológicos, el TEV es una complicación frecuente con una incidencia del 20% del total, además de presentar mayor morbimortalidad y complicaciones hemorrágicas y trombóticas. Por eso, se podría evaluar el riesgo de ETEV con escalas ambulatorias como la escala de Khorana; no obstante, esta escala no tiene en cuenta los sarcomas, a pesar de mayor riesgo de trombosis (2,3,4).
La identificación de un trombo tumoral en arteria pulmonar, observada mediante EBUS, es una manifestación muy poco frecuente pero reconocida en la literatura (5,6). La observación de un trombo intravascular mediante EBUS presenta una buena correlación con los hallazgos del AngioTC, tanto a en trombos centrales como en ramas más periféricas (7). A diferencia del tromboembolismo clásico, el trombo tumoral puede no responder completamente a la anticoagulación, lo que obliga a un manejo individualizado. La elección del tratamiento anticoagulante también representa un reto. Las guías actuales recomiendan heparinas de bajo peso molecular (HBPM) como primera línea en pacientes oncológicos con TEV al inicio de la fase aguda, para en la fase crónica cambiar a anticoagulantes orales directos (ACOD) que han emergido como una alternativa oral segura y eficaz en determinados subgrupos (8).
Por último, cabe destacar la importancia del diagnóstico precoz de TEV en este caso mediante EBUS, para completar de forma multimodal con AngioTC y PET-TC, y así caracterizar adecuadamente tanto la extensión tumoral como el componente trombótico, lo que refuerza la complejidad e importancia de la evaluación multidisciplinar en estos pacientes tan complejos.
II CLINIC CONTEST NAVARRA En Fibrilación Auricular, Tromboembolismo Venoso asociado al Cáncer y Control de Dislipemia con Terapia Oral en el ámbito sanitario de Navarra Tromboembolismo venoso asociado a cáncer
1. Konstantinides SV et al. Guía ESC 2019 para el diagnóstico y tratamiento de la embolia pulmonar aguda. Rev Esp Cardiol. 2020;73(6): 497.e1-497. e58.
2. Krzyzaniak H, You DZ, Mosca G, Monument MJ, Schneider PS. Venous thromboembolism rates in patients with bone and soft tissue sarcoma of the extremities following surgical resection: A systematic review. J Surg Oncol. 2021 Sep;124(3):390-399.
3. Kamalapathy PN, Kline A, Hollow H, Raskin K, Schwab JH, LozanoCalderón S. Predictors of Symptomatic Venous Thromboembolism in Patients with Soft Tissue Sarcoma in the Lower Extremity. Cancers (Basel). 2023 Jan 3;15(1):315.
4. Kronzer E, Robinson SI, Collins DA, McBane RD 2nd. Primary pulmonary artery sarcoma versus pulmonary thromboembolism: a multimodal imaging comparison. J Thromb Thrombolysis. 2021 Nov;52(4):1129-1132.
5. Şentürk A et al. Diagnóstico por la imagen del tromboembolismo pulmonar mediante ecografía endobronquial. Arch Bronconeumol. 2013;49(6):268–271.
6. Llopis Pastor E, Franco Serrano J, Burés Sales E. Tromboembolismo pulmonar diagnosticado mediante ecobroncoscopia. Arch Bronconeumol. 2013;49(12):553-6.
7. Sanz-Santos J, Andreo F, García-Olivé I, Remón J, Monsó E. Diagnosis of acute pulmonary embolism by endobronchial ultrasound as an incidental finding. Respiration. 2011; 81:150–1.
8. Sachdeva A, Lee HJ, Malhotra R, Shepherd RW. Endobronchial ultrasound diagnosis of pulmonary embolism. Journal of Bronchology & Interventional Pulmonology. 2013; 20:33–4.
DEL HALLAZGO INCIDENTAL AL MANEJO DEL TROMBO TUMORAL: EBUS EN EL DIAGNÓSTICO PRECOZ DE


Figura 1: A) Imagen ecobroncoscópica sugestiva de trombo flotante en el interior de la arteria pulmonar derecha. B) Angio-TC torácico con contraste. Defecto de depleción nodular en arteria pulmonar derecha.

II CLINIC CONTEST NAVARRA
En Fibrilación Auricular, Tromboembolismo Venoso asociado al Cáncer y Control de Dislipemia con Terapia Oral en el ámbito sanitario de Navarra
Iñigo Poyo Molina. Medicina Familiar y Comunitaria. Centro de Salud Chantrea.

VENOSA PROFUNDA (TVP) DISTAL EN PACIENTE ONCOLÓGICO DESDE ATENCIÓN PRIMARIA. Iñigo Poyo Molina
El tromboembolismo venoso (TEV) es una complicación frecuente en pacientes con cáncer, especialmente en fases avanzadas de la enfermedad o durante tratamiento activo. En Atención Primaria (AP), la sospecha clínica exige un abordaje ágil y razonado que combine escalas de predicción clínica y pruebas de imagen si se dispone de ellas. En este caso, se presenta el manejo integral de una trombosis venosa profunda (TVP) distal en un paciente oncológico, diagnosticada mediante ecografía clínica y tratada desde Atención Primaria.
Varón de 68 años con antecedente de adenocarcinoma de próstata Gleason 8, en tratamiento hormonal de deprivación androgénica y pendiente de inicio de radioterapia paliativa por diseminación ósea. Acude a consulta por edema progresivo y dolor en la pierna izquierda de cuatro días de evolución. Sin antecedentes personales ni familiares de trombosis previas.
Exploración física y hallazgos clínicos:
■ Dolor a la compresión gemelar izquierda.
■ Edema infra patelar con discreta asimetría de perímetros (2 cm de diferencia con la pierna contralateral).
■ No signos inflamatorios, no fóvea.
■ Pulsos distales presentes y simétricos.
■ Ausencia de disnea, dolor torácico, taquipnea o desaturación (saturación de oxígeno 97% basal, frecuencia respiratoria 14 rpm).
Valoración inicial: Escala de Wells modificada.
Se aplica la escala de Wells modificada para la evaluación de la probabilidad pretest de TVP, obteniendo un total de 3 puntos, lo que indica una alta probabilidad de trombosis venosa profunda. Esta puntuación se desglosa de la siguiente manera:
Ítem Valoración
Cáncer activo (en tratamiento)
Edema de toda la pierna
+1 punto
+1 punto
Dolor a la palpación del trayecto venoso profundo +1 punto
Total
+3 puntos
II CLINIC CONTEST NAVARRA En Fibrilación Auricular, Tromboembolismo Venoso asociado al Cáncer y Control de Dislipemia con Terapia Oral en el ámbito sanitario de Navarra Tromboembolismo venoso asociado a cáncer
Algoritmo visual: Cálculo de la probabilidad clínica de TVP (Figura 1).
Diagnóstico ecográfico en consulta. Se realiza Ecografía Doppler desde la consulta de AP, siguiendo el protocolo de exploración compresiva de tres puntos:
■ Vena femoral común: permeable y compresible (Figura 2).
■ Vena poplítea: permeable y compresible (Figura 3).
■ Vena tibial posterior: ocupación parcial, no compresible, hallazgo compatible con TVP distal (Figura 4).
Diagnóstico:
Trombosis venosa profunda distal izquierda en paciente oncológico activo.
Intervención terapéutica.
Desde consulta de AP se decide:
■ Iniciar tratamiento con heparina de bajo peso molecular (Enoxaparina) a dosis de 1 mg/kg cada 12 horas (dosis terapéutica).
■ Explicar el probable diagnóstico, evolución esperada y signos de alarma.
■ Realizar interconsulta no presencial al servicio de Hematología (Unidad de Coagulación) para seguimiento y eventual decisión sobre duración del tratamiento anticoagulante.
■ Se recomienda mantener reposo relativo con movilización suave, mantener la pierna en alto, siempre que sea posible, y vigilar signos de progresión (aumento del dolor, edema o disnea), acudiendo a Urgencias si aparecen.
SEGUIMIENTO Y EVOLUCIÓN
A los diez días se cita al paciente para revisión en consulta, donde se objetiva disminución del edema y dolor. El paciente tolera bien la anticoagulación. Desde Hematología se recomienda mantener la HBPM al menos durante 6 meses, dada la condición oncológica activa.
DISCUSIÓN
Este caso ilustra un abordaje integral, resolutivo y seguro del TEV asociado a cáncer desde AP. Se destaca el uso de herramientas clínicas (escala de Wells) para evitar exploraciones innecesarias y el valor añadido del ecógrafo como elemento clave en la toma de decisiones. La accesibilidad al ecógrafo en consulta permite a los médicos de AP
VENOSA PROFUNDA (TVP) DISTAL EN PACIENTE ONCOLÓGICO DESDE ATENCIÓN PRIMARIA. Iñigo Poyo Molina
diagnosticar y tratar con seguridad eventos graves como la TVP, optimizando recursos y mejorando la atención del paciente oncológico. Con todo ello se plantea un enfoque proactivo en el inicio del tratamiento desde AP, sin demoras ni derivaciones innecesarias, promoviendo una atención más eficiente y centrada en el paciente.
1. García de Casasola G, Torres Macho J. Manual de Ecografía Clínica. 1.ª ed. Madrid: Grupo de Trabajo de Ecografía Clínica, Hospital Infanta Cristina; 2012.
2. Khorana AA, Noble S, Lee AYY, Soff G, Meyer G, O’Connell C, et al. Cancerassociated venous thromboembolism. Nat Rev Clin Oncol. 2022;19(5):305–18.
3. Lyman GH, Carrier M, Ay C, Di Nisio M, Hicks LK, Khorana AA, et al. Venous thromboembolism prophylaxis and treatment in patients with cancer: ASCO guideline update. J Clin Oncol. 2021;39(36):4199–213.
4. Ministerio de Sanidad. Guía de Práctica Clínica sobre el manejo del tromboembolismo venoso. Madrid: Ministerio de Sanidad; 2020.
5. NICE. Venous thromboembolic diseases: diagnosis, management and thrombophilia testing. NICE guideline [NG158]. London: National Institute for Health and Care Excellence (NICE); 2020.
II CLINIC CONTEST NAVARRA En Fibrilación Auricular, Tromboembolismo Venoso asociado al Cáncer y Control de Dislipemia con Terapia Oral en el ámbito sanitario de Navarra Tromboembolismo venoso asociado a cáncer
Cálculo de la probabilidad clínica TVP (escaa de Wells)
TVP improbable TVP probable
Dímero D
Negativo
Positivo
Ecografía por compresión sistema venoso simplificada
Negativo
Diagnóstico de TVP muy poco probable. Es seguro no anticoagular
Positivo
Positivo
Ecografía por compresión sistema venoso simplificada
Negativo
Diagnóstico probable de TVP.Valorar confirmación antes de anticoagular*
Repetir ecografía por compresión sistema venoso simplificada a los 10-14 días
Figura 1: Cálculo de la probabilidad clínica de TVP. Imagen tomada del Manual de Ecografía Clínica de García de Casasola y Torres Macho (2012). *En hasta un 3-5% de los casos puede haber falsos positivos en el diagnóstico de TVP con ecograf ía por compresión.
DIAGNÓSTICO Y TRATAMIENTO DE LA TROMBOSIS VENOSA PROFUNDA (TVP) DISTAL EN PACIENTE ONCOLÓGICO DESDE ATENCIÓN PRIMARIA. Iñigo Poyo Molina





Figura 4: Ocupación parcial de vena tibial posterior con falta de compresibilidad.
Figura 2: Comparativa ecográfica de la vena femoral común (sin compresión a la izquierda y con compresión a la derecha).
Figura 3: Comparativa ecográfica de la vena poplítea (sin compresión a la izquierda y con compresión a la derecha).

TROMBOEMBOLISMO
TROMBOEMBOLISMO
Casos presentados
Casos presentados
II CLINIC CONTEST NAVARRA En Fibrilación
Auricular, Tromboembolismo Venoso asociado al Cáncer y Control de Dislipemia con Terapia Oral en el ámbito sanitario de Navarra
CASOS PRESENTADOS

Andoni Fernández González.
MIR. Cardiología.
Amaia Martínez León. Cardiología.
Amaia Loyola Arrieta.
MIR. Cardiología.
Hospital Universitario de Navarra (HUN).

II CLINIC CONTEST NAVARRA En Fibrilación Auricular, Tromboembolismo Venoso asociado al Cáncer y Control de Dislipemia con Terapia Oral en el ámbito sanitario de Navarra Tromboembolismo venoso asociado a cáncer
Mujer de 73 años con accidente isquémico transitorio en junio 2023. En el ecocardiograma transtorácico (ETT), insuficiencia mitral (IM) moderada degenerativa con necrosis licuefactiva (NL) asociada sobre calcificación anular mitral (CAM) posterior.
Cuatro meses después, ingresa por accidente cerebrovascular (ACV), objetivándose durante el ingreso fibrilación auricular (FA) de novo. En resonancia magnética cerebral, se evidencian múltiples infartos subagudos precoces de probable etiología cardioembólica, iniciando anticoagulación. Ante febrícula, se extraen hemocultivos y serologías para microorganismos típicos y atípicos, resultando negativos.
En ETT y ecocardiograma transesofágico (ETE) se observó progresión de IM siendo severa por perforación de valva (tipo I de Carpentier) a nivel posterior, adyacente al área de calcificación caseosa del anillo mitral (CCAM) e imágenes vibrátiles sugestivas de vegetaciones (Figura 1), sospechándose endocarditis infecciosa (EI). Se amplió estudio con tomografía computarizada (TC) cardiaca, que evidencia NL de gran extensión involucrando miocardio inferior y velo posterior, además de solución de continuidad de pared calcificada adyacente a base de P2-P3 (Figura 2A, B, C), reforzando la posibilidad de rotura de la misma como foco embolígeno. Solicitamos PET 18F-Fluorodesoxiglucosa, que muestra captación anular mitral hipermetabólica heterogénea compatible con proceso infeccioso activo (Figura 2D).
Se presenta en sesión médico-quirúrgica, optándose por recambio valvular mitral quirúrgico pese a dificultad técnica de la intervención. Durante el procedimiento se visualiza severa calcificación del anillo posterior con NL, dejando una cavidad de 30x10mm. Se extirpan las valvas y se ancla bioprótesis mitral, apoyada en la porción posterior del anillo mitral sobre bandas de pericardio bovino. En análisis de pieza quirúrgica, presencia de inflamación crónica con ausencia de infección activa. Posteriormente, buena evolución, con prótesis normofuncionante y ausencia de nuevos eventos embólicos.
DISCUSIÓN
La CAM es un proceso crónico degenerativo predominante a nivel posterior del anillo fibroso mitral, asociado principalmente a edad avanzada, sexo femenino, enfermedad renal y factores de riesgo de aterosclerosis (1) cuya presencia implica un riesgo de ACV estimado
Andoni Fernández González, Amaia Martínez León y Amaia Loyola Arrieta
del 4,8 al 24,1% (2). La CCAM es una variante infrecuente (<1%), de contenido licuefactivo (3), asociada a mayor riesgo de ACV embólico.
Existe discrepancia respecto al manejo. Algunos autores recomiendan seguimiento estrecho en asintomáticos e intervención quirúrgica ante embolismo, aumento del riesgo embólico y/o indicación por valvulopatía (3). Otros recomiendan intervención quirúrgica independientemente de síntomas y eventos embólicos (4).
Respecto al tratamiento médico, algunos autores plantean anticoagulación como terapia preventiva en los casos de comunicación de la CAM con cavidades cardiacas, independientemente de su asociación con fibrilación auricular (5).
Sin embargo, otras publicaciones como las de Chevalier B et al, 2011; De Hemptinne et al, 2015; Dietl CA et al, 2016; o Fujiwara M et al, 2022; describen 3 mecanismos embólicos posibles de la CCAM: desprendimiento directo de elementos calcificados, embolización del material fibrinoso, o embolización del material caseoso mediante fístula. En consecuencia, la antiagregación y anticoagulación, resultarían inefectivas (2,3,4,6).
En nuestro caso, el estudio de imagen multimodal sugiere rotura de la calcificación y embolización del material caseoso como mecanismos fisiopatológicos posibles del accidente cerebrovascular; por lo que el inicio de la anticoagulación fue indicada por la detección de fibrilación auricular y no por la CCAM con evento embólico asociado.
La MAC y especialmente la CCAM aumentan el riesgo cardiovascular y tienen potencial embólico. La cirugía podría ser una opción para evitar complicaciones embólicas. Actualmente no existe evidencia para apoyar la anticoagulación de forma rutinaria en estos pacientes con el objetivo de prevenir eventos embólicos.
II CLINIC CONTEST NAVARRA En Fibrilación Auricular, Tromboembolismo Venoso asociado al Cáncer y Control de Dislipemia con Terapia Oral en el ámbito sanitario de Navarra Tromboembolismo venoso asociado a cáncer
1. Movahed MR, Saito Y, Ahmadi-Kashani M. Mitral annulus calcification is associated with valvular and cardiac structural abnormalities. Cardiovasc Ultrasound 2007; 5:14
2. Dietl CA, Hawthorn CM, Raizada V. Risk of Cerebral Embolization with Caseous Calcification of the Mitral Annulus: Review Article. Open Cardiovasc Med J. 2016 Nov 15;10:221-232.
3. Fujiwara M, Hatani Y, Fujimoto W, Yamashita S. Three Cases of Caseous Calcification of the Mitral Annulus Resulting in Spontaneous Fistulation. CASE (Phila). 2022 May 20;6(8):355-360.
4. De Hemptinne Q, de Cannière D, Vandenbossche JL. Cardiac calcified amorphous tumor: A systematic review of the literature. Int J Cardiol Heart Vasc. 2015 Jan 29;7:1-5.
5. Higashi H, Ohara T, Nakatani S, Hashimoto S et al. A case of caseous calcification of the mitral annulus: a potential source of embolic stroke. J. Cardiol Cases 2010;2(3):e141–3.
6. Chevalier B, Reant P, Laffite S et al. European Journal of Cardio-thoracic Surgery 39 (2011) e184—e185.
Andoni Fernández González, Amaia Martínez León y Amaia Loyola Arrieta


Figura 2: Ecocardiograma transesofágico.
A y B: necrTC (A, B, C) y PET 18F-FDG (D)
Figura 1: Ecocardiograma transesofágico.
A y B: necrosis licuefactiva (NL) del anillo mitral posterior (círculo) con imágenes móviles sugestivas de vegetación (flecha).
C y D: Insuficiencia mitral (IM) severa excéntrica por perforación/fistulización y desestructuración de calcificación caseosa del anillo mitral (CCAM).
A, B y C: CCAM con necrosis licuefactiva (NL) extensa involucrando miocardio inferior y velo posterior mitral, con solución de continuidad de la pared calcificada (flecha).
D: hipercaptación del área de NL (flecha).
II CLINIC CONTEST NAVARRA En Fibrilación
Auricular, Tromboembolismo Venoso asociado al Cáncer y Control de Dislipemia con Terapia Oral en el ámbito sanitario de Navarra
CASOS PRESENTADOS

Amaia Loyola Arrieta.
MIR. Cardiología. Marina Virosta Gil.
MIR. Cardiología. Andoni Fernández González.
MIR. Cardiología.
Hospital Universitario de Navarra (HUN).


Amaia Loyola Arrieta, Marina Virosta Gil y Andoni Fernández González
Varón de 49 años, con consumo ocasional de vino, exfumador (IPA 30 paquetes-años), ex usuario de drogas por vía parenteral (UDVP), con consumo habitual de heroína entre los 20 y los 25 años. Además, presenta antecedentes de hepatitis 1984 con serologías positivas para VHC y VHB, y negativa para VIH.
En junio de 2023, el paciente presenta durante varios días cuadro de febrícula, tiritona y dolor en región escapular, resistente a la analgesia convencional. A pesar de ello no consulta.
A finales de septiembre de 2023, comienza nuevamente con febrícula matutina asociada a dolor pleurítico izquierdo y clínica genitorurinaria. En esta ocasión consulta con su médico de Atención Primaria, quien realiza una radiografía de tórax en la que se objetiva un infiltrado en lóbulo inferior izquierdo (LII). Asimismo, se solicita urocultivo. Ante la sospecha de infección respiratoria se inicia tratamiento empírico con levofloxacino durante 9 días, quedando pendiente de resultados de urocultivo. El paciente presenta mejoría inicial, con recaída de la febrícula. En el urocultivo se aísla E. faecalis. Ante la falta de respuesta y el nuevo aislamiento microbiológico, se inicia tratamiento con amoxiclina-clavulánico. La evolución posterior es desfavorable con persistencia de la clínica, motivo por el cual acude a Urgencias. Se realiza nueva radiografía de tórax en la que se objetiva un nuevo infiltrado en LII. Analíticamente destaca una PCR de 225 mg/L, sin alteraciones en el hemograma. Se extraen hemocultivos que resultan negativos. Dada la sospecha de neumonía de un mes de evolución resistente a dos líneas de tratamiento antibiótico, se decide ingreso en Neumología para tratamiento intravenoso con Levofloxacino y Ceftriaxona.
Durante el ingreso, se amplía el estudio con las siguientes pruebas complementarias:
■ Ampliación analítica con dímero-D (DD): 756 ng FEU/mL.
■ Reacción en cadena de la polimerasa (PCR) virus respiratorios, Antígenos urinarios de Legionella y Neumococo, Esputo, Hemocultivos y urocultivos solicitados desde urgencia, Exudado nasofaríngeo PCR para Legionella, Mycoplasma, B. pertussis, B. parapertussis, Quantiferon. Todo ello negativo.
■ Autoinmunidad. Negativa.
II CLINIC CONTEST NAVARRA En Fibrilación Auricular, Tromboembolismo Venoso asociado al Cáncer y Control de Dislipemia con Terapia Oral en el ámbito sanitario de Navarra Tromboembolismo venoso asociado a cáncer
Ante valores elevados de DD, se realiza TAC-TEP que muestra datos compatibles con embolismo izquierdo asociado con infartos pulmonares e infiltrados sugestivos de patología inflamatoria-infecciosa (Figura 1).
Se inicia tratamiento anticoagulante con Enoxaparina 80 mg/12h subcutánea y se amplía el estudio con eco-doppler de extremidades inferiores que no muestra imágenes sugerentes de trombosis. Posteriormente, se solicita valoración por Hematología de cara a completar estudio por sospecha de neoplasia subyacente. En este sentido, se solicita eco-doppler cervical en el que no se identifican ganglios de tamaño significativo en cadenas ganglionares laterocervicales susceptibles de biopsia con aspiración de aguja fina.
El paciente presenta buena evolución con el tratamiento antiinfeccioso puesto desde Urgencias y el tratamiento anticoagulante añadido durante el ingreso. Finalmente, es dado de alta con bajo tratamiento con enoxaparina quedando pendiente de realizar PET de manera ambulatoria para búsqueda de neoplasia oculta. Dicha prueba objetiva que la afectación pulmonar parenquimatosa detectada por TAC, presenta una captación hipermetabólica en fase de resolución.
Con el propósito de esclarecer el origen de la patología pulmonar, se realiza una ecobroncoscopia en la que se recoge citología de aspirado bronquial y citología mediante lavado broncoalveolar. Ambas resultan negativas. Además, se puncionan adenopatías derechas e izquierdas en las que no se objetivan signos de malignidad.
Posteriormente, presenta un nuevo episodio de fiebre y dos días después dolor pleurítico derecho y disnea, acudiendo nuevamente a Urgencias. Desde el mismo, se extraen nuevos hemocultivos y se decide ingreso en Neumología con piperacilina-tazobactam de manera empírica. En el hemocultivo, esta vez se aísla E. faecalis. Se repite nuevo TAC en el que se describe consolidación en LID, opacidades nodulillares bilaterales y multilobares y lesión tisular parahiliar izquierda previa parcialmente cavitada.
Dado los hallazgos de lo que aparentan ser émbolos sépticos y la presencia de bacteriemia por E. faecalis (germen cardiotropo), se realiza interconsulta a Cardiología.
Como prueba inicial, se realiza ecocardiograma transtorácico que muestra (Figura 2) una imagen heterogénea móvil de hasta 26 mm
Amaia Loyola Arrieta, Marina Virosta Gil y Andoni Fernández González
anclada en el velo anterior tricuspídeo, que no compromete la funcionalidad de la válvula ni se extiende hacia estructuras vecinas. Dado el contexto clínico se interpreta como vegetación.
Con los hallazgos ecocardiográficos, se establece la sospecha principal de que los embolismos pulmonares son de origen séptico y no tromboembolismos, por lo que se decide de manera conjunta con el servicio Hematología suspender la anticoagulación.
Tras aislamiento de E. faecalis se plantea con principal puerta de entrada la vía digestiva y se amplía estudio con colonoscopia, en la que se hallan múltiples pólipos con distribución en racimos menores a un centímetro, que hacen sospechar de posible etiología inflamatoria. La anatomía patológica evidencia presencia de Linfoma folicular y en el estudio molecular se objetiva ruptura del gen BCL 2 (MC24-81), ausencia de ruptura del gen BCL 6 (MC24-82) y ausencia de reordenamiento del gen c-MYC (MC24-83). Ante dichos hallazgos, Hematología solicita una ampliación de estudio con TAC abdominal y PET para estratificación y valorar la necesidad de biopsia. Dichas pruebas complementarias no muestran hallazgos patológicos sugestivos de patología tumoral por lo que deciden seguimiento ambulatorio por su parte.
El paciente permanece estable, sin desarrollo de insuficiencia cardiaca ni datos clínicos que hicieran sospechar compromiso del funcionamiento valvular. Se realizan ecocardiogramas reglados de control que confirman normofunción valvular y, tras comprobar estabilidad clínica, es dado de alta con seguimiento en consultas.
Se nos presenta un paciente joven ex UDVP con un cuadro que inicialmente orienta a infección respiratoria sin aislamiento microbiológico (más allá del urinario) y con elevación del DD. Se decide realizar TC-TEP por si pudiera tratarse de una embolia pulmonar. Una vez obtenido el diagnóstico, se estudia el posible mecanismo subyacente. Por ello, tras descartar una trombosis venosa profunda mediante eco Doppler se procede a la búsqueda de un proceso neoplásico (síndrome febril resistente a antibioterapia, síndrome constitucional, nódulos pulmonares). Ante la negatividad de las pruebas complementarias y el aislamiento (meses después de la última toma de antibiótico) posterior en hemocultivos de E. faecalis (microorganismo incluido como criterio mayor para el diagnóstico de endocarditis infecciosa
II CLINIC CONTEST NAVARRA En Fibrilación Auricular, Tromboembolismo Venoso asociado al Cáncer y Control de Dislipemia con Terapia Oral en el ámbito sanitario de Navarra Tromboembolismo venoso asociado a cáncer
en las últimas guías de Endocarditis publicadas por la Sociedad Europea de Cardiología) finalmente se alcanza el diagnóstico definitivo. El caso pone de manifiesto la dificultad diagnóstica de una endocarditis que puede simular muchas otras afectaciones (tipo infecciosa, embolia pulmonar, neoplasia…).
Si bien la etiología más frecuente de embolia pulmonar es la causa trombótica, existen distintos tipos de materiales y células que pueden causarla (células tumorales, hematopoyéticas, bacterianas…). La embolia séptica está comúnmente relacionada con la endocarditis derecha y suele presentarse en pacientes con factores de riesgo para la misma como UDVP, portadores de catéteres y marcapasos. El aislamiento más frecuente suele ser S. Aureus si bien cada vez se aíslan con mayor frecuencia bacterias anaerobias gram positivas y negativas como en este caso.
1. Chahoud J, Sharif Yakan A, Saad H, Kanj SS. Right-Sided Infective Endocarditis and Pulmonary Infiltrates. Cardiology in Review. 2016;24(5):230–7.
2. Guía ESC 2019 para el diagnóstico y tratamiento de la embolia pulmonar aguda. Revista Española de Cardiología. 2020 Jun; 73(6): 497.e1–58
3. Nii T, Yoshikawa H, Okabe T, Tachibana I. Septic pulmonary and systemic embolism in tricuspid endocarditis. BMJ Case Rep. 2014 Nov 24;2014: bcr2014206569. doi: 10.1136/bcr-2014-206569. PMID: 25422337; PMCID: PMC4244345.



II CLINIC CONTEST NAVARRA En Fibrilación
Auricular, Tromboembolismo Venoso asociado al Cáncer y Control de Dislipemia con Terapia Oral en el ámbito sanitario de Navarra
CASOS PRESENTADOS

Marina De La Escosura Muñoz.
MIR. Neumología.
Ana José Martín Serrablo.
MIR. Neumología.
Hospital Universitario de Navarra (HUN).


UN TRATAMIENTO DEFINITIVO
De La Escosura Muñoz y Ana José Martín Serrablo
Varón de 58 años con antecedentes personales de interés de hipertensión arterial, hipercolesterolemia, obesidad tipo I, glucemia basal alterada, infarto agudo de miocardio en territorio inferior en 1994, poliposis adenomatosa tubular, enfermedad pulmonar obstructiva crónica, apnea obstructiva del sueño en grado moderado y fumador activo con un índice paquetes-año de 40.
En estudio por alta sospecha de tumor maligno a nivel de colon ascendente localizado. Se realiza una colonoscopia para diagnóstico con toma de biopsias de la lesión y durante el procedimiento se registra alteración en la tira de ritmo del electrocardiograma (ECG), con bradicardia, descenso de ST y T, visualizado en una derivación, sin ECG completo en ese momento, con desaturación hasta 84-85%.
Una vez el paciente se despierta del procedimiento se interroga sobre síntomas: vida activa sin disnea de esfuerzo, no episodios de dolor torácico. No refiere tos ni expectoración habituales ni procesos bronquiales frecuentes. No palpitaciones. No mareo ni síncope. En revisión de empresa previa refiere inflamación de piernas, sin datos aparentes de trombosis venosa (no empastamiento pantorrillas, no cordones venosos).
En la exploración se objetiva buen estado general, normocoloreado y normohidratado con tensión arterial mantenida, tendencia a taquicardia con 100 lpm, y saturación de O2 a 89% aire ambiente con exploración física normal a nivel cardiopulmonar y de extremidades inferiores (sin cordones venosos ni edemas). En el electrocardiograma se observa ritmo sinusal a 68 lpm con bloqueo de rama derecha y bloqueo auriculo-ventricular de 1º grado, conocido previamente.
Tras la valoración por Anestesia durante el procedimiento endoscópico, se decide valoración en Urgencias e ingreso a cargo de Neumología por insuficiencia respiratoria aguda.
Durante su estancia en la planta de hospitalización, el paciente permanece estable hemodinámicamente, se realiza angioTAC, que revela un defecto de repleción en arteria pulmonar derecha que impresiona de aspecto crónico, por lo que se inicia anticoagulación a dosis terapéuticas y se solicita ecocardiograma, objetivándose dilatación del ventrículo derecho con datos de hipertensión arterial pulmonar (PSAP=64 mmHg).
II CLINIC CONTEST NAVARRA En Fibrilación Auricular, Tromboembolismo Venoso asociado al Cáncer y Control de Dislipemia con Terapia Oral en el ámbito sanitario de Navarra Tromboembolismo venoso asociado a cáncer
Al alta, se realiza seguimiento ambulatorio en consulta monográfica de Circulación Pulmonar y se inicia anticoagulación oral hasta completar el estudio de su enfermedad tromboembólica. Al mismo tiempo, se ha completado el diagnóstico de la lesión intestinal, siendo un carcinoma colorrectal estadio II tratado durante esos meses con colectomía parcial junto con linfadenectomía locorregional, y seguimiento mediante pruebas de imagen. Tras 6 meses de anticoagulación oral, se solicita gammagrafía de ventilación-perfusión, que objetiva defectos de perfusión parcheados.
Para el estudio hemodinámico se solicita cateterismo cardiaco derecho, que revela parámetros compatibles con hipertensión precapilar (PAP media 45mmHg PCP 12mmHg RVP5uW) y se confirma así el diagnóstico de hipertensión pulmonar tromboembólica crónica (HPTEC). Se deriva a la Unidad Multidisciplinar de Hipertensión Tromboembólica Crónica del Hospital 12 de Octubre (centro de referencia a nivel nacional), donde se realiza tromboendarterectomía pulmonar, mejorando los parámetros hemodinámicos y resolviéndose así la hipertensión pulmonar con gran mejoría clínica.
La American Society of Clinical Oncology (ASCO) y la National Comprehensive Cancer Network (NCCN) recomiendan la profilaxis antitrombótica en pacientes con cáncer con riesgo alto de enfermedad tromboembólica venosa (ETEV), como por ejemplo en aquellos pacientes que requieren cirugía, quimioterapia o con alto riesgo ambulatorio determinado por herramientas de evaluación de riesgo como la escala de Khorana. En pacientes con cáncer colorrectal confirmado, la profilaxis antitrombótica se recomienda en el contexto perioperatorio y en pacientes ambulatorios de alto riesgo, tanto con heparina de bajo peso molecular (HBPM) como anticoagulantes orales inhibidores del factor Xa (Rivaroxabán y Apixabán). Sin embargo, no está clara la indicación de anticoagulación profiláctica en pacientes en estudio de una sospecha de neoplasia maligna colorrectal antes de confirmarse, pero la evidencia actual dice que no es necesario iniciar profilaxis antitrombótica, a pesar de ser un tipo de tumor que aumenta significativamente el riesgo de trombosis y que contribuye a la morbilidad y mortalidad. Se recomienda individualizar cada caso evaluando el riesgo hemorrágico y trombótico en consulta ambulatoria, pero hacen falta más estudios que apoyen estas afirmaciones.
UN TRATAMIENTO DEFINITIVO
Marina De La Escosura Muñoz y Ana José Martín Serrablo
Por otro lado, la HPTEC es una enfermedad rara y poco frecuente. Entre el arsenal terapéutico encontramos los anticoagulantes, la tromboendarterectomía pulmonar (TEA), angioplastia con balón y los vasodilatadores (riociguat). El tratamiento específico de la enfermedad tromboembólica crónica debe ser evaluado en centros especializados por equipos multidisciplinares. La TEA es considerado el único tratamiento curativo, y además es el único tipo de hipertensión pulmonar que se puede resolver con tratamiento. La elección de los pacientes que pueden ser sometidos a esta técnica deriva de parámetros del paciente, de la localización del trombo (central y accesible) y de la repercusión hemodinámica (medido mediante cateterismo cardiaco por resistencias vasculares). En nuestro caso, el paciente cumplía todos los criterios, por lo que se intervino, resolviéndose así la hipertensión pulmonar.
Es importante destacar la importancia de la valoración tanto en el momento agudo como realizar un seguimiento ambulatorio posterior para predecir la posible repercusión a nivel hemodinámico y diagnosticar esta rara enfermedad.
II CLINIC CONTEST NAVARRA En Fibrilación Auricular, Tromboembolismo Venoso asociado al Cáncer y Control de Dislipemia con Terapia Oral en el ámbito sanitario de Navarra Tromboembolismo venoso asociado a cáncer
1. Kimpton M, Carrier M. What’s New in the Prevention and Treatment of Cancer-Associated Thrombosis. Hematology. American Society of Hematology. Education Program. 2019;2019(1):158-166.
2. Papadopoulos V, Tsapakidis K, Markou A, et al. New Prophylaxis Strategies to Reduce the Risk of Thromboembolism in Cancer. Expert Review of Anticancer Therapy. 2021;21(10):1135-1144.
3. Lyman GH, Carrier M, Ay C, et al. American Society of Hematology 2021 Guidelines for Management of Venous Thromboembolism: Prevention and Treatment in Patients With Cancer. Blood Advances. 2021;5(4):927974.
4. Streiff MB, Holmstrom B, Angelini D, et al. Cancer-Associated Venous Thromboembolic Disease, Version 2.2021, NCCN Clinical Practice Guidelines in Oncology. Journal of the National Comprehensive Cancer Network : JNCCN. 2021;19(10):1181-1201.
5. Key NS, Khorana AA, Kuderer NM, et al. Venous Thromboembolism Prophylaxis and Treatment in Patients With Cancer: ASCO Guideline Update. Journal of Clinical Oncology : Official Journal of the American Society of Clinical Oncology. 2023;41(16):3063-3071.
6. Guía ESC 2019 para el diagnóstico y tratamiento de la embolia pulmonar aguda. Grupo de Trabajo de la Sociedad Europea de Cardiología (ESC) para el diagnóstico y tratamiento de la tromboembolia pulmonar aguda. Rev Esp Cardiol. Disponible en: https://doi.org/10.1016/j.recesp.2019.12.030
7. López Gude, MJ. Pérez de la Sota, E et al. Tromboendarterectomía pulmonar en 106 pacientes con hipertensión pulmonar tromboembólica crónica. Disponible en: https://www. archbronconeumol.org/es-tromboendarterectomia-pulmonar106-pacientes-con-articuloS030028961400461X#:~:text=La%20 tromboendarterectom%C3%ADa%20pulmonar%20ofrece%20resultados,la%20mayor%C3%ADa%20de%20los%20pacientes.
UN TRATAMIENTO DEFINITIVO
Marina De La Escosura Muñoz y Ana José Martín Serrablo

1: Gammagrafía ventilación-perfusión pulmonar. Defectos de perfusión parcheados.
II CLINIC CONTEST NAVARRA En Fibrilación
Auricular, Tromboembolismo Venoso asociado al Cáncer y Control de Dislipemia con Terapia Oral en el ámbito sanitario de Navarra
CASOS PRESENTADOS

Ariadna Setuain Indurain.
MIR. Medicina Interna. Amaia Torrecilla Ugarte.
MIR. Medicina Interna.
Hospital Universitario de Navarra (HUN).


Ariadna Setuain Indurain y Amaia Torrecilla Ugarte
Varón de 85 años, que acude a urgencias por disnea de reposo sin otra causa aparente. Niega dolor torácico o palpitaciones. Afebril. Ausencia de tos o expectoración. No esputos hemoptoicos ni edemas en extremidades. Sin otra clínica en la anamnesis por aparatos.
Antecedentes:
Celiaquía; Depresión; Lumbalgia; Diverticulosis colónica; Carcinoma basocelular extirpado; Déficit de vitamina b12; Facoemulsificación del ojo derecho implante de lente intraocular; Rotura completa de los tendones del manguito rotador. Bursitis subacromio-subdeltoidea; No hábitos tóxicos. Sin alergias conocidas.
ENFERMEDAD ACTUAL
Presenta disnea de reposo sin otra causa aparente. Habitualmente lleva una vida activa, camina todos los días sin angina ni disnea de esfuerzo. Niega síncope, mareo o palpitaciones asociadas.
No ha objetivado aumento de peso los últimos días. Por el contrario, refiere pérdida involuntaria de peso los últimos meses. No disminución del ritmo de diuresis o edemas en extremidades.
Tiene algo de tos seca. Sin esputos hemoptoicos ni fiebre termometrada.
No cefalea. Refiere hiporexia. Sin naúseas ni vómitos. Niega disfagia, disfonia o adenopatías objetivadas. Ritmo deposicional preservado. Sin sangre ni productos patológicos. Ausencia de síndrome miccional.
Exploración física
Constantes: Presión arterial 163/ 84 mmHg, frecuencia cardiaca 71 latidos por minuto (lpm), temperatura de 36,4ºC, saturación basal de 89%.
- General: Aceptable estado general. Ausencia de ingurgitación yugular. Normocoloreado. Normohidratado. Eupneico en reposo.
- Auscultación cardiaca: Rítmica sin soplos.
- Auscultación pulmonar: Buena ventilación sin ruidos sobreañadidos.
- Abdomen: Blando, depresible, no doloroso a la palpación. Sin irritación peritoneal. Peristaltismo de progresión.
II CLINIC CONTEST NAVARRA En Fibrilación Auricular, Tromboembolismo Venoso asociado al Cáncer y Control de Dislipemia con Terapia Oral en el ámbito sanitario de Navarra Tromboembolismo venoso asociado a cáncer
- Neurológico: Consciente, orientado. Lenguaje fluente. Sin focalidad neurológica.
- Extremidades: Ausencia de edemas, no datos de trombosis venosa profunda, normoperfundido.
Pruebas complementarias
- Electrocardiograma (ECG): ritmo sinusal FC 71 lpm. PR corto. QRS estrecho. Sin alteraciones de la repolarización.
- Radiografía de tórax: Índice cardiotorácico preservado. Pinzamiento del seno costofrénico derecho. Izquierdo libre. Opacidades pseudonodulares en lóbulo inferior izquierdo. Sin alteraciones en el marco óseo.
- Analítica de sangre: Discreta leucocitosis. INR 1,24. Fibrinógeno 781 mg/dl. Dímero D 5430 ng/ml. Función renal preservada. Troponinas 44,6 pg/ml. Na 132 mmol/L. PCR 123 mg/L. NT proBNP 773 pg/ml
- Angio TAC: Múltiples defectos de repleción centrales en la luz de arterias lobares, segmentarias y subsegmentarias bilaterales en relación con TEP agudo. Tronco pulmonar de calibre aumentado (35 mm), sin observar signos de sobrecarga de cavidades derechas. Además, presenta una neoplasia pancreática con probable afectación metastásica hepática y pulmonar. Área densa en cuerpo vertebral de D11 que podría estar en relación con metástasis en el contexto actual.
En la primera valoración en Urgencias se calcula la probabilidad clínica pretest. En este caso con el score de Ginebra (+1 punto por >65 años) se clasificaría como probabilidad baja. Calculándolo con el score de Wells (+3 puntos; sin diagnóstico alternativo), recibiría una probabilidad intermedia. Ante una probabilidad clínica baja-intermedia se solicitan una radiografía de tórax, electrocardiograma y una analítica con dímero D.
En la analítica destaca un Dímero D 5430 ng/ml. Ante la disnea sin otra causa aparente y elevación del dímero D, se solicita un angio TAC. En el angio TAC presenta: múltiples defectos de repleción centrales en la luz de arterias lobares, segmentarias y subsegmentarias bilaterales en relación con TEP agudo. Tronco pulmonar de calibre aumentado (35 mm), sin observar signos de sobrecarga de cavidades derechas.
Ariadna Setuain Indurain y Amaia Torrecilla Ugarte
Además, presenta una neoplasia pancreática con probable afectación metastásica hepática y pulmonar. Área densa en cuerpo vertebral de D11, que podría estar en relación con metástasis en el contexto actual.
Se calcula la escala de Pulmonary Embolism Severity Index (PESI) 145 (85 años, cáncer, varón, saturación <90%) clase V riesgo elevado. Según la clasificación de embolia de pulmón y riesgo de muerte precoz de las guías de la Sociedad Europea de Cardiología, sería un TEP de riesgo intermedio-bajo. Ingresa en planta con tratamiento con Heparina de bajo peso molecular (HBPM) ajustada a peso Enoxaparina 80 mg/12h subcutánea.
DISCUSIÓN
Este caso clínico vuelve a mostrar la estrecha relación que existe entre la enfermedad tromboembólica venosa (ETV) y la neoplasia oculta.
El cáncer multiplica por 6-10 veces la incidencia de ETV, que constituye un factor pronóstico desfavorable independientemente en los pacientes oncológicos.
Un episodio de ETV puede ser la primera manifestación de una neoplasia oculta hasta en un 10% de los casos. Sin embargo, las guías actuales no recomiendan hacer un cribado a todos los pacientes con ETV no provocada.
La recomendación actual es hacer una anamnesis dirigida, una exploración física minuciosa y solicitar las pruebas complementarias en base a nuestra sospecha diagnóstica. Se recomienda seguir los cribados poblacionales establecidos en cada región.
Hay que tener en cuenta, en caso de recurrencia tromboembólica a pesar del tratamiento anticoagulante, trombosis venosa en el territorio esplácnico o cerebral se deberá descartar un síndrome mieloproliferativo crónico con la mutación de JAK2 V617F en sangre periférica.
En pacientes con trombosis esplácnica y signos de aplasia o hemólisis y en casos de síndrome de Budd-Chiari se recomienda descartar HPN mediante citometría de sangre periférica.
II CLINIC CONTEST NAVARRA En Fibrilación Auricular, Tromboembolismo Venoso asociado al Cáncer y Control de Dislipemia con Terapia Oral en el ámbito sanitario de Navarra Tromboembolismo venoso asociado a cáncer
1. Konstantinides S V., Meyer G, Bueno H, et al. 2019 ESC Guidelines for the diagnosis and management of acute pulmonary embolism developed in collaboration with the European respiratory society. Eur Heart J. 2020;41(4):543-603. doi:10.1093/eurheartj/ehz405
2. Penaloza A, Verschuren F, Meyer G, et al. Comparison of the unstructured clinician gestalt, the wells score, and the revised Geneva score to estimate pretest probability for suspected pulmonary embolism. Ann Emerg Med. 2013;62(2):117-124.e2. doi: 10.1016/j.annemergmed.2012.11.002
3. Timp JF, Braekkan SK, Versteeg HH, Cannegieter SC. Epidemiology of cáncer associated venous thrombosis. Blood 2013; 122: 1712-23.
4. Sørensen HT, Mellemkjaer L, Olsen JH, Baron JA. Prognosis of cancers associated with venous thromboembolism. N Engl J Med 2000; 343: 184650.
5. Delluc A, Antic D, Lecumberri R, Ay C, Meyer G, Carrier M. Occult cancer screening in patients with venous thromboembolism: guidance from the SSC of the ISTH. J Thromb Haemost 2017; 15: 2076-2079.
6. Lobo JL, Alonso S, Arenas J, et al. Consenso multidisciplinar para el manejo de la tromboembolia de pulmón. Arch Bronconeumol. 2021;(xx):19. doi:10.1016/j. arbres.2021.01.031
II CLINIC CONTEST NAVARRA En Fibrilación
Auricular, Tromboembolismo Venoso asociado al Cáncer y Control de Dislipemia con Terapia Oral en el ámbito sanitario de Navarra
CASOS PRESENTADOS
GRAVE EN PACIENTE
MUTACIÓN ONCOGENÉTICA
SUSCEPTIBLE DE TERAPIA ONCOLÓGICA DIRIGIDA

José Juan Illarramendi Mañas. Oncología Médica. Emilio Gomez Arteta. Hematología.
Jorge Illarramendi Esteban. MIR. Hematología.
Hospital Universitario de Navarra (HUN).

II CLINIC CONTEST NAVARRA En Fibrilación Auricular, Tromboembolismo Venoso asociado al Cáncer y Control de Dislipemia con Terapia Oral en el ámbito sanitario de Navarra Tromboembolismo venoso asociado a cáncer
Mujer nacida en junio de 1967. Exfumadora. Hepatopatía crónica por virus con respuesta mantenida tras tratamiento antiviral. Hernia discal. Variante patogénica por deleción en el gen BRCA2 (6503delTT).
Historia oncológica:
Intervenida, en marzo de 2003, mediante cuadrantectomía + linfadenectomía axilar por carcinoma ductal infiltrante, estadio pT1N0M0. Recibió tratamiento adyuvante con hormonoterapia y radioterapia. Diagnosticada de metástasis ósea, en septiembre de 2020, con afectación amplia en columna vertebral y calota, extendiéndose a la duramadre. Comenzó una primera línea de tratamiento estándar con Palbociclib y Letrozol sin beneficio clínico, continuándose con Capecitabina. Tras un ingreso en planta por panmucositis grado 3 con sobreinfección por herpes simplex 2 e hiponatremia, la paciente es derivada, en noviembre de 2021, a un hospital de cuidados paliativos para soporte y potencial recuperación funcional.
El 14/01/22 es trasladada a Urgencias del hospital de agudos de referencia por disnea paroxística, con sospecha de tromboembolismo pulmonar (TEP) y anotación de “paciente no apta para reanimación cardiopulmonar”.
Exploración:
Destaca la taquicardia (134 lpm) y taquipnea (32 rpm). Tensión arterial: 100/61 mm Hg. Saturación O2: 94% (con mascarilla de reservorio). Crepitantes basales.
Analítica:
Destacamos las cifras de fibrinógeno (1052 mg/dl) y dímero D de la fibrina (10782 ng FEU/ml). pO2: 57 mmHg.
Electrocardiograma:
Taquicardia sinusal. QRS estrecho con patrón S1Q3T3.
Ecocardiograma:
Pésima ventana. Importante dilatación y disfunción ventricular derecha, con severa hipocinesia de pared lateral. PSAP de al menos 5054 mmHg. Dilatación de vena cava con colapso parcial, inferior al 50%.
José Juan Illarramendi Mañas, Emilio Gomez Arteta y Jorge Illarramendi Esteban
TAC Torácico (Figura 1):
No factible de realizar en Urgencias, dada la inestabilidad de la paciente. TEP agudo bilateral, con defecto de repleción en ramas lobares de arterias pulmonares bilaterales, con extensión a ramas segmentarias. Calibre aumentado de arteria pulmonar principal (3,6 cm), con aumento de cavidades cardíacas derechas y relleno de vena cava y arterias suprahepáticas. Condensación en lóbulo superior izquierdo, sugestiva de infarto pulmonar. Condensaciones basales con atelectasia de lóbulo inferior izquierdo, sin poder descartarse componente de infarto.
Tratamiento:
Diagnóstico de TEP clase V, PESI 144 puntos. Valoradas de forma multidisciplinar la situación y opciones existentes, se optó por tratamiento endovenoso con Heparina sódica (bolo lento de 4000 UI, seguido de perfusión continua a 900 UI/h, con ajustes posteriores). Una vez constatada la mejoría se cambió a Enoxaparina subcutánea. Durante el ingreso recibió también tratamiento de soporte, incluyendo diuréticos y corticoterapia. Como apoyo respiratorio se realizó oxigenoterapia de alto flujo (OAF) a 60-70 litros/minuto. Precisó posterior traslado a la Unidad COVID, tras detectarse sobreinfección por SARSCoV-2. Una vez conseguida la estabilización y mejoría de la paciente, pudo ser dada de alta tras 17 días de ingreso.
EVOLUCIÓN Y SITUACIÓN ACTUAL
Se ha continuado la anticoagulación, sustituyéndose la enoxaparina por anticoagulante oral de acción directa que sigue en la actualidad, con buena tolerancia y sin complicaciones. Ha continuado asimismo tratamiento oncológico sistémico con quimioterapia, destacándose la excelente respuesta y tiempo sin progresión conseguido con un derivado del platino (carboplatino), al que son especialmente sensibles las pacientes con mutaciones en el gen BRCA. No se ha podido administrar tratamiento dirigido con Olaparib, al tener resolución negativa de financiación en España para enfermedad metastática. Tras más de 3 años de seguimiento (mayo de 2025), la paciente hace vida ambulatoria, continúa tratamiento de quimioterapia y no ha vuelto a presentar ningún otro proceso tromboembólico.
II CLINIC CONTEST NAVARRA En Fibrilación Auricular, Tromboembolismo Venoso asociado al Cáncer y Control de Dislipemia con Terapia Oral en el ámbito sanitario de Navarra Tromboembolismo venoso asociado a cáncer
La incidencia y manejo de tromboembolismos venosos (TEV) en pacientes con tumores sólidos que presentan mutaciones (u otras alteraciones moleculares) en genes susceptibles de beneficiarse de los últimos avances en terapias dirigidas contra dichas alteraciones, es un tema de importante actualidad sobre el que se han publicado revisiones recientemente. Se considera concluyentemente validado en ellas un aumento en el riesgo de TEV para tumores con reordenamientos en los genes ALK y ROS1, existiendo cierta evidencia también para las mutaciones en RET, RAS y otros genes (1) (2).
Los genes BRCA1 y BRCA2 tienen una gran importancia en la transmisión hereditaria de la susceptibilidad a los cánceres de mama, ovario, próstata, páncreas y de otras localizaciones. Algunos estudios indican que la producción de proteínas procoagulantes podría ser un factor oncogenético importante en pacientes con mutaciones en el gen BRCA2 (3), aunque otros estudios no han demostrado un aumento en la incidencia de TEV en estos pacientes (4). El estado mutacional de BRCA se ha incorporado a modelos predictivos de embolia pulmonar en pacientes sometidas a reconstrucción mamaria (5) y el tratamiento dirigido con inhibidores de PARP podría aumentar el riesgo de TEV en pacientes con mutaciones en BRCA (6).
El contexto de cuidados paliativos, tanto en pacientes que siguen terapia oncológica activa como en pacientes terminales, representa una situación especial para la evaluación y tratamiento de pacientes con TEV (7). Resulta importante considerar que los pacientes diagnosticados de tumores sólidos con mutaciones u otras alteraciones moleculares accionables pueden tener respuestas extraordinarias y mantenidas a las terapias dirigidas aún en el contexto de deterioro del estado general que precise de soporte paliativo concurrente. Esto se denomina efecto o respuesta Lazarus. Existen casos publicados en este sentido, como el de un paciente afecto de carcinoma de pulmón con reordenamiento de ROS1 que presentó TEV con TEP grave recurrente, tratado con heparina no fraccionada, y excepcional respuesta a la terapia dirigida con Crizotinib en el Istituto Nazionale di Tumori de Milán (8). Resultan obvias las potenciales reflexiones bioéticas sobre ello (9), tal y como ilustra el caso que presentamos.
1. Lanting V, Oskam M, Wilmink H, Kamphuisen PW, Van Es N. The role of germline and somatic mutations in predicting cancer-associated thrombosis: a narrative review. Curr Opin Hematol 2025; 32: 138-145.
2. Pelegrin-Mateo FJ, Beato Zambrano C, Brozos Vázquez E, Garcia Escobar I, Muñoz Martín A. Cancer genetic profile and risk of thrombosis. Eur J Intern Med 2025 Apr 11 doi: 10-1016/j.ejim.2024.04.004.
3. Pérez-Segura P, Zamorano-León JJ, Acosta D, et al. BRCA2 gene mutations and coagulation-associated biomarkers. Thromb Haemost 2016; 115: 415-423.
4. Muñoz AJ, De Toro M, Ortega L, et al. Venous thromboembolism incidence in cancer patients with germline BRCA mutations. Clin Transl Oncol 2022; 24: 154-158.
5. Enajat M, Dam T, Geenen A, Timman R, Van Der Hulst R, Mureau M. Pulmonary embolism after abdominal flap reconstruction. Prediction and prevention. Plast Recontr Surg 2013; 131: 1213-1222.
6. Maiorano A, Catalano M, Mercinelli C, et al. Incidence and risk of thromboembolic and cardiovascular adverse events with PARP inhibitor treatment in patients with metastatic castration-resistant prostate cancer: A systematic review and safety meta-analysis. Eur Urol Sci 2025; 72: 1-9.
7. Debourdeau P, Severstre MA, Bertoletti L, et al. Treatment of cancerassociated thromboembolism in patients under palliative care. Arch Cardiovasc Dis 2024; 117: 94-100.
8. Beninato T, Lo Russo G, Garassino MC, De Braud F, Platania M. Recurrent thrombosis followed by Lazarus response in ROS1 rearranged NSCLC treated with crizotinib; a case report. Tumori 2020; 106: NP41-NP45.
9. Perumalswami CR, Jagsi R, Goold SD. Predicting a “Lazarus effect” in patients with advanced cancer near the end of life: prognostic uncertainty, oncologists´emotions, and ethical questions. Am J Bioeth 2019; 19: 57-60.
II CLINIC CONTEST NAVARRA En Fibrilación Auricular, Tromboembolismo Venoso asociado al Cáncer y Control de Dislipemia con Terapia Oral en el ámbito sanitario de Navarra Tromboembolismo venoso asociado a cáncer

II CLINIC CONTEST NAVARRA En Fibrilación
Auricular, Tromboembolismo Venoso asociado al Cáncer y Control de Dislipemia con Terapia Oral en el ámbito sanitario de Navarra
CASOS PRESENTADOS

Marina Segur García. Cardiología.
Hospital Universitario de Navarra (HUN).

II CLINIC CONTEST NAVARRA En Fibrilación Auricular, Tromboembolismo Venoso asociado al Cáncer y Control de Dislipemia con Terapia Oral en el ámbito sanitario de Navarra Tromboembolismo venoso asociado a cáncer
Paciente de 54 años, exfumador desde hace 2 años (índice paquetes-año 80) y dislipémico en tratamiento hipolipemiante.
Diagnosticado hace 4 meses, tras realizarse estudio por síndrome constitucional de varios meses de evolución, de un adenocarcinoma de la unión gastroesofágica estadio IV con múltiples adenopatías locorregionales y retroperitoneales, bajo tratamiento quimioterápico con Fluorouracilo, Leucovorina, Oxaliplatino y Docetaxel (FLOT) con respuesta inicial favorable.
Consulta en su Centro de Salud por cuadro de dolor en extremidad inferior derecha, a nivel gemelar, de 2 días de evolución, con edematización, enrojecimiento y aumento de temperatura de la misma. Al ir a tumbarse en la camilla de la consulta, comienza con dolor súbito centrotorácico opresivo no irradiado acompañado de sudoración profusa y sensación nauseosa, sin llegar a vomitar. Mantiene estabilidad hemodinámica en todo momento, objetivándose en electrocardiograma (ECG) isquemia transmural ínfero-posterior.
En este contexto se activa código infarto trasladándose al paciente a su hospital de referencia con disponibilidad de servicio de hemodinámica. A su llegada a Urgencias, el dolor torácico ha cedido y el ECG ha normalizado transcurridos no más de 15 minutos desde el inicio de los síntomas (Figura 1).
Sin embargo, al realizar el cambio de camilla, el paciente presenta súbitamente disfasia y hemiplejia derecha. Tras la valoración pertinente se decide completar el estudio con angiografía por tomografía computarizada (TAC) torácica y cerebral, siendo diagnosticado de tromboembolismo pulmonar (TEP) central con afectación bilateral, aunque prodominantemente de arteria pulmonar derecha, con repercusión sobre cavidades derechas, objetivándose además como hallazgo, una imagen compatible con trombo acabalgado a nivel interauricular (Figura 2).
Arterias coronarias valoradas por esta técnica sin lesiones y estudio cerebral anodino sin evidencia de ictus agudo. Tras finalizar estas pruebas de imagen se constata completa resolución espontánea de la clínica neurológica presentada previamente (duración máxima de 20 minutos), sin secuelas.
A partir de este momento el paciente mantuvo estabilidad clínica y hemodinámica en todo momento sin presentar nuevas alteraciones agudas de la repolarización ni síntomas neurológicos. El ecocar-
diograma transtorácico (ETT) objetivó dilatación y disfunción sistólica moderada-severa del ventrículo derecho con una presión sistólica pulmonar estimada de 45 mmHg, resto del estudio anodino. A continuación, se realizó ecocardiograma transesofágico (ETE) que confirmó la presencia de una imagen filamentosa sugestiva de gran trombo moviéndose libremente entre ambas aurículas a través de un foramen oval permeable (FOP) (Figura 3).
Se realizó ecografía-doppler a pie de cama de miembros inferiores confirmándose trombosis venosa profunda (TVP) de la vena poplítea derecha.
Ante dichos hallazgos de interpreta el cuadro como TVP complicada con TEP y embolia paradójica a nivel coronario y cerebral de trombo en tránsito a través de FOP.
En vista de todo lo previamente mencionado, teniendo en cuenta la edad del paciente y la respuesta favorable a la primera línea de tratamiento quimioterápico, se decidió intervención quirúrgica urgente. Se realizó, mediante atriotomía derecha, trombectomía en aurícula derecha y aurícula izquierda con ampliación de FOP para la extracción del trombo íntegro, seguido de cierre del mismo mediante sutura directa (Figura 4).
También se realizó trombectomía de la arteria pulmonar derecha a través de arteriotomía longitudinal de la misma entre la cava superior y la aorta. Salida de bomba sin incidencias y con resultado en ETE intraoperatorio satisfactorio.
El postoperatorio inmediato en la Unidad de Cuidados Intensivos cursó sin complicaciones, con extubación precoz, permaneciendo el paciente estable hemodinámicamente sin apoyo vasoactivo. La estancia hospitalaria total fue de 10 días, sin complicaciones significativas y con control ecocardiográfico correcto. El paciente fue dado de alta con anticoagulación oral crónica y derivado para completar estudio ambulatorio de trombofilia, que finalmente fue negativo, achacándose el origen del cuadro descrito a la procoagulabilidad propia de las neoplasias activas, como la presentada por el paciente.
El estado protrombótico en pacientes con cáncer es una condición bien documentada y multifactorial que aumenta significativamente el riesgo de eventos tromboembólicos, tanto venosos como arteriales. Este estado es el resultado de una compleja interacción entre las
II CLINIC CONTEST NAVARRA En Fibrilación Auricular, Tromboembolismo Venoso asociado al Cáncer y Control de Dislipemia con Terapia Oral en el ámbito sanitario de Navarra Tromboembolismo venoso asociado a cáncer
células tumorales y el sistema hemostático del huésped, mediada por la producción de proteínas procoagulantes, citoquinas inflamatorias y la activación de células del huésped como las células endoteliales, los monocitos y las plaquetas.
Si a esta condición se le suma la presencia de un FOP, se puede llegar a producir la denominada embolia paradójica, una entidad poco frecuente, pero con un alto riesgo de morbimortalidad que consiste en el paso de un coágulo o partícula embólica desde la circulación venosa a la circulación arterial a través de un cortocircuito de derecha a izquierda a través de un defecto septal auricular, siendo el FOP la causa más común.
La escasa incidencia de este tipo de cuadro clínico supone un reto diagnóstico y terapéutico y la actuación debe ser urgente por el alto riesgo de complicaciones, de ahí el interés de este caso clínico.
Debido a la escasa frecuencia de esta entidad, las opciones terapéuticas óptimas no están claramente definidas ya que la mayoría de evidencia clínica disponible en este campo se basa en estudios observacionales con un número limitado de pacientes. Existe consenso de que la ETE resulta esencial para confirmar el diagnóstico y orientar hacia la mejor estrategia de manejo. Las estrategias terapéuticas más utilizadas en la actualidad son la cirugía, la anticoagulación y la trombólisis, siendo la presentación y la estabilidad clínica del paciente determinantes para la elección del tratamiento más adecuado. Generalmente se prefiere la cirugía (consistente en trombectomía y cierre del FOP o defecto septal existente) a la trombólisis o a la anticoagulación, dado que estas últimas pueden desencadenar una fragmentación del trombo, favoreciendo un aumento del riesgo de embolismos sistémicos recurrente.
De este modo, conforme a la evidencia disponible en la actualidad, se apoya la elección del tratamiento quirúrgico como primera opción en pacientes hemodinámicamente estables, como el paciente del caso presentado, reservando la anticoagulación simple como segunda opción, especialmente en aquellos pacientes con elevada comorbilidad. Por último, la trombólisis estaría indicada en aquellos pacientes con inestabilidad hemodinámica en los que no se puede realizar trombectomía quirúrgica a sabiendas de que asocia una mayor mortalidad e incidencia de embolismos sistémicos.


Figura 1: ECG en Centro de Salud (izda) y ECG a la llegada a Urgencias, con cese espontáneo de síntomas (dcha).

Figura 2: Angiografía por tomografía computarizada (TAC) torácica y cerebral.
II CLINIC CONTEST NAVARRA En Fibrilación Auricular, Tromboembolismo Venoso asociado al Cáncer y Control de Dislipemia con Terapia Oral en el ámbito sanitario de Navarra Tromboembolismo venoso asociado a cáncer


II CLINIC CONTEST NAVARRA En Fibrilación
Auricular, Tromboembolismo Venoso asociado al Cáncer y Control de Dislipemia con Terapia Oral en el ámbito sanitario de Navarra
CASOS PRESENTADOS

Marina De La Escosura Muñoz.
MIR. Neumología.
Andrea Téllez Lorenzo.
MIR. Neumología.
José Alberto Espinoza Pérez. Neumología.
Hospital Universitario de Navarra (HUN).

II CLINIC CONTEST NAVARRA En Fibrilación Auricular, Tromboembolismo Venoso asociado al Cáncer y Control de Dislipemia con Terapia Oral en el ámbito sanitario de Navarra Tromboembolismo venoso asociado a cáncer
Mujer de 68 años acude al servicio de Urgencias por cuadro de disnea grado 3-4 de la mMRC, de una semana de evolución.
Antecedentes:
Hipertensión arterial; síndrome mielodisplásico (displasia multilínea: necesidad de transfusiones sanguíneas), en seguimiento activo por parte de Hematología.
ENFERMEDAD ACTUAL
Cuadro clínico caracterizado por disnea de mínimos esfuerzos, acompañada de sensación de mareos, dolor de miembro inferior izquierdo con aumento del diámetro con respecto a contralateral y calor local. Se solicitan ecografía doppler de miembros inferiores con diagnóstico de trombosis venosa profunda (TVP) a poplíteo y femoral, angioTAC con tromboembolia pulmonar (TEP) en ambas arterias pulmonares (principalmente en la izquierda), arterias lobares y segmentarias bilaterales.
Ingresa en Medicina Interna con el diagnóstico de TEP agudo de intermedio-bajo riesgo, según la escala de ESC 2019. Se inicia la anticoagulación.
En ecocardiograma transtorácico (ETT) presenta dilatación ventricular derecha, ventrículo izquierdo no dilatado FEVI normal, insuficiencia tricúspidea moderada y PSAP: 55 mmHg. Se da el alta con anticoagulación oral con Acenocumarol.
Continua en seguimiento por Hematología (octubre-noviembre 2017). A destacar molestias en la extremidad inferior izquierda, se indica tratamiento con medias compresivas con buena respuesta.
En revisión de julio 2018 presenta astenia y disnea progresiva de semanas de evolución, en ese momento grado 2 de la mMRC. Por tal motivo es remitida desde Hematología a la consulta de Circulación Pulmonar de Neumología.
Se inicia estudio de la disnea con pruebas funcionales respiratorias (FVC 89%; FEV1/FVC 79%, FEV1 86%), ecografía doppler (septiembre/18) de miembros inferiores con trombosis residual (desde femoral común hasta troncos infrapoplíteos) y en ETT: IT moderada con PSAP estimada de 85 mmHg y aurículas no dilatadas.
INUSUAL
Marina De La Escosura Muñoz, Andrea Téllez Lorenzo y José Alberto Espinoza Pérez
Ante la sospecha de hipertensión pulmonar tromboembólica crónica (HPTEC) se solicita angioTAC torácico. En agosto 2018 (15 meses tras evento agudo), presenta trombosis crónica bilateral y signos de hipertensión arterial, además de adenopatías mediastínicas y persistencia del aumento del tamaño de la rama lobar inferior (izquierda) con signos TEP agudo (morfología abombada que obliga a descartar afectación tumoral por tumor intima pulmonar).
En gammagrafía de septiembre 2018, se observan múltiples áreas de hipoperfusión con morfología en cuña y con ventilación más conservada en ambos campos pulmonares sugestivas de lesiones embólicas.
El diagnóstico, en ese momento, fue de embolia pulmonar aguda sobre crónica y probable HPTEC. Se descarta la afectación tumoral mediante PET-TAC.
Ante la sospecha de HPTEC, se completa el estudio con un cateterismo cardiaco derecho (CCD), realizado en septiembre de 2018, el cual confirma hipertensión arterial precapilar pulmonar grave (PAPm 71 mmHg, PCP 7 mmHg Resistencias vasculares pulmonares 9,7 W GC 2,88L/min). Se decide inicio con Taladafilo y se remite a la paciente a nuestro centro de referencia (H12O) donde, tras la valoración de las pruebas complementarias, se decide tratamiento mediante tromboendarterectomía (TEA) pulmonar (en marzo 2019).
Tras la cirugía, la paciente presenta buena evolución posterior, con mejoría de la clase funcional (II/IV). A los 6 meses (septiembre 2019) se realiza la valoración pronóstica recomendada por la ESC, presentando un BNP de 40 ng/L; ETT con PSAP de 62 mmHg; previamente 85 mmHg, área AD 22 mm2, no derrame pericárdico, remodelado positivo sobre cavidades derechas.
Cateterismo derecho (noviembre 2019) (PAPm 30 PCP 6mmHg RVP RVP>2). Ergometría (VO2 97%; 17 ml/min/kg, VE/VCO2 elevados en el punto de AT). En ese momento, la paciente estaba en un bajo riesgo por lo que se suspende el tratamiento vasodilatador con Tadalafilo.
A los 3 años de la TEA (marzo 2022), se objetiva un empeoramiento en la situación cardiopulmonar presentando una clase funcional II-III, insuficiencia respiratorio tipo 1 y necesidad de oxigenoterapia continua domiciliaria (OCD) y portátil por desaturación con el esfuerzo; en el ETT (marzo 2022) se aprecia aumento de la PSAP de 60 a 90 mmHg.
II CLINIC CONTEST NAVARRA En Fibrilación Auricular, Tromboembolismo Venoso asociado al Cáncer y Control de Dislipemia con Terapia Oral en el ámbito sanitario de Navarra Tromboembolismo venoso asociado a cáncer
En CCD (abril 2022) presenta PAPm 43 mmHg, PCP 13 mmHg, resistencias pulmonares >2W. En ese momento se encuentra en un riesgo intermedio-alto por lo que, tras discutir el caso en Comité de Hipertensión Pulmonar, se inicia tratamiento con Riociguat. No se llega a dosis plenas (2.5 mg C/8h VO) por mala tolerancia (edemas generalizados y aumento de disnea). Se cambia a Tadalafilo 40 mg C/24h VO con mejoría parcial de los síntomas.
Unos meses después (noviembre 2022), nuevo empeoramiento clínico disnea grado 3-4 de la mMRC, clase funcional III-IV), aumento de volumen en extremidades inferiores. Se discute el caso en comité multidisciplinar para valorar opciones de tratamiento. Se plantea Macicentan, pero por el antecedente de anemia (con valores entre 6-8 g/dL de forma habitual, secundaria a síndrome mielodisplásico) se descarta.
Se decide ajustar el tratamiento diurético y reinicio de Riociguat (junio 2023). Nuevamente presenta aumento de peso por retención de líquidos, por lo que ingresa para tratamiento depletivo intravenoso. Se realiza nuevo ajuste de diuréticos, se consigue llegar a dosis plenas de Riociguat (febrero 24) sin nuevos episodios de retención de líquidos.
En septiembre de 2024, se diagnostica de leucemia mieloide aguda (LMA) secundaria a síndrome mielodisplásico con displasia multilínea y deleción 5q y se inicia tratamiento activo con Lenalidomida, además de las transfusiones sanguíneas habituales (cada 2-3 semanas) de forma crónica.
La situación cardiopulmonar se estabiliza, pero no llega a estar en un riesgo bajo de la escala pronóstica de la ESC, principalmente por la limitación en el tratamiento por el antecedente de la anemia que contraindica inhibidores antagonistas de receptores de endotelina.
La paciente continua seguimientos en consulta de Hematología, presenta un empeoramiento clínico progresivo y finalmente fallece por una complicación de la leucemia que padece.
La hipertensión pulmonar tromboembólica crónica (HPTEC) es una patología cada vez más estudiada y con mayor incidencia, probablemente por una mayor conciencia de enfermedad y screening.
La asociación entre la patología tumoral y la trombosis a varios niveles es bien conocida, por ser el cáncer un factor trombótico importante
INUSUAL
Marina De La Escosura Muñoz, Andrea Téllez Lorenzo y José Alberto Espinoza Pérez
y en general permanente, aunque en patologías premalignas la relación no está tan bien establecida, por lo que en nuestro caso, siendo una paciente sin patología previa ni otros factores de riesgo trombóticos parece lógico pensar que el síndrome mielodisplásico jugó un papel importante en el desarrollo de la HPTEC, sobre todo dada la trasformación leucemiforme final.
La valoración de este tipo de pacientes de forma precoz tras el alta es primordial y se realiza en consulta especializada de circulación pulmonar para valorar el riesgo de HPTEC, decidir el mantenimiento o suspensión de la anticoagulación y valorar síntomas residuales.
Las opciones de tratamiento en la HPTEC constan de tratamiento quirúrgico (considerándose curativo) y tratamiento médico con inhibidores de la fosfodiesterasa 5 (Sildenafilo, Tadalafilo), estimulantes de la guanilato ciclasa soluble (Riociguat) y antagonistas de los receptores de la endotelina (Bosentan, Macitentan).
Los efectos secundarios son diversos, pero destaca la anemización secundaria al uso de antagonistas de los receptores de endotelina. En este caso, la mala tolerancia por la edematización secundaria al Riociguat y la anemia de la paciente limitaban las opciones terapéuticas.
Un comité multidisciplinar para la valoración de esta enfermedad compleja y con baja incidencias es de gran importancia para el manejo óptimo tanto farmacológico como quirúrgico.
II CLINIC CONTEST NAVARRA En Fibrilación
Auricular, Tromboembolismo Venoso asociado al Cáncer y Control de Dislipemia con Terapia Oral en el ámbito sanitario de Navarra
CASOS PRESENTADOS

Eugenia Cañete Dellamea.
MIR. Oncología Médica. Amaia Urtasun Rezusta.
MIR. Oncología Médica. Hospital Universitario de Navarra (HUN).


Cañete Dellamea y Amaia Urtasun Rezusta
Paciente de 38 años, fumadora de 10 cigarrillos al día con antecedentes personales de úlcera gástrica y litiasis biliar, que acude a Urgencias por cuadro de cefalea y fiebre de 38.5ºC. Refiere desde hace una semana cefaleas intermitentes, holocraneales, sin fotofobia, sonofobia ni focalidad neurológica acompañante. Fiebre de hasta 38,5ºC. Paralelamente, presenta dolor abdominal en hipocondrio derecho que ha progresado hasta ser generalizado. Lesiones cutáneas pruriginosas en abdomen y miembros inferiores. No alteración del ritmo intestinal. Sensación nauseosa persistente y algún vómito aislado. Tos sin expectoración y sensación disneica ocasional. Dolor costal que se asocia a la tos.
En la exploración, se encuentra hemodinámicamente estable, eupneica en reposo, normocoloreada y normohidratada. Consciente y orientada, destacando dolor abdominal a la palpación en fosa iliaca izquierda y en hipocondrio derecho con Murphy dudoso. Se realiza analítica sanguínea, que destaca aumento de reactantes de fase aguda y leve aumento de transaminasas. Se solicita ecografía abdominal, en la que se visualiza una lesión sin clara órgano-dependencia en fosa iliaca izquierda, de posible causa infecciosa o inflamatoria y mínimo líquido libre intraabdominal. Se decide ampliar el estudio con TAC abdominopélvico, en el que se observa trombosis de la vena cava inferior suprarrenal, extendiéndose el defecto de repleción hacia la vena renal izquierda. Se observa también obstrucción de vena cava inferior infrarrenal que se extiende por ambas venas ilíacas comunes y externas, y aumento de la circulación venosa colateral. Ante estos hallazgos, se inicia anticoagulación con Enoxaparina 80 mg cada 12h y se decide ingreso en planta para completar estudio.
EVOLUCIÓN
Durante su estancia en planta, debido a episodio de dolor torácico y disnea, se solicita angio-TAC que descarta tromboembolismo pulmonar y muestra estabilidad del trombo de vena cava que se extiende desde la aurícula derecha hasta la porción intrahepática y suprarrenal, sugiriendo la posibilidad diagnóstica de tumoración maligna primaria de vena cava inferior. Por mala accesibilidad quirúrgica para toma de muestras, se realiza PET en el que se observa proceso tumoral que engloba la vena cava en su porción intrahepática, sin focos de captación locorregionales o a distancia. Se realiza punción ecoendoscópica
II CLINIC CONTEST NAVARRA En Fibrilación Auricular, Tromboembolismo Venoso asociado al Cáncer y Control de Dislipemia con Terapia Oral en el ámbito sanitario de Navarra Tromboembolismo venoso asociado a cáncer
de la masa, observándose una proliferación fusocelular atípica con positividad para caldesmon y desmina en el estudio inmunohistoquímico, y un Ki-67 de 40%, sugiriendo que se trate de un leiomiosarcoma. Se presenta el caso en Comité de Tumores, acordándose realizar una reevaluación de la extensión tumoral. En el TAC de control se aprecia aumento del volumen tumoral, considerándose un tumor irresecable por lo que se decide traslado a Oncología Médica para inicio, en mayo 2018, de tratamiento sistémico por 6 ciclos con Adriamicina y Olaratumab con posterior mantenimiento con Olaratumab hasta septiembre de 2023, que inicia 2ª línea con Gemcitabina-Docetaxel por progresión local y pulmonar. En enero 2024, inicia 3ª línea con Trabectedina por nueva progresión tumoral recibiendo el último ciclo en febrero 2025 por progresión local tras la que se decide discontinuar tratamiento sistémico y priorizar el tratamiento sintomático. En cuanto al tratamiento anticoagulante, se realizó seguimiento por Hematología. Inicialmente en abril 2018 se manejó con Enoxaparina 80 mg cada 12h. En TAC de control, realizado en agosto, se observa progresión trombótica hacia venas ilíacas comunes, iliacas externas e hipogástricas derechas, y persistencia de obstrucción intrahepática por componente tumoral y trombótico que condiciona un síndrome de Budd-Chiari de origen primario y presencia de vasos colaterales a distintos niveles. Ante estos hallazgos, se modifica tratamiento a Tinzaparina 14000 UI cada 24h, que mantiene hasta diciembre 2019 cuando inicia Acenocumarol, que es preciso suspender por prurito, iniciándose tratamiento con Warfarina. En marzo de 2020, ante aumento de varices abdominales y ascitis -a pesar del cambio de anticoagulant- retoma Tinzaparina 14000 UI, regresando a Warfarina en abril del mismo año ante ausencia de mejoría de varices. En agosto de 2022 se suspende por petición de la paciente y retoma tratamiento con Tinzaparina a dosis de 12000 UI cada 24h. En octubre de 2023, la paciente solicita volver a tomar Warfarina pero interaccionaba con el esquema de quimioterapia que estaba recibiendo en ese momento (Gemcitabina), por lo que se inicia tratamiento con Edoxaban 60 mg cada 24h.
En marzo de 2025, ingresa en Oncología Médica por colestasis. Se realiza CPRE (Colangiopancreatografía Retrógrada Endoscópica), que descarta dilatación de la vía biliar y orienta hacia infiltración parenquimatosa tumoral. Durante el ingreso presenta anemización en contexto de rectorragias por lo que se suspende anticoagulación. Ingresa nuevamente en abril de 2025 por deterioro del estado general, mal
Eugenia Cañete Dellamea y Amaia Urtasun Rezusta
control del dolor y disminución del nivel de conciencia en contexto de insuficiencia hepática, falleciendo el 17 de abril de 2025.
Los sarcomas de vasos son tumores raros, siendo los de vena cava inferior los más frecuentes. El leiomiosarcoma es un tumor de origen mesenquimal, procedente de las células musculares lisas de la túnica media; suelen alcanzar un gran tamaño sin producir metástasis ni clínica asociada, siendo un hallazgo incidental en forma de masa retroperitoneal. Puede crecer intra o extraluminalmente, afectando a estructuras vecinas, siendo la localización más frecuente a nivel intrahepático, como en nuestra paciente. Desde su descripción en 1871, se han reportado alrededor de 450 casos (1). Entre los factores de mal pronóstico se incluyen la presentación de trombosis venosa, el síndrome de Budd-Chiari, crecimiento tumoral intraluminal y la oclusión completa del vaso. Además, estos tumores tienen peor pronóstico en comparación con leiomiosarcomas con las mismas características histológicas en otras localizaciones (2). La resección quirúrgica completa es la opción terapéutica que proporciona mayor supervivencia a largo plazo, siendo el papel de la quimioterapia neoadyuvante y adyuvante controvertido y sin un claro consenso, aunque se utiliza en pacientes que progresan, recurren o en enfermedad metastásica (3).
La trombosis de vena cava asocia una morbimortalidad significativa y su incidencia puede estar infraestimada por la falta de métodos estandarizados para su detección, además de la variabilidad en su presentación clínica. Es más frecuente en pacientes con anomalías congénitas de la vena cava, aunque también puede darse en pacientes sin alteraciones anatómicas pero que presentan un estado de hipercoagulabilidad, junto con patología adquirida del vaso o de estructuras adyacentes como un tumor maligno y el síndrome de BuddChiari, que presentaba nuestra paciente. La anticoagulación supone el tratamiento principal y debe instaurarse inmediatamente tras el diagnóstico, junto con otras medidas que son útiles en función del tiempo de presentación. No hay recomendaciones específicas sobre el manejo de la anticoagulación, pero se aconseja utilizar heparinas durante la fase aguda, siendo posible el uso de anticoagulación oral durante los 3-6 meses posteriores en caso de que sea provocada o durante un período extendido en no provocadas y pacientes con alto riesgo de retrombrosis (4).
II CLINIC CONTEST NAVARRA En Fibrilación Auricular, Tromboembolismo Venoso asociado al Cáncer y Control de Dislipemia con Terapia Oral en el ámbito sanitario de Navarra Tromboembolismo venoso asociado a cáncer
Los sarcomas de partes blandas del retroperitoneo y, entre ellos, el leiomiosarcoma son tumores poco frecuentes. A pesar de que la cirugía sigue siendo la mejor opción terapéutica, dado el bajo número de casos descritos, hay poca información en la literatura actual sobre el pronóstico y el papel de la quimioterapia. Es por ello que se comenta el caso de esta paciente y se revisa la literatura referente.
1. García M, Messa O, Ríos D, López H, Canedo J. Leiomiosarcoma de la vena cava inferior: reporte de un caso y revisión de la literatura. Rev Colomb Cancerol. 2014;18(1):41–5
2. Arif SH, Mohammed AA. Leiomyosarcoma of the inferior vena cava presenting as deep venous thrombosis; case report. Radiol Case Rep. 2020;15(2):133–5.
3. Inada Y, Sawada S, Kato T, Kanbe S, Itagaki Y, Ohshima T, et al. Leiomyosarcoma of the inferior vena cava. Rinsho Hoshasen. 1987;32(8):971–4.
4. Alkhouli M, Morad M, Narins CR, Raza F, Bashir R. Inferior Vena Cava thrombosis. JACC Cardiovasc Interv. 2016;9(7):629–43.
TROMBOSIS VENOSA PROFUNDA COMO DEBUT DE LEIOMIOSARCOMA DE VENA CAVA
Eugenia Cañete Dellamea y Amaia Urtasun Rezusta


TAC Abdominal al diagnóstico
TAC de control: síndrome de Budd-Chiari y vasos colaterales.
II CLINIC CONTEST NAVARRA En Fibrilación
Auricular, Tromboembolismo Venoso asociado al Cáncer y Control de Dislipemia con Terapia Oral en el ámbito sanitario de Navarra
CASOS PRESENTADOS

Amaia Cabasés Ordóñez. Medicina Familiar y Comunitaria. Centro de Salud Aranguren. Javier Ecay Narváiz. Medicina Familiar y Comunitaria. Centro de Salud Mendillorri.
Leyre Langarica Villar. Medicina Familiar y Comunitaria. Centro de Salud Aranguren.


Amaia Cabasés Ordóñez, Javier Ecay Narváiz y Leyre Langarica Villar
Varón de 46 años, sin antecedentes personales de interés ni tratamientos previos. No alergias conocidas. No hábitos tóxicos. Trabaja en una oficina, realiza viajes mensuales por trabajo. Casado, tiene dos hijos, de 12 y 9 años.
Acude a su Médico de Atención Primaria (AP) por palpitaciones en contexto de esfuerzos de 2 meses de evolución. Relata que es una persona que sale a correr 3 días por semana una media de 10 km, y desde hace unas semanas se intensifican los episodios de palpitaciones con grandes esfuerzos, sin dolor torácico asociado, pero que le obligan a parar, recuperándose espontáneamente en minutos. No cortejo vegetativo asociado, no pérdida de peso ni otra sintomatología acompañante, salvo dolor intenso en gemelo izquierdo, que lo había atribuido a contractura muscular.
A la exploración, buen estado general, buena coloración de piel y mucosas. No se palpan adenopatías. Auscultación cardiaca rítmica, sin ruidos patológicos. Auscultación pulmonar sin alteraciones patológicas. Abdomen blando y depresible, sin masas ni visceromegalias. Dolor a la palpación de gemelo de extremidad inferior derecha (EID), no se palpa cordón venoso, no signos de infección ni inflamación.
Se realiza ecografía de EID en Centro de Salud (CS), objetivándose la vena poplítea, tibiales posteriores y peroneas dilatadas, con contenido ecogénico en su interior y no colapsables a la compresión extrínseca en relación con trombosis venosa profunda. Vena femoral común, superficial, profunda, cayado de la safena y safena mayor permeables y colapsables a la compresión extrínseca (Figura 1 y 2).
Dados los hallazgos, se decide derivar al paciente al servicio de Urgencias para realización de analítica sanguínea (AS) y descartar la posibilidad de tromboembolismo pulmonar (TEP).
En AS de urgencias se objetiva DD de 1670, sin otras alteraciones, y se decide realizar ECG y AngioTAC. En el mismo, se describen hallazgos compatibles con pequeño TEP periférico en rama subsegmentaria del LID. Resto de ramas de arterias pulmonares permeables. Sin signos de hipertensión pulmonar ni sobrecarga cardiaca derecha. Estructuras vasculares mediastínicas de calibre normal. No derrame pleural ni pericárdico. Parénquima pulmonar bien aireado, sin alteraciones significativas. Estructuras óseas conservadas (Figura 3).
Se realiza interconsulta (IC) a Hematología, quienes indican pautar durante 1 semana Clexane 60 mg/12h y posteriormente iniciar Dabi-
II CLINIC CONTEST NAVARRA En Fibrilación Auricular, Tromboembolismo Venoso asociado al Cáncer y Control de Dislipemia con Terapia Oral en el ámbito sanitario de Navarra Tromboembolismo venoso asociado a cáncer
gatrán 150 mg/12h, solicitando visado. Se recomienda seguimiento de anticoagulación en consultas de Medicina Interna y estudio etiológico del TEP.
Durante la consulta de Medicina Interna, se revalora al paciente y se realizan nuevas pruebas complementarias (PC), Estudio de Trombofilia normal y se solicita estudio endoscópico. Se realiza, a su vez, interconsulta (IC) al servicio de Anestesia para valoración previa a gastro-colonoscopia en paciente anticoagulado recientemente con Dabigatrán.
En la gastroscopia se objetiva los siguientes hallazgos: Esófago: Mucosa esofágica de aspecto normal. Línea Z bien definida. Unión esofagogástrica: Normal. Estómago: Se observa una lesión ulcerada e infiltrativa de bordes irregulares en la región del antro gástrico, de aproximadamente 4 cm de diámetro, con mucosa circundante eritematosa y friable. Se toman múltiples biopsias de la lesión. Píloro: Transitable. Duodeno: Bulbo y segunda porción sin alteraciones significativas.
Impresión diagnóstica:
Lesión ulcerada infiltrativa en antro gástrico, sospechosa de neoplasia. Biopsias enviadas para estudio anatomopatológico (Figura 4).
En colonoscopia se objetivan los siguientes hallazgos; Recto y colon sigmoide: Mucosa de aspecto normal. Colon descendente, transverso y ascendente: Sin hallazgos patológicos. Ciego: Se visualiza válvula ileocecal sin alteraciones. Íleon terminal: Mucosa normal. No se observaron pólipos, masas ni signos de sangrado activo.
Impresión diagnóstica:
Colonoscopia sin hallazgos patológicos.
Con toda la información, tanto los servicios de Digestivo y Oncología Médica, además de coordinase con Medicina Interna e informar a su médico de cabecera al respecto, se reunieron en Comité de Tumores para realizar un manejo conjunto del caso y planificar el tratamiento óptimo para el paciente.


II CLINIC CONTEST NAVARRA En Fibrilación Auricular, Tromboembolismo Venoso asociado al Cáncer y Control de Dislipemia con Terapia Oral en el ámbito sanitario de Navarra Tromboembolismo venoso asociado a cáncer


II CLINIC CONTEST NAVARRA En Fibrilación
Auricular, Tromboembolismo Venoso asociado al Cáncer y Control de Dislipemia con Terapia Oral en el ámbito sanitario de Navarra
CASOS PRESENTADOS

RECURRENTE
Marina Planelles Ripoll.
MIR. Oncología Médica. Marta Moneo Puig.
MIR. Oncología Médica. Hospital Universitario de Navarra (HUN).

II CLINIC CONTEST NAVARRA En Fibrilación Auricular, Tromboembolismo Venoso asociado al Cáncer y Control de Dislipemia con Terapia Oral en el ámbito sanitario de Navarra Tromboembolismo venoso asociado a cáncer
Antecedentes personales:
Mujer de 79 años, que entre sus antecedentes personales destacan el diagnóstico de enfermedad obstructiva crónica (EPOC) tipo mixta y bocio multinodular.
Historia oncológica:
La paciente fue diagnosticada en una TAC (tomografía computarizada) de seguimiento del bocio, de un carcinoma escamoso pulmonar estadio IIIB, en junio de 2020, con PDL1 inferior al 5%. Se inició tratamiento con quimiorradioterapia concomitante con Carboplatino y Vinorelbina x 4 ciclos. Posteriormente, continuó con Durvalumab, un antiPDL1, hasta que la TAC de control de julio de 2021 objetivó progresión ganglionar mediastínica e hiliar. Comenzó entonces tratamiento de primera línea con Carboplatino y Gemcitabina, obteniéndose respuesta parcial radiológica. En la TAC de reevaluación de noviembre de 2021 (Figura 1) se observó un tromboembolismo pulmonar (TEP) segmentario-subsegmentario derecho incidental, refiriendo la paciente a la anamnesis posterior disnea de medianos esfuerzos de dos semanas de evolución. Por lo tanto, se inició tratamiento anticoagulante con Tinzaparina a dosis de 175 UI/kg/día y se continuó el tratamiento de quimioterapia hasta cumplir 10 ciclos, el último en diciembre de 2021.
En las revisiones posteriores se objetivó estabilidad desde el punto de vista oncológico y resolución del TEP derecho, describiendo estructuras vasculares de calibre normal ya en la TAC de un mes después del evento. Tras 7 meses de tratamiento con Tinzaparina, se incluyó a la paciente en el estudio APICAT (Apixaban Cancer Associated Thrombosis), por lo que la anticoagulación se modificó a Apixabán.
Sin embargo, un año después del inicio de Apixabán, en junio de 2023, dado que había sido un TEP subsegmentario, la paciente no se encontraba en tratamiento oncológico activo y no había evidencia de enfermedad, se suspendió el tratamiento anticoagulante.
Historia actual:
En enero de 2025, la paciente acude a Urgencias por aumento progresivo de su disnea basal de una semana de evolución con disminución de la actividad habitual.
MANEJO DE UN TEP RECURRENTE
Marina Planelles Ripoll y Marta Moneo Puig
A la exploración inicial, la paciente está afebril y estable hemodinámicamente con saturación de oxígeno basal del 93%. La auscultación cardíaca es rítmica, sin soplos y en la auscultación pulmonar no se objetivan alteraciones.
Durante su estancia en Urgencias se solicita analítica sanguínea, que evidencia como parámetros destacables una elevación del dímero D de 1740 ng/ml, troponinas y pro-BNP en rango y ausencia de parámetros infecciosos. También se realiza radiografía de tórax y electrocardiograma, que se muestran dentro de la normalidad. En este contexto, para descartar la presencia de TEP, dado la clínica y el valor del dímero D, se completa el estudio mediante una angio-TAC (Figura 2), que muestra varios defectos de repleción a nivel de arterias segmentarias y subsegmentarias de los lóbulos superior, medio e inferior derecho y língula, y lóbulo superior izquierdo. No se aprecian signos de sobrecarga de cavidades derechas. Se evalúa con todos estos datos el Índice de Severidad de Embolismo Pulmonar (PESI), siendo de 115 puntos.
Tras los hallazgos evidenciados, se decide ingreso en planta de hospitalización e inicio de anticoagulación con Enoxaparina 60 mg/12 horas (se corresponde a 1 mg/kg/12 horas). Al mantenerse estable clínica y hemodinámicamente, la paciente es dada de alta a los 5 días con el plan de anticoagulación en domicilio: al cumplir 7 días de tratamiento con Heparina cada 12 horas podrá comenzar posteriormente con Apixabán 5 mg/12 horas.
Los eventos tromboembólicos venosos (TEV) son una complicación frecuente en pacientes con cáncer, siendo una causa importante de morbilidad y la segunda causa prevenible de muerte en este grupo (1). Representan entre el 15-20 % de los casos de TEV y tienen una alta tasa de recurrencia. El riesgo trombótico aumenta por varios factores, incluyendo las características de cada paciente, el tipo de tumor y los tratamientos oncológicos. Por eso, se requiere un seguimiento riguroso y manejo personalizado del tratamiento antitrombótico en cada uno de ellos (2).
El caso descrito plantea dos cuestiones: cuánto tiempo debe mantenerse la anticoagulación, teniendo en cuenta el riesgo de recurrencia; y a qué dosis debemos mantener el anticoagulante, considerando el riesgo de sangrado que supone el tratamiento de anticoagulación a dosis terapéuticas.
II CLINIC CONTEST NAVARRA En Fibrilación Auricular, Tromboembolismo Venoso asociado al Cáncer y Control de Dislipemia con Terapia Oral en el ámbito sanitario de Navarra Tromboembolismo venoso asociado a cáncer
Respecto a la duración de la anticoagulación, el TEP se diagnostica en múltiples ocasiones de forma incidental en las TAC de control de los pacientes oncológicos y las guías clínicas recomiendan tratar estos casos igual que los TEP sintomáticos. Sin embargo, aunque se recomienda una duración inicial de tratamiento anticoagulante de 6 meses, no se establece un tiempo concreto más allá de ese período. La decisión de continuar depende de factores como la presencia de cáncer activo, el tratamiento sistémico en curso, el tipo y la extensión del TEP, y las preferencias del paciente (3).
Diversos estudios como HOKUSAI-VTE, SELECT-D y ONCO DVT han demostrado que mantener la anticoagulación más allá de los 6 meses (hasta 12 meses en la mayoría de los casos) reduce significativamente la recurrencia de trombosis sin aumentar el riesgo de sangrado mayor clínicamente relevante.
Otro factor a tener en cuenta y que nos ayuda a plantearnos la suspensión del tratamiento anticoagulante en nuestra paciente es el riesgo de recurrencia de trombosis y sangrado en los TEP incidentales. Una revisión sistemática sugiere que los TEP incidentales presentan menor riesgo de recurrencia, pero mayor riesgo de sangrado que los sintomáticos, por lo que se debe valorar el riesgo-beneficio según las características del diagnóstico (4). Todos estos datos no aportan una conclusión clara respecto a la duración del tratamiento en nuestra paciente, pero al no identificarse factores de alto riesgo de recurrencia, la suspensión del tratamiento después de 1 año y 7 meses se considera adecuada.
Por otro lado, el estudio APICAT, en el que participó la paciente, expone un nuevo aspecto a valorar en el tratamiento anticoagulante, la dosis del mismo. Se trata de un estudio randomizado, doble ciego, de no inferioridad, que incluye pacientes con diagnóstico oncológico y episodio trombótico venoso (Trombosis venosa profunda o TEP) que han cumplido al menos 6 meses de tratamiento anticoagulante a dosis terapéuticas. Se comparan dos grupos que reciben Apixabán: uno con dosis reducida (2.5 mg/12 horas) y otro con dosis completa (5 mg/12 horas), durante un año. El objetivo principal es medir la recurrencia trombótica y, como objetivo secundario, evaluar la seguridad en términos de sangrado clínicamente relevante. Recientemente, se han publicado resultados de este estudio (octubre 2018-septiembre 2023), que analizando 1766 pacientes concluye que la anticoagulación prolongada con dosis reducidas de Apixabán no fue inferior a las dosis
MANEJO DE UN TEP RECURRENTE
Marina Planelles Ripoll y Marta Moneo Puig
completas en la prevención de TEV recurrente en pacientes con cáncer activo. Además, la dosis reducida presentó una menor incidencia de complicaciones hemorrágicas clínicamente relevantes (5).
El manejo de los eventos trombóticos en pacientes oncológicos es complejo. El tratamiento anticoagulante podría suspenderse tras 6 meses, si no hay factores de riesgo de recurrencia; y el estudio APICAT resalta que dosis reducidas de Apixabán pueden ser una opción segura. Lo esencial es el manejo personalizado y la evaluación continua.
1. Tirandi A, Preda A, et al. Pulmonary embolism in patients with cancer: an updated and operative guide for diagnosis and management. Int J Cardiol. 2022; 358: 95-102.
2. Au C, Gupta E, et al. Clinical presentations and outcomes in pulmonary embolism patients with cancer. J Thromb Thrombolysis. 2021; 51(2): 430436.
3. Ortega L, Pelegrín FJ, et al. SEOM clinical guidelines on venous thromboembolism (VTE) and cancer (2023). Clin Transl Oncol. 2024.
4. Caiano L, Carrier M, et al. Outcomes among patients with cancer and incidental or symptomatic venous thromboembolism: A systematic review and meta-analysis. J Thromb Haemost. 2021;19(10):2468-2479
5. Mahé I, Carrier M, et al. Extended Reduced-Dose Apixaban fos Cancer Associated Venous Thromboembolism. N Engl J Med. 2025; 392: 1363-1373.
II CLINIC CONTEST NAVARRA En Fibrilación Auricular, Tromboembolismo Venoso asociado al Cáncer y Control de Dislipemia con Terapia Oral en el ámbito sanitario de Navarra Tromboembolismo venoso asociado a cáncer


2: Angio-TAC 01/2025.
II CLINIC CONTEST NAVARRA En Fibrilación
Auricular, Tromboembolismo Venoso asociado al Cáncer y Control de Dislipemia con Terapia Oral en el ámbito sanitario de Navarra
CASOS PRESENTADOS

Ignacio Antonio Martínez Adán.
MIR. Neumología.
Carlos Idoate Domenech.
MIR. Neumología.
Sonia Herrero Martín. Neumología.
Hospital Universitario de Navarra (HUN).

II CLINIC CONTEST NAVARRA En Fibrilación Auricular, Tromboembolismo Venoso asociado al Cáncer y Control de Dislipemia con Terapia Oral en el ámbito sanitario de Navarra Tromboembolismo venoso asociado a cáncer
Varón de 51 años, con antecedentes de hipertensión arterial y tabaquismo activo con un consumo acumulado de 51 paquetes/año fue diagnosticado, en octubre de 2024, de adenocarcinoma pulmonar parahiliar derecho T3N0M0 con una expresión de PDL1 del 20%. Discutido en comité multidisciplinar de cáncer de pulmón, se decidió tratamiento combinado con quimioterapia y radioterapia concomitante dada la irresecabilidad del mismo por invasión mediastínica.
Se administró el tratamiento radioterápico (dosis total de 66 Grays con un esquema de 33 fracciones) y quimioterapia con Carboplatino y Vinorelbina, con buena tolerancia. Tras completar la pauta inicial, en enero de 2025, se inició inmunoterapia con Durvalumab.
Cuatro días después del inicio de la inmunoterapia, el paciente acudió a Urgencias por disnea progresiva, tos seca y picos febriles de hasta 39ºC. Ingresó con diagnóstico de presunción de neumonía infecciosa, iniciándose tratamiento antibiótico empírico con amoxicilina y Ácido clavulánico. Se observó mejoría sintomática parcial que contrastaba con empeoramiento radiológico, por lo que se amplió estudio con una Tomografía Computarizada (TC) de tórax (Figura 1, 2 y 3).
El TC se informó como “Extensas opacidades en vidrio deslustrado que afectan al lóbulo superior derecho, región superior del lóbulo inferior derecho y de forma menos evidente a lóbulo medio, con algunas zonas de broncograma aéreo, de nueva aparición que en el contexto clínico puede corresponder a neumonitis rádica”. Se inició corticoterapia con Metilprednisolona a dosis de 0,5 mg/kg/día (60 mg/día), con importante mejoría del estado general. Se decidió alta hospitalaria el día 3 de febrero con indicación de pauta descendente de corticoides a un ritmo de descenso de 4 mg de Metilprednisolona cada semana hasta alcanzar una dosis de mantenimiento de 20 mg diarios.
Un mes más tarde, el paciente acudió nuevamente a Urgencias por disnea progresiva, tos seca y taquicardia de tres días de evolución, sin fiebre ni distermia asociada. Se realizó un nuevo TC torácico en el que se apreció “Tromboembolismo Pulmonar bilateral (TEP) sin signos de sobrecarga cardíaca, progresión de neumonitis rádica y disminución de masa parahiliar derecha”. Ante el diagnóstico de TEP de riesgo intermedio-bajo, se ingresó en hospitalización convencional, se inició Enoxaparina 100 mg cada 12 horas y se escaló corticoterapia a 60 mg/día (Figura 4).
Ignacio Antonio Martínez Adán, Carlos Idoate Domenech y Sonia Herrero Martín
A las 24 horas del ingreso, el paciente debutó con picos febriles de hasta 38ºC, por lo que se inició antibioterapia empírica con Amoxicilina y Ácido clavulánico. No se consiguió mejoría sintomática, con empeoramiento analítico y persistencia de fiebre, por lo que se escaló el tratamiento a Piperacilina/Tazobactam. Pese a ello, presentó mala evolución, precisando ingreso en Medicina Intensiva por cuadro de sepsis respiratoria. Se amplió la cobertura antibiótica con Trimetoprim-Sulfametoxazol y Levofloxacino y se realizó un nuevo TC torácico, que informó de “empeoramiento radiológico respecto a TC previo con extensas opacidades con patrón en vidrio deslustrado y empedrado de distribución bilateral multilobar a descartar neumonía atípica (especialmente por Pneumocystis jirovecii). Distorsión parenquimatosa compatible con cambios de fibrosis post tratamiento de radioterapia parahiliares derechos”. Posteriormente se realizó una broncoscopia con lavado broncoalveolar, que confirmó la infección por Pneumocystis jirovecii (Figura 5).
La neumonitis rádica es una complicación de la radioterapia conocida desde 1896. Según estudios, afecta hasta a un 10% de los pacientes, de manera proporcional a la dosis de radiación recibida. Su diagnóstico, pese a ser de exclusión y esencialmente radiológico (opacidades en vidrio deslustrado y consolidaciones en TC, asociando pérdida de volumen e incluso afectación pleural) (1), se inicia a partir de la disnea, un síntoma común a enfermedades como las infecciones respiratorias o el TEP, al que podría enmascarar.
La incidencia de TEP en el paciente con neumonitis rádica es un tema del que no disponemos de clara evidencia científica, que demuestren la unión de ambas entidades; sin embargo, se conoce que más del 70% de los eventos tromboembólicos venosos (ETEV) en el paciente oncológico ocurren en pacientes ambulatorios y se ha identificado el tratamiento combinado (sistémico y radioterápico) como un factor de riesgo independiente para estos eventos. No obstante, no está establecida una tromboprofilaxis rutinaria en estos pacientes, siendo algo a individualizar (2).
Así, se debe sopesar el riesgo de un evento tromboembólico venoso, con escalas como la KHORANA score, que en el caso clasificaba un riesgo intermedio de ETEV al inicio del tratamiento combinado, sin modificarse tras reevaluación al alta de la neumonitis rádica. Por el
II CLINIC CONTEST NAVARRA En Fibrilación Auricular, Tromboembolismo Venoso asociado al Cáncer y Control de Dislipemia con Terapia Oral en el ámbito sanitario de Navarra Tromboembolismo venoso asociado a cáncer
contrario, otras más completas y también validadas como la CATSCORE, clasificaba un riesgo leve/moderado de ETEV que aumentó a riesgo alto tras la neumonitis rádica. Por otro lado, el riesgo hemorrágico en la escala VTE-BLEED se mantuvo en alto riesgo sin cambios por tratarse de un cáncer activo.
En resumen, lo que podemos apreciar es que escalas como la Khorana score no valoran cambios en la situación del paciente como el descrito que sí se incluye en la CATSCORE, que a un mismo riesgo hemorrágico nos hubiera hecho plantearnos la tromboprofilaxis ambulatoria. De hecho, esta es la tendencia observada en la investigación con ensayos clínicos actuales como el TARGET-TP que incluye pacientes con cáncer pulmonar y en el que, junto al uso de escalas clínicas y biomarcadores como fibrinógeno y dímero D, administran tromboprofilaxis con enoxaparina frente a placebo, describiendo menores tasas de ETEV sin mayor número de eventos de sangrado mayor (3).
Otro de los diagnósticos que enmascaran frecuentemente la presencia de TEP en el paciente oncológico son las infecciones. Dado que el tratamiento de la neumonitis rádica se basa en la administración de antiinflamatorios de tipo esteroideo (asociando con ello inmunosupresión), el riesgo de infección respiratoria atípica (especialmente por Pneumocystis jirovecii) debe ser tenido en cuenta a la hora de evaluar al paciente, siendo recomendable valorar de manera individualizada la indicación de pautas antibióticas profilácticas (1).
Por tanto, podemos concluir que, dada la complejidad del paciente oncológico, un buen diagnóstico diferencial debe incluir tanto las causas más frecuentes de disnea con infiltrados pulmonares como aquellas que no lo son tanto, reevaluando constantemente la respuesta al tratamiento como un indicador más de la necesidad de ampliar estudios. En cualquier caso, el riesgo de ETEV debe estar presente en todo paciente oncológico, valorando la idoneidad de la tromboprofilaxis mediante el uso de escalas de riesgo clínico (2).
DILEMAS EN LA ANTICOAGULACIÓN ONCOLÓGICA: MANEJO DE UN TEP RECURRENTE
Ignacio Antonio Martínez Adán, Carlos Idoate Domenech y Sonia Herrero Martín
1. Ruysscher DD, Wauters E, Jendrossek V, Filippi AR, Revel M-P, FaivreFinn C, et al. Diagnosis and treatment of radiation induced pneumonitis in patients with lung cancer: An ESTRO clinical practice guideline. Radiother Oncol. 2025;207(110837):110837.
2. Morán LO, Mateo FJP, Balanyà RP, Revuelta JR, Martínez SR, Fombella JPB, et al. SEOM clinical guidelines on venous thromboembolism (VTE) and cancer (2023). Clin Transl Oncol. 2024;26(11):2877–901.
3. Alexander M, Harris S, Underhill C, Torres J, Sharma S, Lee N, et al. Riskdirected ambulatory thromboprophylaxis in lung and gastrointestinal cancers: The TARGET-TP randomized clinical trial. JAMA Oncol. 2023;9(11):1536–45.

ingreso 2 días después

II CLINIC CONTEST NAVARRA En Fibrilación Auricular, Tromboembolismo Venoso asociado al Cáncer y Control de Dislipemia con Terapia Oral en el ámbito sanitario de Navarra Tromboembolismo venoso asociado a cáncer

Figura 5: Fibrosis y vidrio deslustrado con empedrado.
II CLINIC CONTEST NAVARRA En Fibrilación
Auricular, Tromboembolismo Venoso asociado al Cáncer y Control de Dislipemia con Terapia Oral en el ámbito sanitario de Navarra
CASOS PRESENTADOS

Amaia Torrecilla Ugarte.
MIR. Medicina Interna.
Ariadna Setuain Indurain.
MIR. Medicina Interna.
Pablo Lasa Berasain.
MIR. Medicina Intensiva.
Hospital Universitario de Navarra (HUN).

II CLINIC CONTEST NAVARRA En Fibrilación Auricular, Tromboembolismo Venoso asociado al Cáncer y Control de Dislipemia con Terapia Oral en el ámbito sanitario de Navarra Tromboembolismo venoso asociado a cáncer
Varón de 67 años, exfumador (índice tabáquico de 10 paquetesaño), sin otros antecedentes de interés. Desde el punto de vista funcional, vive con su mujer en entorno urbano, es independiente para las actividades básicas de la vida diaria y realiza una vida activa. Actualmente jubilado, trabajó como empresario. Es diagnosticado de leucemia mieloblástica aguda (LMA), sin maduración con monosomía del cromosoma 7. Durante el ingreso inicial se canaliza un catéter central de inserción periférica (PICC) de doble lumen en extremidad superior derecha y se administra tratamiento de inducción con Idarubicina y Citarabina. Posteriormente, recibe tratamiento de consolidación con Citarabina a dosis altas. A los cuatro meses del diagnóstico, se le realiza un trasplante de progenitores hematopoyéticos (TPH) alogénico de intensidad reducida. Se encuentra en tratamiento actual con Tacrólimus 0.5 mg 1 comprimido cada 24 horas, Aciclovir 800 mg 1 comprimido cada 12 horas, Sulfametoxazol/Trimetoprima 800/160 mg 1 comprimido cada 48 horas y Omeprazol 20 mg 1 comprimido cada 24 horas.
A los tres meses tras el trasplante, estando previamente asintomático, comienza con un cuadro de 24 horas de evolución caracterizado por edematización, aumento de temperatura y coloración violácea de extremidad superior derecha en relación con el PICC, acompañado de dolor y sensación de acorchamiento del antebrazo y mano. Sin fiebre termometrada u otra clínica asociada. Ante el empeoramiento progresivo acude al servicio de Urgencias, donde presenta una tensión arterial de 126/83 milímetros de mercurio, frecuencia cardiaca de 78 latidos por minuto, saturación basal de 94%, sin fiebre. En la exploración física presenta un buen estado general, se encuentra eupnéico en reposo. La extremidad superior derecha muestra edema desde axila hasta dedos de las manos, con coloración eritemato-violácea, aumento de temperatura, empastamiento al tacto y circulación colateral a nivel axilar anterior y pectoral visible. Pulso radial presente. Auscultación pulmonar con normofonesis y auscultación cardiaca rítmica, sin soplos. La exploración abdominal y del resto de extremidades es anodina.
En Urgencias se realizan las siguientes pruebas complementarias: Analítica sanguínea, donde destaca hemoglobina de 12 g/dL, plaquetas 97.000/L, función renal conservada con iones en rango y proteína C reactiva de 6 mg/L.
A PROPÓSITO DE UN CASO
Amaia Torrecilla Ugarte, Ariadna Setuain Indurain y Pablo Lasa Berasain
Ecografía doppler de la extremidad afecta, que describe hallazgos compatibles con trombosis total en tercio proximal de la subclavia y parcial de la vena axilar (Figura 1).
Se inicia anticoagulación a dosis terapéuticas con heparina de bajo peso molecular (HBPM) (Enoxaparina 80 mg cada 12 horas) e ingresa en planta para control evolutivo.
El paciente permanece en planta de hospitalización durante 4 días, donde presenta una evolución clínica favorable, con disminución del edema y del dolor. Tras tres días de anticoagulación, se procede a la retirada del PICC. Finalmente, es dado de alta con el diagnóstico de trombosis venosa profunda de vena axilar y subclavia derecha en relación con el PICC, con indicación de continuar tratamiento anticoagulante con HBPM a dosis terapéuticas. En la revisión ambulatoria a los 15 días, se modifica la anticoagulación, sustituyendo la HBPM por Apixabán 5 mg, un comprimido cada 12 horas. Se mantiene la anticoagulación durante 3 meses, periodo en el cual el paciente permanece clínicamente estable, sin exteriorización de sangrado u otras complicaciones asociadas.
El uso del catéter venoso central (CVC) en el ámbito oncológico es cada vez más frecuente, ya que permite la administración de agentes citotóxicos, la transfusión de hemoderivados, la extracción de muestras sanguíneas y la nutrición parenteral. El catéter central de inserción periférica (PICC), es un tipo de CVC que se coloca en vena cava superior a través de una vía periférica del brazo (vena basílica, braquial o menos frecuente en la vena cefálica). Está indicado para tratamientos limitados en el tiempo en pacientes con buen acceso venoso periférico (1-3). A pesar de sus numerosas ventajas, la utilización de estos dispositivos se asocia con un aumento del riesgo de complicaciones tanto infecciosas como trombóticas, que pueden tener un impacto negativo en la calidad de vida y supervivencia de los pacientes (1-3).
La estimación de eventos trombóticos en pacientes oncológicos portadores de CVC varía ampliamente (1); según la literatura, la trombosis asociada al uso de catéter presenta una incidencia que oscila entre el 3,6 % y el 66 % (4). En pacientes oncohematológicos portadores de PICC, se estima una prevalencia de trombosis asociada del 9% (5).
La trombosis del PICC se caracteriza clínicamente por la aparición de edema, eritema y dolor en la extremidad portadora del catéter,
II CLINIC CONTEST NAVARRA En Fibrilación Auricular, Tromboembolismo Venoso asociado al Cáncer y Control de Dislipemia con Terapia Oral en el ámbito sanitario de Navarra Tromboembolismo venoso asociado a cáncer
aunque puede cursar de manera asintomática. En ocasiones se sospecha en el contexto de dificultad en la extracción de sangre a través del PICC. Las potenciales complicaciones más relevantes son el tromboembolismo pulmonar, la infección y la pérdida de funcionalidad del catéter. La demora en el diagnóstico puede conducir al desarrollo del síndrome de vena cava superior o a la generación de trombos a nivel auricular (1,3).
En el diagnóstico de trombosis del PICC, la venografía se considera la prueba gold standard. Sin embargo, la prueba más utilizada es la ecografía doppler con compresión, con una sensibilidad del 97% y una especificidad del 96% (1).
En cuanto al tratamiento, las recomendaciones referentes al tratamiento anticoagulante de las trombosis de miembros superiores se basan fundamentalmente en los datos disponibles para la enfermedad tromboembólica de miembros inferiores. El tratamiento de los pacientes asintomáticos es igual al de los sintomáticos (1). Según la guía de trombosis de la Sociedad Española de Oncología Médica de 2022, no se recomienda la retirada del catéter, salvo que éste no funcione adecuadamente, haya datos de infección, haya datos de gravedad como inestabilidad hemodinámica o TEP, la anticoagulación esté contraindicada o no exista resolución de los síntomas a pesar de una correcta pauta de anticoagulación. En cuanto a la anticoagulación, en caso de retirada del catéter, se recomienda el tratamiento con HBPM por un mínimo de 3-6 meses. En caso de mantenerlo, se recomienda la anticoagulación indefinida. El manejo con anticoagulantes orales directos puede ser considerado como una opción de tratamiento (6). Por último, en cuanto a la prevención de trombosis de CVC, a nivel general la profilaxis primaria con fármacos anticoagulantes no está recomendada (1,6). A nivel no farmacológico, se ha demostrado que los ejercicios de miembros superiores cuantificados pueden reducir el riesgo de trombosis del PICC, mejorando la circulación venosa de los pacientes (3).
A PROPÓSITO DE UN CASO
Amaia Torrecilla Ugarte, Ariadna Setuain Indurain y Pablo Lasa Berasain
1. Martinez del Prado P., Martinez de Castro E. (2017). Profilaxis y tratamiento de la trombosis asociada a catéter venoso central. SEOM.
2. Sánchez Cánovas, M., García Torralba, E., Blaya Boluda, N. et al. Thrombosis and infections associated with PICC in oncohematological patients, what is their relevance?. Clin Transl Oncol 26, 3226–3235 (2024). https://doi.org/10.1007/s12094-024-03548-8.
3. Luo, H., Jin, C., Li, X., Jiang, Y., & Zhou, J. (2023). Quantified versus willful handgrip exercises for the prevention of PICC-related thrombosis: A meta-analysis and systematic review. Medicine, 102(10), e32706. https:// doi.org/10.1097/MD.0000000000032706
4. Hu, Z., He, R., Zhao, Y., Luo, M., Fan, Y., & Li, J. (2024). Risk assessment models for PICC-related venous thrombosis in adult patients with cancer: A network meta-analysis. Thrombosis Research, 239(109030), 109030. https://doi.org/10.1016/j.thromres.2024.05.003.
5. Dos Santos, B.N., Beato, B.V.G., Ferreira, E.B. et al. Prevalence of PICCrelated thrombosis in patients with hematological malignancies: a systematic review. Support Care Cancer 32, 462 (2024). https://doi. org/10.1007/s00520-024-08636-7.
6. Pacheco V., Luque N., Rogado J. et al. (2022). Algoritmo guía clínica SEOM de trombosis y cáncer. SEOM.

Figura 1: Imagen de eco-doppler vascular. Vena subclavia con contenido ecogénico en su interior, ausencia de colapsabilidad y ausencia de flujo doppler.
II CLINIC CONTEST NAVARRA En Fibrilación
Auricular, Tromboembolismo Venoso asociado al Cáncer y Control de Dislipemia con Terapia Oral en el ámbito sanitario de Navarra
CASOS PRESENTADOS
CEREBRAL, CONSIDERACIONES

Sara Labari Jiménez.
MIR. Hematología y Hemoterapia Amaya Sádaba Martínez.
MIR. Oncología Médica Hospital Universitario de Navarra (HUN).


CONSIDERACIONES ESPECIALES EN EL USO DE ANTICOAGULANTES ORALES DE ACCIÓN DIRECTA
Sara Labari Jiménez y Amaya Sádaba Martínez
Mujer de 68 años afecta de dos lesiones cerebrales de larga evolución; lesión izquierda no biopsiada ni intervenida, informada como posible glioma de bajo grado en imagen, y lesión derecha resecada con realización de lobectomía del polo temporal derecho, en noviembre 2018, en el contexto de crecimiento tumoral con resultado de Oligodendroglioma anaplásico (Grado III OMS) IDH1 mutado 1/19q codelecionado.
En diciembre de 2018, en el contexto de neoplasia activa, es diagnosticada de un tromboembolismo pulmonar (TEP) de la arteria segmentaria del lóbulo superior derecho y lateral de la língula con infarto pulmonar en lóbulo inferior izquierdo.
Inicia tratamiento con Enoxaparina 4.000 UI cada doce horas (pesa 60 Kilogramos) con modificación posterior a 10.000 UI al día de Tinzaparina sódica hasta completar un año de tratamiento.
Se comienza quimioterapia adyuvante bajo esquema Procarbazina, Lomustina y Sulfato de Vincristina (PCV). La paciente presentó mielotoxicidad, motivo por el que no pudo administrarse tratamiento quimioterápico completo. Debido a persistencia de enfermedad activa, requiere mantenimiento de anticoagulación y, en febrero de 2020, se solicita visado para comenzar Edoxabán 60 miligramos (mg) al día, dosis plenas. En mayo de 2023, se reducen dosis de Edoxabán a 30 mg al día tras traumatismo craneoencefálico junto con sangrado en ceja profuso, con mantenimiento de estas dosis posteriormente.
En octubre de 2024, ante nueva progresión tumoral se reinicia nueva línea de quimioterapia de PCV a dosis reducidas (50%). Ese mismo mes presenta nuevo traumatismo craneoencefálico en contexto de empeoramiento clínico. En imagen se observan focos de sangrado agudo tumoral, por lo que se suspende transitoriamente la anticoagulación. Ante buena evolución clínica, es dada de alta con Enoxaparina 4000 UI al día y tras buena evolución radiológica, al mes de tratamiento, se modifica anticoagulación con Apixabán 2.5 mg dos veces al día, como terapia extendida. Por mala tolerancia oral se reinicia Enoxaparina 8000 UI al día.
Tras seis ciclos de quimioterápico presenta progresión tumoral, por lo que en marzo de 2025 inicia tratamiento de radioterapia. Presenta empeoramiento neurológico durante la misma en forma de crisis comiciales, decidiéndose limitación del esfuerzo terapéutico y finalmente la paciente fallece.
II CLINIC CONTEST NAVARRA En Fibrilación Auricular, Tromboembolismo Venoso asociado al Cáncer y Control de Dislipemia con Terapia Oral en el ámbito sanitario de Navarra Tromboembolismo venoso asociado a cáncer
El tromboembolismo venoso (TEV) es una complicación frecuente y potencialmente mortal en pacientes oncológicos, siendo la segunda causa de muerte en estos pacientes por detrás de la progresión de la enfermedad de base. Aproximadamente entre un 4% y un 20% de los pacientes con cáncer desarrollarán un episodio de TEV durante el curso de su enfermedad (1). La asociación entre cáncer y trombosis se debe a múltiples mecanismos patogénicos, incluyendo la activación de la coagulación por células tumorales, la inflamación sistémica, la disfunción endotelial y los efectos secundarios a tratamientos oncológicos como la quimioterapia, terapia hormonal o agentes antiangiogénicos (1,2).
Entre los tumores con mayor riesgo trombótico encontramos las neoplasias primarias cerebrales, en especial los gliomas de alto grado. Los pacientes con gliomas IDH mutado (incluyendo grados 2 a 4 y oligodendrogliomas con codeleción 1p/19q grados 2 a 3, según la clasificación actual de la OMS) tienen un menor riesgo de TEV que aquellos pacientes con glioblastomas IDH “wild-type” (3).
Históricamente, la presencia de tumores cerebrales primarios o metástasis se consideraba una contraindicación relativa para la anticoagulación debido al elevado riesgo de hemorragia intracraneal. Las guías prefieren el uso de heparinas de bajo peso molecular (HBPM) frente a antivitamina K (AVK) debido a su perfil de seguridad más favorable. Recientes avances y estudios han demostrado que ciertos pacientes pueden beneficiarse de la terapia anticoagulante y de la utilización de anticoagulantes orales de acción directa (ACODs) (1). Sin embargo, los estudios que existen de anticoagulación en pacientes oncológicos excluyeron en gran medida a pacientes con gliomas u otros tumores cerebrales primarios, debido al riesgo de hemorragia intracraneal (HIC). Por tanto, la evidencia disponible proviene de estudios retrospectivos con limitaciones en tamaño muestral.
Entre los pacientes con afectación cerebral, ciertos tumores primarios como el glioblastoma o astrocitoma presentan un riesgo intrínseco elevado de hemorragia. Las metástasis cerebrales derivadas de melanoma, carcinoma de células renales, coriocarcinoma y carcinoma tiroideo muestran una mayor tendencia a sangrado intratumoral espontáneo (1). En estos escenarios, la evaluación del riesgo hemorrágico es esencial para decidir la estrategia anticoagulante.
EN
Y
CEREBRAL, CONSIDERACIONES ESPECIALES EN EL USO DE ANTICOAGULANTES ORALES DE ACCIÓN DIRECTA
Sara Labari Jiménez y Amaya Sádaba Martínez
Por otro lado, un metaanálisis reciente que incluyó 566 pacientes demostró que los ACODs se asocian a un menor riesgo de hemorragia intracraneal, en comparación con las heparinas de bajo peso molecular (HBPM) en pacientes con tumores cerebrales primarios (RR 0.18; IC 95%: 0.06–0.50; p = 0.001) (5). No obstante, en pacientes con metástasis cerebrales no se observaron diferencias estadísticamente significativas en el riesgo de hemorragia fatal.
Los ACODs que se administran dos veces al día producen picos plasmáticos menores y concentraciones más estables de fármacos, en comparación con regímenes de una vez al día. Esta menor fluctuación en la concentración plasmática podría contribuir a un menor riesgo de eventos hemorrágicos, pero no existe evidencia de calidad con ensayos comparativos que apoye esta hipótesis.
En el caso de nuestro paciente, ante hallazgos de un TEP y al tratarse de un tumor cerebral primario (oligodendroglioma), se comenzó en la fase aguda anticoagulación con HBPM. Las dosis fueron, en primer lugar, intermedias con progresión a dosis plenas posteriormente. Debido a no poder completar tratamiento quimioterápico completo y no haber logrado remisión de la enfermedad, se decidió continuar anticoagulación con un ACOD y posteriormente se redujo la dosis por haber presentado dos traumatismos craneoencefálicos con hallazgos de sangrado intratumoral. Estos fármacos permiten una reducción de dosis que resulta muy útil como tratamiento extensivo tras las fases iniciales a dosis plenas.
Es necesario vigilar interacciones farmacológicas ya que algunos tratamientos oncológicos (inhibidores de tirosina quinasa, inhibidores de proteasoma, quimioterapias) pueden alterar los niveles plasmáticos de ACODs, al interferir con las vías del citocromo P450 y la glicoproteína-P (4) y algunos inductores enzimáticos potentes como ciertos antiepilépticos incluyendo Fenitoína, Carbamazepina y Fenobarbital.
La anticoagulación en pacientes con cáncer y afectación cerebral debe ser individualizada y evaluada por un equipo multidisciplinar (incluyendo oncólogos, neurólogos, internistas, hematólogos, especialistas en cuidados paliativos, etc.) Las decisiones deben realizarse valorando el riesgo-beneficio, considerando las características clínicas y radiológicas del tumor (sangrado activo, edema cerebral significativo o mal control neurológico) y las preferencias del paciente junto con su calidad y esperanza de vida.
II CLINIC CONTEST NAVARRA En Fibrilación Auricular, Tromboembolismo Venoso asociado al Cáncer y Control de Dislipemia con Terapia Oral en el ámbito sanitario de Navarra Tromboembolismo venoso asociado a cáncer
Los ACODs, particularmente Apixabán y Edoxabán, ofrecen alternativas eficaces y seguras en pacientes seleccionados con tumores cerebrales primarios y bajo riesgo de sangrado. Sin embargo, su uso debe ser cauteloso en presencia de metástasis hemorrágicas o insuficiencia renal significativa. Las heparinas de bajo peso molecular siguen siendo la primera elección, tanto en escenarios de alto riesgo hemorrágico como en pacientes frágiles con mala tolerancia oral, como finalmente ocurrió en nuestro caso clínico. La toma de decisiones debe apoyarse en un enfoque multidisciplinar y en la evidencia científica más reciente.
1. SEOM clinical guidelines on venous thromboembolism (VTE) and cancer (2024).
2. Streiff MB, et al. NCCN Guidelines Insights: Cancer-Associated Venous Thromboembolic Disease, Version 2.2021.
3. Jo J, Diaz M, Horbinski C, Mackman N, Bagley S, Broekman M, Rak J, Perry J, Pabinger I, Key NS, Schiff D. Epidemiology, biology, and management of venous thromboembolism in gliomas: An interdisciplinary review. Neuro Oncol. 2023.
4. Farge D, et al. International clinical practice guidelines for the treatment and prophylaxis of venous thromboembolism in patients with cancer.
Lancet Oncol. 2019.
5. Mahajan A, et al. Direct oral anticoagulants vs low-molecular-weight heparin for cancer-associated venous thromboembolism with brain tumors: A systematic review and meta-analysis. Thromb Res. 2021.
II CLINIC CONTEST NAVARRA En Fibrilación
Auricular, Tromboembolismo Venoso asociado al Cáncer y Control de Dislipemia con Terapia Oral en el ámbito sanitario de Navarra
CASOS PRESENTADOS

Marta Moneo Puig.
MIR. Oncología Médica. Maria José Lecumberri Biurrun.
MIR. Oncología Médica. Hospital Universitario de Navarra (HUN).

II CLINIC CONTEST NAVARRA En Fibrilación Auricular, Tromboembolismo Venoso asociado al Cáncer y Control de Dislipemia con Terapia Oral en el ámbito sanitario de Navarra Tromboembolismo venoso asociado a cáncer
Mujer de 26 años, con antecedente de esclerosis múltiple (EM), en tratamiento activo con Ocrelizumab. Valorada en consulta de Urología, en junio de 2024, en contexto de urgencia miccional relacionada con EM, es cuando se objetiva, en ecografía abdominal, masa quística dependiente de anejos. Se completa así estudio, siendo diagnosticada de un carcinoma de células claras de ovario estadio IIIC, por implante peritoneal, candidato a cirugía de citorreducción primaria consistente en histerectomía total con anexectomía bilateral + omentectomía supra e inframesocólica + linfadenectomía radical pélvica y paraaórtica con resultado de resección completa.
Inicia, posteriormente, tratamiento adyuvante con Carboplatino+Paclitaxel (recibe un total de 3 ciclos) cuando comienza con dolor a nivel dorsal y femoral derecho, que obliga a solicitar pruebas de reevaluación de enfermedad oncológica, evidenciando progresión a nivel óseo multifocal, ganglionar y peritoneal. Comienza, en este contexto, nueva línea de tratamiento oncológico con Datopotamab+Deruxtecan dentro de ensayo clínico -del que recibe dos ciclos- cuando, en diciembre de 2024, se evidencia nueva progresión ósea. Se plantea inicio de nueva línea de tratamiento con Adriamicina liposomal + Bevacizumab (BV), momento en el que acude a Urgencias por cuadro de 3 horas de evolución de parálisis facial izquierda periférica, objetivándose en escáner y angio resonancia craneal (Imágenes 1 y 2), trombosis de senos transverso y sigmoideo izquierdos motivo por el que inicia tratamiento con Enoxaparina 80mg/24h. Consecuentemente, comienza tratamiento con Adriamicina liposomal en monoterapia (Primer ciclo sin BV por episodio reciente de trombosis aguda, a valorar asociar en posteriores, en función de riesgo/beneficio). En este punto, ingresa por tos secundaria a neumonía basal izquierda; durante dicho ingreso presenta deterioro clínico progresivo, a expensas de cuadro suboclusivo intestinal alternante secundario a enfermedad oncológica rápidamente progresiva. Dada la refractariedad de medidas implementadas con deterioro clínico irreversible, se inicia bomba de perfusión de sedación. La paciente fallece el 26 de febrero de 2025.
Los pacientes con cáncer presentan un mayor riesgo de Enfermedad Tromboembólica Venosa (ETV) secundario al propio estado de hipercoagulabilidad, asociado al tumor y a distintos factores de riesgo
UNA COMPLICACIÓN POCO COMÚN
Marta
Moneo Puig y Maria José Lecumberri Biurrun
dependientes tanto del paciente como del propio tumor o del tratamiento instaurado para el abordaje del mismo. Por todo ello, el riesgo de ETV se incrementa aproximadamente entre 4 y 7 veces en los pacientes oncológicos, siendo significativamente mayor durante los 3-6 primeros meses tras el diagnóstico. Se trata, además, de una complicación que ensombrece notablemente el pronóstico, constituyendo la segunda causa de muerte prevenible en estos pacientes (1).
Entre los factores de riesgo para desarrollarla, se encuentran la presencia de comorbilidades previas (enfermedad respiratoria, cardíaca, renal, obesidad), una mayor tendencia a la inmovilización, un mal estado funcional, edad avanzada o antecedentes de trombosis y trombofilias hereditarias (1).
Por otro lado, destacan aquellos factores relacionados con el propio tumor, siendo los tumores sólidos con muy alto riesgo de ETV el cáncer de páncreas y el gástrico, encontrándose los ginecológicos dentro del subtipo de alto riesgo. La histología adenocarcinoma, los tumores de alto grado y la enfermedad metastásica contribuyen de igual modo a aumentar el riesgo (1). En lo que se refiere a los relacionados con el tratamiento, la administración de quimioterapia (QT) aumenta más de 6 veces el riesgo de desarrollar ETV. Entre los fármacos que se asocian de forma más evidente al desarrollo de enfermedad tromboembólica se encuentran los platinos, fundamentalmente Cisplatino, con menor riesgo objetivado, aunque representativo, para Carboplatino, fármaco recibido por nuestra paciente. Otros tratamientos como la terapia hormonal con Tamoxifeno o antiangiogénicos como el BV contribuyen de igual modo a aumentar el riesgo (1).
En lo que respecta a la trombosis venosa cerebral (TVC), esta es una forma poco frecuente de ETV que afecta principalmente a adultos jóvenes y de mediana edad. Los factores de riesgo para desarrollarla se superponen en parte con los que condicionan un mayor riesgo de ETV en general, incluyendo la trombofilia genética, el embarazo, el uso de anticonceptivos orales y la obesidad. Sin embargo, otros como el trauma craneal y las infecciones de oído, son específicos para el desarrollo de la misma (2).
Esta complicación puede presentarse en forma de hipertensión intracraneal aislada, focalidad neurológica, como en el caso que nos atañe, o en forma de encefalopatía.
En lo que respecta a la asociación de este evento con la enfermedad oncológica, no se dispone actualmente de ensayos clínicos que evalúen
II CLINIC CONTEST NAVARRA En Fibrilación Auricular, Tromboembolismo Venoso asociado al Cáncer y Control de Dislipemia con Terapia Oral en el ámbito sanitario de Navarra Tromboembolismo venoso asociado a cáncer
esta relación (2). En este sentido, contamos únicamente con un estudio de casos y controles, publicado en 2017, que concluye que el cáncer es un factor de riesgo para el desarrollo de TVC, especialmente dentro del primer año tras el diagnóstico y en pacientes con cáncer de tipo hematológico. Dicho riesgo se incrementa de igual modo en varios tipos de cáncer sólido, siendo más evidente en pacientes con cáncer de pulmón, aumentándose asimismo de manera significativa en tumores ginecológicos, asociación que no resulta tan evidente tras el primer año (3). Por otro lado, y en lo que se refiere al tratamiento con BV, la incidencia de ETV en ensayos clínicos se objetiva similar en pacientes tratados con BV en combinación con QT, comparado con aquellos que reciben únicamente QT. Aunando los estudios publicados para todas las indicaciones, la incidencia global de ETV oscila desde 2,8% hasta 17,3% en pacientes tratados con BV, en comparación con el 3,2% hasta 15,6% de los controles. Si bien es cierto que los pacientes con antecedente de ETV pueden presentar un riesgo mayor de recurrencia con BV en combinación con QT que con QT sola, actualmente no se considera contraindicación absoluta para la introducción del mismo, a excepción de presentar un tromboembolismo pulmonar de alto riesgo (4).
Aunque existen datos suficientes para afirmar que el tratamiento anticoagulante combinado con BV es seguro, ante la aparición de cualquier evento tromboembólico atribuible a un inhibidor de angiogénesis, las recomendaciones actuales consisten en la interrupción inmediata del tratamiento (4).
- La ETV representa la segunda causa de muerte en el paciente oncológico y puede anteceder al diagnóstico tumoral en meses e incluso años. Por ello, el abordaje correcto de esta patología es de vital importancia para el adecuado manejo de estos pacientes.
- A pesar de que la TVC es una enfermedad poco común, contamos con datos incipientes que indican que la enfermedad oncológica es un factor de riesgo importante para desarrollarla, especialmente durante el primer año tras el diagnóstico y fundamentalmente en pacientes con cáncer hematológico.
- Los pacientes tratados con BV pueden tener un mayor riesgo de ETV. El tratamiento con BV se debe interrumpir en pacientes con reacciones tromboembólicas que amenacen la vida.
DE
UNA COMPLICACIÓN POCO COMÚN
Marta Moneo Puig y Maria José Lecumberri Biurrun
Aquellos con antecedente de ETV pueden tener un riesgo mayor de recurrencia con BV en combinación con QT, lo que no supone contraindicación absoluta para el inicio del mismo.
1. Morán, L.O., Mateo, F.J.P., Balanyà, R.P. et al. SEOM clinical guidelines on venous thromboembolism (VTE) and cancer (2023). Clin Transl Oncol 26, 2877–2901.
2. Saposnik G, Barinagarrementeria F, Brown RD Jr, Bushnell CD, Cucchiara B, Cushman M, deVeber G, Ferro JM, Tsai FY; American Heart Association Stroke Council and the Council on Epidemiology and Prevention. Diagnosis and management of cerebral venous thrombosis: a statement for healthcare professionals from the American Heart Association/ American Stroke Association. Stroke. 2011 Apr;42(4):1158-92.
3. Silvis, S. M., Hiltunen, S., Lindgren, E., Jood, K., Zuurbier, S. M., Middeldorp, S., … Coutinho, J. M. (2017). Cancer and risk of cerebral venous thrombosis: a case-control study. Journal of Thrombosis and Haemostasis, 16(1), 90–95.
4. Agencia Española de Medicamentos y Productos Sanitarios; Bevacizumab.
II CLINIC CONTEST NAVARRA En Fibrilación Auricular, Tromboembolismo Venoso asociado al Cáncer y Control de Dislipemia con Terapia Oral en el ámbito sanitario de Navarra Tromboembolismo venoso asociado a cáncer


Imagen izquierda: Trombosis de seno sigmoideo en TAC. Imagen derecha: Trombosis de seno sigmoideo en angio resonancia.
II CLINIC CONTEST NAVARRA En Fibrilación
Auricular, Tromboembolismo Venoso asociado al Cáncer y Control de Dislipemia con Terapia Oral en el ámbito sanitario de Navarra
CASOS PRESENTADOS

Inhar Esnaola Barriola.
MIR. Neurología.
Elena Escriche Gorospe.
MIR. Neurología.
Maria Molina Goicoechea. Neurología.
Hospital Universitario de Navarra (HUN).

II CLINIC CONTEST NAVARRA En Fibrilación Auricular, Tromboembolismo Venoso asociado al Cáncer y Control de Dislipemia con Terapia Oral en el ámbito sanitario de Navarra Tromboembolismo venoso asociado a cáncer
Varón de 74 años, valorado en Urgencias Extrahospitalarias y trasladado al hospital como Código Ictus por debilidad en las extremidades derechas de 5 horas de evolución. Presentaba dislipemia y tabaquismo (hasta 40 cigarrillos diarios) como factores de riesgo vascular. Otros antecedentes destacables: un infarto agudo de miocardio inferior no complicado, ulcus gástrico, esteatosis hepática de origen alcohólico e isquemia crónica de miembros inferiores grado IIA.
A su llegada, el paciente se encontraba hemodinámicamente estable y afebril con lenguaje normal. Consciente, alerta y orientado temporoespacialmente. No presentaba alteraciones del campo visual, signos meníngeos, afectación pupilar ni alteración de los pares craneales. Se objetivó un déficit motor hemicorporal derecho, con fuerza 4/5 en el miembro superior y 3/5 en el miembro inferior, según la escala del Medical Research Council (MRC). No se detectaron déficits sensitivos ni dismetrías.
Se completó el estudio mediante tomografía computarizada craneal y angio-TC, en las que se observaron signos de ateromatosis sin estenosis significativas, sin imagen de oclusión de arteria intracraneal. Asimismo, se identificó una imagen hiperdensa, pseudonodular, en el margen izquierdo de la base de la lengua. En las determinaciones analíticas iniciales, destacaron la anemia (Hb 10.4 g/dL), la elevación de proteína C reactiva (56.5 mg/L) y el consumo de fibrinógeno (95 mg/ dL).
El paciente ingresó con un diagnóstico inicial de ictus isquémico de etiología desconocida y en las primeras 24 horas experimentó un empeoramiento brusco de su estado neurológico, con una nueva focalidad contralateral a la inicial, presentando disartria moderada, desviación óculo-cefálica hacia la derecha, hemianopsia homónima derecha y hemiparesia izquierda, con fuerza 0/5 en la extremidad superior y 3/5 en la inferior. Se realizó un nuevo angio-TC, identificándose en esta ocasión una oclusión de la arteria cerebral media derecha en su segmento M2. El equipo de radiología intervencionista logró la recanalización de la arteria mediante trombectomía mecánica, a pesar de lo cual el paciente no mejoró clínicamente, presentando una tetraparesia y disartria graves.
Durante el segundo día de hospitalización, el paciente desarrolló un deterioro del nivel de conciencia, con insuficiencia respiratoria y deterioro general progresivo. En las analíticas destacó un marcado au-
Inhar Esnaola Barriola, Elena Escriche Gorospe y Maria Molina Goicoechea
mento de dímero D (30,455 ng FEU/mL). La radiografía de tórax reveló una condensación en el lóbulo inferior derecho, por lo que se inició tratamiento antibiótico con Amoxicilina/Clavulánico 2g/8h de forma intravenosa. Los hemocultivos resultaron negativos y el paciente permaneció afebril durante todo el ingreso. La resonancia magnética cerebral mostró múltiples lesiones isquémicas en varios territorios arteriales, con infartos corticales en ambos hemisferios cerebrales y también en hemisferios cerebelosos. Dos de las lesiones isquémicas presentaban signos de transformación hemorrágica. Se realizó una ecocardiografía transtorácica para descartar endocarditis, sin hallazgos de vegetaciones, complicaciones perivalvulares ni disfunción valvular.
Tras una revaloración integral junto con la familia, se decidió no instaurar medidas invasivas como la intubación orotraqueal. Finalmente, el paciente falleció al cuarto día de hospitalización. Ante la sospecha de estado protrombótico secundario a neoplasia oculta, se solicitó a la familia consentimiento para la realización de autopsia clínica; ésta reveló una extensa diseminación metastásica de adenocarcinoma pulmonar, con afectación difusa de ambos pulmones, metástasis en tiroides y ganglios mediastínicos. Se observó una amplia invasión linfovascular, con numerosos trombos en vasos de pequeño y mediano calibre en pulmón, riñones y tejidos blandos pericárdicos. En la válvula mitral se identificó una lesión verrucosa de 0.3 cm, rica en fibrina y compatible con endocarditis trombótica no infecciosa. La lesión de la base de la lengua se diagnosticó de rabdomioma lingual.
La hipercoagulabilidad asociada al cáncer impacta de manera significativa el pronóstico vital de los pacientes oncológicos. Si bien gran parte de los eventos trombóticos se producen en el territorio venoso, existe también un incremento considerable del riesgo de tromboembolismo arterial. En este contexto, en los pacientes con cáncer la enfermedad cerebrovascular representa la segunda complicación neurológica más frecuente después de las metástasis (1). Los adenocarcinomas son el subtipo más frecuentemente asociado a fenómenos tromboembólicos, siendo el cáncer de pulmón el más prevalente, seguido de los de páncreas, colorrectal, mama y próstata (2).
En contraste con otros órganos, donde las manifestaciones subclínicas son frecuentes, en el sistema nervioso central la sintomatología
II CLINIC CONTEST NAVARRA En Fibrilación Auricular, Tromboembolismo Venoso asociado al Cáncer y Control de Dislipemia con Terapia Oral en el ámbito sanitario de Navarra
Tromboembolismo venoso asociado a cáncer
suele ser más evidente. Los ictus asociados a cáncer se caracterizan por una mayor gravedad clínica y tienden a presentar un curso tórpido (1). Como en el caso descrito, es habitual observar infartos cerebrales en diferentes territorios vasculares, lo que da lugar al característico signo radiológico de los “tres territorios”, altamente sugestivo de un origen neoplásico (3). Esta distribución multifocal favorece la aparición de cuadros encefalopáticos y crisis epilépticas como manifestaciones clínicas predominantes (1).
El estado procoagulante en el cáncer es el resultado de múltiples mecanismos fisiopatológicos que alteran el equilibrio entre la trombosis y la fibrinólisis endógena. Estos mecanismos varían en función de la localización tumoral y el subtipo histológico, destacando la producción de mucina, la liberación de vesículas extracelulares, la sobreexpresión de factor tisular, la disminución de la activación de anticoagulantes fisiológicos o la actividad plaquetaria anormal entre otros (4).
La coagulación intravascular diseminada, consecuencia de la activación excesiva de la cascada de coagulación, se traduce clínicamente en una diátesis hemorrágica coexistente con fenómenos trombóticos (4). En estrecha relación, la endocarditis trombótica no infecciosa se caracteriza por la formación de vegetaciones estériles compuestas principalmente por depósitos de fibrina en las válvulas cardíacas, y constituye una de las causas más frecuentes de ictus en pacientes oncológicos (5). Adicionalmente, los embolismos paradójicos representan otro mecanismo relevante, ya que la mayor incidencia de trombosis venosa profunda en el contexto oncológico, sumada a la considerable prevalencia de foramen oval permeable y shunts en la población general, puede facilitar la aparición de embolismos venaarteria (6).
El dímero D tiene un papel importante en el diagnóstico por ser altamente específico para estados de hipercoagulabilidad y posee valor pronóstico, puesto que su descenso tras el inicio del tratamiento anticoagulante indica una respuesta favorable (7).
El manejo, además del abordaje integral del paciente oncológico y las terapias dirigidas a la neoplasia subyacente, se fundamenta principalmente en la anticoagulación, siendo la heparina de bajo peso molecular (HBPM) y los anticoagulantes orales de acción directa (ACOD) las opciones de primera línea, con resultados comparables entre ambos (8,9). Sin embargo, la incomodidad relacionada con la administración subcutánea de HBPM puede condicionar la adherencia terapéutica,
como se evidenció en un ensayo clínico en el que casi la mitad de los pacientes asignados a Enoxaparina abandonaron el tratamiento por molestias derivadas de las inyecciones (1). Este hallazgo ha motivado el desarrollo de estudios como el ensayo TEACH2, que compara la eficacia de Apixabán y Aspirina, considerando la relevante participación de las plaquetas en la patogenia del ictus asociado a cáncer y los posibles beneficios adicionales de la antiagregación, como la inhibición del crecimiento tumoral y la reducción del riesgo de metástasis (6). La duración óptima del tratamiento anticoagulante es motivo de debate y debe individualizarse, aunque se recomienda prolongarlo mientras persista la actividad tumoral (10).
El abordaje diagnóstico y terapéutico de estos pacientes es de elevada complejidad, por lo que este caso requirió la estrecha colaboración de los servicios de Urgencias extra y hospitalarias, Hematología, Cardiología, Medicina Intensiva, Radiología, Neurología y Anatomía Patológica; un enfoque multidisciplinar fundamental para optimizar las oportunidades terapéuticas y la atención del paciente oncológico con complicación trombótica.
II CLINIC CONTEST NAVARRA En Fibrilación Auricular, Tromboembolismo Venoso asociado al Cáncer y Control de Dislipemia con Terapia Oral en el ámbito sanitario de Navarra Tromboembolismo venoso asociado a cáncer
1. Navi BB et al. Ischemic stroke in cancer patients: A review of an underappreciated pathology. Vol. 83, Annals of Neurology. John Wiley and Sons Inc.; 2018. p. 873–83.
2. Quintas S et al. Predictors of unknown cancer in patients with ischemic stroke. J Neurooncol. 2018 May 8;137(3):551–7.
3. Nouh AM et al. Three Territory Sign: An MRI marker of malignancyrelated ischemic stroke (Trousseau syndrome). Neurol Clin Pract. 2019 Apr 1;9(2):124–8.
4. Dardiotis E et al. Cancer-associated stroke: Pathophysiology, detection and management (Review). Int J Oncol. 2019 Jan 2;
5. Ahmed O et al. Non-bacterial thrombotic endocarditis: a clinical and pathophysiological reappraisal. Vol. 46, European heart journal. 2025. p. 236–49.
6. Navi BB et al. Cancer and Embolic Stroke of Undetermined Source. Vol. 52, Stroke. Wolters Kluwer Health; 2021. p. 1121–30.
7. Ohara T et al. The emerging value of serum D-dimer measurement in the work-up and management of ischemic stroke. Vol. 15, International Journal of Stroke. SAGE Publications Inc.; 2020. p. 122–31.
8. Lee MJ et al. Hypercoagulability and Mortality of Patients with Stroke and Active Cancer: The OASIS-CANCER Study. J Stroke. 2017 Jan 31;19(1):77–87.
9. Nam KW et al. Treatment of Cryptogenic Stroke with Active Cancer with a New Oral Anticoagulant. Journal of Stroke and Cerebrovascular Diseases. 2017 Dec;26(12):2976–80.
10. Tsantes AG et al. Cancer-Associated Thrombosis: Pathophysiology, Laboratory Assessment, and Current Guidelines. Cancers (Basel). 2024 May 30;16(11):2082.
II CLINIC CONTEST NAVARRA En Fibrilación
Auricular, Tromboembolismo Venoso asociado al Cáncer y Control de Dislipemia con Terapia Oral en el ámbito sanitario de Navarra
CASOS PRESENTADOS

Ainhoa Sánchez Pastor.
MIR. Medicina Interna.
Pablo Aragón Muñoz.
MIR. Medicina Interna.
Ana María Álvarez Aramburu.
Medicina Interna.
Hospital Universitario de Navarra (HUN).

II CLINIC CONTEST NAVARRA En Fibrilación Auricular, Tromboembolismo Venoso asociado al Cáncer y Control de Dislipemia con Terapia Oral en el ámbito sanitario de Navarra Tromboembolismo venoso asociado a cáncer
Paciente de 66 años, natural de Chile, que consta con antecedentes de diabetes mellitus tipo 2 en tratamiento con antidiabéticos orales y asma bronquial extrínseca. Además, tiene insuficiencia venosa que se encuentra en seguimiento en las consultas de Cirugía Vascular, dado que fue tratada con esclerosis y radiofrecuencia de la vena safena mayor izquierda y con esclerosis de colaterales. No tiene alergias conocidas a medicamentos ni hábitos tóxicos.
La paciente consulta inicialmente en el servicio de Urgencias por dolor lumbar bajo, irradiado hasta el pie izquierdo, con sensación de adormecimiento. Se produce tanto en reposo como en movimiento. El cuadro vino precedido por sobreesfuerzo al intentar arrastrar un armario con motivo de la visita de un familiar. A las 48 horas de este esfuerzo, comenzó a notar dolor en región inguinal izquierda con sensación de “tirantez”.
No refiere incontinencia fecal ni urinaria, aunque sí mayor tendencia al estreñimiento en los últimos días. Niega claro déficit motor en las extremidades inferiores.
Niega haber objetivado fiebre, sensación distérmica o escalofríos, y niega clínica a otros niveles.
Desde el inicio del cuadro ha consultado en diversas ocasiones en el servicio de Urgencias, precisando analgesia del tercer escalón para control del dolor. En algunas de las visitas se solicitan estudios analíticos, en los que se objetivan leucocitosis y elevación de la PCR, que van progresivamente en ascenso.
Finalmente, tras las visitas recurrentes, se decide ingreso hospitalario con tratamiento antibiótico por sospecha de espondilodiscitis, dado el dolor lumbar incapacitante y los reactantes de fase aguda en las analíticas.
Al ingreso, en la exploración, la paciente presenta un regular estado general por dolor de alta intensidad, pero se encuentra hemodinámicamente estable, afebril y con saturación de oxígeno adecuada. Presenta obesidad de predominio troncular.
En la auscultación cardiopulmonar, únicamente destaca un soplo sistólico 2/6 en mesocardio. En la exploración del balance muscular, en la extremidad inferior izquierda, se objetiva paresia 3/5, artefactada por el dolor en región de cadera ipsilateral. Las extremidades inferiores muestran signos de insuficiencia venosa crónica de predominio en pierna izquierda.
En planta, persiste con dolor de gran intensidad por lo que se solicita estudio con resonancia magnética (RM). Además, se suspende el tratamiento antibiótico iniciado en Urgencias por la sospecha de espondilodiscitis, dado que los hemocultivos son negativos. En la RM se objetiva una invasión del cuerpo vertebral L3, por lo que se completa el estudio con un TC toraco-abdominal; en el que se observa una masa/conglomerado adenopático en región ilíaca izquierda con invasión de estructuras musculares y óseas locorregionales, adenopatías retroperitoneales y cuerpos vertebrales bajos. Se solicita una punciónbiopsia de la lesión, objetivando un tumor maligno pobremente diferenciado sin claro origen.
Durante la estancia en planta, la paciente presenta dolor en la extremidad inferior izquierda; con datos clínicos de edematización y aumento de dolor progresivo; por lo que se solicita estudio con ecografía Doppler reglada, visualizando un trombo en vena intergemelar izquierda. Se inicia anticoagulación con heparina de bajo peso molecular por este motivo. En este contexto, como complicación de la anticoagulación, la paciente presenta una hemorragia digestiva alta con anemización importante, condicionando una mayor morbilidad. Debido al mal control del dolor y las múltiples complicaciones adquiridas durante el ingreso, se maneja el cuadro de forma conservadora y se deriva finalmente a la paciente a un centro de media estancia.
La trombosis clínica se presenta hasta en un 10% de los pacientes con cáncer, y está asociada a una mayor morbimortalidad, debido al propio evento y a su tratamiento; lo que hace fundamental incidir en la prevención.
Las masas pélvicas son propensas a la trombosis venosa profunda (TVP) ya que suelen estar anatómicamente cerca de los vasos sanguíneos ilíacos, aunque se trata de una complicación infrecuente. Además, en varias de las series de casos revisadas, se diagnostican las masas pélvicas de forma secundaria, cuando se solicita un estudio de imagen ampliado debido a que la trombosis no responde al tratamiento habitual.
Además, otro aspecto a tener en cuenta es que en las trombosis de la extremidad que se producen en este contexto, cobra mucha importancia el síndrome postrombótico dado que es más frecuente,
II CLINIC CONTEST NAVARRA En Fibrilación Auricular, Tromboembolismo Venoso asociado al Cáncer y Control de Dislipemia con Terapia Oral en el ámbito sanitario de Navarra Tromboembolismo venoso asociado a cáncer
supone un detrimento en la calidad de vida de los pacientes y una mayor morbilidad.
En lo que respecta a la fisiopatología, la formación de TVPs secundarias a las masas pélvicas no se debe exclusivamente a la compresión de la vena ilíaca. También se ve influido por el estasis venoso, el daño endotelial y la hipercoagulabilidad.
Por ello, dado que hay varios predisponentes para el cuadro trombótico, para la mayor parte de los casos como el descrito arriba, durante el ingreso hospitalario se recomienda la tromboprofilaxis si no hay un elevado riesgo de sangrado. Ante todo, cuando contamos con varios factores de riesgo, como pacientes con obesidad, insuficiencia venosa, inmovilizados por mal control del dolor, etc.
En los pacientes ambulatorios, en cambio, el manejo de la prevención de la TVP no está igual de establecido. La decisión de la anticoagulación profiláctica debe ser individualizada, realizando un cuidadoso balance entre el riesgo de trombosis y el riesgo de sangrado. Existen algunas escalas que pueden ayudar al manejo de estos pacientes, como la escala de Khorana.
Por otra parte, como ya hemos comentado, en varias de las series de casos el diagnóstico de las masas pélvicas es posterior al episodio trombótico. Se trata de una patología que puede pasar desapercibida, por no realizar una historia clínica en profundidad sobre la clínica, por ausencia de conocimiento o por tener unas manifestaciones clínicas larvadas, que no se ponen de manifiesto hasta producir cuadros compresivos como el que hemos objetivado. Además, el diagnóstico puede modificar la actitud terapéutica, dado que en ocasiones pueden recibir tratamiento endovascular con una mejoría clínica y en la calidad de vida de los pacientes, por lo que debemos tener presente esta entidad en el diagnóstico diferencial.
CONCLUSIONES
Este cuadro clínico nos permite remarcar la importancia de realizar una evaluación detallada y un seguimiento adecuado para prevenir complicaciones graves, como la trombosis.
Estratificar adecuadamente el riesgo trombótico de los pacientes y mantener una vigilancia estrecha de los factores de riesgo, permite iniciar precozmente la tromboprofilaxis en caso de ser precisa. También es favorable realizar un abordaje integral, dado que, por ejemplo, el manejo adecuado del dolor puede evitar la inmovilización y
EL MANEJO INTEGRAL ANTE LO INUSUAL
Ainhoa Sánchez Pastor, Pablo Aragón Muñoz y Ana María Álvarez Aramburu
minimizar el riesgo. Asimismo, es preciso un índice de sospecha adecuado para identificar posibles etiologías subyacentes cuando una trombosis no responde al tratamiento habitual, dado que podría condicionar el manejo y la morbimortalidad.
1. Baer, H. E., Laux, A., Swain, S., Pounds, L., Hicks, T., Sideman, M., Haidar, G., & Davies, M. (2017). Malignant iliac vein compression with symptomatic iliofemoral deep venous thrombosis. Journal of Vascular Surgery: Venous and Lymphatic Disorders, 5(1), 161.e5.
2. Liu C, Li D, Guo J, Cui Q, Zhang L, Zeng Y. Four case reports on pelvic tumors with deep venous thromboses as main symptoms and literature review. J Can Res Ther 2018;14: S254-6.
3. Singh G, Alshareef S, Meka M (October 25, 2020) Deep Vein Thrombosis Secondary to Extrinsic Compression: A Case Report. Cureus 12 (10): e11160.
4. Barnaby, J., Martynov, A., Shah, S., & Ramanathan, A. (2020). Giant subserosal myoma causing deep venous thrombosis in a patient with pre-existing May-Thurner syndrome. Radiology Case Reports, 15(6), 644–649.
5. Bauer, K. A. (2024). Risk and prevention of venous thromboembolism in adults with cancer. UpToDate
II CLINIC CONTEST NAVARRA En Fibrilación
Auricular, Tromboembolismo Venoso asociado al Cáncer y Control de Dislipemia con Terapia Oral en el ámbito sanitario de Navarra
CASOS PRESENTADOS

Diego Amigot Baldero.
MIR. Medicina Interna.
Enara Echauri Carlos.
MIR. Medicina Interna.
Carlos Vizcay Aranaz. Medicina Interna.
Hospital Universitario de Navarra (HUN).


Diego Amigot Baldero, Enara Echauri Carlos y Carlos Vizcay Aranaz
Mujer de 57 años, que ingresa en planta de Medicina Interna desde el servicio de Urgencias por tromboembolismo pulmonar (TEP) y trombosis venosa profunda (TVP) a nivel de extremidad inferior derecha (EID), de etiología no filiada.
Antecedentes:
Diagnosticada previamente de TEP subsegmentario derecho en 1997 coincidiendo con la gestación, sin claro desencadenante y con estudio realizado por parte de Hematología sin alteraciones a destacar. Asimismo, neoplasia de mama derecha diagnosticada en 2015, tratada mediante segmentectomía, con quimioterapia y radioterapia adyuvantes, dada de alta de consultas en 2022. Como antecedentes de menor relevancia, dispepsia funcional, cólico renal derecho y neuralgia del trigémino. Nunca fumadora ni consumidora de alcohol. No historia familiar de trombosis. No usuaria de terapia hormonal anticonceptiva. Antecedente en su madre de carcinoma de mama a los 65 años.
Encontrándose previamente bien, acude al servicio de Urgencias por dolor y edema a nivel de EID de 12 horas de evolución. Desde hace tres meses, inicia con afonía, disnea de esfuerzo y dolor continuo, de características pleuríticas, a nivel de hemitórax izquierdo. Sudoración nocturna y astenia coincidiendo con este periodo. Además, hallazgo de adenopatías supraclaviculares izquierdas de unos días de evolución. No presenta clínica infecciosa a la anamnesis por aparatos; tampoco episodios de hemoptisis, disnea o presíncope. Niega traumatismos previos, intervenciones quirúrgicas recientes, inmovilización o viajes prolongados. Afebril y sin sensación distérmica. No anorexia ni pérdida de peso. No disfagia ni odinofagia. No náuseas ni vómitos. No dolor abdominal. No alteraciones en hábito deposicional. Ni prurito cutáneo, acolia ni coluria. No tos ni expectoración. No hemoptisis. No palpitaciones. No clínica miccional.
En la primera valoración de la paciente, realizada en planta de hospitalización, presenta una tensión arterial de 108/71 mmHg, una frecuencia cardiaca de 89 latidos por minuto, una saturación basal de oxígeno del 98% a aire ambiente y una temperatura de 35.8ºC.
II CLINIC CONTEST NAVARRA En Fibrilación Auricular, Tromboembolismo Venoso asociado al Cáncer y Control de Dislipemia con Terapia Oral en el ámbito sanitario de Navarra Tromboembolismo venoso asociado a cáncer
Muestra buen estado general, encontrándose eupneica en reposo, normocoloreada y normohidratada, bien perfundida, consciente y orientada. Auscultación cardiopulmonar sin alteraciones, abdomen anodino y exploración neurológica normal. A nivel de extremidades inferiores destaca un discreto aumento de perímetro de EID con dolor a la palpación de pantorrilla. A nivel cervical, hallazgo de adenopatías supraclaviculares izquierdas, no dolorosas, adheridas a planos profundos.
Pruebas complementarias:
En Urgencias se realiza analítica de sangre, donde destaca una anemia normocítica normocrómica con hemoglobina de 11 g/dL y una marcada elevación del Dímero D hasta 19292 ng FEU/mL. Resto del estudio donde se incluye coagulación, Troponina I y NT-proBNP sin alteraciones. Con dichos resultados, se solicita una ecografía doppler de extremidades inferiores, con hallazgos compatibles con TVP extensa a nivel de EID.
Durante el ingreso, se solicita un escáner toracoabdominal, con hallazgos a destacar de TEP lobar derecho, parálisis de cuerda vocal izquierda, adenopatías cervicales y mediastínicas múltiples, y lesiones óseas múltiples en pelvis y columna dorsolumbar de predominio blástico sugestivas de metástasis. Asimismo, se realiza eco-PAAF de una de las adenopatías supraclaviculares, con diagnóstico anatomopatológico compatible con carcinoma de mama con sobreexpresión de receptores de estrógenos, HER2 negativo. Se solicita determinación de varios marcadores tumorales, con elevación del antígeno carcinoembrionario y del Cyfra 21.1. Resultados normales de alfa-fetoproteína, beta-2-microglobulina, antígeno contra el anticuerpo 15.3, antígeno contra el anticuerpo Ca 19.9 y antígeno contra el anticuerpo Ca 125 y enolasa específica neuronal.
Desde el servicio de Urgencias, se inicia anticoagulación con Enoxaparina 60 mg cada 12h, que se mantiene durante el ingreso en planta, progresando posteriormente a Acenocumarol tras una semana de tratamiento. Dada la sospecha inicial de neoplasia oculta, se realiza TAC torácico y posteriormente abdominal con los hallazgos descritos en el apartado anterior. Es valorada por Otorrinolaringología para la realización de PAAF ecoguiada, filiando finalmente el origen
MÁS
Diego Amigot Baldero, Enara Echauri Carlos y Carlos Vizcay Aranaz
de la neoplasia. No se realiza estudio de trombofilia dada la sospecha de que el episodio de TVP y TEP está relacionado claramente con la neoplasia activa. Se decide alta a domicilio con consulta ambulatoria en Oncología para decidir tratamiento a dicho nivel. Asimismo, se cita en consultas de Hematología para decidir anticoagulación a largo plazo, optándose finalmente por iniciar tratamiento con Edoxaban.
La enfermedad metastásica se constituye como el factor oncológico asociado a enfermedad trombótica de mayor importancia. La presencia de neoplasia activa, especialmente en estadios avanzados, se asocia a un aumento significativo del riesgo trombótico debido a múltiples mecanismos procoagulantes inducidos por el tumor, entre los que destacan la sobreexpresión de factor tisular, la liberación de micropartículas procoagulantes y la producción de citocinas que alteran el equilibrio hemostático. Varios estudios han demostrado que los pacientes con cáncer presentan hasta cinco veces más riesgo de TVP y TEP que la población general, riesgo que se ve incrementado en algunos tipos de neoplasias (páncreas, estómago, pulmón y ovario). Asimismo, se ha observado que la carga tumoral y la presencia de metástasis, como en nuestro caso con lesiones óseas y adenopatías múltiples, incrementan de forma exponencial la probabilidad de eventos tromboembólicos.
El factor tisular es una glicoproteína transmembrana que inicia la cascada de coagulación extrínseca y se sobreexpresa en muchas células cancerosas. Son varios los estudios que han sugerido que el factor tisular está sobreexpresado en pacientes con cáncer, contribuyendo significativamente al desarrollo de trombosis venosa en estos pacientes.
Asimismo, se ha descrito que otras citocinas inflamatorias, como la interleucina 6 y el factor de necrosis tumoral alfa, también favorecen un estado de hipercoagulabilidad a través de la alteración de la hemostasia.
La incidencia de neoplasia oculta en pacientes con ETEV no filiada se sitúa entre el 4% y el 10%, siendo mayor durante los seis primeros meses tras el episodio trombótico. Por tanto, desde el punto de vista diagnóstico ante una trombosis no filiada, se recomienda un abordaje escalonado de búsqueda de neoplasia oculta, especialmente si existen otros datos que hagan sospechar una enfermedad oncológica.
II CLINIC CONTEST NAVARRA En Fibrilación Auricular, Tromboembolismo Venoso asociado al Cáncer y Control de Dislipemia con Terapia Oral en el ámbito sanitario de Navarra Tromboembolismo venoso asociado a cáncer
1. Koizume S, Miyagi Y. Tissue factor in cancer-associated thromboembolism: possible mechanisms and clinical applications. Br J Cancer. 2022;127(12):2099-107. PMID: 36097177.
2. Hisada Y, Mackman N. Mechanisms of cancer-associated thrombosis. Res Pract Thromb Haemost. 2023;7(3):100123. PMID: 37122533.
3. Noble S, Pasi J. Epidemiology and pathophysiology of cancer-associated thrombosis. Br J Cancer. 2010;102 Suppl 1:S1-9. PMID: 20386546.
4. van Es N, Le Gal G, Otten HS, Robin P, Piccioli A, Lecumberri R, et al. Screening for occult cancer in patients with unprovoked venous thromboembolism: a systematic review and meta-analysis of individual patient data. Ann Intern Med. 2017;167(6):410-7. PMID: 28828492.
II CLINIC CONTEST NAVARRA En Fibrilación
Auricular, Tromboembolismo Venoso asociado al Cáncer y Control de Dislipemia con Terapia Oral en el ámbito sanitario de Navarra
CASOS PRESENTADOS

Andrea Ortega Picón.
MIR. Neumología.
Óscar Gil Sodupe.
MIR. Neumología.
María Alfonso Imízcoz. Neumología.
Hospital Universitario de Navarra (HUN).

II CLINIC CONTEST NAVARRA En Fibrilación Auricular, Tromboembolismo Venoso asociado al Cáncer y Control de Dislipemia con Terapia Oral en el ámbito sanitario de Navarra Tromboembolismo venoso asociado a cáncer
Varón de 69 años, que presenta cojera y dolor en región glútea derecha. Desde Atención Primaria se le realiza una radiografía (Rx) de dicha extremidad, donde se aprecia una imagen lítica en el trocánter mayor. Se completa el estudio con tomografía computarizada (TAC) y resonancia magnética (RNM) que resulta con el hallazgo de una tumoración lítica femoral proximal derecha de comportamiento agresivo. Se biopsia la lesió,n estableciendo el diagnóstico de Condrosarcoma grado 1 y se realiza exéresis de la tumoración en bloque. Recibe tratamiento tromboprofiláctico 30 días con heparina de bajo peso molecular (HBPM).
Seis meses después, acude a urgencias por presentar tos y hemoptisis con respuesta desfavorable a tratamiento antibiótico empírico. Se realiza una Rx de tórax en la que se evidencia consolidación en lóbulo inferior derecho (LID) así como un pinzamiento del seno costofrénico y engrosamiento pleural ipsilateral. Dados sus antecedentes oncológicos, se completa el estudio con angio-TC. En éste se describe la presencia de tromboembolismo (TEP) bilateral e infartos pulmonares en LID y base de lóbulo superior izquierdo (LSI). Dado el riesgo intermedio-bajo (escala ERS-ESC (1)) se decide ingreso en planta convencional. Se inicia tratamiento anticoagulante con HBPM 80 miligramos (mg) cada 12 horas subcutáneo (peso 75 kg). Durante el ingreso se modifica el tratamiento anticoagulante a HBPM 60 mg cada 12 horas dada la persistencia de leve hemoptisis con mejoría progresiva. Al alta, se inicia tratamiento con anticoagulante oral de acción directa (ACOD) Edoxabán 60 mg cada 24 horas, que el paciente acepta autofinanciarse.
En la consulta de revisión presenta disnea progresiva, dolor pleurítico y persistencia de leve hemoptisis con aumento del infiltrado parenquimatoso en Rx de tórax. Es derivado a urgencias para realizar nuevo angio-TC de manera urgente. El nuevo angio-TC realizado evidencia una progresión del TEP que ahora ocupa la práctica totalidad de las arterias de los lóbulos medio e inferior derechos, acompañándose de marcado engrosamiento vascular. Además, se aprecian nuevos émbolos trombóticos. Se ingresa de nuevo al paciente y se completa estudio con ecocardiograma transtorácico (ETT) reglado que revela una insuficiencia tricuspídea moderada, que permite estimar una presión sistólica de arteria pulmonar (PSAP) de 98 milímetros de mercurio (mmHg). Además, se describe un ventrículo izquierdo no dilatado con
fracción de eyección (FEVI) preservada, asociado a un aplanamiento septal sistólico en relación a la hipertensión pulmonar (HTP) severa. Sin valvulopatías ni otras alteraciones.
Se realiza broncoscopia con lavado broncoalveolar, observándose datos de compresión extrínseca a nivel de bronquios subsegmentarios. La citología resulta negativa para malignidad. No se realiza punción de las lesiones de la arteria pulmonar con ecobroncoscopia (EBUS) dada la HTP severa asociada y el riesgo de sangrado fatal.
Con los resultados obtenidos hasta la fecha, se decide, de acuerdo con radiología torácica, la realización de nuevo TC que informa de la presencia de hallazgos en parénquima pulmonar, que sugieren tromboembolismo tumoral intravascular con progresión respecto a estudios previos e imágenes de nódulos periféricos que sugieren también corresponder a nódulos tumorales. Además, presenta diversas opacidades parenquimatosas en parénquima, a valorar probables infartos pulmonares secundarios. Se refleja también la existencia de nódulos intramusculares adyacentes a prótesis derecha, a descartar nódulos tumorales.
Completamos el estudio con tomografía por emisión de positrones con fluorodesoxiglucosa (PET-TC) para descartar una posible progresión tumoral, describiéndose captación hipermetabólica a nivel de la arteria pulmonar derecha que se extiende hasta formaciones nodulares periféricas, así como a nivel intramuscular adyacente a prótesis de cadera derecha.
Se biopsian los nódulos intramusculares con resultado anatomopatológico compatible con metástasis de condrosarcoma.
Debido a la rápida progresión objetivada, se asume el diagnóstico de recidiva tumoral de condrosarcoma con probable afectación pulmonar (tanto vascular como parenquimatosa) y se plantea tratamiento sistémico activo. Explicando al paciente las escasas opciones de respuesta y habiendo que asumir además el riesgo de cardiotoxicidad asociado, el paciente decide no realizar el tratamiento quimioterápico activo. Se mantiene en seguimiento por el equipo de soporte de atención domiciliaria de paliativos, falleciendo semanas después en su domicilio, según su voluntad.
Aunque las lesiones intraluminales malignas de la arteria pulmonar son una entidad rara, se debe realizar diagnóstico diferencial con la tromboembolia pulmonar (TEP).
II CLINIC CONTEST NAVARRA En Fibrilación Auricular, Tromboembolismo Venoso asociado al Cáncer y Control de Dislipemia con Terapia Oral en el ámbito sanitario de Navarra Tromboembolismo venoso asociado a cáncer
La presencia de una neoplasia previa en un paciente o incluso de una neoplasia oculta es un factor de riesgo moderado (1) que predispone al TEP. Sin embargo, como acabamos de ver, no toda lesión que ocupa espacio en la arteria pulmonar corresponde a un TEP.
Los tumores primarios que nacen en los vasos sanguíneos sistémicos son muy raros; aunque la prevalencia exacta es desconocida, se estima que se encuentra entre un 0,001% y un 0,03% de los casos (2). Dentro de estos, los tumores originarios de la arteria pulmonar presentan una incidencia aún menor, lo que hace que, junto con la clínica inespecífica y la imagen dudosa, en muchas ocasiones resulta difícil de diferenciar de un trombo.
Existe otra entidad reconocida que es el embolismo tumoral. La prevalencia (estudiada en autopsias) asciende hasta el 26% en pacientes con diferentes tumores sólidos (4). No suelen proliferar o invadir localmente, sino que se comportan como una porción inactiva del tumor sin progresión. La clínica es indistinguible de la de un TEP.
En una revisión de 1085 autopsias se observó que los tumores que con mayor frecuencia provocan metástasis intraarterial son aquellos que tienen acceso a venas de gran calibre, como los tumores gástricos o de mama (5). También han sido descritos casos aislados de afectación por sarcomas de alto grado y condrosarcomas (3,6).
Las pruebas diagnósticas que diferencian una lesión ocupante de espacio de un TEP son el angio-TC, la RNM y el PET. Sin embargo, lo que más suele ayudar en la diferenciación es el PET ya que las neoplasias presentan captación y el trombo no tiene actividad metabólica (2).
Lo que nuestro paciente presentaba, dada la clínica y el comportamiento, nos hace sospechar que se trataba de un proceso metastásico de su condrosarcoma de base. Además, las imágenes radiológicas mostraban un empeoramiento clínico con disnea, junto a hemoptisis franca y una progresión de la lesión ocupante de espacio motivando dicha sospecha. El tratamiento principal de este tipo de lesiones es quirúrgico (4), pero debido a la irresecabilidad de las lesiones pulmonares se propuso tratamiento sistémico.
Pese a que tanto las neoplasias primarias, los émbolos tumorales y las metástasis en las arterias pulmonares son entidades raras, debemos pensar en ellas ante un TEP con un comportamiento atípico y agresivo, pese a un tratamiento anticoagulante eficaz.
1. Konstantinides S V., Meyer G, Bueno H, Galié N, Gibbs JSR, Ageno W, et al. 2019 ESC Guidelines for the diagnosis and management of acute pulmonary embolism developed in collaboration with the European respiratory society (ERS). Eur Heart J. 2020;41(4):543–603.
2. Lashari BH, Kumaran M, Aneja A, Bull T, Rali P. Beyond Clots in the Pulmonary Circulation: Pulmonary Artery Tumors Mimicking Pulmonary Embolism. Chest [Internet]. 2022;161(6):1642–50. Available from: https://doi. org/10.1016/j.chest.2022.01.013
3. Claes AS, Hoton D, Galant C, Ghaye B. Intravascular tumour embolism from chondrosarcoma. The Lancet [Internet]. 2022;399(10332):e29. Available from: http://dx.doi.org/10.1016/S0140-6736(16)30382-8
4. Restrepo CS, Betancourt SL, Martinez-Jimenez S, Gutierrez FR. Tumors of the Pulmonary Artery and Veins. Seminars in Ultrasound, CT and MRI [Internet]. 2012;33(6):580–90. Available from: http://dx.doi.org/10.1053/j. sult.2012.04.002
5. Shepard JAO, Moore EH, Templeton PA, McLoud TC. Pulmonary intravascular tumor emboli: Dilated and beaded peripheral pulmonary arteries at CT. Radiology. 1993;187(3):797–801
6. Peixoto LS, Valiante PM, Rodrigues RS, Barreto MM, Zanetti G, Marchiori E. An Unusual Cause of Tree-in-Bud Pattern: Pulmonary Intravascular Tumor Embolism Caused by Chondrosarcoma. Lung. 2015;193(1):151–3

Figura 1: Evolución de la enfermedad en TAC pulmonar (ventana pulmón y mediastino) desde septiembre 2023 (izquierda) hasta febrero 2024 (derecha)
II CLINIC CONTEST NAVARRA En Fibrilación
Auricular, Tromboembolismo Venoso asociado al Cáncer y Control de Dislipemia con Terapia Oral en el ámbito sanitario de Navarra
CASOS PRESENTADOS

Andrea Macua Landívar.
MIR. Medicina Interna
Ana María Álvarez Aramburu.
Medicina Interna Hospital Universitario de Navarra (HUN).


Varón de 75 años, que ingresa desde el servicio de Urgencias por síncopes de repetición.
Antecedentes personales:
Diagnosticado previamente de EPOC tipo enfisema y adenocarcinoma de pulmón con metástasis cerebrales (T1aN3M1b) en julio de 2021. Se realizó radiocirugía sobre las metástasis y comenzó con quimioterapia con Permetrexed + Pembrolizumab (35 ciclos) hasta noviembre de 2023. El PET de control, en febrero de 2024, mostró progresión por lo que se inició Capmatinib. Hábitos tóxicos: fumador de 1 paquete/día desde los 15 años.
Anamnesis:
Refiere desde hace un mes y medio episodios de mareo acompañados de sudoración, taquicardia y náuseas. En el último episodio presenta pérdida de consciencia, motivo por el cual consulta. No refiere estupor postcrítico, no relajación de esfínteres, no movilización de extremidades. No cefalea, no dolor torácico, no disnea ni palpitaciones previas a cuadro sincopal. Inicialmente eran únicamente en bipedestación y con una frecuencia de 1-2 episodios al día. Sin embargo, en los últimos días han aumentado en frecuencia (actualmente unos 4-5 al día) y han ocurrido estando sentado e incluso tumbado. No refiere fiebre ni clínica infecciosa.
Pruebas complementarias recientes previas al ingreso:
- Ecoscopia cardiaca, en la que no se objetivaba patología cardiaca.
- TC toracoabdominal control: nódulo de 7 mm de nueva aparición en lóbulo inferior derecho, a controlar evolutivamente con TC control precoz o valorar PET.
Exploración física:
A su llegada a Urgencias, el paciente se encuentra hemodinámicamente estable, con buena saturación de oxígeno basal. Auscultación cardiaca y pulmonar sin alteraciones patológicas significativas. Resto de la exploración sin nada destacable, incluyendo la exploración neurológica en la que no se objetivan alteraciones.
II CLINIC CONTEST NAVARRA En Fibrilación Auricular, Tromboembolismo Venoso asociado al Cáncer y Control de Dislipemia con Terapia Oral en el ámbito sanitario de Navarra Tromboembolismo venoso asociado a cáncer
Inicialmente, se solicita un electroencefalograma en el que se descarta actividad epileptiforme como causa de los síntomas y un holter de tensión arterial, en el que se observan 3 episodios presincopales que coinciden con momentos de hipotensión sin taquicardia. Una vez objetivados los episodios de hipotensión y descartada etiología cardiaca, mediante ecoscopia cardiaca realizado al comienzo de los síntomas, se completa el estudio con una resonancia magnética craneal en la que no se observan criterios de progresión respecto al estudio previo y una analítica de sangre y orina completa en la que se solicitan anticuerpos onconeuronales y anticuerpos anti canales de calcio, siendo los resultados negativos. Con los resultados de estas pruebas, se descartan los siguientes diagnósticos: síndrome de Eaton-Lambert paraneoplásico (no debilidad, no otros síntomas miasteniformes, anticuerpos negativos), neuropatía autonómica paraneoplásica (no otros síntomas de disautonomía, anticuerpos onconeuronales negativos) e insuficiencia suprarrenal, al realizarse un del test de Synacthen con resultado normal.
Durante el ingreso, el paciente persiste con la clínica, por lo que se inicia tratamiento con Fludocortisona 0.05 mg/24h y posteriormente Midodrina (2,5 mg en 3 tomas).
Ante la ausencia de mejoría clínica y no objetivarse la causa de los síncopes, se decide completar el estudio con un PET, en el que se describe un llamativo aumento de tamaño y metabolismo en conglomerado/masa adenopático paratraqueal alto izquierdo/retroclavicular, que podría condicionar compresión vascular (subclavia y carótida izquierdas). Con esta nueva información nos planteamos, como nueva posibilidad diagnóstica, un síndrome de robo de subclavia.
Ante esta sospecha, se revisan las cifras de tensión arterial sin encontrarse diferencias entre ambas extremidades superiores ni en sedestación ni en decúbito, ni alteraciones en los pulsos. Además, se comprueba clínicamente que los episodios de mareo no están provocados por los movimientos del brazo izquierdo, ni hay síntomas ni signos isquémicos en el mismo. Por lo que también descartamos esta posibilidad.
Finalmente, para acabar de caracterizar mejor la lesión cervical se completa estudio con TC cervical en el que se observa: Masa/conglomerado adenopático y adenopatías satélites en vértice torácico izquierdo que engloba arteria y venas subclavias izquierdas así como
la desembocadura de la vena yugular interna homolateral, con trombosis de la porción distal de la vena subclavia y la porción distal de la vena yugular interna por debajo del nivel vertebral C6, estando el resto de vena yugular permeable.
Juicio clínico final:
Con estos resultados llegamos a los siguientes diagnósticos finales:
- Síncopes de repetición por probable compresión de los barorreceptores carotideos por masa adenopática paratraqueal izquierda.
- Trombosis vena subclavia y la porción distal de la vena yugular interna izquierdas.
Tratamiento:
Tratamiento anticoagulante con Enoxaparina a dosis 1.5 mg/kg/ día y 10 sesiones de radioterapia sobre el conglomerado adenopático cervical, con mejoría progresiva. En última consulta refiere no haber tenido nuevos síncopes.
DISCUSIÓN
El paciente de este caso presenta varios factores de riesgo importantes para el desarrollo de trombosis: edad avanzada, proceso oncológico activo, vida sedentaria y tabaquismo. En este caso, el desencadenante más claro parece ser el proceso tumoral.
En pacientes oncológicos, la trombosis venosa profunda es entre cuatro y siete veces más frecuente que en la población general. Este riesgo es todavía más elevado en ciertos tipos de cáncer como los hematológicos, gastrointestinales y pulmonares de células no pequeñas, como en nuestro paciente. Son varios los factores que contribuyen a este aumento de frecuencia de trombosis. Por un lado, la secreción de factores procoagulantes producidos por el tumor (factor tisular, cisteína proteasas, micropartículas tumorales, citocinas inflamatorias, interleuquina-1 y 6, factor de necrosis tumoral- alfa) conlleva a un estado protrombótico. Por otro lado, puede ser una complicación local del tumor por compresión vascular extrínseca por masas tumorales o adenopatías o por invasión endotelial tumoral directa. Esto reduce el flujo venoso produciendo éstasis y predisponiendo a trombosis localizadas, como ocurre en nuestro caso.
II CLINIC CONTEST NAVARRA En Fibrilación Auricular, Tromboembolismo Venoso asociado al Cáncer y Control de Dislipemia con Terapia Oral en el ámbito sanitario de Navarra Tromboembolismo venoso asociado a cáncer
Hay que tener en cuenta que una trombosis venosa profunda en localización atípica debe alertarnos sobre una posible etiología tumoral local. El 90-95% de las trombosis se localizan en extremidades inferiores; sin embargo, en nuestro caso se trata de una trombosis en las venas yugular y subclavia, por lo que habría que indagar en factores secundarios causantes. La mayoría de las trombosis en extremidades inferiores son secundarias a factores de riesgo sistémicos (inmovilidad, cirugía, cáncer). En contraposición, la causa más frecuente de trombosis en extremidades superiores es secundaria, principalmente por catéteres o tumores.
Desde el punto de vista de tratamiento, las trombosis venosas asociadas a cáncer requieren anticoagulación. Hay que tener en cuenta que, en estos casos donde la trombosis es una complicación local de la compresión tumoral directa, el control local del tumor ya sea mediante intervención quirúrgica, quimioterapia o radioterapia, que ha sido el tratamiento aportado a nuestro paciente, son igual de importantes para el tratamiento del proceso trombótico.
1. Khorana, A. A., et al. (2021). Venous Thromboembolism and Cancer: A Contemporary Review. JCO Oncology Practice, 17(4), 173–179. Revisión detallada sobre fisiopatología, riesgos y manejo de la trombosis en pacientes oncológicos.
2. Farge, D., et al. (2019). International clinical practice guidelines for the treatment and prophylaxis of venous thromboembolism in patients with cancer. The Lancet Oncology, 20(10), e566–e581. Guía internacional sobre tromboprofilaxis y tratamiento de TEV en cáncer (actualización del grupo ITAC-CME).
3. Key, N. S., et al. (2021). Venous thromboembolism prophylaxis and treatment in patients with cancer: ASCO Clinical Practice Guideline Update. Journal of Clinical Oncology, 38(5), 496–520. Guía de práctica clínica de la American Society of Clinical Oncology (ASCO).
4. Caine, G. J., Stonelake, P. S., Lip, G. Y. H., & Kehoe, S. T. (2002). The hypercoagulable state in cancer: pathogenesis and current debate. Neoplasia, 4(6), 465–473. Enfoque fisiopatológico sobre la hipercoagulabilidad en pacientes con cáncer.
II CLINIC CONTEST NAVARRA En Fibrilación
Auricular, Tromboembolismo Venoso asociado al Cáncer y Control de Dislipemia con Terapia Oral en el ámbito sanitario de Navarra
CASOS PRESENTADOS

Laura Valderas Monge.
MIR. Medicina Interna. Maddi Taboada Palacios.
MIR. Medicina Interna.
Francisco Javier Anniccherico Sánchez. Medicina Interna.
Hospital Universitario de Navarra (HUN).

II CLINIC CONTEST NAVARRA En Fibrilación Auricular, Tromboembolismo Venoso asociado al Cáncer y Control de Dislipemia con Terapia Oral en el ámbito sanitario de Navarra Tromboembolismo venoso asociado a cáncer
Paciente de 73 años, sin alergias medicamentosas conocidas. Presenta factores de riesgo vascular como dislipemia pura sin tratamiento (última cifra de colesterol LDL de 105 mg/dl en febrero 2025) y exfumador desde el año 2020, con un índice paquetes/año de 40. Asimismo, presentó en 2016 un carcinoma escamoso de tercio superior de esófago (estadio T3N+M0), que requiere tratamiento multidisciplinar con quimioterapia, radioterapia y cirugía (esofaguectomía tipo McKeown). En este contexto, presenta disfagia para líquidos por estenosis postquirúrgica, que ha precisado varias dilataciones esofágicas. En la actualidad, el antecedente oncológico se encuentra en remisión completa. Aparte de la esofaguectomía, ha precisado colecistectomía laparoscópica por colecistitis aguda en 2019. Su tratamiento habitual incluye espesante para líquidos y suplementación de vitamina B12 intramuscular de forma trimestral. No ha sido transfundido previamente y niega hábitos tóxicos. Sin antecedentes familiares de interés. Es independiente para todas las actividades básicas e instrumentales de la vida diaria (Índice de Barthel 100 puntos); vive en domicilio con su esposa. Realiza vida activa con funciones superiores conservadas.
HISTORIA ACTUAL
El paciente acude al servicio de Urgencias por signos de flogosis (dolor, edema, eritema, calor e impotencia funcional) en extremidad inferior izquierda de 3 días de evolución. Afebril en domicilio, sin sensación distérmica. No traumatismo previo ni heridas. No encamamiento reciente ni síndrome constitucional. De forma concomitante, refiere presentar en las 48 horas previas expectoración hemoptoica en forma de coágulos, sin disnea ni dolor torácico. Niega tos ni cuadro catarral. No mareo ni síncope. Disfagia habitual para líquidos. No dolor abdominal ni cambios en ritmo intestinal. Resto de anamnesis sin incidencias reseñables.
Exploración física:
El paciente se mantiene hemodinámicamente estable con presión arterial de 125/80 mmHg, frecuencia cardíaca de 105 latidos por minuto, afebril con temperatura de 36.2ºC y saturación arterial de oxígeno de 94%, aire ambiente.
Consciente y orientado en las tres esferas, colaborador y con buen estado general. Sin adenopatías palpables. La auscultación cardíaca
Laura Valderas Monge, Maddi Taboada Palacios y Francisco Javier Anniccherico Sánchez
es rítmica y sin soplos. Se objetiva normofonesis bilateral. El abdomen tiene peristaltismo de conservado; blando y depresible. No doloroso a la palpación, sin masas ni megalias. Extremidad inferior izquierda con importante edema y eritema, desde empeine hasta rodilla y región poplítea ipsilateral. Diámetro de zona gemelar izquierda aumentado respecto la contralateral (30 y 25 mm, respectivamente). Caliente y empastado, signo de Homans positivo. No se palpa cordón fibroso. Dolor difuso a la palpación. Exploración neurovascular sin alteraciones.
Pruebas complementarias:
En Urgencias se extrae analítica de sangre incluyendo hemograma, bioquímica y coagulación, en la que se objetiva un Dímero D de 14789 ng FEU/ml. Sin anemia (hemoglobina de 15.4 g/dl) con resto de hemograma en rango y sin reactantes de fase aguda (sin leucocitosis ni fibrinógeno. Proteína C Reactiva en rango). Perfil renal conservado con Filtrado Glomerular estimado de 86 ml/min/m2. Electrocardiograma y radiografía de tórax postero-anterior y lateral sin alteraciones. Cultivo de esputo con resultado de flora habitual y se inicia cuantificación de hemoptisis. Se realiza una Ecografía Doppler de la extremidad afecta en la que se objetiva trombosis venosa profunda (TVP) en femoral común, femoral superficial y poplítea y tronco tibioperoneo proximal izquierdos; por lo tanto, una TVP extensa en extremidad inferior izquierda. Es valorado por Hematología, ya que se trata de un paciente con TVP en extremidad y que de forma concomitante tiene hemoptisis; es decir, presenta tanto trombosis como sangrado. Se inicia anticoagulación a dosis intermedias con heparina de bajo peso molecular (HBPM) Enoxaparina 40 mg cada 12 horas, en espera de la evolución del paciente. Se cursa ingreso en planta de hospitalización para estudio y tratamiento.
Durante el ingreso, se realiza escáner torácico y abdominal, para despistaje de tromboembolismo pulmonar (TEP), dada la hemoptisis junto con la TVP de nueva aparición, y descartar recidiva tumoral por neoplasia esofágica previa. En dicho escáner se objetiva TEP a nivel de arterial intermediaria derecha, sin áreas sospechosas.
A nivel abdominal, se objetiva una zona estenosante de 3 cm en el ángulo esplénico, que obliga a descartar neoplasia. Sin recidiva tumo-
II CLINIC CONTEST NAVARRA En Fibrilación Auricular, Tromboembolismo Venoso asociado al Cáncer y Control de Dislipemia con Terapia Oral en el ámbito sanitario de Navarra Tromboembolismo venoso asociado a cáncer
ral a nivel esofágico. En primer lugar, el paciente se encuentra hemodinámicamente estable, presenta un índice de gravedad de grado IV según Pulmonary Embolism Severity Index (PESI), sin disfunción de ventrículo derecho y sin elevación de biomarcadores cardíacos. Todo ello compatible con TEP de intermedio-bajo riesgo. Por otro lado, en relación a la lesión estenosante del ángulo esplénico a estudio, se solicita colonoscopia diagnóstica. Al resolverse la hemoptisis, se aumenta la anticoagulación a dosis terapéuticas (Enoxaparina 80mg/12h), que requiere ser suspendida 24 horas antes de la endoscopia. El paciente presenta limitación para tomarse la preparación oral de la colonoscopia, dada la disfagia habitual para líquidos, por lo que se administra a través de sonda nasogástrica. A pesar de que la endoscopia se realiza de forma incompleta, por abundante cantidad de restos semisólidos, se objetiva una lesión con centro deprimido y patrón vascular irregular de aproximadamente 25 mm, sugestiva como primera posibilidad de aspecto neoformativo. Se toman múltiples biopsias de la misma con resultado de adenocarcinoma intramucoso–displasia grave de intestino grueso (pTis). Esa misma noche, se reinicia HBPM a dosis intermedias (Enoxaparina 40 mg/12h). Al tratarse de una lesión muy sospechosa y realizarse la endoscopia de forma incompleta, se solicita una nueva colonoscopia que se realiza de forma ambulatoria, ya que el paciente se encontraba clínica y hemodinámicamente estable. Se mantuvo 48 horas con heparina a dosis intermedias y posteriormente, a dosis terapéuticas. Tras 10-14 días con heparina se valorará cambio a un ACOD, en espera de la decisión del Comité de Tumores.
DISCUSIÓN
En el caso clínico previamente expuesto, la trombosis venosa profunda de miembros inferiores fue la primera manifestación de la enfermedad. Dentro del estudio se objetivó un TEP y un cáncer de sigma silente hasta el momento del diagnóstico. Precisó seguimiento por Hematología para ajuste de la anticoagulación, ya que se trataba de un paciente complejo con trombosis y sangrado, simultáneamente, además de someterse a procedimientos invasivos durante el ingreso.
La TVP junto con el TEP son las dos manifestaciones de la enfermedad tromboembólica venosa. Ambos procesos están íntimamente relacionados, de manera que un 20-50% de las TVP asocian TEP y en un 70-80% de los TEP se demuestra una TVP (1). Asimismo, la existen-
Laura Valderas Monge, Maddi Taboada Palacios y Francisco Javier Anniccherico Sánchez
cia de una asociación en ambos sentidos entre cáncer y activación del sistema hemostático es bien conocida, debido a anomalías en los componentes de la Triada de Virchow (estasis sanguínea, hipercoagulabilidad y lesión endotelial) (2). La trombosis asociada al cáncer (TAC) es una entidad frecuente en la población oncológica, ya que un cáncer multiplica por 6-10 veces la incidencia de TEP, pudiendo ser este último la primera manifestación de una neoplasia que había permanecido oculta hasta ese momento (hasta en un 10% de los casos) (3), como en nuestro caso clínico. La aparición de TAC se asocia a un peor pronóstico del proceso neoplásico subyacente, siendo la segunda causa de muerte en pacientes oncológicos. Requiere tratamientos individualizados ya que, aparte del riesgo trombótico, pueden presentar complicaciones hemorrágicas. La base del tratamiento de estos pacientes, una vez superan la fase aguda, son los anticoagulantes de acción directa (ACODs) (4). Por ello, hay que tener en cuenta que ante el diagnóstico de ETEV debemos indagar sobre un posible origen neoplásico, dada su clara asociación y la morbimortalidad que conlleva.
1. Aparicio EM et al. Manual de Diagnóstico y Terapéutica Médica Hospital Universitario 12 de Octubre. 9ª edición. Enfermedad tromboembólica y trombosis venosa profunda. Páginas 212-213. MSD 2022.
2. Abdol Razak NB, Jones G, Bhandari M, Berndt MC, Metharom P. Cancer Associated Thrombosis: An Overview of Mechanisms, Risk Factors, and Treatment. Cancers (Basel). 2018; 10(10):380.
3. Lecumberri R. Búsqueda de cáncer oculto en pacientes con tromboembolismo venoso: un dilema por resolver. Hospital Universitario de Navarra, España. 2016. Angiología Volume 68, Issue 6, November–December 2016, Pages 456-458. DOI: https://doi.org/10.1016/j. angio.2016.04.003
4. Lyman GH, Carrier M, Ay C, Di Nisio M, Hicks LK, Khorana AA, et al. American Society of Hematology 2021 guidelines for management of venous thromboembolism: prevention and treatment in patients with cancer. Blood Adv. 2021; 5(4):927-974.
II CLINIC CONTEST NAVARRA En Fibrilación
Auricular, Tromboembolismo Venoso asociado al Cáncer y Control de Dislipemia con Terapia Oral en el ámbito sanitario de Navarra
CASOS PRESENTADOS

Marta Lorente Escudero.
MIR. Geriatría
Belén González Glaría.
Geriatría.
Hospital Universitario de Navarra (HUN).


Marta Lorente Escudero y Belén González Glaría
Varón de 84 años, que acudió al servicio de Urgencias por varicorragia y dolor intenso en ambos miembros inferiores de aparición brusca de 2 horas de evolución, de inicio en zona proximal que irradiaba hasta zona distal (ambos pies). No parestesias. No traumatismo previo. No anestesia en silla de montar ni relajación de esfínteres. No procesos infecciosos recientes, afebril. No disnea, dolor torácico ni abdominal. Refiere hiporexia y pérdida ponderal de unos 3-4 kg en 3 meses, sin causa aparente.
Antecedentes:
El paciente presenta los siguientes antecedentes personales de interés:
- Hábitos tóxicos: Ex consumidor habitual de alcohol en cantidades moderadas, estimado en 20–40 g/día (equivalente a 2–4 unidades estándar).
- Cardiovasculares: Hipertensión arterial esencial y dislipemia sin tratamiento farmacológico. Obesidad grado I. Miocardiopatía dilatada probablemente enólica.
- Respiratorio: Enfermedad Pulmonar Obstructiva Crónica GOLD 2 no agudizador.
- Renal: Enfermedad Renal Crónica grado 3b.
- Hepático: Hepatopatía crónica leve.
Respecto a su situación basal, según Valoración Geriátrica Integral, cabe destacar:
- A nivel funcional: Independiente para las actividades básicas e instrumentales de la vida diaria (índice de Barthel 85/100 y Lawton 7/8). Deambulación y transferencias sin apoyos. Incontinencia urinaria ocasional. No salva escaleras.
- A nivel cognitivo-afectivo: Cambio cognitivo hace varios años con mantenimiento del rendimiento global. No episodios de delirium previos. No problema afectivo.
- A nivel nutricional: Mantiene dieta normal, sin adaptación de texturas. No disfagia. Hiporexia y pérdida ponderal de unos 3-4 kg en 3 meses. Ritmo deposicional diario dentro de la normalidad. Abandono del hábito enólico hace 2 años.
- A nivel neurosensorial: Hipoacusia bilateral leve no corregida. No déficit visual.
- Otros síndromes geriátricos: No dolor crónico. No polifarmacia.
II CLINIC CONTEST NAVARRA En Fibrilación Auricular, Tromboembolismo Venoso asociado al Cáncer y Control de Dislipemia con Terapia Oral en el ámbito sanitario de Navarra Tromboembolismo venoso asociado a cáncer
Inicialmente, el paciente ingresó en el servicio de Cirugía Vascular por dolor brusco e intenso en ambos miembros inferiores, donde se diagnosticó de isquemia aguda bilateral de miembros inferiores y se realizó embolectomía selectiva con recuperación de pulsos distales. En la valoración inicial, no se identificó una fuente embolígena clara (sin arritmias ni trombos cardiacos intracavitarios). Como únicos hallazgos relevantes cabe destacar aneurisma de aorta abdominal e ilíaca derecha y ateromatosis difusa.
Tras estabilización postquirúrgica, fue derivado a un hospital de media estancia con anticoagulación a dosis terapéuticas para recuperación funcional donde, unos días después, comenzó con dolor y aumento de volumen en la zona quirúrgica de la pierna derecha, compatible con hematoma con sangrado activo, requiriendo volver al hospital terciario de zona para reintervención quirúrgica y drenaje. Por este motivo, se le suspendió el tratamiento anticoagulante.
En su segundo ingreso, nuevamente en Cirugía Vascular, tras la reintervención quirúrgica de miembro inferior derecho, presentó edema y dolor en miembro superior izquierdo, confirmándose ecográficamente trombosis venosa braquial izquierda aguda. Por ello, se inició anticoagulación a dosis terapéuticas con Heparina de Bajo Peso Molecular (HBPM). Sin embargo, 2 días después, desarrolló un hematoma en la misma extremidad con evolución a síndrome compartimental, por lo que se realizó fasciotomía urgente y, posteriormente, injerto cutáneo por parte de Cirugía Plástica.
Cabe señalar que, durante este periodo, precisó intervención y seguimiento por el servicio de Geriatría para optimización de los problemas sobreañadidos: episodio de infección urinaria por Escherichia Coli productora de BLEE (β-lactamasas de espectro extendido), tratada con Ertapenem endovenoso, y un cuadro de delirium hiperactivo multifactorial, precisando ajuste de psicofármacos.
Por otro lado, en el contexto de fenómenos trombóticos/hemorrágicos recurrentes y marcadores inflamatorios elevados, se inició estudio de neoplasia oculta. Analíticamente, se demostró elevación del Antígeno Carcinoembrionario (CEA) y Antígeno Carbohidrato (CA) 19.9. Además, las pruebas de imagen revelaron una masa hipodensa de 3.2 cm en cola de páncreas con adenopatías retroperitoneales y probables metástasis hepáticas, compatible con adenocarcinoma pancreático estadio IV.
Marta Lorente Escudero y Belén González Glaría
Exploración física inicial (en el primer ingreso de Cirugía Vascular):
Paciente hemodinámicamente estable y con aceptable estado general. Consciente, desorientado temporoespacialmente. Eupneico en reposo. No ingurgitación yugular.
- Cardiopulmonar: Rítmico, sin soplos ni ruidos respiratorios patológicos.
- Abdominal: Abdomen globuloso, blando y depresible, doloroso a la palpación de mesogastrio e hipocondrio derecho, sin defensa ni signos de peritonismo. Peristaltismo de progresión. No ascitis. Se palpa hepatomegalia de un través.
- Extremidades inferiores: Pulso femoral y poplíteo bilaterales presentes. No se palpan pulsos distales. Frialdad en ambos pies, con plantas cianóticas y relleno distal muy enlentecido. No déficits sensitivos ni pérdida de movilidad. Sin edemas.
Pruebas complementarias:
En el servicio de Urgencias y durante ambos ingresos hospitalarios, se llevaron a cabo las siguientes pruebas complementarias:
- Angiografía por Tomografía Axial Computerizada: Aneurisma aortoilíaco, obstrucción infrapoplítea bilateral.
- Ecocardiografía transtorácica: Miocardiopatía dilatada con función sistólica de ventrículo izquierdo moderadamente deprimida (40%). Presión sistólica de la arteria pulmonar estimada de 43 mmHg por insuficiencia tricuspídea leve. No trombos intracavitarios. Sin derrame pericárdico.
- Holter: Ritmo sinusal. No se documenta fibrilación auricular ni otro tipo de arritmias.
- Analíticas sanguíneas (varias), a destacar de todas ellas: Hemoglobina 9.8 g/dL, Proteína C Reactiva 78 mg/L, Velocidad de Sedimentación Globular 85 mm/h, Dímero D >5000 ng/mL, CEA y CA 19.9 elevados.
- Estudio de trombofilia negativo.
- TAC toracoabdominal: Masa hipodensa en cola pancreática (3.2 cm), probable adenocarcinoma con invasión vascular, y múltiples lesiones hepáticas que sugieren origen metastásico.
Confirmado el diagnóstico de adenocarcinoma pancreático estadio IV, se concluyó que los eventos trombóticos múltiples correspondían
II CLINIC CONTEST NAVARRA En Fibrilación Auricular, Tromboembolismo Venoso asociado al Cáncer y Control de Dislipemia con Terapia Oral en el ámbito sanitario de Navarra Tromboembolismo venoso asociado a cáncer
a un síndrome de Trousseau. El paciente fue evaluado multidisciplinarmente, descartándose tratamiento activo por mal pronóstico en relación a estadio tumoral avanzado. Se mantuvo anticoagulación con HBPM a dosis terapéuticas bajo estrecha monitorización, con riesgo hemorrágico elevado. Finalmente, el paciente fue derivado nuevamente al hospital de media estancia para cuidados paliativos, con apoyo familiar organizado y enfoque centrado en priorizar su confort y calidad de vida. Evolucionó sin nuevos eventos trombóticos hasta su fallecimiento semanas después, en contexto de progresión tumoral y fallo multiorgánico.
El caso presentado ilustra de forma paradigmática el síndrome de Trousseau, una manifestación paraneoplásica de estado protrombótico típicamente asociada a adenocarcinomas mucosecretantes (1). Aunque clásicamente descrito como tromboflebitis migratoria, el espectro clínico del síndrome de Trousseau en personas mayores es amplio y puede incluir eventos arteriales y venosos múltiples, incluso como forma de debut del cáncer (2). En este contexto, la coexistencia de fenómenos trombóticos de localización atípica, niveles persistentemente elevados de dímero D y marcadores inflamatorios sin causa aparente, debe plantear la hipótesis diagnóstica de un proceso neoplásico subyacente (3). Estudios recientes han evidenciado que en pacientes mayores, los infartos cerebrales múltiples sin factores de riesgo convencionales pueden ser la primera manifestación del síndrome de Trousseau, siendo los niveles elevados de dímero D (>5.000 ng/mL) y la dispersión de lesiones isquémicas en la imagen los principales indicadores diagnósticos (2,3). La HBPM continúa siendo el tratamiento de elección por su eficacia demostrada en este contexto, aunque su uso en pacientes ancianos frágiles debe individualizarse por el elevado riesgo de sangrado (4) or develop them rapidly over days to weeks. Several disorders can present with this extreme clinical phenotype, including catastrophic antiphospholipid syndrome (APS. En estadios tumorales avanzados, como en el caso presentado, el abordaje debe priorizar la calidad de vida mediante cuidados paliativos integrales (4)or develop them rapidly over days to weeks. Several disorders can present with this extreme clinical phenotype, including catastrophic antiphospholipid syndrome (APS).
Marta Lorente Escudero y Belén González Glaría
En definitiva, este caso subraya la necesidad de una valoración geriátrica integral ante trombosis inexplicadas, facilitando una detección precoz de neoplasias ocultas y una toma de decisiones centrada en el paciente.
1. Meng C, Feng Y, Yang Y, Zhang K, Wang R, Wang Y, et al. Trousseau syndrome with recurrent cerebral infarction as the first oneset in a gastrointestinal malignant tumor patient: A case report. Medicine (Baltimore). 2024 Oct 25;103(43):e40146.
2. Li C, Fan M, He W, Gong Y, Su L. Case Report: Acute cerebral infarction as the initial manifestation of malignant tumors with trousseau syndrome in the elderly. Front Oncol. 2023;13:1188998.
3. Ling Y, Li Y, Zhang X, Dong L, Wang J. Clinical features of Trousseau’s syndrome with multiple acute ischemic strokes. Neurol Sci. 2022 Apr;43(4):2405–11.
4. Ortel TL, Erkan D, Kitchens CS. How I treat catastrophic thrombotic syndromes. Blood. 2015 Sep 10;126(11):1285–93.
II CLINIC CONTEST NAVARRA En Fibrilación
Auricular, Tromboembolismo Venoso asociado al Cáncer y Control de Dislipemia con Terapia Oral en el ámbito sanitario de Navarra
CASOS PRESENTADOS

Claudia Agra Martínez.
MIR. Oncología Médica Amaya Sádaba Martínez.
MIR. Oncología Médica Hospital Universitario de Navarra (HUN).


Mujer de 66 años, que acude al hospital para continuar tratamiento antineoplásico, refiriendo dolor e inflamación en brazo izquierdo.
Antecedentes personales:
Sin antecedentes personales de interés. Fumadora de unos 30 cigarrillos/día.
Desde el punto de vista oncológico, diagnosticada en noviembre de 2024 de un carcinoma infiltrante de mama izquierda fenotipo triple negativo, estadio IV por metástasis hepáticas, pulmonares y óseas, en tratamiento con Paclitaxel, Pembrolizumab y Zolendronato.
La paciente acude, el 30 de abril de 2025, a consulta para continuar tratamiento con quimioterapia basada en taxanos, inmunoterapia y zolendronato.
Refiere dolor, inflamación y enrojecimiento en zona de inserción de PICC (catéter central de inserción periférica), motivo por el cuál consultó con su médico de Atención Primaria que, ante la sospecha de infección asociada a catéter, inició tratamiento con Amoxicilina 1g/8h vía oral durante 10 días. Tras 5 días de antibioterapia, la paciente refiere no mejoría de la clínica.
Exploración física:
Extremidad superior izquierda: edema y tumefacción de extremidad respecto a contralateral. Eritema y aumento de temperatura en zona de inserción de PICC y dolor a la palpación.
Pruebas complementarias:
Ante la clínica de la paciente, compatible con trombosis venosa así como la presencia de factores de riesgo como son en este caso cáncer de mama activo, tratamiento con quimioterapia y presencia de un catéter venoso central de inserción periférica, se solicita ecografía doppler para descartar la presencia de una trombosis venosa.
En dicha prueba se objetiva trombosis en vena basílica con permeabilidad de venas braquiales, axilar, subclavia y yugular derechas.
II CLINIC CONTEST NAVARRA En Fibrilación Auricular, Tromboembolismo Venoso asociado al Cáncer y Control de Dislipemia con Terapia Oral en el ámbito sanitario de Navarra Tromboembolismo venoso asociado a cáncer
Tras el diagnóstico, se inicia tratamiento anticoagulante con Fondaparinux 2,5mg/kg durante 45 días.
La paciente presenta buena evolución clínica con disminución progresiva de los signos locales de trombosis. Actualmente todavía no ha completado los 45 días de tratamiento anticoagulante.
El sistema venoso superficial de las extremidades superiores está formado por las venas basílica, cefálica, cubital media y cefálica accesoria. Entre ellas, las venas basílica y cefálica son las más utilizadas para colocar catéteres venosos periféricos y catéteres centrales de inserción periférica, los cuales terminan en la unión de la vena cava superior con la aurícula derecha.
La trombosis venosa superficial (TVS), anteriormente conocida como tromboflebitis, es un trastorno venoso definido como una reacción inflamatoria con capacidad de originar un trombo de forma secundaria en el sistema venoso superficial. Ha sido considerada durante muchos años como una entidad benigna y autolimitada. Sin embargo, estudios realizados en los últimos años han demostrado que la TVS, al igual que la TVP, puede ser reflejo de una situación de hipercoagulabilidad con posibilidad de complicaciones graves.
La incidencia de TVS en la población general se encuentra en torno al 3-11%. Asimismo, se ha demostrado que existe asociación entre la enfermedad tromboembólica venosa (ETV) y el cáncer, teniendo estos pacientes cuatro veces más probabilidades de ETV que la población general.
La TVS en miembros superiores, generalmente se relaciona con la colocación de catéteres venosos o las punciones venosas de repetición.
Entre los factores de riesgo asociados a TVS, distinguimos aquellos relacionados con el paciente y aquellos relacionados con el catéter venoso.
En cuanto a los relacionados con el paciente se encuentran: historia previa de trombosis venosa, insuficiencia venosa crónica, inmovilización, cirugía reciente y cáncer activo, entre otros.
El cáncer contribuye a través de diversos mecanismos, como la liberación de factores procoagulantes, la compresión venosa directa o factores relacionados con el cáncer como la cirugía, el reposo en cama o los tratamientos protrombóticos.
TROMBOSIS TRAS EL CATÉTER
Claudia Agra Martínez y Amaya Sádaba Martínez
La quimioterapia puede contribuir por diversos motivos, como el daño endotelial directo, la acidosis y las reacciones adversas que conducen a un aumento del reposo en cama y la inmovilización, exacerbando así la hipercoagulabilidad. Entre los agentes quimioterápicos específicos asociados con un mayor riesgo se encuentran el Fluorouracilo, el Etopósido, los fármacos basados en platino, como es el caso de la paciente, el Paclitaxel y la Vincristina.
En relación con el catéter, el principal factor de riesgo descrito es el tipo de catéter, siendo más frecuente en los PICC en comparación con los catéteres venosos centrales. La incidencia notificada de trombosis asociada a PICC es del 2% en la población general, aumentando hasta el 13,8% en los pacientes con cáncer. Además, el calibre del catéter y el número de luces también influyen en el riesgo, de manera que a mayor calibre y mayor número de luces, el riesgo es mayor.
Respecto a la clínica, en muchos casos los pacientes permanecen asintomáticos y puede ser el mal funcionamiento del catéter el único signo de alarma.
Sin embargo, las manifestaciones clínicas más frecuentes son hinchazón y edema de la extremidad en el 93% de los casos, coloración azul en el 77%, enrojecimiento y aumento de temperatura local, dolor y desarrollo de vasos colaterales en el área circundante.
El diagnóstico de la TVS es fundamentalmente clínico, la anamnesis y la exploración física son fundamentales. Asimismo, el diagnóstico clínico debe ir acompañado del estudio radiológico mediante el empleo de la ecograf ía doppler, gold stándard para el diagnóstico de tromboembolismo venoso, que ofrece una sensibilidad del 91% y una especificidad del 93%. El papel del dímero D como marcador diagnóstico sigue siendo controvertido debido a su alta sensibilidad (100%) pero baja especificidad (14%), pudiendo verse influenciados por factores de confusión como inflamación o infecciones concurrentes.
En casos de incertidumbre diagnóstica o sospecha de falsos negativos por ecografía, se debe considerar una ecografía de seguimiento u otras pruebas de imagen como angiotomografía computarizada, resonancia magnética o venografía.
En cuanto al tratamiento, generalmente se prefieren las heparinas de bajo peso molecular (HBPM), como la Enoxaparina o el Fondaparinux, frente a la heparina no fraccionada debido a su perfil de seguridad favorable y facilidad de uso. Los antagonistas de la vitamina K
II CLINIC CONTEST NAVARRA En Fibrilación Auricular, Tromboembolismo Venoso asociado al Cáncer y Control de Dislipemia con Terapia Oral en el ámbito sanitario de Navarra Tromboembolismo venoso asociado a cáncer
siguen siendo una alternativa aceptable para pacientes sin cáncer o para aquellos en quienes la HBPM está contraindicada.
No existe una pauta establecida sobre la dosis y duración del tratamiento con heparinas en pacientes con TVS. Tras la realización de ecograf ía Doppler, se recomienda iniciar tratamiento con Fondaparinux o HBPM a dosis profilácticas durante al menos seis semanas. En caso de progresión de la TVS se debe iniciar tratamiento con HBPM a dosis terapéuticas.
Dado que la presencia de un catéter representa un factor de riesgo trombogénico persistente, su extracción debe considerarse en determinadas circunstancias, como por ejemplo cuando existe contraindicación para anticoagulación. No existe contraindicación para mantener el catéter durante el tratamiento anticoagulante, sino que éste puede mantenerse sin complicaciones relacionadas.
La trombólisis y los procedimientos intervencionistas representan estrategias terapéuticas específicas para pacientes seleccionados, como aquellos con síntomas graves, como el deterioro funcional de la extremidad o carga tromboembólica extensa.
En cuanto a la tromboprofilaxis, actualmente las guías clínicas no recomiendan la tromboprofilaxis farmacológica de rutina para pacientes ambulatorios con cáncer y catéter venoso. La Sociedad Europea de Oncología Médica recomienda evaluar el riesgo trombótico utilizando diversas puntuaciones y considerar la tromboprofilaxis en pacientes de alto riesgo, independientemente de la presencia de un catéter venoso central.
En conclusión, la TVS es una complicación asociada a la presencia de catéteres venosos en los pacientes con cáncer. Su diagnóstico es inicialmente clínico, pero precisa de pruebas de imagen como ecografía doppler para confirmación. La clínica consiste en el enrojecimiento, calor y dolor en la zona de inserción del dispositivo. El tratamiento se basa en tratamiento anticoagulante. La dosis y duración del mismo no están bien establecidas.
TROMBOSIS TRAS EL CATÉTER
Claudia Agra Martínez y Amaya Sádaba Martínez
1. López-Rubio M, Lago-Rodríguez M-O, Ordieres-Ortega L, Oblitas C-M, Moragón-Ledesma S, Alonso-Beato R, et al. A comprehensive review of catheter-related thrombosis. J Clin Med. 2024;13(24):7818.
2. Ellis MH, Fajer S. A current approach to superficial vein thrombosis. Eur J Haematol. 2013;90(2):85-8.
3. Decousus H, Epinat M, Guillot K, Quenet S, Boissier C, Tardy B. Superficial vein thrombosis: risk factors, diagnosis, and treatment. Curr Opin Pulm Med. 2003;9(5):393-7.
4. Lee JT, Kalani MA. Treating superficial venous thrombophlebitis. J Natl Compr Canc Netw. 2008;6(8):760-5.
5. Morán LO, Mateo FJP, Balanyà RP, Revuelta JR, Martínez SR, Fombella JPB, et al. SEOM clinical guidelines on venous thromboembolism (VTE) and cancer (2023). 2024;26(11):2877–901.

Finalistas
Finalistas

II CLINIC CONTEST NAVARRA En Fibrilación Auricular, Tromboembolismo
Venoso asociado al Cáncer y Control de Dislipemia con Terapia Oral en el ámbito sanitario de Navarra
FINALISTAS
HABITUAL

Enara Echauri Carlos.
MIR. Medicina Interna.
Diego Amigot Baldero.
MIR. Medicina Interna.
Joao Luis Modesto Dos Santos. Medicina Interna.
Hospital Universitario de Navarra (HUN).

II CLINIC CONTEST NAVARRA En Fibrilación Auricular, Tromboembolismo Venoso asociado al Cáncer y Control de Dislipemia con Terapia Oral en el ámbito sanitario de Navarra
Control de Dislipemia con Terapia Oral
Mujer de 64 años con antecedente de hiperlipidemia (en tratamiento con atorvastatina 40 mg una vez al día), siendo exfumadora desde los 50 años de edad (menos de 10 paquetes/año acumulado) y reconociendo consumo ocasional de cantidades moderadas de alcohol, sin consumir otros tóxicos.
La paciente ingresa por mareo a estudio, siendo finalmente diagnosticada de sinupatía crónica etmoidal anterior y maxilar derecha con ototubaritis secundaria, recibiendo el tratamiento pertinente y con adecuada evolución clínica. Durante el ingreso se solicitó analítica sanguínea donde se objetivó una cifra de colesterol LDL de 141 mg/dL, por lo que al alta se decide intensificación del tratamiento con atorvastatina de 80 mg/24h junto con Ezetimiba de 10 mg/24h, siendo citada en consulta ambulatoria y habiendo calculado un riesgo cardiovascular según la escala SCORE2 del 4% (riesgo bajo-moderado).
En el control ambulatorio a los 3 meses, la paciente permanece asintomática y se detecta en analítica de sangre de control un descenso de cifras de LDL a 98 mg/dL y lipoproteína (a) (Lp (a)) de 142 mg/dL. Ya en consulta se le interroga por hábitos de vida; reconoce seguir dieta mediterránea, pero sin apenas realizar ejercicio físico. Asimismo, se realiza ecoscopia de carótidas, objetivando placas de ateroma bilaterales (0.8 cm en el lado derecho y 0.7 cm en lado izquierdo, además de en bifurcación) y ecocardioscopia, donde se objetiva fracción de eyección de ventrículo izquierdo (FEVI) preservada sin disfunción diastólica, cavidades normales, raíz de aorta de 2 cm con válvula calcificada probablemente bicúspide. Ante estos hallazgos, se realiza una reevaluación del riesgo cardiovascular de la paciente, que tras los nuevos hallazgos se reclasifica como alto riesgo cardiovascular (exfumadora, hiperlipidemia con LDL de 98 mg/dL en tratamiento farmacológico insuficiente con estatina a dosis máximas y Ezetimiba, Lp (a) a de 142 y evidencia de enfermedad aterosclerótica subclínica).
Se valoran las diferentes opciones de tratamiento para alcanzar objetivos de cifras de colesterol, existiendo las opciones de los inhibidores de PCSK9 inyectables o el Ácido bempedoico oral. Revisando los criterios para el inicio de ambos tratamientos en Navarra, y dado que la paciente no había sufrido ningún evento cardiovascular previamente, se instaura tratamiento con Ácido bempedoico.
Enara
Echauri Carlos, Diego Amigot Baldero y Joao Luis Modesto Dos Santos
Ante la incorporación de la ecografía en la práctica clínica diaria y las nuevas determinaciones en riesgo cardiovascular como la Lp (a), emerge un escenario en la práctica clínica diaria donde pacientes con cifras de colesterol LDL en rango aparentemente aceptable presentan factores modificadores de riesgo como la Lp (a) y la presencia de placas subclínicas, hecho que cambia su estratificación de riesgo de manera muy importante.
La Lp (a) es una lipoproteína con estructura similar a la LDL, unida a la apolipoproteína (a), con efectos proaterogénicos y protrombóticos.
Su elevación >50 mg/dL se asocia con mayor riesgo de enfermedad cardiovascular, y valores >100-125 mg/dL son especialmente significativos a la hora de determinar la prevención primaria. Idealmente, los niveles deberían ser solicitados la primera vez que se pide un perfil lipídico a un paciente (1). La medición debe realizarse una vez en la vida, con excepción de las mujeres que tienen solicitados los niveles previos a la menopausia, ya que se recomienda una medición adicional aproximadamente a los 5 años de la menopausia o tras haber cumplido 50 años (2).
Las concentraciones de Lp (a) están determinadas genéticamente en >90%, con una influencia mínima del estilo de vida, en contraposición de los niveles de LDL que están influidos por ambos (1). A pesar de contar con varias líneas de investigación en este área, hasta la fecha no existen terapias farmacológicas que tengan como diana terapéutica la Lp (a) (aunque distintos tratamientos hipolipemiantes parecen tener un efecto discreto en dicha determinación). Así, la importancia de conocer sus niveles radica sobre la mayor prevención del resto de factores de riesgo cardiovascular, así como en el grado de exigencia en el tratamiento hipolipemiante en estos pacientes.
Diversos estudios epidemiológicos muestran que entre un 20% y un 30% de la población presenta niveles elevados de Lp (a), lo que la convierte en un factor de riesgo altamente prevalente y muchas veces infradiagnosticado. Esta elevada prevalencia junto con la baja variabilidad a lo largo de la vida (por su determinación genética), refuerza la necesidad de su inclusión sistemática en la evaluación del riesgo cardiovascular. El caso presentado pretende ilustrar la importancia de incluir las nuevas determinaciones en la evaluación del riesgo cardiovascular del paciente, atendiendo al cambio de paradigma que supone con vistas a la prevención de la enfermedad aún no establecida. No obstante, y siendo la prevención primaria un pilar fundamental en el manejo de
II CLINIC CONTEST NAVARRA En Fibrilación Auricular, Tromboembolismo Venoso asociado al Cáncer y Control de Dislipemia con Terapia Oral en el ámbito sanitario de Navarra Control de Dislipemia con Terapia Oral
la enfermedad cardiovascular, el diagnóstico precoz de la enfermedad subclínica es igualmente necesario. En el estudio PESA, realizado en 2015 para determinar la prevalencia de la enfermedad aterosclerótica subclínica en España, se objetivó la presencia de placas ateroscleróticas en el 63% de los participantes (3).
En este sentido, cobra especial importancia mencionar el papel de la ecografía clínica multivaso (ECMV), sobre todo en aquellos pacientes de “aparente” riesgo calculado intermedio-bajo, en quienes la detección precoz de enfermedad vascular aterosclerótica en fase subclínica será clave para implementar mediadas que disminuyan su morbimortalidad. Así, la ecografía es una técnica simple, inocua, barata y que debe ser incorporada a la práctica clínica diaria de los médicos, tanto en consulta como en el ingreso hospitalario. A pesar de que la forma de evaluar esta entidad (tanto los distintos territorios vasculares, como la carga de placa) no es homogénea, publicaciones recientes ponen de manifiesto que protocolos estandarizados como el protocolo VASUS+ (4) permiten visualizar de forma inmediata las lesiones y ajustar de forma más precisa el riesgo del paciente, con un impacto terapéutico inmediato y sustancial.
En cuanto al abordaje terapéutico de la paciente, cabe destacar que estaba en tratamiento con una estatina de alta intensidad (Atorvastatina 80 mg), que puede reducir el LDL hasta en un 50-60% mediante la reducción de la síntesis endógena del colesterol (inhibiendo la enzima HMG-CoA reductasa). La combinación con Ezetimiba, inhibidor de la absorción intestinal de colesterol, puede alcanzar una reducción adicional del 20-25%. Sin embargo, en la paciente el LDL de 98 mg/dL seguía por encima de objetivo (<70 mg/dL en pacientes de alto riesgo), por lo que se inició tratamiento con Ácido bempedoico.
El Ácido bempedoico, realiza su acción hipolipemiante mediante la inhibición de la enzima ATP-citrato liasa. Esta enzima está involucrada en la síntesis endógena del colesterol, en un estadio más inicial que HMG-CoA reductasa. Su activación ocurre específicamente en el hígado, lo que evita efectos adversos musculares, una ventaja en pacientes intolerantes a estatinas. Este fármaco reduce el colesterol LDL entre el 17-20% en monoterapia y hasta un 38% combinado con Ezetimiba, con un perfil de seguridad favorable y administración oral. Su coste-efectividad, es superior al de los IPCSK9 en pacientes sin eventos cardiovasculares previos (mientras que el tratamiento anual con IPCSK9 supera los 4.000-6.000 euros, el bempedoico ronda los 1.000-1.500 euros anuales
Enara Echauri Carlos, Diego Amigot Baldero y Joao Luis Modesto Dos Santos
por paciente). Además, al ser un tratamiento oral, mejora la adherencia respecto a IPCSK9, que requieren administración subcutánea cada dos a cuatro semanas.
La valoración del riesgo cardiovascular es un pilar fundamental de los objetivos de salud a nivel mundial, con una morbimortalidad muy importante asociada a la aterosclerosis. En este sentido, la estratificación del riesgo de los pacientes debe ser fiable y multidisciplinar, siendo de particular importancia identificar a los pacientes de aparente bajo riesgo que ocultan factores modificadores de la severidad de la enfermedad como pueden ser las nuevas determinaciones analíticas o nuevos métodos diagnósticos. Así, tanto atendiendo a la practicidad de la Lp (a) (una sola determinación en la vida, como norma) o a la utilidad clínica de la ECMV, se debe considerar su utilización en la práctica clínica diaria. Por último, se deben contemplar las nuevas dianas terapéuticas como el Ácido bempedoico, atendiendo a su eficacia, seguridad y facilidad de administración.
1. Borge G Nordestgaard, Anne Langsted. Lipoprotein (a) and cardiovascular disease. The Lancet, vol 404, issue 10459, 2024, p 1255-1264, ISSN 0140-06736.
2. Anagnostis P, Antza C, Trakatelli C, Lambrinoudaki I, Goulis DG, Kotsis V. The effect of menopause on lipoprotein (a) concentrations: A systematic review and meta-analysis. Maturitas. 2023. Jan; 167:39.
3. Fernandez-Friera L, Peñalvo JL, Fernandez-Ortiz A, Ibañez B, LopezMelgar B, Lacalustra M, et al. Prevalence, Vascular distribution, and multiterritorial extent of subclinical aterosclerosis in a middle-aged cohort: The PESA (Progression of Early Subclinical Atherosclerosis) study. Circulation. 2015 Jun 16; 131 (24): 2104-13.
4. Moya Mateo E, García Alonso R, Sánchez Sánchez C, Tung-Chen Y, Rodilla E, Beltran Romero L et al. Posicionamiento para el uso de la ecografía clínica multivaso en la evaluación del riesgo vascular: protocolo VASUS+. Recomendaciones 2024 del grupo de riesgo vascular, ecografía clínica de la SEMI y SEH-LELHA. Revista clínica española, vol 225, num4, p223-230 (abril 2025).
II CLINIC CONTEST NAVARRA En Fibrilación Auricular, Tromboembolismo
Venoso asociado al Cáncer y Control de Dislipemia con Terapia Oral en el ámbito sanitario de Navarra
FINALISTAS

Miriam Sánchez Sánchez.
MIR. Cardiología.
Lorena Malagón López. Cardiología.
Hospital Universitario de Navarra (HUN).


TOLERANCIA PRIMERO, EFECTIVIDAD DESPUÉS
Miriam Sánchez Sánchez y Lorena Malagón López
Mujer de 74 años que acude a consulta sucesiva de seguimiento.
Antecedentes personales:
- -Factores de riesgo cardiovascular (FRCV): dislipemia en tratamiento farmacológico. No hipertensión arterial, no Diabetes Mellitus, no fumadora, no consumo de alcohol ni otros tóxicos. No antecedentes familiares de cardiopatía isquémica precoz.
- -Adenocarcinoma de colon ascendente intervenido en 2003 y tratado posteriormente con quimioterapia adyuvante. Controles posteriores sin evidencia de recurrencia de enfermedad.
Desde el punto de vista cardiológico, antecedente de cardiopatía isquémica que debuta en agosto de 2024 con infarto agudo de miocardio sin elevación de ST (IAMSEST) con isquemia eléctrica anterior, complicado inicialmente con ligeros datos de insuficiencia cardíaca. En la coronariografía se observó enfermedad coronaria significativa de un vaso: lesión crítica de arteria descendente anterior (DA) proximal que se trató con angioplastia con balón e implante de un stent farmacoactivo con buen resultado. Ecocardiograma al alta de hospitalización con disfunción ventricular severa (FEVI 30%), aquinesia distal anteroseptal y de ápex, ventrículo derecho normofuncionante, sin valvulopatías. Por otra parte, se inició de entrada tratamiento hipolipemiante con estatina de alta potencia (Rosuvastatina 20 mg) asociada a Ezetimiba por LDL superior a 120 mg/dl (Tabla 1).
Seguimiento estrecho inicial en consulta, sobre todo dirigido a titulación de tratamiento neurohormonal con limitación por tendencia a la hipotensión arterial. Por otro lado, en la analítica sanguínea de control realizada seis semanas tras el inicio del tratamiento hipolipemiante de alta potencia, se observa que los niveles de LDL se encuentran dentro del rango objetivo en prevención segundaria (recomendándose un valor de LDL <55 mg/dl y una reducción del 50% respecto a los niveles basales(1)). Sin embargo, destaca la elevación de transaminasas cuatro veces por encima del límite superior de la normalidad (Tabla 2). Por lo tanto, se decide suspender Rosuvastatina y Ezetimiba y realizar un nuevo control analítico pasadas seis semanas, que muestra normalización de niveles de transaminasas, por lo que se decide reintroducir tratamiento hipolipemiante con Atorvastatina 80 mg asociado a Ezetimiba.
II CLINIC CONTEST NAVARRA En Fibrilación Auricular, Tromboembolismo Venoso asociado al Cáncer y Control de Dislipemia con Terapia Oral en el ámbito sanitario de Navarra Control de Dislipemia con Terapia Oral
Tratamiento habitual:
- Ácido acetil salicílico (AAS) 100 mg 0-1-0.
- Ticagrelor 90 mg 1-0-1.
- Omeprazol 20 mg 1-0-0.
- Enalapril 2,5 mg 1-0-0.
- Bisoprolol 2,5 mg 0-0-1.
- Eplerenona 12,5 mg 0-1-0.
- Dapaglifozina 10 mg 0-1-0.
- Atorvastatina/Ezetimiba 80 mg/10 mg 0-0-1.
Acude a consulta de seguimiento tras la reintroducción del tratamiento hipolipemiante de alta potencia con Atorvastatina y Ezetimiba, una vez normalizados los niveles de transaminasas. Actualmente, la paciente refiere mialgias y calambres musculares intensos que le dificultan sus actividades habituales, síntomas que comenzaron coincidiendo con la reintroducción de Atorvastatina.
Exploración física:
Constantes: tensión arterial 100/60 mmHg, frecuencia cardiaca 70 latidos por minuto (lpm), temperatura 35,7ºC y saturación basal 96%. Consciente y orientada, bien perfundida. No ingurgitación yugular a 45º, auscultación cardiaca rítmica sin soplos, auscultación pulmonar sin ruidos sobreañadidos. No edemas en extremidades inferiores.
Ante la presencia de mialgias y calambres musculares de carácter limitante, se opta por la suspensión del tratamiento con atorvastatina, programándose una visita próxima en dos semanas para reevaluar y confirmar la posible relación causal con el fármaco.
A las dos semanas, la paciente refiere mejoría importante de los síntomas. Por lo tanto, se opta por no reanudar el tratamiento con estatinas e iniciar Ácido bempedoico 180 mg al día en asociación con Ezetimiba.
Se solicita un nuevo control analítico pasadas tres semanas del inicio de Ácido bempedoico y Ezetimiba, que muestra perfil lipídico fuera de rango objetivo en prevención secundaria: colesterol total 167 mg/dl, colesterol HDL 63 mg/dl, colesterol no HDL 104 mg/dl (objetivo < 85 mg/dl), colesterol LDL 92 mg/dl y apolipoproteína B 80 mg/dl
TOLERANCIA PRIMERO, EFECTIVIDAD DESPUÉS
Miriam Sánchez Sánchez y Lorena Malagón López
(objetivo < 65 mg/dl). No obstante, dado que la paciente se encuentra asintomática y sin mialgias, manteniendo una vida activa, se decide no modificar el tratamiento hipolipemiante y realizar un segundo control analítico, otorgando un mayor margen de tiempo para valorar la respuesta al tratamiento.
Se lleva a cabo un nuevo control analítico a las siete semanas del inicio del tratamiento, observándose una mejoría notable del perfil lipídico respecto al control previo: colesterol total 158 mg/dl, colesterol HDL 74 mg/dl, colesterol no HDL 84 mg/dl, colesterol LDL 68 mg/dl y apolipoproteína B 58 mg/dl. Aunque los niveles de colesterol LDL se mantienen fuera del rango objetivo, el tratamiento con Ácido bempedoico y Ezetimiba ha logrado alcanzar los objetivos en cuanto a colesterol no LDL y apolipoproteína B (ApoB). Se opta por una estrategia terapéutica individualizada, teniendo en cuenta que la paciente permanece asintomática, por lo que no se progresa en la titulación del tratamiento hipolipemiante.
La elección del tratamiento hipolipemiante debe basarse en la evaluación conjunta del riesgo cardiovascular, los niveles de colesterol LDL y la tolerancia al tratamiento. Se ha demostrado que la reducción de los niveles de colesterol de LDL con estatinas disminuye el riesgo de eventos cardiovasculares y mortalidad, por lo que constituyen el tratamiento farmacológico de primera línea. Sin embargo, un porcentaje de pacientes (10-15%) presentan intolerancia a estatinas sobre todo por mialgias, elevaciones de creatina cinasa (CK) y de transaminasas(2). El Ácido bempedoico es un profármaco que inhibe la ATPcitrato liasa (ACL), enzima que actúa antes de la HMG-CoA reductasa, diana de las estatinas, en la síntesis de colesterol. Su acción reduce el colesterol intracelular, aumenta los receptores de LDL y disminuye los niveles plasmáticos de colesterol LDL, además de suprimir la síntesis hepática de Ácidos grasos.
En pacientes intolerantes a estatinas, el Ácido bempedoico ha demostrado una reducción significativa del colesterol LDL frente a placebo, con descensos medios entre el 21 % y el 28 %. Además, la combinación con Ezetimiba logró una reducción del 38 % en comparación con placebo.
En conclusión, aunque el Ácido bempedoico presenta un efecto hipolipemiante más modesto en comparación con las estatinas de alta
II CLINIC CONTEST NAVARRA En Fibrilación Auricular, Tromboembolismo Venoso asociado al Cáncer y Control de Dislipemia con Terapia Oral en el ámbito sanitario de Navarra
Control de Dislipemia con Terapia Oral
potencia, constituye una alternativa válida en casos de intolerancia. Según nuestra experiencia, se recomienda realizar el control analítico a partir de las 8 semanas del inicio del tratamiento para una adecuada valoración de su eficacia.
INTOLERANTES A
TOLERANCIA PRIMERO, EFECTIVIDAD DESPUÉS
Miriam Sánchez Sánchez y Lorena Malagón López
1. Servicio de Cardiología del Hospital Universitario de Navarra. Protocolo para el manejo del control lipídico tras un síndrome coronario agudo. 2024.
2. Agencia española de medicamentos y productos sanitarios. Informe de Posicionamiento Terapéutico de Ácido bempedoico (Nilemdo®) y Ácido bempedoico con ezetimiba (Nustendi®) en hipercolesterolemia. Mayo 2022.


II CLINIC CONTEST NAVARRA En Fibrilación Auricular, Tromboembolismo Venoso asociado al Cáncer y Control de Dislipemia con Terapia Oral en el ámbito sanitario de Navarra
CASOS PRESENTADOS

Maddi Taboada Palacios.
MIR. Medicina Interna.
Laura Valderas Monge.
MIR. Medicina Interna.
Hospital Universitario de Navarra (HUN).
Ángela Gómez Garduño.
Medicina Interna.
Hospital García Orcoyen. Estella.

II CLINIC CONTEST NAVARRA En Fibrilación Auricular, Tromboembolismo Venoso asociado al Cáncer y Control de Dislipemia con Terapia Oral en el ámbito sanitario de Navarra Control de Dislipemia con Terapia Oral
Paciente de 65 años, derivada desde Atención Primaria a consultas de Medicina Interna por astenia progresiva, que atribuye principalmente al cuidado de un familiar. Ha perdido un total de 2-3 kg de peso en 4 meses y ha padecido episodios de dolor en epigastrio de tipo cólico acompañado de 3 deposiciones diarreicas al día.
Como antecedentes personales nos encontramos con lo siguiente:
- Fue estudiada por el Servicio de Cardiología por palpitaciones, siendo atribuidas a posibles rachas breves de taquicardias paroxísticas supra-ventriculares oligosintomáticas. Además, también valorada por el mimo Servicio por dolor de tipo anginoso, con prueba de esfuerzo no valorable por imposibilidad para su realización completa, con estudio gammagráficamente negativo para isquemia miocárdica a la frecuencia alcanzada y el TAC cardiaco mostró arterias coronarias sin lesiones.
- Hipercolesterolemia.
- Anemia ferropénica de origen hemorroidal.
- Osteopenia.
- Es fumadora de 20 cigarrillos al día, desde los 20 años de edad.
Su tratamiento habitual consiste en 1 comprimido al día de calcio + vitamina D3 a dosis de 1.000 mg/880 unidades internacionales y un comprimido de levadura de arroz rojo después de la cena.
Durante la valoración en consultas de Medicina Interna refiere astenia intensa de un año de evolución, con sensación de cansancio desde el momento en el que se despierta; además, refiere mal descanso nocturno con sueño fraccionado cada 3 horas. Niega clínica cardiorrespiratoria en el momento actual, pero sí explica episodios de bronquitis aguda de repetición, con uno o dos cuadros al año, por los que requiere toma de antibiótico y uso de inhaladores que le pauta el Médico de Atención Primaria. Refiere patrón intestinal con 2-3 deposiciones diarreicas al día de 6 meses de evolución, que en el momento actual han mejorado; paralelamente, pérdida de peso de 2-3 kg de peso en los últimos 4 meses. Por otro lado, refiere cefalea holocraneal habitual, que va en aumento en las últimas dos semanas.
Se explora a la paciente por sistemas, teniendo una exploración neurológica rigurosamente normal, ausencia de adenopatías palpables,
una auscultación cardiopulmonar sin hallazgos de interés, el abdomen blando y depresible sin signos de patología aguda y las extremidades inferiores sin edemas ni signos de trombosis venosa profunda.
Con toda la información mencionada que se obtiene en la primera consulta, se solicita un análisis de sangre completo con intención de indagar en posibles causas de la astenia por la que se consulta y se cita a la paciente para revisión de resultado.
En dicha analítica se puede observar: un hemograma normal, con una velocidad de sedimentación en 1ª hora no elevada, la función renal preservada, la glucemia en rango y una hemoglobina glicada de 5,3%, una ferritina en 47ug/L con el resto del perfil férrico en rango, el calcio y la vitamina D con niveles adecuados y con una batería completa de serologías negativa. Lo que sí que destaca en el análisis mencionado es el perfil lipídico, donde se evidencia un colesterol total de 297 mg/dl, un HDL 67 mg/dl, colesterol no HDL 230 mg/dl, índice Colesterol/Colesterol HDL de 4,4, el LDL calculado de 205 mg/dl y con unos triglicéridos de 124 mg/dl.
Además, en esta segunda consulta y viendo los resultados del análisis mencionado, se realiza una ecoscopia carotidea donde se visualizan dos placas de ateroma en la carótida interna derecha y en el bulbo derecho de 1,3 cm y 1,2 cm respectivamente; por otro lado, en la carótida izquierda, no se encuentran placas de ateroma pero se observa un grosor de íntima media (GIM) de 0,9, siendo este valor un marcador de aterosclerosis temprana y riesgo cardiovascular. También se realiza ecoscopia de las arterias femorales donde no se visualizan placas.
Con todo ello, se reafirma el diagnóstico previo de hipercolesterolemia y se calcula el SCORE2, dando un resultado de un 8.7 % de riesgo de sufrir un evento cardiovascular en 10 años, siendo este un riesgo intermedio para su edad. Teniendo en cuenta esta información y con un TAC coronario en el 2020 sin alteraciones, el objetivo de LDL en esta paciente sería de <100 mg/dl; pero, si añadimos a la ecuación el hecho de que se ha detectado ateromatosis carotidea subclínica y que se trata de una paciente fumadora, el riesgo de padecer un evento cardiovascular en 10 años se eleva a “riesgo alto” por lo que el objetivo es más estricto con necesidad de descenso del LDL a <70 mg/dl.
Teniendo en cuenta el objetivo mencionado y recordando que previamente únicamente era tomadora de cápsulas de arroz rojo, se decide inicio de terapia con un comprimido por la noche de Rosuvastatina
II CLINIC CONTEST NAVARRA En Fibrilación Auricular, Tromboembolismo Venoso asociado al Cáncer y Control de Dislipemia con Terapia Oral en el ámbito sanitario de Navarra Control de Dislipemia con Terapia Oral
20 mg+Ezetimiba 10 mg, con cita para revisión y nuevos análisis de sangre de control en 3 meses.
A las dos semanas del inicio del tratamiento hipolipemiante, la paciente se pone en contacto con las consultas de Medicina Interna explicando intolerancia al tratamiento por aumento de cefalea, empeoramiento del insomnio y dolor con sensación de debilidad de predominio en extremidades superiores. Dada la intolerancia y la necesidad de tratamiento para conseguir los objetivos de LDL mencionados, se decide suspender el comprimido de Rosuvastatina+Ezetimiba y se inicia tratamiento con Ácido bempedoico 180 mg al día.
En la consulta de revisión, que finalmente se realizó a los 4 meses, se observa un LDL en el análisis sanguíneo de 93 mg/dL, con valores previos de 205 mg/dl, siendo el Ácido bempedoico además muy bien tolerado por la paciente. Por ello, se decide continuar con el fármaco hasta conseguir los niveles mencionados de <70 mg/dL, teniendo en cuenta su riesgo cardiovascular elevado, y se insiste en la necesidad del cese tabáquico.
Este caso clínico es el ejemplo claro de la ventana de oportunidad que se nos plantea en cualquier acto médico para mejorar la salud de los pacientes en aspectos que probablemente no sospechamos en un primer momento. La paciente explicada acude a consulta de un médico especialista por astenia, que finalmente se ha podido mejorar con una correcta higiene del sueño y mejorando los hábitos de vida a unos más saludables, pero esa misma consulta ha sido una oportunidad para poder estudiar su salud en otro aspecto, como es el riesgo cardiovascular. Las enfermedades cardiovasculares encabezan la lista de causas prematuras de mortalidad en todo el mundo, pero está en manos de cualquier médico detectar el riesgo de padecer estas enfermedades, siendo posible en muchas ocasiones detectarlo con pruebas complementarias tan sencillas como puede ser un análisis de sangre. En esta paciente, en una única consulta, se ha detectado un riesgo cardiovascular elevado y se ha podido así realizar un correcto manejo para prevenir eventos cardiovasculares futuros, actuando por ello en el escalón de la prevención primaria a raíz de una consulta por otra causa.
Finalmente, mencionar los nuevos fármacos que se comienzan a utilizar en el tratamiento hipolipemiante, como por ejemplo el Ácido bempedoico, que se trata de una terapia oral de toma única al día que resulta cómoda para el paciente y que puede ser de gran ayuda
Maddi Taboada Palacios, Laura Valderas Monge y Ángela Gómez Garduño
en pacientes, como la que se ha expuesto en este documento, que tengan intolerancia a las clásicas estatinas.
1. Sociedad Española de Arteriosclerosis. Estándares de la Sociedad Española de Arteriosclerosis 2024 para el control global del riesgo vascular. Barcelona: SEA; 2024.
2. Comité Español Interdisciplinario para la Prevención Cardiovascular (CEIPC). Guía Europea de Prevención Cardiovascular en la Práctica Clínica: Adaptación Española del CEIPC 2008. Madrid: Instituto de Salud Carlos III; 2008.
3. Mach F, Baigent C, Catapano AL, Koskinas KC, Casula M, Badimon L, et al. 2019 ESC/EAS Guidelines for the management of dyslipidaemias: lipid modification to reduce cardiovascular risk. Eur Visseren FLJ, Mach F, Smulders YM, Carballo D, Koskinas KC, Bäck M, et al. 2021 ESC Guidelines on cardiovascular disease prevention in clinical practice: Developed by the Task Force for cardiovascular disease prevention in clinical practice with representatives of the European Society of Cardiology and 12 medical societies. Eur Heart J. 2021;42(34):3227–337.
4. Nissen SE, Lincoff AM, Brennan D, Ray KK, Kastelein JJP, Bash D, et al. Bempedoic Acid and Cardiovascular Outcomes in Statin-Intolerant Patients. N Engl J Med. 2023;388(15):1353–64.
II CLINIC CONTEST NAVARRA En Fibrilación Auricular, Tromboembolismo Venoso asociado al Cáncer y Control de Dislipemia con Terapia Oral en el ámbito sanitario de Navarra
CASOS PRESENTADOS

Maite Odriozola Garmendia.
MIR. Análisis Clínicos.
Amaia Loyola Arrieta.
MIR. Cardiología. Marina Virosta Gil.
Cardiología. Hospital Universitario de Navarra (HUN).


Mujer de 28 años, antecedentes de epilepsia focal temporal, en tratamiento con Lacosamida 50 mg/12h.
Acude a consulta derivada por su médico de Atención Primaria por alteraciones analíticas persistentes de colesterol, inicia tratamiento con Atorvastatina 40 mg:
- AS en junio de 2023: Colesterol total 282 mg/dL, HDL 140 mg/ dL, LDL calculado 125 mg/dL, triglicéridos 60 mg/dL, colesterol/ colesterol HDL 2.
- AS en agosto de 2024: Colesterol total 245 mg/dL, HDL 123 mg/ dL, LDL calculado 110 mg/dL, triglicéridos 90 mg/dL, colesterol/ colesterol HDL 2.
- AS en febrero de 2025: Colesterol total 240 mg/dL, HDL 138 mg/ dL, LDL calculado 96 mg/dL, triglicéridos 85 mg/dL, colesterol/ colesterol HDL 2.
Resto de hemograma, coagulación y bioquímica sin alteraciones destacables.
A la anamnesis, la paciente no describe síntomas de carácter cardiovascular. Refiere que en su familia “todos tienen el colesterol alto, pero es del bueno”. No antecedentes familiares de enfermedades cardiovasculares. No refiere cefalea, no dolor torácico ni abdominal, no náuseas ni vómitos, no alteraciones visuales, no lesiones cutáneas, no frialdad en extremidades, no síntomas compatibles con claudicación intermitente.
Exploración física:
Anodina. No se observan xantomas ni arcos corneales. Pulsos distales presentes, no alteraciones sensitivas. Auscultación cardíaca: rítmico, sin ruidos sobreañadidos. Auscultación pulmonar: murmullo vesicular conservado, sin ruidos patológicos. Exploración abdominal: no se palpan masas ni megalias, no doloroso, ruidos peristálticos presentes, no soplo. Exploración neurológica sin alteraciones.
El diagnóstico nos sugiere una hiperalfalipoproteinemia primaria. Por lo tanto, explicamos a la paciente la benignidad del cuadro e indicamos seguimiento por parte de su médico de Atención Primaria. Se retira la Atorvastatina.
II CLINIC CONTEST NAVARRA En Fibrilación Auricular, Tromboembolismo Venoso asociado al Cáncer y Control de Dislipemia con Terapia Oral en el ámbito sanitario de Navarra Control de Dislipemia con Terapia Oral
Las HDL desempeñan un claro papel protector contra la aterosclerosis mediante la inhibición de algunos mecanismos patogénicos de las LDL u otros agentes inflamatorios, pero especialmente mediante el transporte inverso de colesterol.
Estos efectos son tan relevantes que diversos estudios han puesto de manifiesto que los valores de HDL pueden modificar el efecto de las LDL en la incidencia de las enfermedades cardiovasculares o ser incluso mejor predictor en el caso de la prevención primaria.
A diferencia de las LDL, las HDL son partículas complejas y con diferentes fenotipos no conocidos del todo, lo cual las convierte en un objetivo creciente para la investigación lipidológica. Se ha observado que cifras elevadas de HDL están asociadas a una disminución del riesgo de enfermedad coronaria y a una mayor longevidad.
La medición de HDL en el laboratorio se realiza mediante el método homogéneo (enzimático-colorimétrico). Esta técnica no requiere precipitación, los reactivos específicos bloquean las LDL/VLDL y permiten solo reacción del HDL con enzimas para su posterior medición por espectrofotómetro a longitud de onda de 600 nm. Posteriormente, el software calcula el valor mediante la curva de calibración. Las ventajas de este método es que es automatizado y rápido, no requiere precipitación. Se trata de una técnica de alta precisión y repetitividad y es adecuado para el manejo de grandes volúmenes de muestras.
La hiperalfalipoproteinemia (HAL) es una alteración del patrón lipídico, en el que se encuentra una elevación de HDL, superiores al percentil 90 de individuos de su mismo grupo de edad y sexo de una población de referencia. La concentración de las partículas VLDL y LDL se encuentra dentro de la normalidad: LDL <150 mg/dL y triglicéridos <200 mg/dL. Se transmite hereditariamente, según un patrón autosómico dominante y ocasionalmente con carácter poligénico o multifactorial, existiendo asimismo formas adquiridas. En las formas primarias, tanto los heterocigotos como los homocigotos presentan cifras de HDL elevadas, aunque en distintas proporciones. Se ha observado en familias con HAL una elevación de las apo A-I y apo E, con valores normales de apo B.
Si bien las HAL son consideradas situaciones protectoras de presentación de episodios cardiovasculares, el cambio de diagnóstico que puede acontecer en el transcurso del tiempo ha de ser tenido en consideración. Ante el diagnóstico de HAL primarias, se deberían evi-
tar recomendaciones farmacológicas y consejos higiénico-dietéticos restrictivos para su posible hipercolesterolemia acompañante. La HAL primaria puede ser utilizado como un factor a restar del resto de factores de riesgo que presente el paciente dentro de la valoración global del riesgo cardiovascular.
- La hiperalfalipoproteinemia se considera una situación protectora.
- No precisa ningún tratamiento dietético ni farmacológico.
- Se debe evitar el posible riesgo de iatrogenia en relación a dieta y medidas de control lipídico innecesarias.
II CLINIC CONTEST NAVARRA En Fibrilación Auricular, Tromboembolismo Venoso asociado al Cáncer y Control de Dislipemia con Terapia Oral en el ámbito sanitario de Navarra Control de Dislipemia con Terapia Oral
Artículo de revista:
Revista Médica Clínica Las Condes. (2012). Rev. Med. Clin. Condes, 23(6), 689-692.
Páginas web:
1. Fundación Española del Corazón. (s.f.). Colesterol y riesgo cardiovascular. Fundación del Corazón. https://fundaciondelcorazon.com/prevencion/ riesgo-cardiovascular/colesterol.html
2. Revista Española de Cardiología. (s.f.). HDL: Un nuevo biomarcador en insuficiencia cardiaca. Revista Española de Cardiología. https:// www.revespcardiol.org/es-hdl-un-nuevo-biomarcador-insuficienciaarticulo-S0300893222001762
3. Revista Española de Cardiología. (s.f.). Parámetros lipídicos y objetivos terapéuticos. Revista Española de Cardiología. https://www. revespcardiol.org/es-parametros-lipidicos-objetivos-terapeuticosarticulo-S1131358712700407
4. University of California San Diego. (s.f.). Apolipoproteína A. MyHealth UCSD. https://myhealth.ucsd.edu/RelatedItems/167,apolipoprotein_a_ES
5. Clínica Universidad de Navarra. (s.f.). Hiperalfalipoproteinemia. Clínica Universidad de Navarra. https://www.cun.es/diccionario-medico/terminos/ hiperalfalipoproteinemia
6. Álvarez, C., & Ramos, A. (2013). Mecanismos básicos: estructura, función y metabolismo de las lipoproteínas. Clínica e Investigación en Arteriosclerosis, 25(3), 123 -132. https://doi.org/10.1016/j.arteri.2013.03.001
7. Wiener Lab Group. (s.f.). HDL Cholesterol. https://access.wiener-lab.com/ VademecumDocumentos/Vademecum%20espanol/hdl_cholesterol_fast_ sp.pdf
8. Departamento de Bioquímica y Biología Molecular, Universidad de Salamanca. (s.f.). Lipoproteínas de alta densidad (HDL). h

II CLINIC CONTEST NAVARRA En Fibrilación Auricular, Tromboembolismo Venoso asociado al Cáncer y Control de Dislipemia con Terapia Oral en el ámbito sanitario de Navarra
CASOS PRESENTADOS

Pablo Aragón Muñoz.
MIR. Medicina Interna.
Ainhoa Sánchez Pastor.
MIR. Medicina Interna.
Marina Virosta Gil.
Medicina Interna
Hospital Universitario de Navarra (HUN).

II CLINIC CONTEST NAVARRA En Fibrilación Auricular, Tromboembolismo Venoso asociado al Cáncer y Control de Dislipemia con Terapia Oral en el ámbito sanitario de Navarra
Control de Dislipemia con Terapia Oral
La enfermedad vascular aterosclerótica constituye la principal causa de morbimortalidad en los países desarrollados. Esta patología crónica y progresiva está íntimamente relacionada con la acumulación de placas de ateroma y reacciones inflamatorias en la pared arterial, lo que genera estrechamiento luminal y riesgo de eventos aterotrombóticos como infartos de miocardio (IAM) o ictus. Diversos estudios han confirmado la relación directa entre los niveles de colesterol LDL (cLDL) y la progresión de la aterosclerosis, estimándose que por cada mmol/L que disminuye el cLDL, se reduce en un 22% el riesgo relativo de eventos vasculares.
La coexistencia de hipertensión arterial (HTA), dislipemia (DLP), diabetes mellitus (DM), obesidad o enfermedad renal crónica (ERC) en un mismo paciente, como ocurre con frecuencia en la práctica clínica, incrementa el riesgo de eventos cardiovasculares y complica el manejo terapéutico. La obesidad y la ERC no solo actúan como factores de riesgo cardiovascular (FRCV) independientes, sino que también dificultan el control metabólico y terapéutico de los pacientes. En los últimos años, se ha producido una revolución en el manejo de la DLP con la aparición de nuevas estrategias farmacológicas como los inhibidores de PCSK9, el Inclisirán o el Ácido bempedoico. Este último, aprobado recientemente, actúa inhibiendo la ATP citrato liasa, enzima clave en la síntesis de colesterol hepático, que ha demostrado ser eficaz en la reducción del cLDL, especialmente en pacientes con intolerancia a estatinas o que requieren terapia combinada.
Varón de 73 años, autónomo, independiente para actividades básicas, con los siguientes antecedentes: HTA, DM tipo 2 insulinodependiente, con mal control metabólico (HbA1c 8%), DLP de difícil control. Obesidad grado II. Cardiopatía isquémica crónica: IAM inferior y posterior, enfermedad coronaria de tres vasos revascularizado, con función ventricular izquierda conservada. Fibrilación auricular (FA) permanente (CHAD2DS2VASC 5 puntos, HASBLED 5 puntos). ERC estadio G3bA2. Síndrome facetario y hernia discal L4-L5 intervenida. Exfumador desde 2013 (IPA 30 paquetes/año). Bebedor de alcohol ocasional. Tratamiento habitual: Ácido acetilsalicílico 100 mg/24h, Edoxabán 30 mg/24h, Bisoprolol 5 mg/12h; Furosemida 40 mg/12h; Enalapril 5 mg/12h; Sitagliptina/Metformina 50/1000 mg/12h; Rosuvastatina/
Pablo Aragón Muñoz, Ainhoa Sánchez Pastor y Cristina García Labairu
Ezetimiba 20 mg/10 mg/24h; Pregabalina 50 mg/24h; Salmeterol/ Fluticasona/ 12 horas inh; Toujeo 30 ui en desayuno.
Acude a Urgencias por disnea progresiva, ortopnea y aumento de edemas de una semana de evolución, coincidiendo con transgresión dietética en celebraciones familiares. A su llegada se encuentra con hipotensión leve, FA a 120 lpm, crepitantes bibasales y edemas en miembros inferiores. Analíticamente destaca elevación de NT-proBNP (1487 pg/mL), PCR elevada (54.2 mg/L), sin daño miocárdico ni deterioro renal, objetivando en la radiografía de tórax redistribución vascular y mínimo derrame pleural bilateral.
Se diagnostica de descompensación de insuficiencia cardiaca con fracción de eyección preservada (IC-FEVIp) en el contexto de FA con respuesta rápida, ingresando en planta de hospitalización. Se instaura tratamiento depletivo con diuréticos intravenosos con buena respuesta clínica, mejoría de la congestión evaluada de forma multiparamétrica y ecografía clínica, y pérdida ponderal asociada. Durante el ingreso se revisa su tratamiento, detectándose mal control lipídico crónico, con cifras previas de LDL de hasta 170 mg/dL. Pese a múltiples intentos de optimización con estatinas de alta potencia por su médico de Atención Primaria, y seguimiento dietético por Enfermería Comunitaria, es derivado a la Unidad de RCV de Medicina Interna en 2023 donde se añade Ezetimiba 10 mg al presentar una cifra de cLDL 127 mg/dl. Sin embargo, el paciente abandona los controles y no acude a las siguientes consultas. Dos años después del último seguimiento, el perfil lipídico durante el ingreso muestra: Colesterol total 127 mg/ dl; HDL 38 mg/dl, LDL de 74 mg/dL, Triglicéridos 89 mg/dl, Lipoproteína A 24 mg/dl, con adecuada adherencia al tratamiento según refiere. Dado su perfil de riesgo cardiovascular muy alto se consensua iniciar Ácido bempedoico 180 mg/24h como terapia adicional, dado que no cumple criterios para inhibidores de PCSK9, estableciendo un objetivo de LDL < 55 mg/dL. En el marco de la reevaluación global del RCV y de la IC, se suspende Metformina/Sitagliptina, iniciando Empagliflozina 10 mg/24h, Finerenona 10 mg/24h y Semaglutida 0,25 mg, fármacos modificadores de la enfermedad y con beneficios demostrados en reducción de eventos cardiovasculares (MACE), progresión de enfermedad renal, control glucémico y riesgo cardiovascular alto, además de pérdidas significativas de peso.
Dos meses tras el alta, el paciente es valorado en consulta de RCV, asintomático, con adecuada adherencia al tratamiento y sin presentar
II CLINIC CONTEST NAVARRA En Fibrilación Auricular, Tromboembolismo Venoso asociado al Cáncer y Control de Dislipemia con Terapia Oral en el ámbito sanitario de Navarra Control de Dislipemia con Terapia Oral
efectos secundarios. La analítica de control revela un LDL de 58 mg/ dL, muy próximo al objetivo, por lo que se decide mantener la pauta terapéutica actual, reforzando la educación sanitaria y seguimiento conjunto con la Unidad de Insuficiencia Cardíaca.
El abordaje de los factores de riesgo cardiovascular (FRCV) y el control lipídico en pacientes pluripatológicos especialmente en riesgo muy alto es un reto y este caso ilustra cómo la inercia terapéutica, las dificultades en la adherencia y la complejidad de las comorbilidades pueden perpetuar un riesgo residual elevado, a pesar de tratamientos previos adecuados. Diferentes guías, sociedades y consensos remarcan que alcanzar el objetivo de cLDL < 55 mg/dL (o incluso < 40 mg/dL en riesgo muy alto) debe ser una prioridad urgente, y propone abandonar la estrategia secuencial clásica por un enfoque más agresivo y precoz: el llamado “Fire to Target”, abogando por combinaciones que alcancen los objetivos establecidos lo antes posible. En este paciente, con enfermedad vascular establecida, DM tipo 2 con afectación de órgano diana, ERC G3bA2 y obesidad, el RCV acumulado justifica este abordaje intensivo. A pesar de una estatina de alta potencia y Ezetimiba, presentaba cifras de LDL persistentemente elevadas. La introducción del Ácido bempedoico permitió un descenso adicional del LDL-C del 22% según los datos del consenso, sin asociarse a efectos adversos relevantes ni interacciones con su polifarmacia. El Ácido bempedoico al actuar inhibiendo la ATP-citrato liasa en el hígado evita los efectos musculares indeseables de las estatinas, lo que lo convierte en un fármaco ideal para intolerantes o como tratamiento combinado. Además, su efecto antiinflamatorio, evidenciado por la reducción de proteína C reactiva, es especialmente atractivo en pacientes con componente inflamatorio y riesgo residual elevado, como los que presentan insuficiencia cardiaca o diabetes
El seguimiento estrecho en la Unidad de RCV, en coordinación con la Unidad de IC, permitió monitorizar de forma precoz la eficacia del tratamiento. A los dos meses, el paciente alcanzaba cifras de LDL de 58 mg/dl, cercanas al objetivo, destacando la importancia del abordaje intensivo y multidisciplinar. Este enfoque integral permitió además la introducción de fármacos modificadores de la IC con beneficios demostrados en reducción de eventos cardiovasculares (MACE), progresión de enfermedad renal, control glucémico y pérdidas significativas
Pablo Aragón Muñoz, Ainhoa Sánchez Pastor y Cristina García Labairu
de peso. Por tanto, el beneficio de estos tratamientos no es únicamente metabólico o hemodinámico, sino que reduce eventos y hospitalizaciones, configurando un arsenal terapéutico que aborda distintas dianas fisiopatológicas. En definitiva, el caso subraya el papel central de la Medicina Interna en la coordinación de múltiples especialidades, integrando los distintos frentes terapéuticos del paciente complejo. Las Unidades de Lípidos o de Riesgo Cardiovascular representan un entorno idóneo para implementar estrategias individualizadas de control intensivo, mientras que las Unidades de IC complementan este abordaje con una visión centrada en la fragilidad y la funcionalidad.
- La aterosclerosis es la principal causa de muerte cardiovascular y requiere una intervención precoz y sostenida de los factores de riesgo cardiovascular.
- El Ácido bempedoico se erige como fármaco eficaz y seguro en el manejo de la DLP en pacientes de alto riesgo, control lipídico subóptimo o tratamiento combinado.
- La existencia de unidades de riesgo cardiovascular especializadas permite individualizar el tratamiento, mejorar la adherencia y garantizar un seguimiento estrecho. El abordaje multidisciplinar y el seguimiento continuado son fundamentales para reducir el riesgo de descompensaciones y eventos cardiovasculares futuros.
1. Vivas D, Escobar C, Cordero A, Fernández-Olmo R, Oterino A, BlancoEchevarría A, et al. Uso de nuevas terapias hipolipemiantes en la práctica clínica. Consenso SEC/SEA/SEEN/SEMFYC/SEMERGEN/SEMG/SEN/SEACV/ S.E.N. REC CardioClinics. 2024. https://doi.org/10.1016/j.rccl.2024.06.002 203;:contentReference[oaicite:0]{index=0}.
II CLINIC CONTEST NAVARRA En Fibrilación Auricular, Tromboembolismo Venoso asociado al Cáncer y Control de Dislipemia con Terapia Oral en el ámbito sanitario de Navarra
CASOS PRESENTADOS

June García Bascones.
MIR. Medicina Interna.
Maider Olaizola Guerrero.
MIR. Medicina Interna.
Sergio Arnedo Hernández.
Medicina Interna
Hospital Universitario de Navarra (HUN).


June García Bascones, Maider Olaizola Guerrer y Sergio Arnedo Hernández
Varón de 60 años, médico de profesión, independiente para las actividades básicas de la vida diaria. Entre sus antecedentes personales destacan hipertensión arterial desde los 50 años, en tratamiento con Nebivolol oral 5 miligramos cada 24 horas, dislipemia en tratamiento con rosuvastatina 10 mg cada 24 horas, asma alérgica, esteatosis hepática y discopatía lumbar. Es exfumador de 25 paquetes-año y no consume alcohol.
Tiene antecedentes familiares de riesgo cardiovascular precoz; su hermano tiene dislipemia y tuvo un infarto agudo de miocardio a los 50 años. Además, su madre falleció a causa de un accidente cerebrovascular.
Estando asintomático, el paciente realizó un curso formativo de ecografía, hallando una ausencia de flujo en su propia arteria carótida derecha mediante ecografía Doppler. Ante dicho hallazgo, se solicitó un angioTAC de troncos supraaórticos (TSA), en el que se objetivó marcada alteración de la morfología de las arterias intracraneales con presencia de estenosis multisegmentarias de aspecto arrosariado en arterias cerebrales posteriores (ACP), medias (ACM) y anteriores (ACA), de forma más significativa en los segmentos M1. Lo descrito planteaba diagnóstico diferencial entre ateromatosis intracraneal y una vasculitis del sistema nerviosos central, por lo que se derivó al paciente a consultas de Neurología.
El paciente se encontraba asintomático desde el punto de vista neurológico, a excepción de parestesias ocasionales en zona media del labio superior, y la exploración neurológica era normal. Se decidió completar el estudio con resonancia magnética (RM) craneal, ecografía Doppler de TSA y Doppler transcraneal. La RM no objetivó alteraciones en la pared de los vasos cerebrales sugerentes de vasculitis. El estudio angiográfico identificó una asimetría con una estenosis no significativa en la ACM proximal derecha, y el Doppler transcraneal mostró una aceleración focal en ACM derecha, en el segmento M1. Todo lo anterior era compatible con una ateromatosis intracraneal asintomática, con estenosis hemodinámicamente significativa en ACM derecha segmento M1 (menor del 50%). Ante dichos resultados, se pautó antiagregación con Adiro 100 mg y se derivó al paciente a la consulta de riesgo cardiovascular (RCV) de Medicina Interna.
II CLINIC CONTEST NAVARRA En Fibrilación Auricular, Tromboembolismo Venoso asociado al Cáncer y Control de Dislipemia con Terapia Oral en el ámbito sanitario de Navarra Control de Dislipemia con Terapia Oral
El paciente acudió a la primera consulta de RCV en enero 2024, asintomático. Presentaba sobrepeso (índice de masa corporal 27 kg/ m2), y el resto de la exploración física era anodina. Revisando el historial de analíticas del paciente, se objetivaron cifras elevadas de colesterol desde hace más de 10 años. El perfil lipídico del paciente en 2014 fue: colesterol total (CT) 300 mg/dl, colesterol LDL (C-LDL) 207 mg/dl, colesterol HDL (C-HDL) 43 mg/dl y triglicéridos (TG) 244 mg/dl. Desde dicha analítica, inició la toma de estatinas durante años controlado por su médico de Atención Primaria, con adecuada adherencia y tolerancia (Atorvastatina 10 mg de 2015 a 2021, Rosuvastatina 10 mg de 2021 a 2023 y Rosuvastatina 20 mg en 2023), hasta el episodio actual.
Se planteó la posibilidad de que el paciente tuviera una hipercolesterolemia familiar heterocigota (HFH), por lo que se utilizaron los criterios Dutch Lipid Clinic Network, en los cuales sumó un total de 4 puntos (3 puntos por cifras de colesterol y 1 por antecedente familiar de eventos cardiovasculares precoces). Esto era sugestivo una posible HFH, por lo que se solicitó analítica completa con perfil lipídico y estudio genético. El estudio genético no identificó variantes asociadas a hipercolesterolemia familiar, hipercolesterolemia autosómica recesiva o déficit de lipasa ácida lisosomal. En analítica sanguínea destacaba un colesterol total 159 mg/dl con C-LDL de 86 mg/dl y C-HDL 47 mg/ dl, y TG 130 mg/dl (tras comienzo de rosuvastatina 20 mg ese mismo año). Además, se solicitó la determinación de lipoproteína a (LpA) (<8 mg/dl), apolipoproteína A-1 (165 mg/dl) y apolipoproteína B-100 (80 mg/dl), todas ellas con resultados en el rango de la normalidad. Dado que se trataba de un paciente de muy alto riesgo cardiovascular, con objetivo de C-LDL inferior a 55 mg/dl, se añadió Ezetimibe 10 mg cada 24 horas al tratamiento.
Tras once meses de tratamiento hipolipemiante bien tolerado, en diciembre 2024, el colesterol total descendió a 145 mg/dl, el C-HDL a 43 mg/dl y el C-LDL a 67 mg/dl. A pesar de no cumplir los objetivos de C-LDL establecidos por las guías, el paciente no era candidato a tratamiento oral con Ácido bempedoico ni subcutáneo con inhibidores de PCSK9 (iPCSK9) o Inclisirán, por las limitaciones del visado en Navarra.
Los hallazgos en las pruebas de imagen confirman enfermedad ateroesclerótica establecida en forma de ateromatosis intracraneal múltiple, lo que estratifica al paciente como muy alto riesgo cardiovascular.
June García Bascones, Maider Olaizola Guerrer y Sergio Arnedo Hernández
En este caso, con el objetivo de reducir el C-LDL por debajo de 55 mg/dl y al menos un 50% de los valores basales, las guías de la Sociedad de Española de Arteriosclerosis (SEA) (1) y Sociedad Europea de Cardiología (ESC) (2) recomiendan empezar tratamiento hipocolesterolemiante de alta intensidad desde el inicio, para alcanzar el objetivo terapéutico. Las últimas recomendaciones dejan de lado la práctica de comenzar con estatinas y continuar más adelante con otros tratamientos, dado que se ha visto que una gran parte de los pacientes no alcanzan los objetivos. Así, se posiciona como primera opción comenzar con terapia oral combinada con estatinas y Ezetimiba, o asociación desde el inicio con Ácido bempedoico, ya que se ha demostrado que esta estrategia facilita la adherencia y la consecución de los objetivos. Además, disminuye los efectos adversos del uso de estatinas a altas dosis durante tiempo prolongado. Indican que el tratamiento combinado es obligatorio en casos de cifras basales de C-LDL superiores a 110 mg/dL.
Por ficha técnica, en Europa el Ácido bempedoico está indicado en adultos con hipercolesterolemia primaria o dislipemia mixta en combinación con una estatina, o una estatina con otros tratamientos hipolipemiantes, que no puedan alcanzar sus objetivos de C-LDL con la dosis máxima tolerada de una estatina (o en monoterapia o en combinación en pacientes en los que esté contraindicada una estatina).
Sin embargo, actualmente, en Navarra el Ácido bempedoico está restringido para pacientes con hipercolesterolemia familiar heterocigótica o con enfermedad vascular aterosclerótica no controlados con la dosis máxima de estatina y Ezetimiba (o únicamente con Ezetimiba en caso de intolerancia o contraindicación a estatinas), siempre y cuando tengan niveles de C-LDL iguales o superiores a 70 mg/dL tras un mínimo de 8 semanas de tratamiento con atorvastatina 80 mg diarios o rosuvastatina 40 mg diarias asociadas a Ezetimiba.
Por tanto, teniendo en cuenta las restricciones de visado de Navarra (3), hay casos, como el descrito anteriormente, que se beneficiarían de la combinación de tratamientos hipolipemiantes, pero al requerir previamente la toma de una estatina y Ezetimiba durante 8 semanas, el C-LDL desciende por debajo de 70 mg/dl. De esta forma, no es posible añadir Ácido bempedóico en este momento al tratamiento, a pesar de no haber alcanzado el objetivo C-LDL de 55 mg/dl.
Además, la SEA recomienda la utilización de iPCSK9 (Evolocumab y Alirocumab) e Inclisirán en pacientes que requieran reducciones de C-LDL superiores a 60%. Sin embargo, dado el visado que existe en
II CLINIC CONTEST NAVARRA En Fibrilación Auricular, Tromboembolismo Venoso asociado al Cáncer y Control de Dislipemia con Terapia Oral en el ámbito sanitario de Navarra Control de Dislipemia con Terapia Oral
Navarra (4), la mayoría de pacientes no cumplen los criterios para su prescripción. En Navarra, estos fármacos están reservados para pacientes con HFH no controlados con la dosis máxima de estatinas y para pacientes menores de 75 años con enfermedad cardiovascular establecida con C-LDL superior a 100 mg/dl a pesar de dosis máxima de estatinas y que tengan controlados el resto de factores de RCV, y en caso de intolerancia o contraindicación a estatinas con C-LDL superior a 100 mg/dl.
Los pacientes con alto y muy alto riesgo cardiovascular deben tener unos objetivos estrictos de reducción del C-LDL, recomendándose actualmente el tratamiento hipolipemiante combinado desde el inicio, con estatinas, Ezetimiba y Ácido bempedoico. Los criterios de visado de Navarra para los fármacos hipolipemiantes suponen una limitación para alcanzar los objetivos.
BIBLIOGRAFÍA
1. Mostaza JM, Pintó X, et al. Estándares de la Sociedad Española de Arteriosclerosis 2024 para el control global del riesgo vascular. Clin Investig Arterioscler. 2024;36:133-194.
2. Visseren FLJ, Mach F, et al. Guía ESC 2021 sobre la prevención de la enfermedad cardiovascular en la práctica clínica. Rev Esp Cardiol. 2022;75(5):429.e1–429.e104.
3. Servicio Navarro de Salud. Criterios de visado de Ácido bempedoico y Ácido bempedoico + ezetimiba en Navarra. Pamplona: Gobierno de Navarra.
4. Servicio Navarro de Salud. Criterios de visado de iPCSK9 e inclisirán en Navarra [Internet]. Pamplona: Gobierno de Navarra.

II CLINIC CONTEST NAVARRA En Fibrilación Auricular, Tromboembolismo Venoso asociado al Cáncer y Control de Dislipemia con Terapia Oral en el ámbito sanitario de Navarra
CASOS PRESENTADOS

ORAL:
Julene Ugarriza Ortueta. MIR. Cardiología.
Hospital Universitario de Navarra (HUN).

II CLINIC CONTEST NAVARRA En Fibrilación Auricular, Tromboembolismo Venoso asociado al Cáncer y Control de Dislipemia con Terapia Oral en el ámbito sanitario de Navarra Control de Dislipemia con Terapia Oral
Paciente de 59 años de muy alto riesgo cardiovascular.
Antecedentes:
Factores de riesgo cardiovascular: exfumador desde hace 7 años, hipertensión arterial (HTA) en tratamiento, diabético tipo 2 (DM tipo 2) en tratamiento con antidiabéticos orales, dislipémico (DLP) con mala tolerancia a estatinas por fatiga y molestias musculares, con Ezetimiba 10 mg como único tratamiento hipolipemiante.
Ingreso en cardiología en diciembre de 2019 por infarto agudo de miocardio con elevación de ST (IAMCEST) inferior, complicado con bloqueo aurículo-ventricular (BAV) completo inicial. En coronariografía urgente presenta enfermedad coronaria significativa de 1 vaso, oclusión trombótica de Coronaria Derecha (CD) media. Se realiza intervencionismo coronario (ICP) primario con trombectomía aspirativa e implante de stent farmacoactivo con buen resultado. En ecocardiograma presenta fracción de eyección ventricular izquierda (FEVI 5560%) sin valvulopatías significativas.
Posteriormente, en seguimiento en consulta de cardiología general y médico de Atención Primaria, se plantea inicialmente inclusión en programa de rehabilitación cardiaca, aunque finalmente no se incluye por mialgias severas en relación con estatinas.
Tratamiento previo: Ácido Acetilsalicílico 100 Mg 0-1-0; Alopurinol 100 Mg 0-0-1; Bisoprolol 5 Mg 1-0-0; Fluoxetina 20 Mg 1-0-0; Glimepirida 2 Mg 3-0-0; Lercadipino 10 Mg 0-0-1; Ezetimiba 10 Mg 0-0-1; Omeprazol 20 Mg 1-0-0.
Posteriormente se realiza seguimiento en consulta, donde se plantea realizar manejo integral de factores de riesgo cardiovascular por mal control de estos, tanto de perfil lipídico, como de obesidad y DM tipo 2.
Exploración física:
Constantes: tensión arterial 168/90 mmHg, frecuencia cardiaca 54 latidos por minuto (lpm), temperatura 36ºC y saturación basal 96%.
Consciente y orientado, bien perfundido. No ingurgitación yugular, auscultación cardiaca arrítmica sin soplos, auscultación pulmonar sin
PRESENTACIÓN DE UN CASO Julene Ugarriza Ortueta
ruidos patológicos. Ligeros edemas sin fóvea en extremidades inferiores.
Peso: 124.4 Kilogramos (Kg), altura: 175 centímetros (cm), IMC: 40.6, perímetro abdominal: 120 cm.
Pruebas complementarias:
- Analítica: Hemoglobina 15.1 g/dl. Plaquetas en rango. Glucosa 219 mg/dl. creatinina 0.93 mg/dL, filtrado glomerular >90 mL/ min/1,73m2. Colesterol total 181 mg/dl. HDL 43 mg/dl. LDL de 90 mg/dl, triglicéridos 203 mg/dl. Apo B 81 mg/dl. GGT 63, creatin quinasa 193. HbA1c 11.6%. PCR 4.4. TSH normal. NT pro-BNP 112.
- Electrocardiograma: bradicardia sinusal a 54 lpm. BAV de 1º grado con PR 240 ms. QRS estrecho. Eje izquierdo. No alteraciones significativas de la repolarización.
EVOLUCIÓN
Durante su seguimiento se realiza ajuste en tratamiento de factores de riesgo:
- Dado que presenta cifras de LDL 90mg/dL (<100 mg/dL y >70mg/dL), únicamente bajo tratamiento con Ezetimiba 10 mg por intolerancia a estatinas, se inicia tratamiento con Ácido bempedoico 180 mg/día. Tras 4 semanas de tratamiento se repite analítica objetivando niveles de LDL de 50mg/dL y por tanto alcanzando cifras objetivo de colesterol LDL.
- Tendencia a la hipertensión arterial de difícil control que requiere la asociación de varios fármacos antihipertensivos (Doxazosina, losartan, hidroclorotiazida y amlodipino a dosis plenas), tras lo cual se consigue control de cifras tensionales (cifras en torno a 130/75 mmHg).
- Parámetros biométricos sin cambios significativos. Se inicia tratamiento con Semaglutida oral a dosis medias. Se propone iniciar tratamiento con Tirzepatida que rechaza.
- Regular control metabólico de la DM, con HbA1c 7.7 %, pese a tratamiento con ISGLT2, Metformina y Semaglutida. Por este motivo, se derivó a consulta de endocrinología.
El infarto agudo de miocardio (IAM) constituye una de las manifestaciones más graves de la enfermedad cardiovascular aterosclerótica
II CLINIC CONTEST NAVARRA En Fibrilación Auricular, Tromboembolismo Venoso asociado al Cáncer y Control de Dislipemia con Terapia Oral en el ámbito sanitario de Navarra Control de Dislipemia con Terapia Oral
(ECV). En relación con ello, es fundamental realizar un control muy estricto de todos los factores de riesgo cardiovasculares tanto en prevención primaria como en secundaria.
La dislipemia y los niveles de LDL son uno de los factores de riesgo modificables más relevantes en la fisiopatología de la aterosclerosis y sus complicaciones, dado que la evidencia que se ha ido obteniendo a lo largo de las últimas décadas demuestra que la reducción intensiva del LDL se asocia con una disminución proporcional del riesgo de eventos cardiovasculares mayores (MACE). Por ello, en las guías de 2019 de dislipemias y en las guías de 2021 de prevención de riesgo cardiovascular de la Sociedad Europea de Cardiología, se establece que los pacientes que hayan sufrido un IAM (y que por tanto se consideran de riesgo cardiovascular muy alto), tienen la recomendación de alcanzar un LDL <55 mg/dL y una reducción ≥50% respecto al valor basal.
Para ello se recomienda una estrategia terapéutica escalonada con inicio con estatinas de alta potencia. Si tras ello no se consigue alcanzar el objetivo se añade Ezetimiba. En los últimos años, además, se han desarrollado nuevas medicaciones que nos permiten intensificar el tratamiento si no se consiguen los objetivos mediante esta combinación, o si los pacientes no toleran estatinas (por intolerancia muscular o hepatotoxicidad).
Entre estas medicaciones se encuentran los inhibidores de la proproteína convertasa subtilisina/kexina tipo 9 (iPSCK9), o el Inclisirán (Ácido ribonucleico de interferencia pequeño que reduce la síntesis hepática de PCSK9). Estos dos actualmente en nuestra comunidad autónoma únicamente se pueden pautar si, tras tratamiento óptimo con estatinas de alta potencia/en caso de intolerancia, persisten cifras LDL >100mg/dL.
Como otra alternativa oral tenemos también el Ácido bempedoico, profármaco oral que, una vez activado en el hígado (por la enzima muy específica ACSVL1), inhibe la ATP citrato liasa (ACLY), una enzima clave en la vía biosintética del colesterol, inhibiendo su síntesis en un paso precoz respecto a la HMG-CoA reductasa (diana de las estatinas).
Su activación limitada al hígado minimiza su efecto sobre el músculo esquelético, lo que reduce significativamente el riesgo de miopatías. Esto lo convierte en una opción especialmente relevante en pacientes con intolerancia a estatinas. Por todo ello, el Ácido bempedoico es una alternativa para tener en cuenta en pacientes
PRESENTACIÓN DE UN CASO
Julene Ugarriza Ortueta
con enfermedad cardiovascular establecida o riesgo alto que no alcanzan objetivos de c-LDL con tratamiento convencional (con LDL ≥70 mg/dL) o que presentan intolerancia a estatinas.
1. 2019 ESC/EAS guidelines for the management of dyslipidemias: lipid modification to reduce cardiovascular risk, European Heart Journal (Vol 41, pp. 111-188).
2. Visseren, F., Mach, F., Smulders, Y. M., et al. (2021). 2021 ESC Guidelines on cardiovascular disease prevention in clinical practice. European Heart Journal (Vol. 42, Issue 34, pp. 3227–3337). Oxford University Press.
3. Nissen, S. E., Lincoff, A. M., Brennan, D., et al (2023). Bempedoic Acid and Cardiovascular Outcomes in Statin-Intolerant Patients. New England Journal of Medicine, 388(15), 1353–1364.
4. Vivas, D., Escobar, C., Cordero, A., et al. (2024). Practical use of new therapies for the management of dyslipidaemias. Consensus SEC/ SEA/ SEEN/ SEMFYC/ SEMERGEN/ SEMG/ SEN/ SEACV/ S.E.N. REC: CardioClinics.
II CLINIC CONTEST NAVARRA En Fibrilación Auricular, Tromboembolismo Venoso asociado al Cáncer y Control de Dislipemia con Terapia Oral en el ámbito sanitario de Navarra
CASOS PRESENTADOS

Amaia Yuan Ibargoyen Aira. MIR. Cardiología. Hospital Universitario de Navarra (HUN).


Amaia Yuan Ibargoyen Aira
Paciente que ingresa de forma programada para revascularización quirúrgica de miembro inferior izquierdo por isquemia crónica grado IV y pie diabético.
Antecedentes personales:
- Sin alergias conocidas.
- Sin antecedentes familiares de interés.
- FRCV:
□ Diabetes mellitus tipo 1, diagnosticada en 1989 con complicaciones microvasculares (retinopatía, nefropatía, disfunción eréctil) y macrovasculares (arteriopatía periférica y pie diabético neuroisquémico).
□ Dislipemia: hipercolesterolemia.
□ Hipertensión arterial.
□ Exfumador desde 2020.
□ Consumo esporádico de bebidas alcohólicas.
- Enfermedad renal crónica estadio 3, probablemente por enfermedad renal diabética sin poder descartar una nefropatía vascular.
- Anemia perniciosa.
- Pólipos de colon. Polipectomía endoscópica (2008, 2013).
Tratamiento en domicilio:
Insulina (TRESIBA): 0-0-30UI, Insulina (NOVORAPID) correctora, Empagliflozina 10mg/24h, AAS 100mg/24h, Candesartan 32mg/24h, Atorvastatina 80mg/24h, Ezetimiba 10mg/24h, Tardyferon 80mg/24h, Vitamina B12 1000mcg/mes.
ENFERMEDAD ACTUAL
La intervención quirúrgica inicial cursa sin complicaciones inmediatas. Sin embargo, esa misma tarde, el paciente debuta con un infarto agudo de miocardio con elevación del ST (IAMCEST) anterolateral no complicado (Killip I) con función biventricular conservada. Se realiza una coronariografía emergente y se revasculariza la arteria responsable con buen resultado, quedando otra lesión para revascularización ambulatoria en un segundo tiempo. El procedimiento cursa sin complicaciones.
El paciente permanece hemodinámicamente estable y sin datos de insuficiencia cardiaca. No repite episodios de angina de pecho ni
II CLINIC CONTEST NAVARRA En Fibrilación Auricular, Tromboembolismo Venoso asociado al Cáncer y Control de Dislipemia con Terapia Oral en el ámbito sanitario de Navarra Control de Dislipemia con Terapia Oral
se registran eventos arrítmicos. A destacar, presenta una lesión renal aguda en probable contexto de nefrotoxicidad por contraste administrado durante arteriografía y posteriormente Coronariografía que evoluciona favorablemente con fluidoterapia, al alta Cr 1’7, FG 39 ml/ min.
Durante el ingreso en planta de hospitalización, se optimiza el tratamiento hipolipemiante oral. El paciente había recibido diferentes pautas de tratamiento con aumento progresivo de la dosis de estatina por falta de eficacia previamente. Previo al ingreso actual, se encontraba bajo tratamiento con estatina de alta potencia (atorvastatina 80 mg) y Ezetimiba 10 mg, con un LDL (lipoproteína de baja densidad) 70 mg/dL en la última analítica, por tanto, sin llegar a alcanzar objetivo LDL <55 mg/dL (paciente de muy alto riesgo cardiovascular previo al IAM). Por dicho motivo, se decide asociar Ácido bempedoico 180 mg/24h al tratamiento de base.
Exploración física:
- Peso 64 Kg, Talla 171 cm, IMC 21,9.
- Constantes: TA 116/85 mmHg, FC 90 lpm, SatO2 96% basal. Afebril.
- Buen estado general. Bien perfundido, pulsos distales disminuidos. PVC no elevada AP murmullo vesicular conservado sin ruidos sobreañadidos AC rítmico, sin soplos
Pruebas complementarias:
- ECG: ritmo sinusal a 95 lpm, elevación del ST de 2 mm en V1-V3 con descenso especular y ondas T negativas en cara inferior y de V4 a V6.
- Radiografía de tórax: sin cardiomegalia, senos costofrénicos libres, sin masas ni alteraciones mediastínicas.
- Coronariografía: Enfermedad coronaria de tres vasos, calcificada.
□ Lesión critica en segmento proximal de descendente anterior (DA) (lesión responsable) con oclusión en zona media (aspecto y comportamiento crónico).
□ Lesiones severas en coronaria derecha media y obtusa marginal con enfermedad difusa.
□ Intevencionismo coronario percutáneo (ICP) primario con balón farmacoactivo en DA proximal.
- Ecocardiografía: sin cardiopatía estructural.
Amaia Yuan Ibargoyen Aira
- AS (12/02/2025): colesterol total 142mg/dL, HDL 47mg/dL, LDL 70mg/dL, TAG 125mg/dL. Transaminasas en rango.
- AS (25/03/2025): colesterol total 127mg/dL, HDL 51mg/dL, LDL 46mg/dL, TAG 151mg/Dl. Transaminasas en rango.
EVOLUCIÓN
La evolución desde el punto de vista tanto vascular de la herida quirúrgica como cardiológico, es favorable en el seguimiento.
Tras asociar Ácido bempedóico 180 mg/24h, se repite un análisis sanguíneo a las 6 semanas donde se evidencia una reducción en los niveles de colesterol total y LDL-col hasta 46mg/dL, consiguiendo así, llegar a objetivo. El paciente presenta una buena tolerancia al nuevo fármaco sin registro de efectos secundarios.
El control de los FRCV, tanto en prevención primaria como en secundaria, es una tarea compleja que hay que abordar de forma multidisciplinar. Es necesario recalcar la importancia de la adherencia al tratamiento y el uso homogeneizado de los tratamientos disponibles para así conseguir optimizar el tratamiento hipolipemiante y reducir el riesgo cardiovascular.
Hace años, las opciones terapéuticas para la optimización del tratamiento hipolipemiante en pacientes de muy alto riesgo cardiovascular que no conseguían llegar a niveles objetivo estaba principalmente limitado al uso de estatinas de alta potencia. Posteriormente, se incluyó la Ezetimiba asociada a las previas, pero, recientemente han ido apareciendo otras moléculas como el Ácido bempedoico (inhibidor de la adenosina trifosfato-citrato liasa), anticuerpos inhibidores del PCSK9, Icosapento de etilo (Ácido graso omega 3) o Inclisiran (RNA pequeño de interferencia anti PCSK9), ampliando así el abanico de opciones de este tipo de pacientes.
Independientemente de la vía de administración (oral, subcutánea), el beneficio de estos últimos fármacos está bien demostrado y dispone del respaldo de los resultados obtenidos en la práctica clínica habitual.
II CLINIC CONTEST NAVARRA En Fibrilación Auricular, Tromboembolismo Venoso asociado al Cáncer y Control de Dislipemia con Terapia Oral en el ámbito sanitario de Navarra Control de Dislipemia con Terapia Oral
1. Visseren, F. L., Mach, F., Smulders, Y. M., Carballo, D., Koskinas, K. C., Bäck, M., Benetos, A., Biffi, A., Boavida, J. M., Capodanno, D., Cosyns, B., Crawford, C., Davos, C. H., Desormais, I., Di Angelantonio, E., Franco, O. H., Halvorsen, S., Hobbs, F. R., Hollander, M., . . . Williams, B. (2022). Guía ESC 2021 sobre la prevención de la enfermedad cardiovascular en la práctica clínica. Revista Española de Cardiología, 75(5), 429.e1-429.e104. https://doi. org/10.1016/j.recesp.2021.10.016
2. Nissen, S. E., Lincoff, A. M., Brennan, D., Ray, K. K., Mason, D., Kastelein, J. J., Thompson, P. D., Libby, P., Cho, L., Plutzky, J., Bays, H. E., Moriarty, P. M., Menon, V., Grobbee, D. E., Louie, M. J., Chen, C., Li, N., Bloedon, L., Robinson, P., . . . Nicholls, S. J. (2023). Bempedoic Acid and Cardiovascular Outcomes in Statin-Intolerant Patients. New England Journal Of Medicine, 388 (15), 1353-1364.

II CLINIC CONTEST NAVARRA En Fibrilación Auricular, Tromboembolismo Venoso asociado al Cáncer y Control de Dislipemia con Terapia Oral en el ámbito sanitario de Navarra
CASOS PRESENTADOS
PELUDA:

Inhar Esnaola Barriola. MIR. Neurología. Elisa Martínez Campos. Neurología. Roberto Muñoz Arrondo. Neurología. Hospital Universitario de Navarra (HUN).

II CLINIC CONTEST NAVARRA En Fibrilación Auricular, Tromboembolismo Venoso asociado al Cáncer y Control de Dislipemia con Terapia Oral en el ámbito sanitario de Navarra Control de Dislipemia con Terapia Oral
Hombre de 66 años con antecedentes personales de alergia a corticoides, tabaquismo activo (12 cigarrillos/día), consumo moderado de alcohol (2 cervezas/día) y dislipemia en tratamiento con estatinas a dosis bajas. Sin hipertensión arterial, ni diabetes mellitus diagnosticados previamente. También presentaba isquemia crónica de miembros inferiores y una cervicobraquialgia izquierda con múltiples hernias discales con afectación radicular.
Fue valorado en Urgencias por un cuadro de dificultad para la articulación del lenguaje y asimetría facial desde el despertar. Unos días antes fue valorado en consultas externas por un episodio autolimitado de dificultad para la articulación del lenguaje, catalogado como posible accidente isquémico transitorio e iniciándose antiagregación simple.
A su llegada, el paciente se encontraba hemodinámicamente estable y afebril. Consciente, alerta y orientado temporoespacialmente. Presentaba una disartria moderada-grave, con la comprensión y la nominación conservadas. No se objetivaron alteraciones del campo visual, signos meníngeos ni afectación pupilar. Presentaba una parálisis facial central izquierda. El resto de la exploración de los pares craneales no mostró alteraciones. No se detectó déficit motor, pero sí hipoestesia hemicorporal derecha.
Se completó el estudio mediante tomografía computarizada (TC) craneal y angio-TC, en las que se observaron una hipodensidad en el territorio de la arteria cerebral media derecha en relación con un infarto subagudo y ateromatosis del cayado aórtico con una placa ateromatosa mixta irregular no calcificada, distal al origen de la arteria subclavia izquierda; además de una estenosis moderada de ambas bifurcaciones carotídeas, sin repercusión distal y asociada a placas calcificadas. A nivel de la circulación intracraneal se identificó una oclusión de una rama distal M3. Posteriormente, se realizó un angioTC aórtico para una mejor filiación de la ateromatosis inestable observada, que mostró extensas calcificaciones ateromatosas y placas blandas con trombos irregulares, algunos de ellos con aspecto flotante. En las determinaciones analíticas del ingreso el perfil lipídico fue el siguiente: colesterol LDL 85 mg/dL, colesterol HDL 31 mg/dL, con una ratio colesterol/colesterol HDL de 4.7 y triglicéridos 143 mg/dL.
Debido a la extensión del infarto y la posibilidad de transformación hemorrágica, se inició doble antiagregación plaquetaria, con poste-
Inhar Esnaola Barriola, Elisa Martínez Campos y Roberto Muñoz Arrondo
rior cambio a anticoagulación con acenocumarol. Además, se añadió tratamiento con estatinas de alta intensidad y tratamiento antidiabético, debido al diagnóstico de Diabetes Mellitus de tipo II durante el ingreso.
El paciente presentó una evolución favorable, hasta quedarse prácticamente asintomático. Se realizó seguimiento en consultas externas mediante ecografías seriadas de troncos supraaorticos y de cayado aórtico, observándose la resolución progresiva de los trombos móviles asociados a la ateromatosis del cayado aórtico. Posteriormente se suspendió la anticoagulación y se reinició tratamiento con antiagregación simple, manteniendo la terapia hipolipemiante con estatinas de alta intensidad y ezetimiba, con cifras de colesterol en rango terapéutico en los controles analíticos (LDL 38 mg/dL, HDL 31 mg/dL, ratio colesterol/colesterol HDL 2.8, y triglicéridos 84 mg/dL) y estabilidad de la ateromatosis en las pruebas de imagen.
El ictus isquémico puede estar causado por múltiples mecanismos diferentes, por lo que conocer la causa subyacente es de gran importancia para aplicar el tratamiento más adecuado en prevención secundaria (1). Una sexta parte de todos los ictus es clasificada como ictus embólico de origen indeterminado (ESUS, por sus siglas en inglés), definidos como aquellos en los que, tras una evaluación diagnóstica exhaustiva, no se identifica una causa específica entre las más frecuentes (2). En este contexto, la ateromatosis del arco aórtico (AAA) ha emergido como un factor causal relevante en la etiología del ictus de origen indeterminado, y no únicamente como un marcador de carga aterosclerótica sistémica (3). En algunas series, se ha detectado ateromatosis en el arco aórtico hasta en un 29% de los ictus de origen indeterminado (4). Sin embargo, esta cifra podría incluso subestimar su implicación real, ya que no contempla los casos clasificados como de origen aterosclerótico carotídeo o intracraneal, a pesar de la frecuente coexistencia de ateromatosis en los distintos territorios. La prevalencia y gravedad de la AAA aumentan con la edad y la presencia de factores de riesgo cardiovascular clásicos como tabaquismo, hipercolesterolemia, hipertensión arterial, diabetes mellitus, sexo masculino, hiperhomocisteinemia e hiperfibrinogenemia (5).
La formación de la AAA, es un proceso lento y dinámico, con diferentes grados de severidad, que no siempre presenta un curso
II CLINIC CONTEST NAVARRA En Fibrilación Auricular, Tromboembolismo Venoso asociado al Cáncer y Control de Dislipemia con Terapia Oral en el ámbito sanitario de Navarra Control de Dislipemia con Terapia Oral
inexorablemente progresivo, ya que puede progresar, mantenerse estable o bajo las circunstancias adecuadas, incluso experimentar regresión. Las placas de mayor grosor (≥4 mm), hipoecogénicas (indicativas de alto contenido lipídico), con componentes móviles o ulceraciones, se asocian a un mayor riesgo embólico (3).
En el extremo más severo del espectro ateromatoso se encuentra la denominada “aorta peluda” o “shaggy aorta”, caracterizada por la presencia de múltiples trombos de pequeño tamaño adheridos a placas inestables, en un contexto de degeneración grave y superficie aórtica friable, lo que constituye una potencial fuente de embolismos sistémicos (6) y que confiere un pronóstico desfavorable debido al difícil manejo y la frecuente comorbilidad (7).
El diagnóstico de AAA se fundamenta en la angio-TC, aunque la naturaleza dinámica de estas lesiones hace que la ecocardiografía transesofágica y, en ocasiones, la ecocardiografía transtorácica supraesternal, sean herramientas útiles tanto para el diagnóstico como para el seguimiento evolutivo (7).
Respecto al manejo terapéutico, la presencia de componentes móviles suele corresponderse a trombos lo que justificaría el uso de anticoagulación, aunque la evidencia proviene fundamentalmente de estudios observacionales con importantes limitaciones metodológicas (5). Por tanto, estos resultados deben interpretarse con cautela.
Por otra parte, el tratamiento hipolipemiante con estatinas ha demostrado un efecto protector independiente en la AAA, tanto en la reducción de eventos embólicos como en la reducción del grosor de las placas, asociado tanto al descenso de LDL como a la intensidad del tratamiento (8). Así, se recomienda el uso de estatinas en todos los pacientes con ictus y AAA, independientemente de los niveles plasmáticos de colesterol, dada la relevancia de los efectos pleiotrópicos de estas moléculas en la regresión, estabilización y desinflamación de la placa ateromatosa (5). En este contexto, también nuevas terapias hipolipemiantes, como el Ácido bempedoico, podrían aportar beneficios adicionales intensificando la reducción de marcadores lipídicos aterogénicos y aportando un efecto antinflamatorio (9).
Por último, la modificación intensiva del estilo de vida constituye un pilar fundamental como parte del tratamiento médico. El ejercicio físico ha demostrado tener un impacto significativo en las placas de ateroma, mediante la mejora de la función endotelial, reducción de la inflamación y la modulación de la respuesta inmune. Estudios
EXTREMA DE LA ATEROMATOSIS DEL ARCO AÓRTICO
Inhar Esnaola Barriola, Elisa Martínez Campos y Roberto Muñoz Arrondo
recientes han demostrado que esquemas como el ejercicio de alta intensidad por intervalos (HIIT por sus siglas en inglés), puede inducir la regresión de placas ateromatosas coronarias (10), por lo que parece lógico pensar que también podría aportar un beneficio similar a la ateromatosis en el arco aórtico o en otras localizaciones.
Por todo ello, se aboga por un abordaje multidisciplinar que integre la colaboración de especialistas hospitalarios, Atención Primaria y profesionales en nutrición y ejercicio físico, con el objetivo de optimizar el pronóstico y la calidad de vida de estos pacientes.
1. Kamel, H. The Evolving Concept of Cryptogenic Stroke. (2020).
2. Hart, R. G., Catanese, L., Perera, K. S., Ntaios, G. & Connolly, S. J. Embolic Stroke of Undetermined Source: A Systematic Review and Clinical Update. Stroke 48, 867–872 (2017).
3. Zavala, J. A. et al. Aortic Arch Atheroma. International Journal of Stroke 1, 74–80 (2006).
4. Ntaios, G. et al. Aortic Arch Atherosclerosis in Patients With Embolic Stroke of Undetermined Source: An Exploratory Analysis of the NAVIGATE ESUS Trial. Stroke 50, 3184–3190 (2019).
5. Capmany, R. P., Oliveras Ibañez, M. & Pesquer, X. J. Complex Atheromatosis of the Aortic Arch in Cerebral Infarction. Current Cardiology Reviews vol. 6 (2010).
6. Hollier, L. H., Kazmier, F. J., Ochsner, J., Bowen, J. C. & Daniel Procter, C. ‘Shaggy’ Aorta Syndrome with Atheromatous Embolization to Visceral Vessels. Ann Vasc Surg vol. 5 (1991).
7. Esnaola Barriola, I. et al. Suprasternal aortic arch echocardioscopy as a potential tool in detection and follow-up of mobile thrombi in patients with ischemic stroke. Front Neurol 15, (2025).
8. Corti, R. et al. Effects of Aggressive Versus Conventional Lipid-Lowering Therapy by Simvastatin on Human Atherosclerotic Lesions. J Am Coll Cardiol 46, 106–112 (2005).
9. Masson, W., Lobo, M., Lavalle-Cobo, A. & Molinero, G. Effect of Bempedoic Acid on atherogenic lipids and inflammation: A meta-analysis. Clínica e Investigación en Arteriosclerosis 33, 117–126 (2021).
10. Vesterbekkmo, E. K. et al. High-intensity interval training induces beneficial effects on coronary atheromatous plaques: a randomized trial. Eur J Prev Cardiol 30, 384–392 (2023).
II CLINIC CONTEST NAVARRA En Fibrilación Auricular, Tromboembolismo Venoso asociado al Cáncer y Control de Dislipemia con Terapia Oral en el ámbito sanitario de Navarra
CASOS PRESENTADOS

Jon Yoldi Urdíroz.
MIR. Endocrinología y Nutrición. Sofía Baniandrés Eizaguirre.
MIR. Endocrinología y Nutrición. Hospital Universitario de Navarra (HUN). Ander Ernaga Lorea.
Endocrinología y Nutrición
Hospital García Orcoyen. Estella.


Mujer de 53 años de edad, remitida a consultas de Endocrinología para valoración de hipercolesterolemia.
Como antecedentes personales destaca HTA, esteatosis hepática y seguimiento activo en hematología por diagnóstico de pseudotrombopenia por plaquetas de tamaño grande desde al menos 2001, sin eventos hemorrágicos asociados. Es fumadora de un cuarto de paquete diario desde hace 38 años. No ha presentado antecedentes personales de eventos cardiovasculares.
En cuanto a antecedentes familiares, ambos progenitores presentan diagnóstico de hipercolesterolemia en la edad adulta y, su padre, además, sufrió un evento anginoso a la edad de 53 años. Tiene una única hermana con diagnóstico hipercolesterolemia desde los 6 años con valores de >400 mg/dl. A su vez, presenta dos hijos sin hipercolesterolemia conocida.
La paciente presenta hipercolesterolemia desde el año 2001, con niveles de LDL oscilantes entre 160-220 mg/dl. Desde entonces, en seguimiento por su médico de Atención Primaria, quien inició tratamiento con estatina desde prácticamente el diagnóstico. En un primer lugar, inició Simvastatina 20 mg, posteriormente Atorvastatina 40 mg y finalmente Rosuvastatina con aumento progresivo de dosis hasta 20 mg, sin lograr efecto en disminución de niveles de colesterol sanguíneo con ninguno de los fármacos, a pesar de buena adherencia al tratamiento. Por ello, se decide derivación a Endocrinología.
En la valoración inicial en consultas de Endocrinología se aprecia a la exploración física un leve arco corneal sin xantomas ni xantelasmas. Además, a destacar, presenta obesidad grado II con perímetro de cintura de 119 cm.
La paciente alcanzó una puntuación de 6 puntos en los criterios
MEDPED para el cribado de hipercolesterolemia familiar, por lo que se realiza estudio genético -que es negativo- para diagnóstico de hipercolesterolemia familiar heterocigótica.
No obstante, dando el control insuficiente de los niveles de colesterol, se decide asociar Ezetimibe al tratamiento (Tabla 1).
Acude a revisión con mejoría espectacular de los niveles de LDL colesterol, tras inicio del tratamiento con Ezetimibe. En los análisis de
II CLINIC CONTEST NAVARRA En Fibrilación Auricular, Tromboembolismo Venoso asociado al Cáncer y Control de Dislipemia con Terapia Oral en el ámbito sanitario de Navarra Control de Dislipemia con Terapia Oral
control, se visualiza un descenso de Colesterol total a 161 mg/dl, LDL 76 mg/dl y no HDL 94 mg/dl.
Se ofrece a la paciente la inclusión en un proyecto de investigación que analiza el genoma completo con el fin de identificar alteraciones genéticas causantes de hipercolesterolemia severa, que la paciente acepta.
Los análisis genómicos detectan mutaciones en las variantes c.1083G>A y c.1974C>G en el gen ABCG8. Estas variantes se clasifican como variantes patogénicas o posiblemente patogénicas compatible con diagnóstico de sitosterolemia.
A su vez, con el fin de cuantificar la presencia de aterosclerosis, se completa estudio con TAC coronario que presenta un Score de calcio total 166 UA (p94%).
En tanto que se trata de una paciente de alto riesgo cardiovascular con LDL fuera de objetivo, aunque con no HDL en objetivo, se considera añadir Ácido bempedoico al tratamiento que finalmente se desestima por la ineficacia de los fármacos que actúan a nivel de la vía HMG-CoA reductasa en esta patología. Finalmente, se entregan recomendaciones nutricionales sobre dieta baja en esteroles vegetales, se insiste en la necesidad de abstención tabáquica y se decide seguimiento en consulta sin modificación del tratamiento (Figura1).
La sitosterolemia es una causa rara de hipercolesterolemia caracterizada por niveles de elevados de esteroles vegetales (1). Presenta una herencia autosómica recesiva y es causada por mutaciones en los genes ABCG5 y ABCG8, encargados de limitar la absorción intestinal y promover la excreción biliar de esteroles en los hepatocitos y enterocitos. Personas sin afectación a nivel de estos genes absorben únicamente un 5% de los esteroles vegetales consumidos cada día y además son rápidamente excretados al conducto biliar (2).
Los individuos con sitosterolemia presentan un fenotipo heterogéneo, en el que la característica principal es la presencia de xantomas y arteriosclerosis prematura. Sin embargo, la presencia de esplenomegalia, anemia hemolítica, trombocitopenia de plaquetas grandes, la falta de respuesta a estatinas o los valores elevados de esteroles vegetales en sangre pueden ser la primera manifestación de la enfermedad (3).
En nuestro caso cabe destacar el diagnóstico temprano de trombocitopenia de plaquetas gigantes junto con hipercolesterolemia con
falta de respuesta a estatinas como primeras manifestaciones clínicas. A su vez, aunque la paciente no había experimentado evento cardiovascular ni presentaba manifestaciones cutáneas como xantomas o xantelasmas, la detección de un p94 de score de calcio coronario TAC sugiere presencia de aterosclerosis subclínica.
El diagnóstico diferencial entre la sitosterolemia y la hipercolesterolemia familiar es complicado puesto que presentan un fenotipo similar y las mediciones plasmáticas de rutina no diferencian esteroles vegetales de colesterol. Para lograrlo es necesario apoyarse en una técnica de espectrometría de masas (4). A destacar que a nuestro caso se le solicitó estudio genético convencional de los genes LDLR, APOB y PCSK-9, dado que cumplía 6 puntos en los criterios MEDPED, que fue negativo.
El abordaje nutricional de la sitosterolemia se basa en la restricción de colesterol vegetal. En cuanto a la farmacoterapia, Ezetimibe por su modo de acción como inhibidor de la absorción del colesterol se posiciona como terapia principal, alcanzando una reducción de entorno al 50% del colesterol plasmático (5). Otra opción terapéutica son los quelantes biliares como la colestiramina, aunque su mala tolerancia gastrointestinal ha relegado su uso. Estos pacientes, además, no suelen responder a estatinas ni alternativas como Ácido bempedoico porque la actividad de la HMG-CoA reductasa está inhibida al máximo (6).
La incorporación en los últimos años de nuevos paneles de secuenciación y el estudio de genoma completo evidencian que la prevalencia de la sitosterolemia es mayor de la descrita en la literatura (7). En definitiva, debemos estar alerta ante casos de hipercolesterolemia moderada-severa que no respondan a tratamiento con estatinas, que sugieran sitosterolemia como causa etiológica, con el fin de prevenir la aparición de eventos cardiovasculares.
II CLINIC CONTEST NAVARRA En Fibrilación Auricular, Tromboembolismo Venoso asociado al Cáncer y Control de Dislipemia con Terapia Oral en el ámbito sanitario de Navarra Control de Dislipemia con Terapia Oral
1. Bhattacharyya AK, Connor WE. Beta-sitosterolemia and xanthomatosis. A newly described lipid storage disease in two sisters. J Clin Invest. 1974 Apr; 53(4):1033–43.
2. Salen G, Starc T, Sisk CM, Patel SB. Intestinal cholesterol absorption inhibitor ezetimibe added to cholestyramine for sitosterolemia and xanthomatosis. Gastroenterology. 2006 May;130(6):1853–7.
3. Rees DC, Iolascon A, Carella M, O’Marcaigh AS, Kendra JR, Jowitt SN, et al. Stomatocytic haemolysis and macrothrombocytopenia (Mediterranean stomatocytosis/macrothrombocytopenia) is the haematological presentation of phytosterolaemia. Br J Haematol. 2005 Jul;130(2):297–309.
4. Renner C, Connor WE, Steiner RD. Sitosterolemia Presenting as Pseudohomozygous Familial Hypercholesterolemia. Clin Med Res. 2016 Jun 1;14(2):103–8.
5. Tsubakio-Yamamoto K, Nishida M, Nakagawa-Toyama Y, Masuda D, Ohama T, Yamashita S. Current therapy for patients with sitosterolemia: effect of ezetimibe on plant sterol metabolism. J Atheroscler Thromb 010; 17:891-900.
6. Expert Panel on Integrated Guidelines for Cardiovascular Health and Risk Reduction in Children and Adolescents; National Heart, Lung, and Blood Institute. Expert panel on integrated guidelines for cardiovascular health and risk reduction in children and adolescents: summary report. Pediatrics 2011;128 Suppl 5: S213-56.
7. Tada MT, Rocha VZ, Lima IR, Oliveira TGM, Chacra AP, Miname MH, et al. Screening of ABCG5 and ABCG8 Genes for Sitosterolemia in a Familial Hypercholesterolemia Cascade Screening Program. Circ Genomic Precis Med. 2022 Jun 1;15(3): E003390.
1: Evolución de niveles de Colesterol total y LDL previos al inicio de Ezetimibe.
1: Niveles séricos de Colesterol total y LDL previos y tras el inicio de Ezetimibe (marcado con la línea vertical).
II CLINIC CONTEST NAVARRA En Fibrilación Auricular, Tromboembolismo Venoso asociado al Cáncer y Control de Dislipemia con Terapia Oral en el ámbito sanitario de Navarra
CASOS PRESENTADOS

DIAGNÓSTICO Y
TERAPÉUTICO
Elena Escriche Gorospe. MIR. Neurología. María Molina Goicoechea.
Neurología. Beatriz Zandio Amorena.
Neurología. Hospital Universitario de Navarra (HUN).


Elena Escriche Gorospe, María Molina Goicoechea y Beatriz Zandio Amorena
Paciente de 72 años, diagnosticado previamente de:
- Hipertensión arterial, dislipemia (última analítica en enero/2025: colesterol total 206 mg/dL, LDL 123 mg/dL), Diabetes Mellitus tipo 2, Enfermedad Pulmonar Obstructiva Crónica. Exfumador desde hace unos 15 años. Exbebedor.
- Ictus isquémico hemisférico derecho de etiología indeterminada (2017).
- Gammapatía monoclonal de origen indeterminado.
Tratamiento: Metformina 850 mg/24h, Acido Acetilsalicilico 100 mg/24h, Atorvastatina 80 mg, Telmisartan 40 mg/24h, Bromuro de ipratropio 20 mg si precisa.
Ingresa el 3/3/2025 por shock séptico secundario a gangrena de Fournier. Se realiza cirugía urgente con desbridamiento de absceso perianal. Presenta buena evolución. El 22/03/2025 se activa Código Ictus por debilidad de extremidades izquierdas y desviación cefálica.
Exploración física: Mal estado general. Consciente. Ojos cerrados que abre a la llamada. Disartria moderada-severa. Desviación oculocefálica derecha forzada que no vence línea media. Parálisis facial central izquierda. Hemiplejia izquierda con anestesia. Escala NIHSS 16 puntos.
Pruebas complementarias
- TC basal: Placa calcificada en el segmento M1 de Arteria Cerebral Media (ACM) derecha, no presente en el TC previo (Imagen 1). Tenue hipodensidad corticosubcortical en ínsula y territorio M4-M5 derecho sugestivo de lesión isquémica aguda. ASPECTS: 8.
- Angio-TC de troncos supra-aórticos: Ateromatosis calcificada del cayado aórtico. Placas calcificadas en ambas bifurcaciones, sin condicionar áreas de estenosis significativa. Placa calcificada en el segmento M1 de ACM derecha, no presente en

II CLINIC CONTEST NAVARRA En Fibrilación Auricular, Tromboembolismo Venoso asociado al Cáncer y
Control de Dislipemia con Terapia Oral en el ámbito sanitario de Navarra
Control de Dislipemia con Terapia Oral
el TC previo, que permite el paso del contraste hacia el segmento M2. Resto de arterias permeables. Al comparar las imágenes con un estudio previo realizado días antes, se observa una placa de ateroma con contornos irregulares en el cayado aórtico. En el estudio actual, dicha placa presenta una discontinuidad sugestiva de pérdida o desprendimiento de un fragmento con respecto al estudio anterior.
- TC-Perfusión: Hipoperfusión del territorio de la ACM derecha con evidencia de isquemia del hemisferio cerebral derecho con área de penumbra significativa.
EVOLUCIÓN
Se decide tratamiento endovascular (trombectomía mecánica) para tratar de extraer el trombo calcificado presente en ACM M1 derecha. Se explica a la familia la probabilidad escasa de éxito teniendo en cuenta la probable composición cálcica del trombo.
En la arteriografía se observa oclusión de segmento M1 distal de ACM derecha con un mínimo paso de contraste en fase tardía. Tras 5 pases de técnica combinada o aspiración no se logra la recanalización completa del territorio de la M1. El TAC de control tras el procedimiento mostró una extensa área de infarto establecido afectando al lóbulo frontal, parietal y temporal posterior derechos, además de edema citotóxico con efecto de masa colapsando el asta frontal del ventrículo lateral derecho.
Al día siguiente presenta una insuficiencia respiratoria y bajo nivel de consciencia (Glasgow 9 puntos). Teniendo en cuenta el mal pronóstico funcional y vital, se decide manejo conservador de su patología no procediendo a realizar medidas invasivas. Se realiza sedación terminal de confort y finalmente el paciente fallece el 25/03.
El término “aterosclerosis” deriva del griego: athero significa pasta, y sclerosis, endurecimiento. Las placas de ateroma se forman mediante un proceso complejo que involucra depósito de lípidos, cambios inflamatorios, migración celular y lesión endotelial. Su inestabilidad puede conducir a rotura, trombosis intraluminal y embolización, desencadenando eventos cerebrovasculares como el ictus o el infarto agudo de miocardio (1).
La inflamación sistémica crónica de bajo grado constituye un me-
ISQUÉMICO POR EMBOLISMO CÁLCICO: UN DESAFÍO DIAGNÓSTICO Y TERAPÉUTICO
Elena Escriche Gorospe, María Molina Goicoechea y Beatriz Zandio Amorena
canismo patogénico central en el desarrollo de aterosclerosis y adicionalmente los estados de inflamación sistémica aguda severa, como la sepsis o la tormenta de citoquinas en COVID-19, se han vinculado a un mayor riesgo de eventos cerebrovasculares, posiblemente por inducir un proceso de aterogénesis acelerada (1). Esto resulta especialmente interesante en el paciente presentado ya que tenía una placa con criterio de estabilidad visible en un AngioTC previo, que probablemente en contexto de la sepsis se inestabilizó y provocó un embolismo cálcico causando el ictus isquémico.
Por todo ello, el control de los factores de riesgo cardiovascular para evitar el desarrollo de las placas de ateroma, así como el tratamiento médico intensivo para la estabilización y la regresión de las placas, son estrategias esenciales para la prevención de eventos vasculares.
La reducción de los niveles de lipoproteínas aterogénicas, sobre todo LDL colesterol sérico, permite reducir globalmente la cantidad de placa aterosclerótica y modificar su composición, estabilizando la placa y disminuyendo la posibilidad de provocar embolias. Clásicamente, este objetivo se ha conseguido con la terapia intensiva con estatinas, como en el caso del paciente presentado, y en los últimos años las nuevas terapias más potentes para la reducción de lípidos también han demostrado efectos en la reducción de eventos cardiovasculares (2).
Las placas vulnerables conllevan un aumento de riesgo de ictus por embolismo arteria-arteria, como consecuencia de la formación de trombos adheridos a su pared, habitualmente ricos en fibrina y plaquetas (3). Con menor frecuencia, estos émbolos pueden tener una composición cálcica, como en el caso del paciente presentado. Las embolias cerebrales cálcicas son una causa de ictus poco frecuente (4) y pueden tener diferente origen: calcificación de la válvula aórtica, del anillo de la válvula mitral y las placas de ateroma calcificadas carotídeas o del cayado aórtico, como en el caso clínico descrito. También pueden ser de origen iatrogénico, asociados a diferentes procedimientos quirúrgicos o intravasculares (cirugía cardíaca, angiografía coronaria y cerebral, angioplastia carotídea) (3).
Este tipo de trombos tienen una serie de particularidades en el manejo en la fase aguda del ictus isquémico: A nivel diagnóstico, es posible identificarlas con mayor facilidad mediante un TC sin contraste (como se objetiva en la imagen adjunta), a diferencia del resto de trombos (4). A nivel terapéutico, su dureza y rigidez limita la efecti-
II CLINIC CONTEST NAVARRA En Fibrilación Auricular, Tromboembolismo Venoso asociado al Cáncer y Control de Dislipemia con Terapia Oral en el ámbito sanitario de Navarra Control de Dislipemia con Terapia Oral
vidad de los tratamientos disponibles en fase aguda para el ictus isquémico: la fibrinolisis intravenosa y la trombectomía mecánica, y además se incrementa el riesgo de daño vascular o rotura mecánica de la pared, lo que empeora el pronóstico funcional y vital de estos pacientes (5). Es por ello importante revisar la indicación y eficacia de estos tratamientos en este subtipo de embolias cerebrales.
En la serie europea de Maurer et al (6) se obtuvo un 57.5% de éxito de recanalización en pacientes con ictus isquémico secundaria a embolia cálcico tratados con trombectomía.
AJ Mosqueira et al (4), presentan una serie 9 pacientes con embolismos cálcicos espontáneos. En el 33% de los pacientes se encontró la causa del embolismo en la arteria carótida y en otro 33% en el corazón. Uno de los pacientes fue tratado con trombectomía mecánica, que resultó ineficaz, y solo 1 de los pacientes presentó buen pronóstico funcional al alta. Otros autores, en cambio (7), presentan un caso de ictus isquémico por embolismo cálcico tratado exitosamente mediante trombectomía mecánica, con buen pronóstico funcional al alta.
En conclusión, la trombectomía mecánica en la embolia cerebral cálcica supone un desafío técnico considerable, con eficacia limitada y un mayor riesgo de complicaciones en comparación con otros tipos de embolismos. No obstante, una oclusión arterial por un embolismo cálcico no supone una contraindicación del tratamiento fibrinolítico (3) ni endovascular (6), siendo fundamental una evaluación individualizada según el perfil clínico y radiológico del paciente.
La aterosclerosis es una patología multifactorial que conlleva un riesgo aumentado de ictus agudo, particularmente en contextos de inflamación sistémica. Un subtipo infrecuente son los embolismos cálcicos, cuya presentación diagnóstica y abordaje terapéutico resultan especialmente desafiantes. En este contexto, la prevención primaria es esencial y el tratamiento hipolipemiante ha demostrado eficacia tanto en la reducción como en la estabilización de las placas ateroscleróticas.
UN DESAFÍO DIAGNÓSTICO Y TERAPÉUTICO
Elena Escriche Gorospe, María Molina Goicoechea y Beatriz Zandio Amorena
1. Gusev E, Sarapultsev A. Atherosclerosis and Inflammation: Insights from the Theory of General Pathological Processes. Int J Mol Sci. 2023 Apr 26;24(9):7910.
2. Sarraju A, Nissen SE. Atherosclerotic plaque stabilization and regression: a review of clinical evidence. Nat Rev Cardiol. 2024 Jul;21(7):487-497.
3. Mayor S, Muñoz R, Olier J, Gállego J. Infarto cerebral por embolismo cálcico y tratamiento trombolítico ineficaz. Neurología. Vol. 29. Núm. 2. Páginas 123-125 (marzo 2014).
4. 4. A J Mosqueira 1 , B Canneti 2 , A Martínez Calvo 3 , P Fernández Armendáriz 3 , M Seijo-Martinez 2 , J M Pumar 4. Calcified cerebral embolism: a 9 case series and review of the literature.
5. Pérez P, Moyano A, Díaz L, Martínez C. Embolismo cerebral calcificado, una causa infrecuente de accidente cerebrovascular. Hospital universitario Clínico San Cecilio, Granada. 35 Congreso Nacional SERAM: Sociedad Española Radiología Médica.
6. C.J. Maurer, T. Dobrocky, F. Joachimski, U. Neuberger, T. Demerath, A. Brehm, A. Cianfoni, B. Gory, A. Berlis, J. Gralla, M.A. Möhlenbruch, K.A. Blackham, M.N. Psychogios, P. Zickler and S. Fischer. Endovascular Thrombectomy of Calcified Emboli in Acute Ischemic Stroke: A Multicenter Study. American Journal of Neuroradiology March 2020, 41 (3) 464-468.
7. Ramírez-Moreno JM, Trinidad-Ruiz M, Ceberino D, Fernández de Alarcón L. Trombectomía mecánica en un ictus isquémico debido a embolia cerebral.
II CLINIC CONTEST NAVARRA En Fibrilación Auricular, Tromboembolismo Venoso asociado al Cáncer y Control de Dislipemia con Terapia Oral en el ámbito sanitario de Navarra
CASOS PRESENTADOS

Alba Domínguez Castillo.
MIR Cardiología. CUN.
Rocío Álvarez Abril.
MIR Cardiología. CUN.
Clínica Universidad de Navarra (CUN)


Prevención del riesgo cardiovascular.
Alba Domínguez Castillo y Rocío Álvarez Abril
Mujer de 39 años con dislipemia familiar, sin otros factores de riesgo cardiovascular conocidos.
Historia cardiovascular:
En marzo de 2023 acudió a consulta por dolor torácico inespecífico. Se realizó ecocardiograma, sin cardiopatía estructural, y ergometría eléctricamente negativa y positiva clínicamente. Por ello, se realizó TC coronaria, sin lesiones coronarias, donde se apreció leve derrame pericárdico. Posteriormente, se le realizó una nueva valoración, con dolor pericarditis, y recibió tratamiento con colchicina e indometacina, con adecuada evolución clínica. Revisiones posteriores satisfactorias.
ENFERMEDAD ACTUAL
Acude a consulta para valoración de factores de riesgo cardiovascular por dislipemia familiar, aporta analítica en la que destaca perfil lipídico:
- Colesterol total 492 mg/dL, HHDL 78 mg/dL, Triglicéridos 71 mg/ dL y LDL 400 mg/dL.
La paciente comenta el reciente inicio de tratamiento para fertilidad.
Exploración física:
TA: 105/59 mmHg. FC: 86 lpm. Peso: 63 kg. Talla: 155 cm. IMC: 26,2 kg/m2.
Buen estado general. Buen color de piel y mucosas. Cuello: no ingurgitación yugular. Latido carotideo rítmico y simétrico. No soplos. Auscultación cardíaca: tonos cardiacos rítmicos, sin soplos. Auscultación pulmonar: Murmullo vesicular fisiológico. Extremidades: No edema. Pulsos conservados.
Exploraciones complementarias:
- Electrocardiograma: Ritmo sinusal a 70 lpm. Eje horizontal. PR normal. QRS estrecho. Sin alteraciones en la repolarización.
- Ecocardiograma-doppler: Ventrículo izquierdo de dimensiones normales. Sin alteraciones de la contractilidad segmentaria. FEVI
II CLINIC CONTEST NAVARRA En Fibrilación Auricular, Tromboembolismo Venoso asociado al Cáncer y Control de Dislipemia con Terapia Oral en el ámbito sanitario de Navarra Control de Dislipemia con Terapia Oral
normal. Función diastólica normal. Ventrículo derecho normal en dimensión y función. Aurículas de tamaño normal. Sin valvulopatías significativas. Raíz aórtica de tamaño normal. Vena cava inferior no dilatada y que colapsa adecuadamente. Sin derrame pericárdico.
EVOLUCIÓN
Debido a que la paciente se encuentra en tratamiento de fertilidad se inicia en prevención primaria tratamiento con Ácido bempedoico/ Ezetimibe. Posteriormente, se realizan revisiones para valorar evolución de perfil lipídico.
- Analítica a los 3 meses de seguimiento: Colesterol total 192 mg/ dL, LDL 94 mg/dL, HDL 83 mg/dL y triglicéridos 72 mg/dL. Lipoproteína a 67,20 mg/dL. Apolipoproteína B 76 mg/dL.
- Analítica a los 6 meses de seguimiento: Colesterol total 190 mg/ dL, LDL 69 mg/dL, HDL 102 mg/dL y triglicéridos 81 mg/dL. Lipoproteína a 57 mg/dL
Durante el año de seguimiento, la paciente no quedó embarazada por lo que se continuó tratamiento hipolipemiante con Ácido bempedoico/Ezetimibe mientras está en tratamiento de fertilidad.
Presentamos una paciente joven con dislipemia severa con LDL de 400 mg/dL, en un contexto clínico y analítico compatible con hipercolesterolemia familiar heterocigota. La paciente presenta un riesgo cardiovascular alto, según las guías de prevención cardiovascular ESC de 2021, considerando un LDL objetivo menor de 70 mg/dL (1).
Por ello, aunque la paciente está asintomática, requiere intervención temprana para prevenir el desarrollo de enfermedad cardiovascular prematura.
En prevención primaria, el tratamiento inicial para control de dislipemia, es el uso de estatinas (1). Debido a que el uso de estatinas está contraindicado tanto en tratamiento de fertilidad, embarazo y lactancia se valora uso de tratamiento hipolipemiante oral alternativo mientras la paciente esté en tratamiento de fertilidad. Una de estas alternativas son el Ácido bempedoico, Ezetimibe y Colesevelam (resina de intercambio aniónico) (2). A pesar de su seguridad durante el tratamiento de fertilidad, una vez sea conocido el embarazo, tanto el
Alba Domínguez Castillo y Rocío Álvarez Abril
Ácido bempedoico como Ezetimibe deben discontinuarse ante la falta de evidencia sólida de seguridad durante el embarazo (2). Debido a que la paciente va a presentar seguimiento estrecho del tratamiento de fertilidad, conociendo precozmente cuando esté embarazada, se decide utilizar estos tratamientos alternativos.
Es importante caracterizar el riesgo cardiovascular de las pacientes en edad fértil ya que aquellas que precisen de tratamiento hipolipemiante, requieren un seguimiento estrecho para individualizar y adaptar el tratamiento según su planificación familiar. Tanto el retraso en el diagnóstico como la interrupción del tratamiento durante los años reproductivos, puede llevar a un incremento de riesgo de eventos cardiovasculares debido al control subóptimo del perfil lipídico (3).
Por ello, es de importancia la colaboración interdepartamental -desde prevención primaria hasta el especialista- para identificar este tipo de pacientes y realizar un seguimiento estrecho con el fin de minimizar el tiempo de discontinuación de tratamiento o valorar terapias alternativas y realizar un seguimiento más estrecho del perfil lipídico durante los meses de gestación para asegurar un adecuado control analítico (4).
Tampoco podemos olvidar los cambios en el perfil lipídico de la mujer en la transición menopáusica, siendo relevante el seguimiento de estas mujeres en esta etapa para ajustar tratamiento hipolipemiante para alcanzar los objetivos en prevención primaria y evitar el desarrollo de enfermedad cardiovascular.
II CLINIC CONTEST NAVARRA En Fibrilación Auricular, Tromboembolismo Venoso asociado al Cáncer y Control de Dislipemia con Terapia Oral en el ámbito sanitario de Navarra Control de Dislipemia con Terapia Oral
1. Visseren FLJ, Mach F, Smulders YM, Carballo D, Koskinas KC, Bäck M, et al. 2021 ESC Guidelines on cardiovascular disease prevention in clinical practice. Eur Heart J. 2021 Sep 7;42(34):3227-3337. doi: 10.1093/eurheartj/ ehab484.
2. Lloyd-Jones DM, Morris PB, Ballantyne CM, et al. 2022 ACC Expert Consensus Decision Pathway on the Role of Nonstatin Therapies for LDL-Cholesterol Lowering in the Management of Atherosclerotic Cardiovascular Disease Risk: A Report of the American College of Cardiology Solution Set Oversight Committee. J Am Coll Cardiol. 2022;80(14):1366-1418. doi:10.1016/j.jacc.2022.07.006.
3. Ruiz Cantero MT, et al. Perspectiva de género en medicina. Infradiagnóstico de la hipercolesterolemia familiar en mujeres jóvenes. Instituto de Salud Carlos III; 2020. p. 201-202.
4. Balla S, Ekpo EP, Wilemon KA, Knowles JW, Rodriguez F. Women Living With Familial Hypercholesterolemia: Challenges and Considerations Surrounding Their Care. Curr Atheroscler Rep. 2020;22(10):60. doi:10.1007/ s11883-020-00881-5.
5. El Khoudary SR, Aggarwal B, Beckie TM, et al. Menopause Transition and Cardiovascular Disease Risk: Implications for Timing of Early Prevention: A Scientific Statement From the American Heart Association. Circulation. 2020;142(25):e506-e532. doi:10.1161/CIR.0000000000000912.

II CLINIC CONTEST NAVARRA En Fibrilación Auricular, Tromboembolismo Venoso asociado al Cáncer y Control de Dislipemia con Terapia Oral en el ámbito sanitario de Navarra
CASOS PRESENTADOS

ANEURISMA
Rocío Álvarez Abril.
MIR Cardiología. CUN.
Alba Domínguez Castillo.
MIR Cardiología. CUN
Clínica Universidad de Navarra (CUN).

II CLINIC CONTEST NAVARRA En Fibrilación Auricular, Tromboembolismo Venoso asociado al Cáncer y Control de Dislipemia con Terapia Oral en el ámbito sanitario de Navarra Control de Dislipemia con Terapia Oral
Control de factores de riesgo cardiovascular.
Mujer de 39 años con dislipemia familiar, sin otros factores de riesgo cardiovascular conocidos.
Valorado en nuestra consulta, asintomático desde el punto de vista cardiovascular, para valoración de factores de riesgo cardiovascular por diagnóstico de dislipemia familiar. Paciente en tratamiento con Atorvastatina y Ezetimibe.
Exploración física:
TA: 105/59 mmHg. FC: 86 lpm. Peso: 63 kg. Talla: 155 cm. IMC: 26,2kg/m2.
Buen estado general. Buen color de piel y mucosas. Cuello: no ingurgitación yugular. Latido carotideo rítmico y simétrico. No soplos. Auscultación cardíaca: tonos cardiacos rítmicos, sin soplos. Auscultación pulmonar: Murmullo vesicular fisiológico. Extremidades: No edema. Pulsos conservados.
Exploraciones complementarias:
- Electrocardiograma: Ritmo sinusal a 61 lpm. Eje semivertical. Alto voltaje de QRS. Repolarización precoz.
- Ecocardiograma-doppler: Ventrículo izquierdo de dimensiones normales. Sin alteraciones de la contractilidad segmentaria. FEVI normal. Función diastólica normal. Ventrículo derecho normal en dimensión y función. Aurículas de tamaño normal. Sin valvulopatías significativas. Raíz aórtica de tamaño normal. Vena cava inferior no dilatada y que colapsa adecuadamente. Sin derrame pericárdico.
- Coronariografía por TAC inicial: Puntuación total de calcio coronario: 0. Arterias coronarias sin estenosis significativas. CARADS 1. Dilatación ectásica, prácticamente aneurismática, del segmento medio de la arteria circunfleja.
- Analítica primera valoración en nuestro centro: Colesterol total 172 mg/dL, LDL 106 mg/dL, HDL 55 mg/dL, Triglicéridos 56 mg/ dL, Lipoproteína A 30.40 mg/dL.
PARA EL MANEJO DEL RIESGO CARDIOVASCULAR
Rocío Álvarez Abril y Alba Domínguez Castillo
Ante la evidencia de dilatación aneurismática del segmento medio de arteria circunfleja y antecedente de dislipemia familiar, se considera al paciente de alto riesgo cardiovascular, iniciando antiagregación en prevención primaria con Ácido acetilsalicílico (AAS) y se intensifica tratamiento hipolipemiante incrementando dosis de Atorvastatina. Además, debido al alto riesgo cardiovascular, se incrementa el seguimiento del paciente para asegurar un adecuado control lipídico y valorar posible progresión de la enfermedad. Este seguimiento se realiza con controles analíticos habituales en su centro de Atención
Primaria de referencia y revisiones periódicas anuales en consulta de prevención cardiovascular. A los dos años de revisión se realiza nueva coronariografía por TAC, en la que se observa progresión de ateromatosis (Coronariografía por TAC: Calcio coronario 4,1. Placas no calcificadas en segmento proximal de arteria coronaria derecha, en tronco principal izquierdo y arteria descendente anterior de estenosis <25% y placa no calcificada en segmento medio arteria descendente anterior con estenosis 25-49%),
Ante evidencia de progresión de la enfermedad y perfil lipídico con colesterol total de 169 mg/dL, LDL 99 mg/dL, HDL 58 mg/dL y triglicéridos de 58 mg/dL, se intensifica el tratamiento para obtener un mejor perfil lipídico. Por ello, se decide iniciar triple terapia hipolipemiante con Rosuvastatina, Ezetimibe y Ácido bempedoico.
Se realiza nueva revisión al año, tras cambio de tratamiento. Se observa una analítica con mejoría de perfil lipídico, consiguiendo colesterol total 139 mg/dL, LDL 68 mg/dL, HDL 48 mg/dL y triglicéridos 52 mg/dL. Se repite coronariografía TC, sin progresión de la enfermedad. Ante estos datos analíticos, se continuará con seguimiento estrecho del paciente y se valorará la introducción de nuevos tratamientos hipolipemiantes en caso de necesitar conseguir objetivo LDL <55 mg/ dL por progresión de la enfermedad o aparición de nuevos factores de riesgo cardiovascular.
La hipercolesterolemia familiar se caracteriza por un incremento de LDL, predisponiendo a aterosclerosis prematura. Este tipo de pacientes se considera de alto riesgo cardiovascular independientemente de su SCORE2 según las guías de prevención cardiovascular ESC 2021, recomendando como objetivo LDL <70 mg/dL(1). En pacientes
II CLINIC CONTEST NAVARRA En Fibrilación Auricular, Tromboembolismo Venoso asociado al Cáncer y Control de Dislipemia con Terapia Oral en el ámbito sanitario de Navarra Control de Dislipemia con Terapia Oral
con dislipemia familiar, en ocasiones, es muy difícil lograr llegar al objetivo deseado con tratamiento oral convencional, requiriendo de tratamientos orales combinados o incluso tratamiento con iPCSK9 (2,3).
Por otro lado, la presencia de aneurisma coronario también incrementa el riesgo cardiovascular del paciente, añadiendo complejidad al caso. A pesar de que en las guías europeas no se hace especial mención a la presencia de esta enfermedad coronaria como modificador del riesgo, las guías de la AHA sobre síndrome coronario crónico consideran esta entidad como alto riesgo cardiovascular, recomendando tratamiento en prevención primaria con AAS y tratamiento hipolipemiante con objetivo LDL <70 mg/dL e incluso de <55 mg/dL en presencia de otros factores de riesgo cardiovascular (4).
La ateroesclerosis produce disfunción endotelial en la pared coronaria, secundaria a la inflamación crónica y proliferación de células musculares lisas; estos mecanismos debilitan la pared coronaria, favoreciendo la formación de aneurismas. Además, los aneurismas coronarios se asocian con incremento de riesgo trombótico por estasis sanguínea. La asociación de arterioesclerosis con aneurisma coronario hace que se incremente el riesgo trombótico (5,6).
Es por ello que en este paciente -a pesar de estar asintomático presenta un incremento de riesgo ateroesclerótico por dislipemia familiar, asociado a la presencia de aneurisma coronario- es de relevancia un seguimiento estrecho de sus factores de riesgo cardiovascular tanto por Atención Primaria como Especializada, con el fin de lograr objetivos de LDL <70 mg/dL e incluso de 55 mg/dL.
PARA EL MANEJO DEL RIESGO CARDIOVASCULAR
Rocío Álvarez Abril y Alba Domínguez Castillo
1. Visseren FLJ, Mach F, Smulders YM, Carballo D, Koskinas KC, Bäck M, et al. 2021 ESC Guidelines on cardiovascular disease prevention in clinical practice. Eur Heart J. 2021 Sep 7;42(34):3227-3337. doi: 10.1093/eurheartj/ ehab484.
2. Kelly MS, Sulaica EM, Beavers CJ. Role of Bempedoic Acid in Dyslipidemia Management. J Cardiovasc Pharmacol. 2020;76(4):376-388. doi:10.1097/ FJC.0000000000000887.
3. Lloyd-Jones DM, Morris PB, Ballantyne CM, et al. 2022 ACC Expert Consensus Decision Pathway on the Role of Nonstatin Therapies for LDL-Cholesterol Lowering in the Management of Atherosclerotic Cardiovascular Disease Risk: A Report of the American College of Cardiology Solution Set Oversight Committee. J Am Coll Cardiol. 2022;80(14):1366-1418. doi: 10.1016/j.jacc.2022.07.006.
4. Virani SS, Newby LK, Arnold SV, et al. 2023 AHA/ACC/ACCP/ASPC/NLA/ PCNA Guideline for the Management of Patients With Chronic Coronary Disease: A Report of the American Heart Association/American College of Cardiology Joint Committee on Clinical Practice Guidelines. J Am Coll Cardiol. 2023;82(9):833-955. doi: 10.1016/j.jacc.2023.04.003.
5. Siasos G, Tsigkou V, Coskun AU, et al. The Role of Shear Stress in Coronary Artery Disease. Current Topics in Medicinal Chemistry. 2023;23(22):21322157. doi:10.2174/1568026623666230329085631.
6. Park SJ, Kim H, Park JK. Comparison of Clinical and Hematologic Factors Associated With Stenosis and Aneurysm Development in Patients With Atherosclerotic Arterial Disease. Ann Vasc Surg. 2019; 60:165-170. doi: 10.1016/j.avsg.2019.03.003
II CLINIC CONTEST NAVARRA En Fibrilación Auricular, Tromboembolismo Venoso asociado al Cáncer y Control de Dislipemia con Terapia Oral en el ámbito sanitario de Navarra
CASOS PRESENTADOS

Adrián Jiménez Delgado.
MIR. Neurología.
Elena María Escriche Gorospe
MIR. Neurología.
Inhar Esnaola Barriola
MIR. Neurología
Hospital Universitario de Navarra (HUN)


EL PAPEL DE LA LIPOPROTEÍNA(A) EN LA PATOGENIA VASCULAR
Adrián Jiménez Delgado, Elena María Escriche Gorospe y Inhar Esnaola Barriola
Paciente de 62 años con antecedentes personales de hipertensión arterial sin tratamiento e hipercolesterolemia (último LDL 199 mg/dL 2 años antes de la primera valoración). Acude a servicio de Urgencias por un cuadro de sensación de mareo e inestabilidad, pérdida de visión en hemicampo derecho y dificultad para comprender lo que leía y lo que quería escribir. El episodio duró en torno a 10 minutos, con posterior recuperación espontánea. La exploración en Urgencias fue normal y se completó el estudio con un TAC Craneal que no mostró alteraciones significativas. Ante la sospecha de AIT (Accidente Isquémico Transitorio), se inicia tratamiento con AAS.
Valorado en consulta 5 días más tarde, el paciente se encuentra asintomático. Se realiza eco-doppler de troncos supra aórticos y transcraneal, con hallazgos de estenosis significativa en territorio proximal de Arteria Cerebral Media (ACM) izquierda/territorio distal de Arteria Carótida Interna (ACI) intracraneal. Dada la clínica y hallazgos, se solicita estudio con analítica de sangre con perfil lipídico, Resonancia Magnética (RM) y angio-Resonancia Magnética (angio-RM)
En La RM y angio-RM realizadas al día siguiente, no se observan signos de isquemia cerebral aguda, pero sí alguna lesión puntiforme previa de probable naturaleza vascular. Además, se identifica una estenosis crítica de la ACI intracraneal distal izquierda que afecta al segmento A1 de la Arteria Cerebral Anterior (ACA) y M1 de la Arteria Cerebral Media (ACM) proximales del mismo lado. La analítica realizada muestra elevación de colesterol 239 mg/dl con HDL 49 mg/dl y LDL 163 mg/dl.
Tras la obtención de estos resultados, se diagnostica al paciente de AIT de etiología aterotrombótica, por lo que se intensifica el tratamiento con doble antiagregación (Acido Acetilsalicilico 100 mg + Clopidogrel 75 mg), antihipertensivo oral (Bisoprolol 2,5 mg) y terapia hipolipemiante (Rosuvastatina 20 mg + Ezetimiba 10 mg), además de insistir en la importancia del control de factores de riesgo cardiovascular con dieta y ejercicio.
A los 3 meses se repite analítica de sangre donde se constata una reducción de los niveles de colesterol (129mg/dl) y una reducción superior al 50% de los niveles de LDL (67mg/dl). El paciente es seguido en consulta permaneciendo asintomático y con buen control de cifras de PA, y niveles de LDL estables en torno a 70 mg/dl. A los 6 meses, se realiza una angio-Tomografía Computarizada (angio-TC),
II CLINIC CONTEST NAVARRA En Fibrilación Auricular, Tromboembolismo Venoso asociado al Cáncer y Control de Dislipemia con Terapia Oral en el ámbito sanitario de Navarra
Control de Dislipemia con Terapia Oral
donde persiste la estenosis crítica en la ACI intracraneal terminal y sus ramas, y pueden apreciarse placas de ateroma calcificadas en dicha localización.
Dos años más tarde, el paciente refiere alteraciones a nivel cognitivo. Se realiza estudio neuropsicológico en el que se objetiva déficit leve en la memoria de trabajo tanto a nivel de bucle fonológico que satura con escasos ítems y en el Sistema Atencional Supervisor, a la hora de manipular la información con la que opera. Se realiza una nueva RM y angio-RM donde se observa una progresión de la estenosis que afecta al sifón carotídeo izquierdo y sus ramas intracraneales.
En controles sucesivos, tras constatar un empeoramiento radiológico y, a nivel analítico, unos niveles de LDL de 69 mg/dl y una elevación de Lipoproteina A 82 mg/dl (<50mg/dl), el paciente se considera de muy alto riesgo vascular. Con el objetivo de alcanzar cifras de LDL <55 mg/dl, se añade al tratamiento Ácido bempedoico y en analíticas posteriores se logra reducir el LDL a 60 mg/dl, aunque la lipoproteína A persiste en cifras incluso más elevadas (97 mg/dl)
En este contexto, dado los hallazgos radiológicos y progresión de la estenosis intracraneal, junto con la clínica referida (AIT y alteración cognitiva leve), el paciente es diagnosticado de Síndrome de Moyamoya unilateral por probable aterosclerosis.
DISCUSIÓN
La enfermedad de Moyamoya es una afección cerebrovascular estenooclusiva caracterizada por la estenosis progresiva de la porción terminal de la arteria carótida interna y la formación de una red anormal de perforantes dilatadas y frágiles en la base del cerebro, en ausencia de comorbilidades asociadas que puedan influir(1). Desde la década de 1950, esta rara enfermedad se ha reportado en Japón y gradualmente ha ganado reconocimiento en todo el mundo. Esta enfermedad puede cursar con cefalea, crisis epilépticas, AITs, ictus isquémicos/hemorrágicos, además de posible deterioro cognitivo. La etiopatogenia es desconocida, aunque sí que se ha atribuido a diferentes factores genéticos (como la mutación RNF213, especialmente en zonas orientales (2)), inflamatorios (enfermedades autoinmunes, post tratamiento radioterápico…). Sin embargo, sigue habiendo muchos interrogantes en este aspecto.
Con el objetivo de profundizar en la fisiopatología de dicha enfermedad, diferentes grupos de investigación han establecido guías
EL PAPEL DE LA LIPOPROTEÍNA(A) EN LA PATOGENIA VASCULAR
Adrián Jiménez Delgado, Elena María Escriche Gorospe y Inhar Esnaola Barriola
diagnósticas de la enfermedad de Moyamoya. En la última guía del Comité de Investigación de la Enfermedad de Moyamoya (1), se presentaron varios cambios, entre los que destaca la retirada del criterio de afectación estenooclusiva bilateral de la ACI intracraneal, dada la creciente evidencia de progresión de afectación unilateral a bilateral en la enfermedad de Moyamoya. Además, la afectación de la ACM o ACA proximal es criterio suficiente.
Aunque la afectación bilateral es típica en la enfermedad de Moyamoya, en fases tempranas puede presentarse de forma unilateral. En el pasado, esta presentación unilateral se denominaba “enfermedad de Moyamoya probable”, pero las guías actuales tienden a unificar la nomenclatura bajo el término de enfermedad de Moyamoya, independientemente de la lateralidad, siempre que no existan condiciones asociadas.
No obstante, hay pacientes que cumplen criterios diagnósticos de enfermedad de Moyamoya, pero presentan comorbilidades asociadas. Debido a ello, se ha designado un nuevo concepto que abarque esta condición: Síndrome de Moyamoya (Moyamoya-like). Las guías más recientes destacan enfermedades autoinmunes, meningitis, tumores cerebrales, síndrome de Down, neurofibromatosis tipo 1 como comorbilidades relacionadas; y aunque excluyen la ateroesclerosis y el hipertiroidismo (1), no hay un consenso universal al respecto. A pesar de ampliar este concepto, la patogenia sigue sin estar definida, pero hay indicios de alteración del metabolismo lipídico.
En concreto, hay un estudio (3) que relaciona este Síndrome de Moyamoya con el aumento de Lipoproteína a (como en el caso del paciente que se presenta), por lo que se requiere un manejo terapéutico más amplio, no solo con tratamiento antitrombótico, sino también con un control estricto de factores de riesgo cardiovascular.
La lipoproteína (a), abreviada como Lp (a), es una partícula lipoproteica plasmática que se asemeja estructuralmente a la lipoproteína de baja densidad (LDL). Las concentraciones de lipoproteína (a) están determinadas en más de un 90% por factores genéticos, con una influencia mínima del estilo de vida (4), mientras que las concentraciones de colesterol LDL están determinadas conjuntamente por el estilo de vida y la genética. Concentraciones elevadas (>50 mg/dl) se asocian con mayor riesgo cardiovascular debido a sus efectos proinflamatorios, proaterogénicos y protrombóticos, siendo especialmente significativo con valores >100-125 mg/dl. Hoy en día, no existen fármacos
II CLINIC CONTEST NAVARRA En Fibrilación Auricular, Tromboembolismo Venoso asociado al Cáncer y Control de Dislipemia con Terapia Oral en el ámbito sanitario de Navarra Control de Dislipemia con Terapia Oral
aprobados para reducir las concentraciones de lipoproteína a, pero existen varios ensayos en desarrollo.
En conclusión, el paciente del caso cumpliría criterios de Síndrome de Moyamoya debido a la morfología y afectación unilateral observada en las imágenes radiológicas, además de tener como comorbilidad la presencia de ateroesclerosis. Con el objetivo de reducir el riesgo de eventos vasculares en este tipo de pacientes, en adición al tratamiento antitrombótico, se requiere una optimización del tratamiento hipolipemiante y el ajuste de los factores de riesgo cardiovascular.
En este contexto, existen estudios en los que ya se ha relacionado el Síndrome de Moyamoya con la lipoproteína a debido a su efecto proinflamatorio y proaterogénico, por lo que, en estos pacientes, el tratamiento hipolipemiante cobra especial importancia ya que podría cambiar el curso de la enfermedad.
1. N. R. Gonzalez et al., «Adult Moyamoya Disease and Syndrome: Current Perspectives and Future Directions: A Scientific Statement from the American Heart Association/American Stroke Association», 1 de octubre de 2023, Wolters Kluwer Health. doi: 10.1161/STR.0000000000000443.
2. M. Ihara et al., «Moyamoya disease: diagnosis and interventions», 1 de agosto de 2022, Elsevier Ltd. doi: 10.1016/S1474-4422(22)00165-X.
3. X. Chen et al., «High lipoprotein(a) concentration is associated with moyamoya disease», Lipids Health Dis, vol. 23, n.o 1, dic. 2024, doi: 10.1186/ s12944-024-02015-1.
4. B. G. Nordestgaard y A. Langsted, «Lipoprotein(a) and cardiovascular disease», The Lancet, vol. 404, n.o 10459, pp. 1255-1264, sep. 2024, doi: 10.1016/S0140-6736(24)01308-4.

II CLINIC CONTEST NAVARRA En Fibrilación Auricular, Tromboembolismo Venoso asociado al Cáncer y Control de Dislipemia con Terapia Oral en el ámbito sanitario de Navarra
CASOS PRESENTADOS

Ángela Alonso Echarte.
MIR. Endocrinología y Nutrición.
Javier Aguirre Castiella.
MIR. Endocrinología y Nutrición.
Hospital Universitario de Navarra (HUN).
Ander Ernaga Lorea.
Endocrinología y Nutrición
Hospital García Orcoyen. Estella.

II CLINIC CONTEST NAVARRA En Fibrilación Auricular, Tromboembolismo Venoso asociado al Cáncer y Control de Dislipemia con Terapia Oral en el ámbito sanitario de Navarra Control de Dislipemia con Terapia Oral
Paciente de 56 años, natural de Albania y residente en España desde 2006, sin antecedentes médicos relevantes, remitida a nuestra consulta en 2007 tras detectarse en una analítica rutinaria un colesterol LDL de 434 mg/dl. Se repitió la determinación, confirmando el nivel, y descartando causas secundarias de hipercolesterolemia (hipotiroidismo, síndrome nefrótico, colestasis). No realizaba ningún tipo de dieta ni tomaba ningún fármaco ni producto de herboristería. Tiene tres hijos con hipercolesterolemia. Desconocía la existencia de más historia familiar de dislipemia, confirmando que no había consanguinidad ni eventos cardiovasculares precoces en la familia. No refería angina, claudicación intermitente o disnea.
En la exploración física, presentaba arco corneal y xantelasma en ambos párpados, no xantomas. Se realizó un estudio genético para hipercolesterolemia familiar que resultó negativo. En 2012 se perdió el seguimiento y fue derivada nuevamente en 2019, cuando se realizó el primer perfil lipídico completo: colesterol total 591 mg/dl, colesterol-LDL 525 mg/dl, colesterol-HDL 47 mg/dl, triglicéridos 95 mg/dl, apolipoproteína B100 (Apo B) 304 mg/dl (60-126 mg/dl), lipoproteína (a) < 9,94 mg/dl. También se realizó ecografía carotidea, TAC coronario y se repitió estudio genético. El grosor íntima-media de la arteria carótida común fue de 0,91 y 1,36 mm, sin detectar placa de ateroma. La medición mediante TAC de la calcificación de las arterias coronarias otorgó un valor de 148 unidades Agatston (percentil 93). El análisis genético mostró una mutación en homocigosis posiblemente patogénica, identificada como c.81C>G (p. Cys27Trp), que codifica para el receptor de LDL (LDLR), siendo la paciente diagnosticada de hipercolesterolemia familiar homocigota (HFHo).
El tratamiento hipolipemiante se inició a los 42 años (2007), con atorvastatina 80 mg cada 24 h, añadiendo Ezetimiba 10 mg al día debido a niveles de LDL en torno a 350 mg/dl. La paciente presentó mal control debido a la mala adherencia al tratamiento y mialgias por estatinas. Posteriormente, se perdió el seguimiento. Fue derivada nuevamente en 2019, con un valor de LDL de 423. Se inició tratamiento con Evolocumab 140 mg cada dos semanas en monoterapia, objetivando cifras de LDL de 525 mg/dl. Se comprobó que la técnica de inyección y adherencia eran correctas. En enero del 2020, tras alcanzar un LDL de 534 mg/dl, se suspendió el iPCSK9, la paciente rechazó tratamientos invasivos como aféresis y se inició rosuvastatina 20 mg y
Ángela Alonso Echarte, Javier Aguirre Castiella y Ander Ernaga Lorea
Ezetimiba 10 mg. No se realizaron mediciones de anticuerpos neutralizantes. Tras este cambio, el valor de LDL fue de 107 mg/dl (Gráfica 1).
La hipercolesterolemia familiar es la enfermedad hereditaria monogénica más común del metabolismo lipídico. Es una enfermedad con patrón de herencia autosómico dominante, pudiendo manifestarse de manera homocigótica o heterocigota. La hipercolesterolemia familiar homocigótica (HFHo) es el resultado de una mutación bialélica de genes que codifican las proteínas que regulan los niveles de colesterol (LDLR, Apo B, proproteínaconvertasa subtilisina/kexina tipo 9 (PCSK9) y Apo E) (1). Su prevalencia estimada en España de 1:450.000. La mayoría de los casos afecta al gen del LDLR (2). Las manifestaciones clínicas son reflejo de los niveles extremadamente altos de colesterol LDL desde el nacimiento. Los pacientes con HFHo suelen presentar un fenotipo más severo que la hipercolesterolemia familiar heterocigota (HFHe), con cifras de c-LDL superiores a 400 mg/dl sin tratamiento (> 300 mg/dl con tratamiento), xantomas antes de la edad de 10 años, alto riesgo de estenosis aórtica, ateroesclerosis acelerada y mortalidad coronaria hacia los 20-30 años (3,4). El diagnóstico puede realizarse mediante criterios clínicos (c-LDL sin tratamiento ≥ 400 mg/dl, xantomas cutáneos y/o tendinosos evidenciados antes de los 10 años de edad o niveles elevados de c-LDL sin tratamiento en ambos progenitores, compatible con HFHe) o mediante pruebas genéticas (3.4). Es imprescindible instaurar tratamiento de alta intensidad de manera escalonada desde edades precoces. Los fármacos disponibles para el tratamiento de la HFHo son las estatinas, Ezetimiba, inhibidores de PCSK9 (iPCSK9) (Evolocumab, Alirocumab), Inclisiran y Lomitapida (5).
Este caso presenta varias peculiaridades. En primer lugar, que no haya desarrollado ECV. La esperanza de vida media en pacientes con HFHo entre 1964 y 2014 descrita es 32,6 ± 11,5 años. Sin tratamiento, más del 50 % de los pacientes con HFHo desarrollan ECV clínicamente significativa antes de los 30 años, y en algunos pacientes pueden presentarse eventos cardiovasculares antes de los 10 años. Casi el 90 % de los pacientes con HFHo sufren un evento cardiovascular antes de los 40 años (6). Se han descrito como factores protectores de ECV en esta enfermedad el género femenino, niveles altos de HDL, no fumar y niveles altos de adiponectina (7). En segundo lugar, la tenden-
II CLINIC CONTEST NAVARRA En Fibrilación Auricular, Tromboembolismo Venoso asociado al Cáncer y Control de Dislipemia con Terapia Oral en el ámbito sanitario de Navarra Control de Dislipemia con Terapia Oral
cia al alza de las LDL tras el inicio de iPCSK9 fue sorprendente. La falta de respuesta a iPCSK9 viene definida como una disminución de las LDL por debajo del 15%, ocurriendo fundamentalmente por falta de adherencia terapéutica, lo cual se descartó en nuestro caso, ya que se comprobó que la adherencia era correcta. Otra posibilidad de falta de respuesta sería el desarrollo de anticuerpos neutralizantes, pero dadas las bajas tasas de inmunogenicidad y su temporalidad, la sugiere una disminución de eficacia por desarrollo de anticuerpos neutralizantes. En pacientes con HFHo, la respuesta a los iPCSK9 varía según el defecto genético específico, observándose una mayor reducción del LDL en sujetos con dos mutaciones defectuosas del receptor de LDL en comparación con aquellos pacientes con incluso una sola mutación nula del receptor de LDL (4). En nuestro caso, la paciente presentaba una mutación nula en homocigosis, lo que podría explicar la menor respuesta al tratamiento con iPCSK9. Y en tercer lugar, fue llamativo que a pesar de ser portadora de una mutación nula en homocigosis, la sensibilidad y rapidez de respuesta a las estatinas de alta intensidad combinada con Ezetimiba fueron notables, consiguiendo reducciones de LDL del 80%, ya que las mutaciones nulas del gen del LDLR se acompañan de menor respuesta a estatinas. En conclusión, presentamos a un paciente adulto diagnosticado de HFHo sin ECV a pesar de no lograr un control óptimo de los niveles de LDL, presentando una respuesta paradójica a los iPCSK9 y una espectacular reducción del colesterol con estatina de alta intensidad asociado a Ezetimiba.
Ángela Alonso Echarte, Javier Aguirre Castiella y Ander Ernaga Lorea
1. Tromp TR, Hartgers ML, Hovingh GK, Vallejo-Vaz AJ, Ray KK, Soran H,et al., Homozygous Familial Hypercholesterolaemia International ClinicalCollaborators. Worldwide experience of homozygous familial hypercholestero-laemia: Retrospective cohort study. Lancet. 2022;99:719–28.2.
2. Sánchez-Hernández RM, Civeira F, Stef M, Perez-Calahorra S, Almagro F, PlanaN, et al. Homozygous familial hypercholesterolemia in Spain: Prevalence andphenotype-genotype relationship. Circ Cardiovasc Genet. 2016; 9:504–10.3.
3. Ascaso JF, Mata P, Arbona C, Civeira F, Valdivielso PML. [Homozygous fami-lial hypercholesterolaemia: Spanish adaptation of the position paper from theConsensus Panel on Familial Hypercholesterolaemia of the European Atheros-clerosis Society Consensus document of the Spanish Society of Arteriosclerosis (SEA) and Familial Hypercholesterolaemia Foundation (FHF)]. Clin Investig Arter.2015;27:80–96.4.
4. Feingold KR, Ahmed SF, Anawalt B. Familial Hypercholesterolemia: Genes and Beyond. Endotext [Internet]. South Dartmouth (MA); 2000.
5. Vivas, D., Escobar, C., Cordero, A., Fernández-Olmo, R., Oterino, A., BlancoEchevarría, A., Botana, M., Escribano, D., Freijo, M. del M., Martínez-Losas, P., Pascual, V., Quiroga, B., Sánchez-Peinador, C., Torres-Fonseca, M., Freixa-Pamias, R., Barrios, V., & Barón-Esquivias, G. (2024). Uso de nuevas terapias hipolipemiantes en la práctica clínica. Consenso SEC/SEA/SEEN/ SEMFYC/SEMERGEN/SEMG/SEN/SEACV/S.E.N. REC: CardioClinics, 59(4), 310–321.
6. Raal FJ, Pilcher GJ, Panz VR, van Deventer HE, Brice BC, Blom DJ, Marais AD. Reduction in mortality insubjects with homozygous familial hypercholesterolemia associated with advances in lipid-lowering therapy. Circulation. 2011;124(20):2202-2207
7. Khoury E, Brisson D, Roy N, Tremblay G, Gaudet D. Identifying markers of car-diovascular event-free survival in familial hypercholesterolemia. J Clin Med.2021;10:1–13.
II CLINIC CONTEST NAVARRA En Fibrilación Auricular, Tromboembolismo Venoso asociado al Cáncer y
Control de Dislipemia con Terapia Oral en el ámbito sanitario de Navarra
Control de Dislipemia con Terapia Oral
Gráfica 1: Evolución de los niveles de colesterol LDL
Agra Martínez, Claudia. ............................................................................ 250
Aguirre Castiella, Javier. ........................................................................... 331
Alaez Cruz, J. Ignacio. ................................................................................. 39
Alfonso Imízcoz, María. ............................................................................. 229
Alonso Echarte, Ángela. ........................................................................... 331
Álvarez Abril, Rocío. .................................................................. 28, 316, 321
Álvarez Aramburu, Ana María. ................................................. 73, 219, 234
Amigot Baldero, Diego. ................................................................... 224, 257
Anniccherico Sánchez, Francisco Javier. ................................................. 239
Aparicio Cordero, Laura. ............................................................................. 73
Aragón Muñoz, Pablo. ...................................................................... 219, 279
Arnedo Hernández, Sergio. ...................................................................... 284
Baniandrés Eizaguirre, Sofía. .................................................................... 304
Cabasés Ordóñez, Amaia. ................................................................ 110, 180
Cañete Dellamea, Eugenia. 174
Criado Martín, Irene. ................................................................................. 100
De La Escosura Muñoz, Marina. 146, 169
Domínguez Castillo, Alba. ............................................................... 316, 321
Ecay Narvaiz, Javier. 110, 180
Echauri Carlos, Enara. .............................................................. 122, 224, 257
Ernaga Lorea, Ander. ........................................................................ 304, 331
Escriche Gorospe, Elena María. ............................................. 213, 310, 326
Esnaola Barriola, Inhar. ............................................................ 213, 299, 326
Espinoza Pérez, José Alberto. .................................................................... 169
Fernández González, Andoni. ............................................ 33, 85, 135, 140
Frigola Castro, Roger Antoni. .................................................................... 122
García Bascones, June. ....................................................................... 95, 284
García Zuazola, Ángela. .............................................................. 45, 51, 115
Gavira Gómez, Juan José. ........................................................................... 28
Gil Sodupe, Óscar. ...................................................................................... 229
Gómez Arteta, Emilio................................................................................. 157
Gómez Garduño, Ángela. ................................................................ 105, 269
González Glaría, Belén. ............................................................................ 244
Gutiérrez Dubois, Jorge. ............................................................................. 39
Herrero González, Paola. .................................................................... 57, 62
Herrero Martín, Sonia. ............................................................................... 191
Ibargoyen Aira, Amaia Yuan. ................................................................... 294
Idoate Domenech, Carlos. ......................................................................... 191
Illarramendi Esteban, Jorge. ...................................................................... 157
Illarramendi Mañas, José Juan. .................................................................. 157
Jiménez Delgado, Adrián. ......................................................................... 326
Labari Jiménez, Sara. ................................................................................. 202
Langarica Villar, Leyre. .............................................................................. 180
Lasa Berasain, Pablo. ................................................................................. 197
Lecumberri Biurrun, María José. ............................................................... 207
Legarra Oroquieta, Pablo. .......................................................................... 33
López De Jaime, Blanca. ...................................................................... 67, 73
Lorente Escudero, Marta. 90, 244
Loyola Arrieta, Amaia. ................................................ 78, 85, 135, 140, 274
Macua Landívar, Andrea. 234
Malagón López, Lorena. ............................................................................ 262
Martín Serrablo, Ana José. 122, 146
Martínez Adán, Ignacio Antonio. ............................................................. 191
Martínez Campos, Elisa. ........................................................................... 299
Martínez León, Amaia. ............................................................................... 135
Millán Bernal, Jana. ..................................................................................... 67
Modesto Dos Santos, Joao Luis. ............................................................... 257
Molina Goicoechea, María. .............................................................. 213, 310
Moneo Puig, Marta. ........................................................................... 185, 207
Muñoz Arrondo, Roberto. ......................................................................... 299
Ochoa González, Amaia. ............................................................................ 28
Odriozola Garmendia, Maite. ............................................................ 78, 274
Olaizola Guerrero, Maider. ................................................................. 95, 284
Ortega Picón, Andrea. ............................................................................... 229
Otermin Maya, Ignacio. ............................................................................... 39
Planelles Ripoll, Marina. ............................................................................ 185
Poyo Molina, Iñigo. .................................................................................... 128
Rodríguez Villeda, Stephania. .................................................................... 90
Sádaba Martínez, Amaya. ............................................................... 202, 250
Salterain González, Nahikari. ..................................................................... 28
Sánchez Cordero, Iratxe. .......................................................................... 105
Sánchez Pastor, Ainhoa. ................................................................... 219, 279
Santisteban Alonso, María del Carmen. ....................................... 57, 62, 90
Segur García, Marina. ................................................................................ 163
Setuain Indurain, Ariadna. ................................................................ 152, 197
Smith López, Ana. ................................................................................ 57, 62
Sola Aparicio, Elena. ................................................................................... 23
Suescun Colomo, Inés. ........................................................ 45, 51, 100, 115
Taboada Palacios, Maddi. ................................................................. 239, 269
Téllez Lorenzo, Andrea. ............................................................................. 169
Torrecilla Ugarte, Amaia. 152, 197
Ugarriza Ortueta, Julene. .......................................................................... 289
Urtasun Rezusta, Amaia. 105,174
Valderas Monge, Laura. .................................................................... 239, 269
Velasco Gametxogoikoetxea, Coro. 45, 51, 115
Vera Sainz, Alberto. .................................................................................... 23
Virosta Gil, Marina. .............................................. 33, 78, 85, 140, 274, 279
Vizcay Aranaz, Carlos. ....................................................................... 95, 224
Yoldi Urdíroz, Jon. ..................................................................................... 304
Zandio Amorena, Beatriz. ........................................................................ 310
Este libro se editó en Pamplona en junio de 2025

